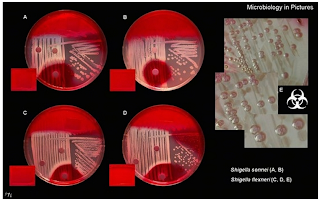

Tema 1 - Microbiologia Clínica
(evolución histórica, conceptos generales, organización de laboratorio)
Microbiología - la ciencia que estudia los seres vivos no visibles al ojo desnudo (microorganismos; aunque se incluyen metazoos parásitos no microscópicos), que atribuyen el origen de la vida sobre la tierra y el mantenimiento del equilibrio en la biosfera (en vida libre como saprofitos o depredadores con distinto grado de simbiosis => comensalismo, mutualismo o parasitismo), aunque también tienen efectos negativos como producir enfermedades; Los virus y viroides => parásitos endo-celulares obligados (no se replica en vida libre); Microbiología medica => estudia a los microorganismos que afectan al hombre (reino procariota/ bacterias, los eucariotas del reino Fungí, los virus y viroides); Parasitología => estudia los eucariotas microscópicas (protozoos) y macroscópicas (metazoos) de endo o ectoparásito (los artrópodos estudiados también como vectores y reservorios de enfermedades transmisibles);
Microbiología medica:
- Microbiología general => se estudia conocimientos históricos, clasificación, estructura y fisiología de los microorganismos.
- Microbiología especial => se estudia 4 grupos de agentes infecciosos (bacteriología, virología, micología y parasitología) + recientemente los viroides (moleculas circulares de ARN de bajo peso molecular que carecen de cubierta proteica) y los priones (proteínas codificadas por genes celulares y actúan como señales reguladoras, responsables de algunas enfermedades neurológicas graves - Creutzfeldt-Jacob y el Kuru)
Evolución histórica de la microbiología - como ciencia especializada no aparece hasta finales del siglo XIX; cuatro periodos:
-1º => periodo especulativo (desde la antigüedad hasta los primeros microscopistas)
-2º => desde 1675 hasta la mitad del siglo XIX (descubrimiento de los microorganismos por Leeuwenhoek en 1675 - constructor de lentes holandes que inventó el microscópio simple)
-3º => periodo de cultivo de microorganismos hasta finales de siglo XIX (Pasteur y Koch logro cristalizar a la Microbiología como ciencia experimental bien asentada.
-4º => desde principios del siglo XX hasta ahora (se estudian fisiológica, bioquímica, genética, ecológica y surgimiento de virología, inmunológia.
- Redi, Spallanzani y otros fisicos del siglo XVII demostraron que el microorganismo no se genera espontaneamente (de novo), postularon la teoría de la biogénesis (ser vivo nace de otro ser vivo).
- Pasteur (1822-1895) demostró que la fermentación era producida por microorganismos en crecimiento.
- Se dobló el interes de muchos naturalistas tras la publicación de los libros de Darwin.
- Davaine (1863-1868) encontró grandes cantidades de m.o. en la sangre de las vacas (bacteridios) y Robert Koch (1843-1910) en 1876 aisló con sus técnicas de cultivo puro el bacilo de antrax (Bacillus anthracis); mas tarde Koch y su colegas confirmaron que las esporas son formas diferenciadas y resistentes de bacilos y demostraron que la enfermedad podía transmitir sucesivamente a ratones sanos inoculándose bacilos obtenidos de cultivo puro; basados en los postulados su maestro Henle, Koch postuló siguentes criterios:
- el microorganismo debe estar presente en todos los individuos enfermos
- el m.o. debe poder aislarse del hospedador y ser crecido en cultivo puro
- la inoculación del m.o crecido en cultivo puro a animales sanos debe provocar la aparición de sintomas específicos de la enfermedad en cuestión (cada enfermedad infecciosa esta causada por un tipo de bacteria diferente)
- el m.o. debe poder ser re-aislado del hospedador infectado de forma experimental.
Las 2 décadas siguientes, se aislaron una gran variedad de bacterias patógenas; en Francia el Instituto Pasteur se concentro sobre los procesos infectivos, la inmunidad del hospedador y la obtención de vacunas (vacuna antirrábica ensayada por Pasteur en 1885, contribuye al nacimiento de la inmunológia).
Conceptos generales y clasificación - al finales del siglo XIX los microorganismos se agrupan en un nuevo reino fuera de la teoría de Darwin => Protistas para los protozoos, las algas microscópicas, los hongos microscópicos y las bacterias como seres microscópicos; Chatton en 1932 clasifica a los seres vivos en 4 reinos => animalia, plantae, protistas inferiores o procariotas (bacterias) y protistas superiores o eucariotas (algas, hongos y protozoos); Whittaker en 1969 agrupa en 5 reinos => animalia, plantae, fungi, procariotas y protista; Magulis en 1992 los agrupa definitivamente por ahora en 2 superreinos /dominios, 5 reinos y 2 subreinos =>
- Dominio: procaryotae, 1 reino: monera, subreino: archeobacteria y eubacteria (incluyendo todas las bacterias divididas en grupos)
- Dominio: eucaryotae, con 4 reinos: protista, fungí, animalia y plantae (incluyendo protozoos, hongos, algas, animales y vegetales); protista => son unicelulares eucariontes pero que no cumplen con las características para estar en algún otro reino organismos de este tipo (p.ej. protozoos)
Diferencias básicas entre los procariotas y los eucariotas:
- célula eucariótica => presenta un núcleo verdadero rodeado por una membrana nuclear con determinado numero de cromosomas que están constituidos por ADN e hitonas (proteínas del núcleo); el citoplasma contiene mitocondrias, cloroplastos, ribosomas y otros orgánulos celulares y todo ello se recubre por una membrana que se prolonga hacia el interior, organizando unos canales en el que forma el retículo endo-plasmático (donde se encuentran los ribosomas - responsables de la síntesis de proteínas); la membrana celular puede o no recubrirse de pared celular (carece de peptidoglicano) para protección o dar la consistencia a la célula; posee celulosa o quitina.
- célula procariótica => mas primitiva, no esta organizada y no posee verdadero núcleo (ADN no esta rodeado de una membrana - se encuentra libre); no posee mitocondrias, sino mesosomas (repliegues de la membrana celular donde se hallan las enzimas responsables de la respiración); tampoco hay cloroplastos, sino cromatóforos (contienen clorofilas); los ribosomas se encuentran pegados a la membrana citoplasmática que están protegidas por una pared celular (peptidoglicano - exclusivo de procariotas, aunque arqueo-bacterias y micoplasmas no lo poseen); las arqueo-bacterias, las eubacterias y los eucariotas se difieren en => la estructura de RNA polimerasa y en la composicion de los lípidos de su membrana.
- los virus => un grupo aparte que no se ha integrado en ningún reino y se discute si son o no seres vivos; es incapaces de reproducirse por si mismos, dependen de un huésped que les proporcione el mecanismo de la replicación y síntesis de macromoléculas); una vez que han conseguido esto, salen de la célula infectada produciendo su muerte; hay virus que infectan a celulas animales, otros a vegetales y otros a bacterias; un virus se define como => un bloque de material genético rodeado por una cubierta proteica que le sirve como vehículo de transmisión; algunos pueden llevar una envoltura circundante compuesta de lípidos y carbohidratos; los viroides (30 especies) => agentes infecciosos (de menor complejidad genética y estructural conocida) que solo afectan a plantas superiores; constituidos por 1 cadena de ARN cíclica corta que no codifica proteínas; tamaño 10 veces menor que los virus (parecen ser una etapa primitiva de los virus); los priones (proteinceous infectious particle) => partículas patógenas de naturaleza proteica sin acido nucleico; identificados en 1982, aunque desde el siglo XVIII se sospechaba de su existencia; las enfermedades "prion" en el hombre (encefalopatías espongiformes transmisibles) afectan al sistema nervioso y se cree que también a los musculos.
Organización de un laboratorio de microbiologia clínica
Estructura (depende del tamaño y características, espacio que dispone y numero de personal):
1. Áreas/ secciones básicas:
- Sección de toma de muestras
- Sección de recepción y registro de muestras
- Sección de siembra de muestras
- Sección de medios de cultivo
- Área de almacén
2. Áreas/ secciones especializadas:
- Sección de bacteriología (se divide en áreas => urocultivos, coprocultivos y parásitos, exudados y anaerobios, hemocultivos)
- Sección de micobacterias
- Sección de micología
- Sección de antibióticos
- Sección de serología o inmuno-microbiología
- Otras secciones (virología o biología molecular)
Normas de seguridad e higiene en el trabajo - tratan de evitar el riesgo de infección al personal que trabaja en el laboratorio así como su extensión a la comunidad (establecidas por el CDC/ centro de control de la enfermedad) americano y del instituto nacional de salud de ese país.
Niveles de seguridad biología:
Nivel 1 => valido para laboratorios de enseñanza que trabajan con microorganismo no patógenos bien conocidos y patógenos oportunistas:
- las puertas permanecen cerradas mientras se trabaja
- las mesas de trabajo se desinfectan al terminar el trabajo y cuando es necesario (derrame/contaminación)
- todo material contaminado debe ser esterilizado antes de desecharlo
- no pipetear aspirando con la boca
- no comer, fumar, aplicarse cosméticos, morder los lapices, bolígrafos o tener alimentos en el laboratorio.
- lavarse las manos después de trabajar con microorganismos y al terminar la jornada (uso de guantes).
- realizar las técnicas correctamente, evitando la producción de aerosoles.
- llevar bata durante el trabajo que se quitara al salir del laboratorio.
- los materiales que no pueden ser esterilizados en el propio laboratorio, se transportaran en contenedores cerrados para el traslado hasta su descontaminación; debe existir autoclave para descontaminar en el mismo edificio.
- deben existir programas de desinfección y desratización
- el diseño del laboratorio debe permitir una fácil limpieza incluso entre los muebles que deben ser impermeable, resistentes a los ácidos, álcalis y al fuego.
- cada laboratorio debe tener un lavabo.
- si las ventanas se pueden abrir, deben estar protegidas con mosquiteros
Nivel 2 => permite el trabajo con microorganismo de peligrosidad potencial moderada (hospitales o centros de salud a nivel primario); ademas de las normas del nivel 1, comprende las siguientes:
- es obligatorio el uso de bata o pijamas que no deben usarse fuera del laboratorio, especialmente en el comedor o cafetería o salidas fuera del edificio.
- las técnicas serologícas con Ags sin capacidad infectante pueden realizarse en las mesas de trabajo
- el acceso al laboratorio debe estar limitado.
- se deben utilizar guantes en todas las técnicas con productos potencialmente peligrosos o animales.
- en un accidente de exposición a productos contaminados (derrame, pinchazos), comunicar inmediatamente al responsable del laboratorio.
- se toma una muestra de suero del personal cuando comienza a trabajar, se archivara como suero base.
- existirá un manual de normas de seguridad en el laboratorio que todo el mundo debe conocer y donde se exponga lo que debe hacerse ante un accidente.
- se trabajara con cabinas de seguridad de nivel I, II o III cuando se realicen técnicas que suponen producción de aerosoles como centrifugación, homogenización de muestras, siembra o procesamiento de muestras en general.
Nivel 3 => es adecuado para trabajar con microorganismos de alto riesgo y comprende las normas de los niveles 1 y 2 y ademas:
- todas las actividades con microorganismo o productos potencialmente patógenos se realizaran en cabinas de seguridad; ningún trabajo se realizara en las mesas de trabajo.
- se utilizaran batas abiertas por la espalda, que no deben llevarse fuera del laboratorio; utilizar guantes cuando se trabaja con material contaminado o animales que se desinfectaran antes de desecharlos; en las habitaciones donde se tienen los animales se utilizaran mascarillas rígidas.
- en el laboratorio no debe haber plantas o animales que no se utilicen en el trabajo.
- el laboratorio debe estar aislado de la circulación general, existiendo una doble puerta de entrada con una habitación para cambiarse de ropa y con ducha.
- las superficies y los muebles deben ser de fácil limpieza; las ventanas deben cerrar hermeticamente; las puertas se cerraran automáticamente.
- cerca de las puerta de salida existirán lavabos que pueden accionar con el pie, codo o rodilla.
- existirá un autoclave para descontaminar en el propio laboratorio
- existirá un sistema de extracción de aire con circulación del mismo de la puerta de entrada hacia el interior del laboratorio; regulación de la entrada y salida del aire acondicionado; el aire de salida de las cabinas de seguridad tipo III saldrá directamente al exterior; el de las cabinas tipo I y II se elimina directamente al exterior o al sistema general del edificio pasando previamente por filtros de alta eficacia (HEPA).
Nivel 4 => este nivel solo se establece en laboratorios de experimentación y no en laboratorios de microbiologia clínica; se necesita este nivel cuando se manejan microorganismos de altísimo riesgo o que son exóticos en ese país, especialmente virus.
Tema 2 - El Control de calidad de un laboratorio microbiologia clínica
El control de calidad sirve para:
- Garantizar la fiabilidad de las técnicas que se realizan en el laboratorio
- Asegurar resultados rápidos y útiles
- Estandarizar las técnicas e interpretar correctamente los resultados
- Controlar la calidad de las muestras, estableciendo una buena comunicación con los clínicos y el personal encargados de obtener muestras
- Aumentar la profesionalidad del personal del laboratorio y la confianza de los clínicos en los resultados que reciben.
Metodos y áreas de control de calidad
1. Control de calidad de las muestras => se debe controlar desde su obtención, transporte y procesamiento hasta la emisión de los resultados siguiendo normas elaboradas con criterios claros de rechazo y establecer horarios fijos de recepción de muestras.
2. Medios de cultivo => deben ser empaquetados correctamente en bolsas cerradas para evitar la desecación, almacenados correctamente y etiquetados con la fecha de caducidad (a 4ºC dura 8-10 semanas; sin empaquetar a 4ºC dura 2 semanas; los caldos y agar en tubo con tapón a 4ºC - 6 meses); los que están preparados en el laboratorio, siguen un control siguiente:
- Control de esterilidad => comprobar con 1 unidad de cada lote (<100) o 3 unidad si es un gran lote mediante incubación a 37ºC durante 24 horas; si se contaminan, debe rechazarse.
- Control de crecimiento => se inocula un medio de cada lote con un inoculo reducido microorganismo control (cepas de colección) que asegure el crecimiento o con un inoculo estándar.
- Control de medios con características selectivas => se inocula con el germen que no debe crecer en ello.
- Control de las características bioquímicas => se utiliza un control positivo que produce la reacción bioquímica esperada.
3. Reactivos de identificación => se deben marcar con la fecha del primer uso y la caducidad.
- Los reactivos de identificación se deben utilizar siempre con un control positivo y negativo.
- No deben utilizarse reactivos caducados o cuyo aspecto no sea el adecuado y debe asegurarse su almacenamiento correcto
- Hay que utilizar siempre el lote o el vial cuya caducidad este mas próxima
4. Cepas control => una colección de cepas de ATCC dispone de prácticamente todos los microorganismo que se utilizan en controles de calidad.
5. Mantenimiento de las cepas control => se mantiene de manera que no pierdan sus características típicas.
6. Control de aparatos => se debe mantener una temperatura ambiente en el laboratorio entre 23-29ºC y la humedad entre 30-50 %; al final de jornada se limpian los superficies con un antiséptico (fenol 5% o glutaraldehido)
- Limpieza => las neveras y congeladores se limpian y se descongelan periódicamente (mínimo 1 vez al año); las cabinas de seguridad, centrifugas, agitadores de tubos se limpian todos los días al acabar el trabajo con antiséptico fenol 5%; las estufas y baños se limpian cada 6 meses.
- Temperatura => un control diario de las estufas, baños, neveras y congeladores antes de empezar el trabajo; se usa un termómetro para cada aparato colocado en el interior del mismo
- Atmósfera de incubación => se controla la cantidad de CO2 de las estufas con un indicador que suele estar acoplado con sistema de alarma; se controla la atmósfera anaerobia mediante catalizadores e indicadores de azul de metileno.
- Cabinas de flujo laminar => un cambio periódico de los filtros y un control de las lamparas ultravioleta.
- Autoclaves => control de esterilizacion (físico del aparato, químico - tiras y biológico - esporas)
- Microscopios => se limpian con suavidad al terminar la jornada, taparlos con su funda; se limpian cada semana los objetivos con alcohol-eter 50%; se realiza periódicamente un ajuste de condensadores y objetivos.
Tema 3 - Técnicas de descontaminación, desinfección y esterilización
En todo laboratorio de microbiologia se debe tener en cuenta:
- todo material para la recogida de muestra debe estar esterilizado
- todo material para la realización de las pruebas debe estar estéril
- antes de cualquier esterilización, el material debe estar limpio y/o desinfectado
- conviene utilizar material desechable
- el material de uso aséptico debe guardarse separadamente del uso séptico
- la limpieza de residuos en el suelo, mesas de trabajo y cualquier superficie se realiza mediante desinfección periódica
- destreza y formación por parte del personal sanitario de laboratorio (deben trabajar en condiciones de total asepsia)
- la manipulación de todo material debe seguir el protocolo de trabajo con medidas cautelares para la prevención de accidentes laborales.
Fases de la manipulación del material del laboratorio
- Material desechable (jeringas, guantes, lancetas) => se utiliza una sola vez y se desecha o se destruye; material punzante o cortante se desecha en recipientes resistentes a la punción; si no es punzante, se auto-clavar y se tirar en contenedores especiales.
- Material reutilizable (de vidrio, de metal, batas, gorro de tela) después de su utilización se limpia, se desinfecta o se esteriliza (según los casos)
- Todo instrumento se limpia inmediatamente después de utilizar (según el protocolo de cada caso), después se desinfecta o se esteriliza directamente para destruir cualquier forma de vida incluidas formas de resistencia o esporas.
- Materiales no esterilizados (pero si se desinfecta - destruir toda forma de vida patógena) que se pueden utilizar => portaobjetos para la tinción, frascos lavadores con agua destilada, frasco de colorantes, etc.
Principios básicos de descontaminación - concepto de limpieza, desinfección y esterilización
- Limpieza => se separa el material entre los de uso aséptico y séptico, se limpia; los instrumentos se limpian primero con agua fría (la sangre se adhieren con calor), después con agua caliente y jabón frotando en los ángulos, se enjuaga y se volverá a aclarar con agua destilada; se seca y se comprueba su estado; se protege si es necesario.
- Desinfección => materiales o superficies inertes (suelo, mesa), se utilizan metodos químicos (detergentes, hipocloritos, etc.); desinfección de manos, piel y mucosas corresponde a técnicas de antisepsia (se aplica tópicamente antisépticos).
- Esterilización => se usa para la reutilización de cualquier material.
Técnicas de descontaminación física
A. Tratamientos térmicos por calor seco y húmedo - consisten en la esterilización o desinfección de los gérmenes por aplicación de calor seco o húmedo.
1. Descontaminación por calor seco (depende de la temperatura, se consigue o no la esterilización)
- Flameado => exponer un objeto a la llama de un mechero durante un tiempo según el material de que se trate (p.ej. la asa de siembra)
- Incineración => se usa un horno crematorio para destruir material desechables (jeringas, catéteres)
- Horno seco => estufas de Pasteur o Poupinel (hornos metálicos de doble pared y bandejas ajustables) mediante resistencias eléctricas, esterilizan durante 2 horas a 180º o 3horas y media a 160ºC; tienen termómetro externo que mide la temperatura en el interior y un selector de temperatura y un reloj;
2. Descontaminación por calor húmedo
- Ebullición => se utiliza poco porque no es fiable; introducir el material en agua hirviendo (100ºC) durante 10 minutos como mínimo; no es un método de esterilización (no destruyen esporas)
- Autoclave => un recipiente cilíndrico que se cierra herméticamente; externamente lleva un manómetro que registra la presión en el interior cuando esta en marcha; presenta una válvula de seguridad que se abrirá espontáneamente cuando la presión interna supere la elegida o resulte peligrosa, una llave de purga que permite la salida de vapor y un reloj que selecciona el tiempo deseado con alarma que indica el final del proceso; interiormente hay una rejilla que se coloca por encima de una resistencia eléctrica cubierta por agua destilada; es muy utilizado y se conseguirá esterilización si sometemos el autoclave a 1 atmósfera durante 20 minutos (120ºC); en el se puede esterilizar => material metálico, cristal, torundas, compresas, paños, batas, plásticos y gomas reutilizables; el inconveniente => con el tiempo los objetos metálicos se oxidan.
Técnica => con autoclave apagado y abierto, añadimos agua destilada hasta la rejilla, sin cubrirla (para que el material que deseamos esterilizar no contacte directamente con el agua); las piezas pequeñas se colocan en cestas/ cajas; se cierra la tapa y se ajusta a presión; se abrirá la llave de purga para que permita la salida de vapor y se ajustara la presión deseada para la esterilización y el tiempo (1 atmósfera - 20 minutos); se pondrá en marcha el aparato y se espera hasta que salga vapor por la llave de purga; se cerrara la llave de purga y la presión comenzara a subir hasta llegar al nivel programado; a partir de aquí comenzara a contar el tiempo de esterilización; una vez realizada la esterilización se apagara el interruptor del autoclave y se esperara a que el manómetro baje a 0; cuando la presión este a 0, abriremos la llave de purga para que salga gran parte del vapor que todavía se encuentra contenido; esto se realizara con cuidado para evitar descompresiones bruscas que podrían originar la apertura de aquellos recipientes tapados con algodón graso; una ves comprobado la salida de vapor, se abre la tapa del autoclave y se extrae el material.
- Tyndalización => método de esterilizaciones consecutivas (repetidas en 3-4 días hasta que se elimine el germen contaminante); se utiliza cuando existe una contaminación de algún material o en el propio autoclave; teóricamente no se deben alcanzar temperatura >100ºC y no se debe abrir el aparato o recipiente que se somete a tyndalización; objetivo => destruir las esporas cuando germinan y evitar contaminaciones por microorganismos resistentes.
- Vapor fluente => utilizar el autoclave siguiendo la técnica habitual, pero la llave de purga abierta, lo que impedirá que se produzca presión y la temperatura nunca sea > 100ºC; es utilizado para materiales o medios que no deban soportar temperaturas >100ºC (p.ej. medios muy azucarados, para evitar su caramelización); es poco usado en microbiologia.
- Uperización => método muy utilizado en la industria alimentaria (tratar el medio a una temperatura de 149-150ºC durante unos instantes (1-5 segundos). No se alteran las propiedades del medio y produce esterilización.
- Pasteurización => no es un método de esterilización y es utilizado en la industria alimentaria (calentar el medio a temperaturas entre 62ºC (15 minutos) y 72ºC (30 minutos); no destruye las formas de resistencia.
Tratamientos a temperatura ambiente
1. Radiaciones ionizantes - las utilizadas en microbiologia son:
- Rayos ultravioletas => para mantener la esterilidad de superficies y recintos; tienen poca penetracion; actúa impidiendo y alterando la duplicación del ADN celular; se debe evitar su presencia en la piel;
- Rayos gamma => para conseguir esterilización en frió, producidos por isotopos radiactivos; presentan un poder de penetración muy alto, constituyendo el método de esterilización mas utilizado a nivel industrial (materiales de uso único o desechable p.ej. guantes, jeringas, catéteres, prótesis, válvulas y que pudiera alterarse por calor)
2. Sistemas de filtración (filtrar a las estructuras que sobrepasen un determinado tamaño, según el tipo de filtro; la efectividad del filtro es proporcional al tamaño del poro, pudiendo conseguirse esterilización); presencia de presión, vació y la carga del filtro (+); las bacterias en medios neutros son (-).
- Filtros de membrana => filtros de celulosa muy purificada y con un tamaño de poro fino o muy fino; existe desde sistemas sencillos hasta sistemas de piezas desmontables que llevan acoplada una bomba de vació para ejercer succión sobre el medio a filtrar.
- Filtros de vidrio poroso o de fibra de vidrio => se utilizan en casos específicos y tienen mas resistencia que los anteriores.
- Filtros de Chamberland => son de porcelana porosa, mas caros que los anteriores y menos utilizados.
- Filtros de flujo laminar => dispositivos de filtrado donde entra aire contaminado y sale estéril; utilizados como mecanismo de esterilización en campanas de flujo laminar, en quirófanos y recinto que pretende crear o mantener un ambiente estéril; flujo => vertical u horizontal.
- Ultrasonidos => introducir el material en tanques de distintos tamaños con liquido desinfectante; una vez puesto en marcha el dispositivo, comienza a vibrar a gran velocidad originando pequeñísimas burbujas que entran en todos los recodos del material consiguiendo eliminar los microorganismos; es poco utilizado, caro y poco practico.
Técnicas de descontaminación química
1. Metodos químicos de desinfección (desinfectantes que se aplica sobre objetos y superficies y antisépticos que se aplica sobre la piel y mucosas); condiciones que cumplir en un buen método de desinfección:
- matar el mayor numero de gérmenes o al menos todos los patógenos
- ser económico
- no ser corrosivo, toxico ni irritante para los tejidos
- se deberá diluir al menos en agua
- tener un olor agradable
Los mas utilizados:
- Detergentes catiónicos => diluidos al 1% para desinfección de manos; mas frecuente para limpieza y desinfección de paredes, suelos, ropa y objetos (sin diluir)
- Clorofenoles => muy eficaces y se asocian con los detergentes catiónicos para mejorar el grado de desinfección.
- Compuestos clorados => para desinfección de superficies, ropas, urinarios; se suelen usar diluidos en agua (lejias /hipocloritos)
- Acido fenico => diluido al 5% para la limpiar objetos y superficies.
-Amoniaco
Los antisépticos mas utilizados:
- Alcoholes => limpiar y desinfectar la piel, las manos (etanol), el filo de instrumental y superficies pequeñas (metanol) que no tiene contacto con la piel (p.ej. alcohol isopropilico 70%)
- Mercurio-cromo => contiene mercurio y un buen desinfectante para heridas superficiales (las mantiene secas y protegidas)
- Derivados yodados => para preparar la piel antes de una intervención quirúrgica, en la punción lumbar, antes de punción para hemo-cultivo, etc.; son efectivos y ejercen su acción por oxidación (p.ej. betadine, ibetane)
Metodos químicos de esterilización - los mas empleados son "Oxido de etileno" => en forma de gas (10ºC) mezclado con CO2, ya que puro es muy oxidante y podría explosionar al mezclarse con O2; presenta un gran poder de penetración y es muy efectivo y duradero; la esterilización se produce a => temperaturas bajas (40ºC) con humedad relativa alta (40-60%) durante un tiempo de 3-8 horas (media de 5); se requiere cámaras o instalaciones especificas para ello, son muy caras; el oxido de etileno se aplica a cualquier material sensible al calor y que no pueda esterilizarse por otros metodos (p.ej. endoscopia, plásticos termo-lábiles, cauchos, material eléctrico); el material esta listo para ser utilizado a las 48 horas después de la esterilización; deberá conservarse estéril en el interior de una bolsa de plástico cerrada por procedimientos termoeléctricos y dura 6 meses.
Control de esterilización - permiten comprobar la eficacia del proceso de esterilización
1. controles de esterilizacion de tipo físico => incluidos en el aparato de esterilizacion (manómetros - miden presión; vacuo-metros - miden el vació en el interior; termómetros, gráficos que registran los valores parámetros mas significativos del proceso: temperatura, humedad, presión, vació, tiempo etc.)
2. controles de tipo químico - comercializados en forma de cinta adhesiva, como indicadores del proceso de esterilizacion (por encima de la temperatura determinada cambian de color), fundamentalmente para el control térmico.
3. sistemas de tipo biológico - comercializados en forma de capsulas cerradas en cuyo interior hay esporas de resistencia a la esterilizacion conocida; dichas ampollas, tras haber sido sometidas a condiciones de esterilizacion, se incuban a 56ºC (Bacillus strearat-haemophilus) o a 40ºC (Bacillus subtilis); a cabo de 24-48 horas, se procede a su lectura donde la germinación y cambio de color indicara si se han producido condiciones de esterilizacion.
Tema 4 - Toma de muestras (recogida, manejo y tratamiento)
Selección de la muestra para tener significación diagnostica - representativa del proceso patológico y cantidad suficiente (p.ej. no es relevante un esputo poco purulento y contaminado por saliva); recipiente estéril adecuado (para un pus de un absceso => anaerobio, estériles);
Procedimiento para la toma de muestras:
- La toma de muestras debe realizarse antes de iniciar el tratamiento ATB (al menos informar al laboratorio de ATB que esta recibiendo)
- Es muy importante seguir las normas necesarias para evitar la contaminación externa de las muestras (descontaminar la piel, evitar áreas con flora normal, medio de cultivo específicos para el patógeno sospechoso)
- La extracción o recogida de las muestras se debe realizarse en el estado adecuado de la enfermedad (durante la fase aguda o diarreica)
- La cantidad recogida debe ser suficiente y es fundamental que se utilice un recipiente estéril y que se envié a laboratorio lo mas pronto posible.
Extracción de sangre para hemocultivos (septicemia)
La técnica de extracción (se hace en un pico febril > 38,5ºC /antes de la toma de la siguiente dosis de ATB) => smarch en el antebrazo, escoger la vena antes de la desinfección (alcohol 70º o clorhexidina alcohólica un área de 5cm - frotando rigurosamente), yodo-povidona 2% desde el centro hacia afuera en el circulo, dejar secar 1 minuto, ponerse guantes estériles, realiza la extracción , cambiar la aguja antes de inyectar la sangre en las botellas de cultivo, desinfectar otra vez la piel con alcohol (sensibilidad al yodo), remitir las botellas de hemocultivos inoculadas inmediatamente; se recomienda 3 muestras de 10 ml (cada extracción para 2 botellas (aerobios y anaerobios) en 24 horas con intervalo de >1 hora (al menos 2-3 extracciones separadas 30 minutes en 24 horas) en sitios diferentes para dilucidar un posible contaminante de la piel; en niños es suficiente extraer 1-5 ml máximo cada extracción; pacientes con tubuladora intravenosa/ catéter, se toma en la vía mas abajo; se extrae lo mas limpio posible para no incluir bacterias saprofitas de la piel; los frascos se marcan con etiqueta del paciente, numero de cama y hora de extracción.
Recogida de LCR (el procesamiento inmediato/ urgente) => se recoge insertando un agua, de forma aséptica, en el espacio sub-aracnoideo a nivel lumbar, se recoge en 3-4 tubos estériles con tapa de rosca (tubo 3º o 4º => recuento celular, 1º y 2º => microbiológicos y bioquímicos; si solo se llena 1 tubo => microbiologia retirara de forma aséptica la cantidad necesaria, el resto => citológicos y bioquímicos; el volumen de muestra es importante (10 ml) para la detección (p.ej.M.tuberculosis y C.neoformans); no se deben refrigerar (temperatura ambiente o estufa a 37º) excepto para estudios virales se pueden refrigerarse hasta 24 horas o congelarse a -70ºC si hay una mayor demora; la muestra bacteriana => turbio (meningococo dentro de leucocitos), virales => transparente;
Recogida de otros líquidos estériles - la aspiración percutánea de liquido sinovial, pleural, pericárdico y peritoneal se hace de forma aséptica y se inyecta inmediatamente en un frasco o tubo esterilizadas (transporte anaerobio), antes, se expulsar las burbujas de aire de la jeringa; se puede añadir una pequeña cantidad de heparina para evitar la coagulacion.
Recogida de muestras del tracto respiratorio superior:
- Exudado faríngeo => se realiza mediante una torunda de algodón, dacrón o alginato de calcio frotando vigorosamente ambas áreas amigdalinas, la faringe posterior y las zonas de inflamación, ulceración, exudación o formación de capsulas; la lengua se oprime con un depresor para reducir al mínimo la contaminación del hisopo con secreciones bucales.
- Exudado nasal => se realiza introduciendo un hisopo profundamente en cada fosa nasal y rotando suavemente.
Tractor respiratorio inferior - el esputo es una muestra menos relevante por la posibilidad de la contaminación por saliva; una buena muestra => instruir debidamente al paciente para lograr una expectoración profunda (ayudarle con fisioterapia respiratoria/ clapping, hidratación o nebulización); pacientes con traquestomías => se recoge aspirando (en un frasco de Lukens); las secreciones bronquiales se recoge mediante broncoscopio, instilando una pequeña cantidad de SF estéril en el árbol bronquial (también puede estar contaminado por flora del tracto superior, aunque es mas relevante que esputo); una muestra mas profunda se recoge mediante broncoscopio con lavado bronco-alveolar (BAL) para buscar Pneumocistis carinii y hongos; cepillado bronquial es una técnica mas agresiva en caso de neumonías por aspiración; muestras de bacterias anaerobias se recoge por una punción transtorácica, biopsia transbronquial y pulmonar abierta.
Recogida de heces (se procesa lo antes posible):
- Toma de muestras para coprocultivo - se recoge con un escobillón que se introduce en un tubo estéril preparado con un medio de transporte adecuado (Cary y Blair) (tubo con una cuchara y liquido rojo/transparente; también se puede utilizar frasco de orina estéril; medio Cary y Blalir mantiene la viabilidad de los patógenos intestinales); basta con impregnar la torunda en las heces en la parte donde se observa sangre, moco o pus;
- Muestras para estudio parasitológico - se recoge durante 3 días consecutivos, se guardan en la nevera en un recipientes cerrados para evitar la desecación (temperatura 3-5ºC); los huevos, las larvas y los quistes de protozoos permanecen viables varios días; la cantidad de muestra es pequeña (1 cucharilla de café en un frasco con alcohol polivinilico /PVA 1:3); para investigar oxiuros (parásitos) se utiliza preparación con cita de celofán; se proporcionan al paciente 6 portaobjetos (se toma durante 6 días consecutivos) con cinta adhesiva transparente; se toma la muestra a primera hora de la mañana antes de lavarse; se aplica la cinta sobre los margenes del ano con una suave presión, se retira y se coloca de en el porta;
Recogida de orina - el frasco estéril no debe abrirse antes de la recogida; las partes genitales se lava solo con agua; se recoge a primera hora de mañana para estudio microbiológico, de forma aséptica, se echa el primer chorro, se recoge la segunda mitad unos 20-30 ml.
Sondaje vesical (puncion de sonda) y puncion suprapubica - se realiza por el personal de enfermeria
Recogida de muestra de tracto genital - se utiliza un tubo con escobillón de algodón como medio de transporte; exudado uretral => el hisopo se introduce 2 cm dentro de la uretra y se rota suavemente antes de retirarlo (muestras separadas para el cultivo de gonococos y clamidias o ureaplasmas => se utiliza 2 escobillones, 1º para estudio de gonococos 2º para clamidias o ureaplasmas); exudado cervical => se inserta un hisopo especial (como uretral) en el canal cervical y rotando-lo y moviendo-lo durante 30" antes de retirar; exudado vaginal => el hisopo se sumerge en el fornix posterior de la vagina; para aislamiento de gonococos pueden ser transportados en el medio de Stuart modificado o en el medio de Amies con carbón en temperatura ambiente, hasta su inoculación; para aislamiento de clamidias y micoplasmas, el medio es tampon con sacarosa y ATB; se puede refrigerar si hay demora en el proceso.
Procedimiento para muestras en anaerobiosis - se obtiene mejor con una jeringa y aguja, a los que debe expulsarse todo el aire.
Transporte de muestras:
- Metodos convencionales => el mas utilizado es hisopos en tubos de plástico que llevan incorporados diversos medios de transporte que consiste en un agar semi-solido, pH regulado, carece de nutrientes, pero contiene tioglicolato de sodio como reductor, para prolongar la viabilidad de los microorganismos cuando exista demora entre la recogida y su cultivo; los mas utilizados => (1) Medio de Stuart (los exudados faríngeos, conjuntivales, nasales y heridas) que mantiene un pH favorable e impide la deshidratación de las secreciones durante el transporte y la oxidación y autodestrucción enzimática de los patógenos presentes (2) Medio de Cary y Blair (muestras fecales) donde las salmonellas y las shigelas pueden recuperarse hasta 49 días después de la toma de muestras y Vibrio cholerae hasta 22 días después.
- Transporte de muestras para estudio en anaerobiosis => cuando la muestra se va a procesar dentro de 30 minutos, puede servir como transporte una jeringa con una aguja insertada en un tapón de goma; si la demora va a ser mayor, se usa un tubo /frasco ampolla lleno de CO2 y libre de O2 con N2/ H2 con indicador en agar o caldo; la muestra liquido se inyecta a traves del tapón de goma después de expulsar el aire de la jeringa y aguja; existe también un hisopo en un tubo anaerobiosis
Envió de muestras (las medidas especiales para un envió por correo a un laboratorio de referencia):
- Muestras que contengan virus deben ser refrigeradas inmediatamente y enviarse en una caja con unidades comerciales refrigerantes
- La sangre no se envía entera, se separa el suero y se envía en un tubo estéril
- La muestra <de 50 ml debe ser envasado en un recipiente hermético irrompible con espacio suficiente entre ambos para retener en caso de rotura; el envase se coloca dentro de otro envase para el envió; el envase externo se identifica con un rotulo rojo y blanco para Agentes biológicos /Material bio-medico.
Manejo inicial de las muestras en el laboratorio - la mayor parte de las muestras para estudio bacteriológico que vayan a demorarse en su procesamiento deben mantenerse en la nevera a excepción de LCR; los fragmentos de pelos o raspados de piel y uñas para el aislamiento de hongos pueden ser mantenidos a temperatura ambiente durante varios días antes de ser inoculados (protegidos del polvo).
Tema 5 - Procesamiento de las muestras en microbiologia clínica
(protocolos de siembra)
Normas básicas generales (antes de proceder al procesamiento de la muestra):
1. Volante de petición debe estar bien cumplimentada (filiación y datos administrativos del paciente, datos clínicos, datos de la muestra, terapéutica seguida, determinación solicitada)
2. Tener constancia de que la obtención de la muestra ha sido realizada correctamente, siguiendo las normas y criterios establecidos por el laboratorio, así como su recogida, transporte y conservación.
3. La siembra de dicha muestra se hará en los medios idóneos para cada caso, bien en placa, por agotamiento y/o método cuantitativo, o bien en tubo.
Procesamiento de las muestras
1. Orinas (debe llegar al laboratorio en contenedor estéril y ha de conservarse a 4ºC en menos de 24 horas)
[a] Agar sangre, chocolate o Cled/Cystine-Lactose-Electrolyte-Deficient (medios general y especifico para orinas) => se siembra en 3 direcciones/ cubrir totalmente la superficie (cuantitativa en Cled o AS - para contar colonias; realizar antibiograma); crecerán todo tipo de germenes: cocos Gram+, bacilos Gram-, levaduras; en Cled/AS no crecen cocos Gram- (Neisseria, Moraxella, Chlamydia); en AS se comprueba las características hemolíticas o no de las bacterias e.j. Stafilococcus aureus (B hemolítico) y en Cled, las característica lactosa (+) => amarillas o lactosa (-) sin cambio de color => azul verdosas.
[b] Agar Mac Conkey (selectivo para bacilos Gram-) => se siembra por agotamiento en cuadrantes (puede ponerse un disco de Colistina en el inoculo para ayudar a la identificación de E.coli (sensible a colistina - común en orinas); crecen bacilos Gram- => Enterobacterias y también Pseudomonas; observaremos las características de lactosa (+) => colonias rojas y lactosa (-) sin cambio de color => rosa.
[c] Agar Citrato de Simmons (solo en algunos protocolos); se siembra en la lengüeta del tubo preparado en pico de flauta; las colonias consumidoras de citrato (+) => vira a azul y las que no, permanece verde; se usa para la diferenciación de Enterobacterias (para diferenciar entre coliformes y coliformesfecales. Los coliformes fecales no fueron capaces de utilizar el citrato como fuente de carbono ni a las sales de amonio como fuente de nitrógeno. Los coliformes no fecales como Enterobacter aerogenes o Salmonella enteritidis podían utilizar el citrato en este medio dando una reacción alcalina) en base a su capacidad de utilizar el citrato (mediante citrato permeasa)
Los gérmenes mas frecuentes que podemos encontrar (en orina se identifican especies):
- E. coli (el mas frecuente) => bacilo Gram-, móvil, sensible a Colistina, lactosa (+), indol (+)
- Streptococcus faecalis => coco Gram+, catalasa (-), oxidasa (-).
- Proteus spp (todas) => bacilo móvil Gram-, resistente a Colistina, lactosa (-), oxidasa (-), Triptófano Desaminasa/TDA (+), ureasa (+) tardío.
- Stafilococcus aureus => coco Gram+, catalasa (+), coagulasa (+), B hemolítico, oxidasa(-).
- Candidas spp (todas) => morfología de levaduras (parece como hematíes)
- Klebsiella spp => bacilo Gram-, inmóvil, sensible a Colistina, ureasa (+), colonias mucosas, lactosa (+), tardío.
- Pseudomonas spp => bacilo Gram-, móvil, sensible a Colistina, lactosa (-), oxidasa (+)
2. Coprocultivos (contenedor especifico para coprocultivo "Cary y Blair" / bote de orina; conservada a 4ºC, procurar procesarla en <24H; se siembran por agotamiento en cuadrantes).
[a] Hecktoen o SS => medios selectivos y diferenciales donde crecerán el genero Salmonella y Shigella; en Hecktoen las Salmonellas spp => colonias lactosas (-), verdosas y pueden ser SH2/sulfihidrogeno/ acido sulfidrico (+) con fondo negro, son bacilos móviles, sensible a Colistina; las Shigellas spp => lactosas (-) , SH2 (-), bacilos inmóviles en fresco y sensibles a Colistina; las colonias lactosas (+) en este medio serán amarillas;
en SS las Salmonellas y Shigella serán el del medio (caramelo) y también con el fondo negro (Salmonellas SH+ y lactosa- ); colonias lactosa (+) => rojizas; las colonias lactosas+ no son patógenas (coliformes fecales) y no se investigan.
[b] Agar Yersinia CIN => para buscar colonias de Yersinia spp (rosa clarito - Yersinia pestis, Yersinia enterocolitica y Yersinia pseudotuberculosis.) que aparece como lactosa (+), sensible a Colistina y bacilos Gram- e móviles, fermentador de manitol. La inhibición selectiva de organismos gram negativos y gram positivos se obtiene mediante cristal violeta (inhibidor de Gram+), desoxicolato sódico (inhibidor de Gam+) y los agentes antimicrobianos: cefsulodina, Irgasan (Triclosan) y novobiocina (inhibidor de S.epidermidis).
[c] Agar Campylosel => crecerá Campylobacter spp (bacilos Gram- con flagelos) como colonias pequeñas translucidas, sensibles a Nalidixico (especies C. coli y C.jejuni) resistente a Nalidixico el C. fetus, en fresco aparecen en coma/en S, ureasa (+) oxidasa (+) catalasa (+); al hacer la prueba del hipurato C.jejuni seran (+) y C.coli (-); P. hipurato => un procedimiento cualitativo para determinar la capacidad de las bacterias de hidrolizar enzimáticamente (hipuricasa) el hipurato sódico que da lugar a acido benzoico y glicina un compuesto de color morado.
[d] Caldo Selenito => caldo enriquecido para los géneros Salmonella y Shigella. el selenito de sodio inhibe la flora Gram+ y la mayoría de la flora entérica excepto Salmonella spp.
[e] Agar McConkey (solo en algunos protocolos) => los coliformes aparecerán como colonias rojas por ser lactosas (+); no es necesario???
[f] Agar TCBS /tiosulfato citrato bilis sacarosa (detectar Vibrio cholerae) => aparecen colonias de color amarillo sacarosa (+), oxidasa (+) y son bacilos Gram- pleomórficos; el extracto de levadura y la peptona proporcionan el nitrógeno y las vitaminas. El citrato sódico, el tiosulfato sódico, la bilis de buey y un pH alcalino fuerte inhiben los organismos Gram+ y suprimir los coliformes (inhibidor para la mayoría de las entero-bacterias), favoreciendo el crecimiento de Vibrio cholerae porque este organismo es sensible a los entornos ácidos. La alta concentración de sodio favorece el crecimiento de Vibrio cholerae que es halotolerante (tolera el medio salado) y de otras especies de Vibrio, cuya mayoría es halofílica. La sacarosa (+) es un carbohidrato fermentable, y el cloruro sódico estimula el crecimiento. El tiosulfato sódico es una fuente de azufre y actúa con el citrato férrico como indicador para detectar la producción de ácido sulfhídrico/SH2. El azul de bromotimol y el azul de timol son indicadores de pH. En Mc, Vibrio Cholerae es lactosa (-).
3. Exudados vaginal y uretral (la muestra llegara en uno o varios escobillones; se siembra por agotamiento en cuadrantes).
[a] Agar Sangre (medio general) => buscamos Streptococcus B hemoliticos del grupo B (S.agalactiae), que aparecerán como colonias pequeñas translucidas con un halo de B hemólisis alrededor de la colonia; son cocos Gram+, catalasa y oxidasa (-), anaerobio facultativo, prueba de látex (+).
[b] Agar chocolate => buscamos Haemophilus spp como colonias muy pequeñas grisáceas que crecen bien por ser gérmenes exigentes en su crecimiento que requieren factor X y/o V (proceden de la degradación de la Hb); también podemos colocar discos de factor X y/o V y mirar el satelitismo; al fresco como coco-bacilos inmóviles, Gram-; oxidasa y catalasa variable.
[c] Agar Thayer Martin o New York => buscamos N.gonorrhoeae o N.meningitis que aparecerán como colonias de color gris; son diplococos Gram-, catalasa (+), oxidasa (+) que fermentan la glucosa pero no el resto de los azucares.
[d] Agar Gardnerella => buscamos Gardnerella vaginalis, como colonias B-hemolíticas y al fresco como bacilo pequeño, Gram variable, anaerobio facultativo, oxidasa (-) y catalasa (-). La presencia de sangre humana favorece el crecimiento de las especies estudiadas, ya que producen ß-hemólisis alrededor de las colonias. La ß-hemólisis en agar con sangre humana es altamente indicativa de presencia de G.vaginalis. Los antibióticos incluidos en el medio inhiben la mayoría de los contaminantes Gram- y de las levaduras.
[e] Vagicult o Roiron (medio liquido) => crecen levaduras (Candidas spp) y Trichomonas (protozoo unicelular flagelado).
[f] Agar Sabouraud (se puede incluir para detectar Candidas spp)
[g] Medio de detección de Micoplasmas y Chlamydias
4. Semen - la muestra llegara en contenedor estéril/ bote de orina; se siembra por agotamiento en cuadrante en medios: Cled, McConkey , Agar Sangre, Agar chocolate, Thayer Martin o New York, Roiron, y cultivo de Clamydias, buscando en cada caso los mismos gérmenes que en el caso del exudado vaginal.
5. Esputo - la muestra ha de llegar en contenedor esteril y conservarse menos de 24H a 4ºC; antes de sembrar se observa por el microscopio si la muestra es valida/ no esta contaminada por saliva; se siembra por agotamiento en cuadrantes; solo se siembra cuando en el Gram, el cociente leucocitos/ celulas epiteliales sea > 2,5 (recuento en fresco/al microscopio); si es < a 1,5 es dudoso. Cuando sean muestras de UCI o provenientes de neumonías se siembran siempre.
[a] Agar Sangre => buscamos colonias de Streptococcus pneumoniae o Branhamella catharralis; S.pneumoniae >> colonias verdosas (alfa hemólisis) y al fresco como coco Gram+, catalasa (-), sensible a la Optoquina; Branhamella catarralis >> colonias blanco-grisáceas y al fresco como cocos Gram-, oxidasa (+), catalasa (+) que no utiliza ningún azucar (no es fermentadora), pero reduce los nitratos a nitritos/ nitratasa+ (lo que le diferencia del genero Neisseria que ademas es fermentadora de glucosa y maltosa).
[b] Agar chocolate => buscamos Haemophilus spp como colonias puntiformes translucidas, que al fresco como coco-bacilos, Gram-, catalasa y oxidasa variable; agar chocolate polyvitex (contiene factor V/ NAD y factor X /hemina procedente de la degradación de Hb)
[c] Agar McConkey => donde creceran Enterobacterias y otros bacilos Gram-.
[d] Medio de Lowestein-Jensen (o Coletsos) => para rescatar Mycobacterium tuberculosis, bacilos acido alcohol resistente (Zhiel Neelsen+) de crecimiento muy lento; los niveles bajos de la penicilina y el ácido nalidíxico también están presentes en el medio de LJ para inhibir el crecimiento de lo Gram+ y Gram-, con el fin de limitar el crecimiento de especies de micobacterias solamente. Presencia de verde malaquita en el medio inhibe las floras mayoría acompañante; que se desinfecta y se solidifica mediante un proceso de espesamiento; el Glicerol mejora el crecimiento de Mycobacterium tuberculosis.
[e] Medio Legionella => muestras de UCI; la Legionella pneumophila es bacilo Gram- (en realidad, se tiñe muy mal, aerobio exigente, movil; en general, no fermenta ni oxida los azucares, sino que utiliza los aminoacidos; es hipurato+ => un procedimiento cualitativo para determinar la capacidad de las bacterias de hidrolizar enzimáticamente (hipuricasa) el hipurato sódico; necesita L-cisteina para crecer y también iones férricos Fe. La inhibición del crecimiento de las bacterias Gram+, la mayoría de las bacterias Gram-, levaduras y mohos, a través de una combinación optimizada de 3 antibióticos. Las colonias que crecen en medio Agar Legionella y no crecen en medio AS deben considerarse, con alta probabilidad, colonias de Legionella.
6. Cepillado bronquial (la muestra vendrá en el cepillo y se conservara a 4ºC < de 24H); se siembra en los mismos medios que en el caso anterior (esputo) añadiendo ademas: agar sangre anaerobios (ASA) o medio AKV (agar sangre kanamicina-vancomicina), selectivo para bacilos Gram- anaerobios y Bacteroides (bacilo Gram-, anaerobio estricto).
7. Exudado faringeo y oral (la muestra viene en torunda, se sembrara por agotamiento en cuadrante).
[a] Agar sangre => crecera todo tipo de gérmenes (medio general enriquecido)
[b] Agar chocolate => crecera todo tipo de gérmenes
[c] Agar Mac Conkey => creceran las Enterobacterias y otros bacilos Gram- poco exigentes.
[d] Agar CNA /agar sangre (de cordero) colistina nalidixico, medio selectivo para Gram+/ inhibe los Gram- => para deteccion de Streptococcus B-hemoliticos, Enterococcus y Staphylococcus??
[e] Agar Sabouraud (solo en orales) => deteccion de Candidas spp.
8. Exudados varios - abscesos heridas ... (se sembrara por agotamiento en cuadrantes. La muestra ha de llegar en tubo estéril y se conservara a 4ºC menos de 24H.
[a] Agar sangre => crecerá todo tipo de gérmenes
[b] Agar chocolate => idem
[c] Agar Mac Conkey => crecerán las Entero-bacterias y otros bacilos Gram (-) poco exigentes.
[d] Agar CNA /agar sangre (de cordero) colistina nalidixico, medio selectivo para Gram+/ inhibidor Gram- => crecerán bien los Steptococcus B-hemolíticos.
[e] Agar ANA (agar sangre anaerobios/ASA, aunque también puede utilizarse agar AKV, agar sangre kanamicina y vancomicina) => medios selectivos para bacilos Gram- anaerobios (estrictos) y Bacteroides.
[f] Caldo Tioglicolato => crecen bien todo tipo de bacterias aerobias o anaerobias; permite el desarrollo de una amplia variedad de microorganismos, incluidos los nutricional-mente exigentes. Además, se observa que las bacterias estrictamente aerobias, crecen en la parte superior, mientras que las anaerobias facultativas o anaerobias estrictas crecen en las profundidades del medio.
RELACION DE LAS BACTERIAS CON EL OXIGENO EN TIOGLICOLATO En base a la relación de las bacterias con el oxígeno, estas se pueden clasificar en :
1. Aerobio estricto: Un organismo el cual requiere utilizar el oxígeno como aceptador terminal de electrones , puede tolerar un nivel del oxígeno equivalente o mayor de una atmósfera de aire (oxígeno del 21%), y tiene un tipo terminantemente respiratorio de metabolismo (Mycobacterium tuberculosis, Bacillus).
2. Anaerobio o Aerobio facultativo: Un organismo que puede crecer bien en ausencia del oxígeno y en la presencia de un nivel de oxígeno equivalente a una atmósfera del aire (oxígeno de 21%) => Enterobacterias, Vibrio spp, Haemophilus spp..
3. Microaerofílico (anaerobio aerotolerante): Un organismo que es capaz de un crecimiento oxígeno-dependiente, pero no puede crecer en la presencia de un nivel del oxígeno equivalente a una atmósfera de aire (oxígeno de <21%) => Campylobacter fetus, Pseudomonas y Neisseria.
4. Anaerobio estricto: Un organismo que es incapaz de crecimiento oxígeno-dependiente y no puede crecer en la presencia de una concentración de oxígeno equivalente a una atmósfera de aire (oxígeno de 21% - nada de O2). (Clostridium botulinum).
5. Anaerobios aero-tolerantes: Pueden crecer con o sin oxígeno pero su metabolismo es siempre fermentativo (Lactobacillus)
9. Liquido cefalorraquídeo - se siembra por agotamiento en cuadrante del sedimento del tubo centrifugado a 1500 rpm a 3000 rpm durante 20 minutos, si en el tubo hay mas de 1 ml de muestra. Sino, vortear el tubo. La muestra se ha de procesar de inmediato y si no es posible, conservarse a 37ºC.
[a] Agar sangre => buscamos Neisseria meningitidis, como pequeñas colonias no hemolíticas y al fresco se ve como diplococos, Gram-, oxidasa (+), catalasa (+), fermentador de glucosa y maltosa (la fermentación de este azucar le diferencia del gonococo; también puede crecer Streptococcus pneumoniae (neumococo) que aparecen como colonias verdosas (Alfa hemolisis) y al fresco como cocos Gram+, catalasa (-), sensible a la optoquina.
[b] Agar chocolate => ídem y ademas pueden crecer Haemophilus spp como colonias puntiformes translucidas, que al fresco aparecerá, como coco-bacilos, Gram-, catalasa y oxidasa variable.
[c] Agar Thayer-Martin => medio selectivo para Neisserias, crecerán bien los meningococos /N.meningitidis.
[d] Medio tioglicolato (caldo) => medios para anaerobios y aerobios.
(f) Ademas se hará una extensión para Gram.
10. Otros líquidos estériles (sinovial, pleural, pericardio...) - se siembran por agotamiento; la muestra ha de llegar en tubo estéril y su conservación no se ha de demorar mas de 24H a 4ºC.
[a] Agar sangre => crecerán casi todo tipo de microorganismos, con características hemolíticas de algunos de ellos.
[b] Agar chocolate => crecerán casi todo tipo de gérmenes, sobre todo exigentes.
[c] Agar McConkey => crecerán Enterobacterias y otros bacilos Gram- poco exigentes.
[d] Agar CNA => agar columbia colistina nalidixico (sangre de cordero), selectivo para Gram (+)
[e] Agar ASA => agar sangre anaerobios selectivo para bacilos Gram- anaerobios y Bacteroides.
11. Cateteres y sondas - se siembra mediante la técnica de Maki (rodamiento del cateter)
[a] Agar chocolate => crecerán casi todo tipo de gérmenes, y podrán crecer bien algunos exigentes como el Haemophillus.
[b] Agar sangre => crecerán bien casi todo tipo de gérmenes y podrá verse sus características hemolíticas si las tuvieran.
[c] Caldo tioglicolato => si se observa crecimiento se hará un pase por Agar chocolate.
[d] También puede ponerse en una placa de agar MacConkey.
12. Hemocultivos - la muestra se introduce en el vial de hemocultivos, conservando a 37ºC en el Bactec (detecta CO2) hasta su identificación.
Medios de cultivo - compuesto por distintos nutrientes requeridos para cultivar gérmenes como las bacterias, hongos y parásitos según sus necesidades nutricionales de cada uno; en función de sus requerimientos, existen grandes diferencias entre los medios de cultivo que nos sirven para diferenciar cada tipo de microorganismo que podrá crecer en unos medios de cultivo y no en otros.
Función de medios cultivo:
- separar y aislar distintas especies microbiales presentes en una muestra.
- paso previo para el estudio de identificación de un microorganismo problema.
- conocer el metabolismo en función del nutriente o sustrato que utiliza (lactosa) o metabolito que produce (indol).
- estudios macroscópicos => visualizar las características de las colonias en medios sólidos.
- realizar antibiogramas determinando la sensibilidad (mayor/menor) de la bacteria problema a distintos antibióticos.
- pruebas de CMI (concentración minima inhibitoria)
- conservar las especies microbiales o muestras.
Requerimientos energéticos y no energéticos de los medios de cultivo - fuente de energia (fuente de carbono y de nitrogeno) y fuente no energética (azufre, fósforo, iones metálicos, factores de crecimiento, f. de arranque y inhibidores) necesarios para el desarrollo (crecimiento) de cultivos microbiales; fuente de carbono => acido acetico, alcohol, citrato sódico, azucares (mono o disacáridos incluso almidón => glucosa, lactosa, maltosa), CO2 (bacterias fotosintetizantes y quimiolitotrofas); conocer el tipo de azucar utilizado => útil para su identificación bioquímica y clasificación taxonómica; fuente de nitrógeno (menos energética) => proteínas completas (gelatina - determinar actividad proteolítica/gelatinasa; extractos de carne y sales de amonio), péptidos/polipeptidos (peptonas - extractos de levadura, caseína - trípsica de caseína/triptófano => formación de indol) o aminoácidos y otros => nitratos, nitrogeno organico, amoniaco, sales de amonio, aminoacidos; conocer la fuente nitrogenada => util para clasificación taxonómica; fuente de azufre => sulfatos, tiosulfatos, aminoacidos (metionina, cisteina, tiamina); fuente de fosforo => fosfatos; iones metalico => hierro, potasio, sodio, magnesio y en concentraciones mas bajas => cinc, manganeso, cobre, cobalto, etc;
Otros requerimientos no energéticos:
Factores de crecimiento => componentes que muchas bacterias no son capaces de fabricar por si solas para su crecimiento (aminoácidos => cisteina; factor X y factor V procedente de la degradación Hb; vitaminas, bases puricas y pirimidicas); factores de arranque => sustancias que permite a la bacteria salir de su fase de latencia y comenzar su fase de crecimiento exponencial (fuentes de energía => glucosa; iones metálicos que estimula el crecimiento); factores inhibidores => componentes que bloquar el proceso metabólicos de algun microbio; muy útiles para la identificación y tipificación bioquímica de las bacterias
(azida sodica => impide Gram-; antibióticos => inhibidores y destructores; colorantes la eosina azul de metileno utilizado por medio Levine; cristal violeta en medio Mac-Conkey => impide Gram+).
Condiciones que ha de cumplir un medio de cultivo:
1. Una composición de nutrientes adecuada (requerimientos energéticos y no energéticos)
2. Condiciones físico-químicas apropiadas:
- Temperatura optima/ideal (según la especie microbiana => psicrófilas <20ºC; mesófilas 18-45ºC; termófilas > 45ºC; las bacterias patógenas del hombre 35-37ºC; fuera de estas no crecen o crecen mucho mas despacio;) e.j.: Yersinia 22ºC, Campylobacter 45ºC (los dos son gastrointestinales)
- Grado de humedad (cantidad de agua que necesita para crecer)
- pH adecuado es en general cercano a la neutralidad +/- 7(estabilizante de pH => buffers o tampones que facilitan el crecimiento); pH acido => Tiobacilos (cerca a 0); pH alcalino => bacilos ureasa positivo/ Proteus (en torno a 8) y Vibrio cholerae (pH 9)
- Presión osmótica en general isotónia (300 miliosmoles)
- Presencia o ausencia de oxigeno; la mayoría de las bacterias aerobias y anaerobias son facultativos que se desarollan bien con y sin O2; existen pocos anaerobios estrictos; bacterias microaerofílica => produce mas CO2.
Principales tipos de medios de cultivo
- según su proporción de agua / su consistencia (sólidos, líquidos, caldo)
- según su uso / su utilización (para aislamiento, crecimiento en general /recuento, identificacion, mantenimiento de cepas, para antibiogramas)
- según su origen del que proceden (naturales, sintéticos y semi-sintéticos, complejos)
- según su presentación (deshidratados o liofilizados, sólidos en placa petri, sólidos en tubo, líquidos en tubo, semi-sólidos en tubo, doble fase en frasco o tubo).
Medios de cultivo según su proporción en agua:
- Medios sólidos > 15% de agar; para aislamiento, identificación, elaboración de antibiogramas) =>1881 Koch utiliza la gelatina (inconveniente => se funde a 24oC y existen bacterias gelatinasa positiva que destruiran tal medio); posteriormente Hesse su alumno usa el agar (medio inerte).
- Medios líquidos/caldos => contiene agua, fuente de carbono, sales minerales y algunos lleva factores de crecimiento, vitaminas, peptonas y aminoácidos.
- Medios semisolidos => agar semi-sólidos (<5% de agar)
Medios de cultivo según su uso o utilización:
- Medios para aislamiento => {a} medios enriquecidos (componentes basicos + caseina soja, triptofano para microorganismo exigente; e.j. agar sangre/chocolate {b} medios selectivos (componentes basicos + componentes que impiden el crecimiento de algún tipo bacteriano para seleccionar) e.j. medio Rothe (para aislar Streptococcus faecalis /Gram+) contiene azida sódica que impide Gram-; la mayoria de medios selectivos son también medios diferenciales {c} medios diferenciales (= medios selectivos + sustancias resalta las caracteristicas microbiales de algunas; e.j. medio Levine (contiene eosina y azul de metileno que inhibe Gram+ y algunas Gram-, facilita a las enterobacterias y lactosa (para las fermentadoras)
- Medios para crecimiento en general => liquida o solida sirve para el crecimiento de la mayor parte de las bacterias (componentes basicos + sales y agua) ; e.j. el caldo comun (contiene extracto de carne, peptona, glucosa, cloruro sodico y agua); el caldo Tioglicolato.
- Medios de identificación (= medios diferenciales) => sirve para clasificar taxonómica-mente el microoganismo; e.j. agua peptonada = indol positivo; caldo Stuart urea-indol = ureasa; glucosa = fermentación de glucosa (sacarolitico = sacarosa positivo).
- Medios de mantenimiento de cepas => mantener las cepas vivas durante periodos de tiempo relativamente largos a temperaturas bajas para impedir su crecimiento; e.j. leche descremada congelada
- Medios para antibiogramas; e.j. Proctor (antibiogramas fungicas), Mueller Hinton (a.b.bacterianas), Wilkins-Chapman (a.b. bacteriana anaerobicas).
Medios de cultivo según su origen
- Medios naturales => poco utilizados, se preparan artesanalmente, constituidos por ciertos tejidos, liquidos organicos (leche, huevo, patata, suero sanguineo)
- Medios semi-sintéticos => parte de su composicion son extractos naturales (levadura, malta, patata, sagre, leche) + constituyentes sintéticos
- Medios sintéticos => estructuras sintéticas mas o menos puras y químicamente definidas disueltas en agua destilada (los mas utilizados en bacteriologia y en general); contiene: fuente de carbono o azucar, fuente de nitrógeno inorgánica como iones NO-3, NH+4 o orgánica como peptona, aminoácidos, aminas, etc., compuestos minerales como oligoelementos, factores de crecimiento (vitaminas, aminoacidos, bases puricas o pirimidínicas).
- Medios complejos => son los primeros que se utilizaron en bacteriología; en actualidad se uss mas en parasitología y virología; se preparan de forma compleja (tejidos animales/carne de musculo, higado, corazon, yema de huevo, azucares, pepetonas, vegetales, etc.
Medios de cultivo segun su presentacion
- Medios deshidratados o liofilizados
- Medios ya preparados
- Medios solidos en placa Petri
- Medios solidos en tubo
- Medios liquidos en tubo
- Medios semisolidos en tubo
- Medios de doble fase en frasco
Principales medios utilizados en microbiología
1. Agua peptonada (peptona en medio acuoso con pH 7 a 37ºC 24-48 horas) => determinación de la producción de indol debido a su alto contenido en triptófano; tras la adición de 5/6 gotas de reactivo Kovacs en hidróxido potásico (KOH 40%) => anillo rojo en la superficie indicara indol positivo.
2. Medio Chapman (selectivo y diferencial) => aislamiento de Staphylococcus (halófilos) S.aureus (coagulasa+); Comp: alto contenido de cloruro sódico 75 gr (agar manitol salado); 15 gr de D-manitol (diferencial => azucar utilizado por algunos estafilococos), 25 gr de rojo fenol (indicador positivo de pH a 37ºC 24-48 horas => amarillo dorado); es orientativa, se debe completar la prueba con pruebas bioquímicas (coagulasa/latex); S.epidermidis no fermentan el manitol, por tanto el color sigue rojizo o purpureo.
3. Agar de Thayer y Martin (Agar New York City) => no permite el crecimiento de muchos microorganismos, pero si permite aislar gonococos y meningococos (Neisseria); Comp: agar chocolate/ sangre calentado + formula polyvitex (vitaminas y aminoácidos) + VCAT (vancomicina => inhibe los Gram+, colistina => inhibe los coliformes /Gram-, anfotericina => antifúngico, trimetropinsulfametroxazol => antibiótico de amplio espectro).
4. Agar chocolate Polyvitex => medio general enriquecidos donde crecen la mayoría de bacteria y Haemophyllus); Comp: agar chocolate + formula polyvitex (vitaminas y aminoácidos) incluyendo factores X (hemina) y V (NAD/ nicotinamida adenina dinucleótido) proporcionados por la hemoglobina y PolyViteX.
5. Medio base Christensen (líquidos y sólidos) => para la prueba de la ureasa; ureasa+ de rojo => rosa; gérmenes con ureasa+ => Proteus y Helicobacter pilory
6. Medio citrato de Simmons (agar solido) => prueba de citrato (como fuente de energía) para la investigación de bacilos Gram- (la diferenciación entre coliformes y coliformes fecales. Los coliformes fecales (E.coli) no fueron capaces de utilizar el citrato como fuente de carbono ni a las sales de amonio como fuente de nitrógeno. Los coliformes no fecales como Enterobacter aerogenes o Salmonella enteritidis podían utilizar el citrato en este medio dando una reacción alcalina); Comp: citrato sódico, azul de bromotimol (indicador pH, de que el citrato esta consumido /se alcalina; verde => azul); gérmenes con citrato permeasa => Klebsiella pneumoniae, Salmonella, Enterobacter aerogenes.
7. Medio Clark y Lubs (caldo/ liquido) => para diferenciar entero-bacterias mediante prueba de Voges-Proskauer (producción de acetoína/ acetil metil carbinol => por reducción a 2,3 butanodiol o por oxidación a diacetilo); y prueba de Rojo de Metilo (acidificación del medio con pH <4,5 y cambio de color a rojo); gérmenes con VP+ => Klebsiella pneumoniae y Enterobacter aerogenes; gérmenes con RM+ => Proteus, E.coli y Salmonella.
8. Medio Cled/Cystine-Lactose-Electrolyte-Deficient (solido) => recuento e identificación de gérmenes en las vías urinarias; Comp: lactosa en alta cantidad, azul de bromotimol (indicador del consume lactosa verde => amarillo); las colonias mas frecuente => E.coli (amarilla L+), Proteus (azul L-), Klebsiella (amarilla azulada y muy mucosa (L+), Pseudomonas aeruginosa (verde L-), Streptococcus faecalis (amarilla L+), Staphylococcus aereus (amarilla L+).
9. Agar sangre (se comercializa con nombre TSA => tripticasa, soja, agar) => investigación de microorganismos hemolíticos (consume hematíes); es un medio general enriquecida; Comp: sangre de cordero (agar columbia) o caballo o ternero => estériles y desfibrinadas; alfa hemólisis/ neumococo (parcial) => halo verdoso/difuso alrededor de la colonia; beta hemólisis/ Streptococcus B-hemolítico y Staphylococcus aureus que causan anginas (total) => halo transparente; gamma hemólisis/ Pseudomona causa gastro intestinales (no hemolizar) => sin halo.
10. Medio eosina azul de metileno /EMB (Medio Levine) => selectivo y diferencial, para aislamiento de entero-bacterias Gram- (E.coli, Enterobacter, Salmonella, Shigella, Proteus, Klebsiella) Comp: alto contenido de lactosa (indicador fermentadora), eosina azul de metileno (indicador de pH y inhibidor los Gram+ y las floras de Gram- fastidiosas).
11. Medio de agar Hektoen (diferencial y selectivo) => aislamiento de entero-bacterias patógenas Gram-; Comp: sales biliares (inhibe Gram+), lactosa (indicador de L+ => amarillo/naranja) sacarosa, peptona, tiosulfato sódico y citrato férrico amoniacal (indicador de la producción SH2/H2S => puntos negro), azul de bromotimol, fuschsina ácida (indicadores de pH); en condición normal es verde => fermentacion de lactosa/acidificación => vira a amarillo/naranja (características de fermentadora L+ Escherichia, Serratia, Klebsiella, Citrobacter, Enterobacter y Vibrio cholerae); cuando se consume lactosa + peptona (se acidifican primero, y después se basifican) => verde; cuando se consume azufre/ disulfurasas+ => precipita el hierro y la colonia se vuelve negro (característica de Salmonella y Proteus vulgaris).
12. Medio Kliger o KIA (Kliger Iron Agar) => medio solido en tubo (color caramelo); muy semejante y mas utilizado es TSI (triple sugar, iron) + 10 gr de sacarosa; muy utilizado para la identificación de entero-bacterias, pruebas de la lactosa, glucosa, gas y SH2; Comp: lactosa (indicador de L+), peptonas, glucosa, citrato férrico amoniacal y tiosulfato sódico (componentes para producir SH2), rojo fenol (indicador de pH); los gérmenes productor de SH2+ => Proteus, Salmonella y Citrobacter; los productores del gas CO2+ => Salmonella y Citrobacter y E.coli.
13. Medio MacConckey (color rosa) => aislamiento e identificación de entero-bacterias Gram-/ poco exigentes; Comp: sales biliares (inhibidor Gram+), lactosa (indicador L+), cloruro sodico, rojo neutro, cristal violeta (inhibidor los cocos de Gram+); L+ (consumidor de lactosa) => rojo (E.coli y Enterobacter aerogenes), L- (no fermentador)=> Salmonella, Shigella y Pseudomonas; Gram- exigentes => Neisseria, Haemophyllus.
14. Medio Mueller Hinton (general) => para la realizacion de antibiograma por el método de Bauer-Kirby
15. Medio Ornitina Movilidad/ MIO (preparado en tubo/ semisolido) => identificación de la movilidad bacteriana (entero-bacterias), capacidad para descarboxilar la ornitina (orinitina descarboxilasa /está dada por un color púrpura/ alcalinidad del medio y la producción de indol (al añadir reactivo de Kovacs); La movilidad se demuestra por un enturbiamiento del medio o por crecimiento que difunde mas allá de la línea de inoculación; el germen que da resultado positivo de los 3 pruebas => E.coli.
16. Medio caldo F-Selenito (selectivo) => medio enriquecido con fosfato para el aislamiento de Salmonella; Comp: selenito sódico (inhibidor de flora Gram+ y Gram- excepto Salmonella); después también se hace cultivo con agar SS.
17. Medio agar S-S (color caramelo) => aislamiento de las bacterias patógenas importantes Salmonella y Shigella; Comp: lactosa (indicador fermentadora de L), tiosulfato sódico y citrato de hierro (indicador de SH2), sales biliares y verde brillante (inhibidor bacillos Gram+), rojo neutro (indicador de pH); L+ (coliformes - E.Coli y Klebsiella) => rojas o rosadas; L- y SH2- => incoloras (típico de Shigella); L- y SH2+ con la precipitación de hierro => negro (típico de Salmonella).
18. Medio Agar XLD (agar xilosa-lisina-desoxicolato) => se utiliza para el aislamiento y diferenciación de bacilos entéricos Gram-, especialmente del género Salmonella y especialmente Shigella (entero-bacterias patógenas); Comp.: xilosa (la fermentan los entéricos menos Shigella), sacarosa y lactosa, desoxicolato de sodico (inhibe Gram+); se puede utilizar para la identificación de lactasa+, lisina descarboxilasa+ => Salmonella que alcaliniza el medio y SH2+ (tiosulfato sódico + citrato de hierro amoniacal).
19. Medio caldo Columbia => caldos para hemocultivos.
20. Medio Castañeda (caldo y solido) => búsqueda de gérmenes Brucella, Vibrios y Pasteurella en sangre (hemocultivos).
21. Medio de Lowenstein-Jensen (selectivo) => cultivo de Mycobacterium tuberculosis y otras micobacterias; Comp: fécula de patata, verde malaquita => inhibidor de la mayoría de gérmenes; la prueba se confirma con tinción de acido alcohol resistencia (Con la tinción de Ziehl-Neelsen las micobacterias se observan como bacilos de color rojo); micobacterias patógenas crecen muy lenta (+ 7 días); los niveles bajos de la penicilina y el ácido nalidíxico también están presentes en el medio de LJ para inhibir el crecimiento de Gram+ y Gram-, con el fin de limitar el crecimiento => único de micobacterias.
22. Medio Sabouraud => para el aislamiento e identificación de hongos micelares y levaduriformes.
23. Medio Sabouraud gentamicina tetrazolium => para el aislamiento e identificación de Candida (levaduriformes); La gentamicina inhibe el crecimiento de la mayoría de las bacterias Gram- y Gram+.
24. Medio Schaedler con vitamina K3 (caldo o agar solido) => para cultivo de anaerobios (estrictos y facultativos); La presencia de factores de crecimiento como el extracto de levadura, la hemina y la vitamina K3 y la adición de sangre de cordero permite el crecimiento incluso de las especies más exigentes.
El agente reductor (L-cistina) y la elevada concentración de dextrosa en el medio favorecen el crecimiento
de especies anaerobias p.ej. Lactobacillus, Streptococcus, Clostridios y Bacteroides.
25. Medio CPS cromogénico (agar/ solido) => es un medio de aislamiento y de identificación destinado a las muestras urinarias; permite realizar (1) el recuento microbiano (método de inoculación estandarizado); (2) identificación de: Escherichia coli, Enterococcus del grupo D, KES (Klebsiella, Enterobacter, Serratia), Proteeae (Proteus, Providencia, Morganella); la concentración elevada de agar evita el crecimiento invasivo de Proteus; el medio se inocua directamente a partir de la orina, respetando técnicas adecuadas de toma de muestras y su transporte; permite la identificacion directa de:
a. E.coli => coloración espontanea (rosa a burdeos) de las colonias productores de B-glucuronidasa (B-GUR) y coloración azul revelada por el reactivo indol cuando la cepa genera triptofanasa.
b. Enterococcus y KES => coloración espontanea azul-verde de las cepas que producen B-glucosidasa (B-GLU).
c. Proteeae => coloración marrón revelada por el reactivo TDA cuando la cepa genera triptófano desaminasa (sin reactivo es incoloro).
Modo operativo - dejar atemperar las placas a temperatura ambiente; inocular la muestra con el asa calibrada de 10ul => sumergir el asa en la orina, mantenerlo verticalmente; descargar el asa al realizar una estría sobre un radio de la placa; realizar estrías perpendiculares muy apretadas sobre toda la superficie de la placa; incubar en la estufa con la tapa hacia abajo a 37ºC en aerobiosis; se examinan los cultivos después de 24 horas de incubación.
Lectura e interpretación:
Recuento - estimar la concentración bacteriana comparando la densidad de las colonias presentes sobre la mitad superior de la placa con la del esquema; <1000 (negativo), entre 1000 - 100.000 (dudoso), mas de 100.000 (positivo)
Identificación - observar las colonias
(1) Colonias de color rosa a burdeos o translucidas con centro rosa a burdeos => presunción de E.coli; confirmar mediante una detección de indol (depositar una colonia sobre un disco de papel previamente embebido de una gota de reactivo R1 del envase ID Indol TDA) => indol+ da una coloración azul (E.coli); la ausencia de color azul (indol-) se debe proceder a la pruebas de API.
(2) Colonias de color azul-verdoso y observación de cocos Gram+ mediante examen directo => Enterococcus; si no cumple esta condición, se debe proceder a las pruebas de API.
(3) Colonias de color azul-verdoso y observación de bacilos Gram- mediante examen directo => grupo KES; la identificación se debe proseguir mediante pruebas bioquímicas (ureasa+ => Klebsiella; ornitina descarboxilasa+ => Enterobacter; gelatinasa+ => Serratia).
(4) Colonias incoloras a marrón-anaranjado => efectuar TDA (depositar sobre algunas colonias idénticas, una gota de reactivo R2 del envase ID Indol TDA), observar la coloración después de unos 30 segundos => TDA+ da una coloración marrón +/- oscuro; efectuar indol => indol+ da color azul (Proteus, Providencia o Morganella); ausencia de coloración azul es indol- (Proteus mirabilis); TDA- da una coloración amarilla y la identificación se debe proceder a las pruebas de API.
Tema 7 - Metodos de Siembra (cultivo de las cepas)
Sembrar - cultivar la muestra utilizando técnica y medios adecuados para conseguir el objetivo (identificar el microorganismo).
Preparación de inóculos (pequeña parte de muestra)
- Muestras viscosas o concentradas (análisis cuantitativo) => suspender un cultivo joven y puro o un producto patológico (muestra biológica) en 5 ml de solución diluyente (caldo de cultivo, suero fisiológico estéril o agua destilada estéril.
- Ajustar con la escala con un gradiente de turbidez (tecnica de Kirby-Bauer) => tubos numerados como patrón de referencia según la concentración de microorganismos; se ajusta mediante comparación visual aproximada o mediante la absorbancia de espectrofotometría; escala de Mcfarland => una serie de tubos con precipitación blanco de sulfato de bario por reacción de acido sulfúrico + cloruro de bario (escala 0,5 = 1,5 x 10.6/ml de microorganismos en el inoculo; escala 1 = 3 x 10.6 /ml; escala 2 = 6 x10.6./ml.
Metodos de inoculación y aislamiento de microorganismos
1. Metodos de siembra - inoculación:
{a} En medio liquido; con asa => se sumerge el asa cargada en el medio y se agita; con pipeta => se vierte el contenido de la pipeta sobre el medio de cultivo y se homogeneiza; con escobillón = con asa.
{b} En medio solido (en placa):
- Inoculación previa al vertido en placa (técnica de Barry - no se utiliza mucho) => 0,1 ml de inoculo + 25 ml de medio cultivo => fundido/ atemperado a 45-55ºC para no esterilizar => homogeneizar => verter en la placa de Petri.
- Inoculación sobre la superficie del medio solidificado (técnica de Kirby-Bauer) => se prepara el inoculo en un tubo estéril; se introduce un escobillón estéril impregnando; se elimina el exceso presionando el escobillón con movimiento de rotación contra las paredes del tubo; se siembra la placa emplenando la técnica de los tres giros distribuyendo uniformemente el inoculo; se deja secar la placa 4-5 minutos en posicion semiabierta e invertida, quedando lista para ser utilizada (en los antibiogramas).
{c} En medio solido (en tubo):
- Siembra por estria en superficie inclinada => se toma la muestra con el asa /hisopo; se introduce en el tubo que contiene el medio; desde el fondo y en progresión ascendente se desliza el asa en movimiento de zig-zag (se utiliza para pruebas bioquímicas y renovar cepas).
- Siembra en picadura (para ver la movilidad de los gérmenes en la zona de punción + pruebas bioquímicas) => se toma la muestra con la aguja o hilo; se punciona en el centro del medio introduciendo la punta de la aguja hasta 2-3 mm del fondo del tubo; se extrae la aguja por la misma linea que se introdujo; medio solido inclinado => puede realizarse tambien una siembra en estría por la superficie del medio con la misma aguja; agar semi-solido => puede usar el asa en lugar de la aguja.
2. Metodos de siembra - aislamiento (para obtener cepas puras/ bien aisladas) :
{a} Siembra en estria o zig-zag => se deposita el inoculo en el extremo superior de la placa; se siembra con el asa o con hisopo, a partir del inoculo, con un movimiento en zig-zag cada vez mas amplio de lado a lado de la placa; el estriado ha de hacerse sin presionar el medio, suavemente, sin levantar el asa y sin flamearla; las colonias mas aisladas las obtendremos en la zona mas distal del inoculo, es decir al acabar la siembra.
{b} Siembra en tres direcciones => se deposita el inoculo en el extremo superior de la placa dejando deslizar hacia el centro para ello inclinaremos la placa (también se puede arrastras con el asa); mediante asa o escobillón, haremos movmientos laterales de un lado a otro de la placa, dejando las estrias muy juntas; giramos la placa 90º y realizamos la misma operación, sin flamear o cambiar de asa; volvemos a girar la placa haciendo lo mismo; al final nos queda una placa muy bien tapizada. Se realiza en urinocultivos para el contaje de las colonias.
{c} Siembra en estría multiple => se deposita el inoculo en un extremo de la placa; con el asa se reparte en varios tramos, siguiendo el borde de la placa; entre cada tramo se ha de flamear o cambiar el asa; los segmentos seguidos describen un poliedro regular y el ultimo tramo se efectua hacia el interior en el que se obtendran colonias aisladas.
{d} Técnica por agotamiento en cuadrantes (lo que usamos) => es muy similar a la anterior pero sin flamear el asa y estriando mas los cuadrantes, aprovechando mas la placa.
{e} Técnica de los 4 cuadrantes => se divide la placa en 4 cuadrantes (pueden rotularse por la parte posterior); se deposita el inoculo en el extremo superior de uno de los cuadrantes y se siembra en estría; sin flamear el asa, se realiza la misma operacion sucesivamente en los otros 3 cuadrantes; en cada uno de ellos se sembrara el inoculo que queda adherido al asa, tras la siembra del anterior; en el ultimo de los cuadrantes sembrado, se encuentran las colonias aisladas.
{f} Técnica de los tres giros => se siembra en estría la mitad de la placa; flamear el asa; se gira la placa 90º, sembrando en estría la mitad superior de la misma; se repite la operación, es decir se ha de flamear el asa, se gira la placa y se estría; la colonia aisladas aparecerá en la zona sembrada en ultimo lugar.
Tema 8 - Características biológicas de la bacteria (Morfología)
Bacterias - organismos unicelulares de tamaño 0,2-2 um, relativamente sencillos, cuya material genético no esta rodeado por una membrana nuclear especial (procariotas).
Estructura - constituidos por elementos obligados (presentes en todas las bacterias e indispensables para su vida => pared celular, membrana plasmática, citoplasma, ribosomas y la región nuclear); elementos facultativos (son elementos de supervivencia y virulencia que pueden estar o no presentes en la bacteria => capsula, flagelos, pelos/pilis, endosporas e inclusiones citoplásmicas)
Pared celular - es el limite externo de la célula con estructura rígida, parecida a la pared celular de las células vegetales; funciones => protegerse de cambios externos adversos, mantener la morfología de la célula, proporciona la resistencia a los antibióticos, dar un paso selectivo de algunas sustancias, proporciona la especificidad de grupo y de tipo (clasificación), implicada en la patogenicidad; dar el color en la tinción de Gram, violeta oscuro => Gram+ y color rosa => Gram-.
Estructura y composicion de la pared celular - Gram+ => mono-estratificada y gruesa, compuesta por mureina (peptidoglicano - mono-capa, 50% peso seco/mucha cantidad), polisacáridos, proteínas y ácidos teicoicos; Gram- => biestratificada y fina (1ª capa es mureina en poca cantidad y 2ª capa formada por polisacáridos proteínas, fosfolipidos y lípidos, no tiene ácidos teicoicos); las bacterias que no son sensibles a la tinción de Gram => BAAR/ acido alcohol resistentes (micobacterias); las que sin pared celular => los de genero mycoplasma/ patógenas; la que tienen (formas S), pero la pierden (formas L).
Membrana plasmática - estructura delgada que se extiende por dentro de la pared celular, encerrando al citoplasma; funciones => actúa como barrera selectiva, interviene en la degradación de nutrientes y producción de energía, en algunas se encuentran pigmentos y enzimas para la fotosíntesis; estructura y composición => fosfolípidos, proteínas y glicolípidos; mesosomas => plegamientos hacia dentro de la membrana plasmática, irregulares (no existen en las celulas eucarióticas), se encargan de dirigir la duplicación del ADN bacteriano y realizar la respiración.
Citoplasma - es todo lo que hay en el interior de la membrana plasmática; función => engloba los orgánulos celulares (región nuclear, ribosomas, inclusiones/depósitos de reserva, vacuolas); no tienen ni aparato golgi, ni retículo endotelial plasmática, ni mitocondria; composicion => 80% de agua, enzimas, iones y principios inmediatos.
Región nuclear - una zona en el interior del citoplasma donde se acumula el acido nucleico; funciones => el acido nucleico transmite la información genética de la célula sobre estructuras y funciones celulares; estructura y composicion => es un núcleo difuso que contiene 1 molécula ADN bicatenario, formando N cromosomas (enroscada en forma de anillo); plásmidos => estructuras que pueden existir ademas de ADN cromosómico (formadas por moleculares de ADN extra-cromosómico bicatenario, pueden estar libres o unidos al ADN cromosómico /episomas), se replican independientemente, se transmite por conjugación, portan genes muy importantes que determinan la resistencia a antibióticos, tolerancia a metales tóxicos y síntesis de enzima.
Ribosomas - son orgánulos celulares muy abundantes (presentes en eucariotas y procariotas) dan aspecto granuloso a su citoplasma; funciones = > síntesis de proteínas; estructura y composicion => en grupos de 3 o 4 unidos por un filamento de ARN mensaje (polirribosomas), cada ribosoma tiene 2 subunidades de 30 y 50 Svedberg (velocidad relativa de sedimentación), procariotas - 70S y eucariotas - 80S; comp: 60%ARNr y 40% proteínas.
Elementos facultativos (algunos no tienen - variables) - son elementos de supervivencia y virulencia
Inclusiones citoplásmicas - aparecen en el citoplasma y no tienen una estructura uniforme; funciones => depósitos de reserva e intervienen en funciones de regulación; Tipos: (1) Gránulos de reserva => lipídicos, corpúsculos metacromáticos (fosfato inorgánico), polisacáridos (glucógeno y almidón), gránulos de azufre; (2) Vacuolas => acúmulos de gases o líquidos rodeados de membrana (donde se fija CO2).
Flagelos - largos apéndices filamentosos frecuentes solo en los bacilos (su presencia es rara); funciones => responsable de la movilidad (elementos patogénico: facilitar la difusión de las bacterias a traves de las
membranas); estructura => tres partes (filamento, codo y corpúsculo basal); tipos => monótricas (1 solo flagelo en un extremo), lofótricas (2 o mas en un extremo), anfítricos (un grupo de flagelos en un extremo y otro grupo en el otro extremo), perítricos (flagelos distribuidos en toda la superficie de la bacteria);
Pelos /pilis o fimbrias - elementos rígidos constituidos por una proteína (pilina); cortos, muy numerosos, distribuidos sobre la superficie, mas frecuentes en Gram- que en Gram+; funciones => capacidad de fijación a superficies (pelos comunes), proporcionan pelos comunes y sexuales (son morfológicamente iguales), sistema de intercambio de información genética por conjugación (pelos sexuales).
Endosporas - solo en bacilos (Bacillus aerobio estricto y Clostridium anaerobio estricto); una forma de resistencia que adoptan algunas bacterias ante situaciones adversas (deficiencia nutricional, desecación, frio, temperaturas elevadas, agentes químicos); se forman por un proceso de esporulación /esporogénesis, pueden permanecer latentes durante cientos de años y volver a una forma vegetativa por un proceso germinación; localización => zona central, subterminal o terminal (depende de su tamaño, pueden o no deformar el bacilo); la espora => célula en reposo con capacidad de resistencia a la desecación, calor y agentes químicos; esporulación => la producción de estructuras, enzimas y metabolitos nuevos y la desaparición de muchos componentes celulares; Morfológicamente comienza con el aislamiento del núcleo y elementos energéticos mediante el crecimiento en vaginante de la membrana; los elementos esenciales para la vida quedan protegidos en esa nueva estructura (endosporas); la bacteria queda en estado latente esperando una condición externas favorables para resurgir.
Capsula - estructura que rodea la pared bacteriana; se visualiza con tinción negativa (tinta china); funciones => regula el intercambio de agua, iones y nutrientes, sirve como almacén externo de nutrientes, defensa frente a Acs, fagos y celulas fagocíticas (elemento virulencia), protege de la desecación (contiene agua), formación de colonias (habitualmente engloba mas de una bacteria); estructura y composición => polisacáridos y proteínas.
Tamaño y Morfología de las Bacterias - 0,2 - 2 um; es preciso utilizar el microscopio óptico; la morfología => información primaria sobre el tipo de bacteria, pero no de forma concluyente (viene dada por la rigidez de la pared; formas => esférica/coco, coco-bacilo, bastoncillo/cilíndrica/bacilo, helicoidal/espirilo, en coma/vibrio, espiral/espiroqueta, estrella y cuadrangular /forma de hifas de hongos (actinomyces/ streptomyces - productor de muchos ATB, ATF y inmunosupresores); agrupación de los cocos => aislados, en parejas/diplococos (granos de cafe - típico de neisserias/meningitis), en cadenas/estreptococos, tetradas o tretacocos (4 celulas => micrococcus/micrococacceae), en racimos/estafilococos, en formas cubicas de 8 elementos/sarcinas (sarcinas ventriculi - tolerancia al medio ácida/ estomago); agrupación de los bacilos => aislados, en parejas/diplobacilos, en cadena/estreptobacilos, algunos se parecen a cocos/cocobacilos (E.coli), en forma empalizada/letra china (corynebacterium - algunos son saprofitos de la piel y también causante de difteria).
Aroma típicos => Pseudomonas aureginosa (olor a jabón); Haemophyllus (olor a semen/yeso); Citrobacter (olor a fétido); Proteus (olor a amoniacal); Klebsiella y E. coli (olor a levadura de pan).
Tema 10 - Fisiología de las bacterias
Morfología macroscópica - estudio de la forma y estructura de las colonias (masas constituidas por muchos millones de bacterias, se aprecian a simple vista y originadas a partir de una bacteria en el medio solido); reconocible en función de => 1. características o tipo de medio de cultivo solido donde se ha desarrollado (un microorganismo puede dar lugar a distintos tipos de colonias) 2. tipo de microorganismo (mayor movilidad => colonias extendidas y planas); la verificación de las colonias (siempre en medios sólidos sembrándolo por estría) => en placa y en tubo con agar inclinado.
Las colonias en placa - sembrándolo por estría
El tamaño y el aspecto de cada colonia son bastante constante para cada genero y especies, hecho que se puede utilizar como característica diferencial; tamaño => 1-2 mm (E.coli); 4-6mm (stafilococcus en agar sangre); extendidas en forma de velo invadiendo toda la superficie del medio (Proteus en AS); puntiformes +/- 0,5 mm o inferiores (stafilococos en AS); forma => según el espesor (planas, elevadas, semiconvexas, cóncavas semicóncavas, semiesféricas, en meseta); según los bordes (lobuladas, onduladas, rizoides, redondeadas, filamentosas, especuladas); superficie de la colonia/ elevación/ aspecto => lisa, rugosa (con capsulas), plana, acuminada, umbilicada, mucosa, seca; consistencia de la colonia => duras, viscosas, mucosas, secas, muy secas, cremosas; transparencia y coloración => debido a la elaboración de algún tipo de pigmento, formación de alguna sustancia por parte de la bacteria o la utilización de algún sustrato del medio que se acidifique o basifique; la presencia o no de halos de transparencia => generado por la prueba de la gelatinasa (+) en placa y también por la actividad hemolítica de ciertas bacterias con hemolisinas (estreptococos hemolíticos tipo alfa, beta y gamma).
Las colonias en tubo, con agar inclinado - sembrándolo por estría
Las colonias presentan las mismas características que en placa, pero su visualización es mucho peor (menor superficie); aspecto => filiforme, rizoide, arborescente, filamentoso, difuso, perlado, equinulada, arrosariada.
Morfología microscópica - estudio de la estructura fina de las bacterias
1. Estudio de su forma como célula procariota individual:
oval/esférica => coco/cocoidea; cilíndrica/bastón => bacilo; espiral/helicoidal => espirilo/sacacorchos /espiroquetas; filamentosa/forma de hifas de hongos => filamentosas (actinomyces/ streptomyces), formas intermedias => vibrio, coco-bacilos; bacterias helicoidales => Borrelia (poca espiras y amplitud), Treponema (tiene mas espiras) y Leptospira (muy apretadas y enroladas).
2. Estudio de su agrupación bacteriana (no todas las formas bacterianas se agrupan, p.ej. los espirilos y los actinomicetos) => los mas frecuentes son las formas cocoideas y las bacilares son menos frecuentes; las cocoideas => diplococos (parejas /granos de café => neisserias y neumococos); estreptococos (paralelos/cadenas => streptococcus); tetradas o tretacocos (4 celulas => micrococcus/micrococacceae); estafilococos (racimos => staphylococcus/ micrococcus); sarcinas (cuboidales de 8 celulas o mas; sarcina ventriculi y también stafilococcus); las bacilares => diplobacilos/parejas, estreptobacilos/ cadenas y formas irregulares/en empalizada/letra china (corinebacterium).
TAXONOMÍA - CLASIFICACIÓN DE LAS BACTERIAS
La clasificación definitiva de las bacterias esta aun por establecer; los que se utilizan actualmente deben considerarse como provisionales o transitiva; la mas utilizada suelen ser recogidas de las manuales BERGEY'S en la 9ª edición de Bergey's Manual of Determinative Bacteriology de 1994, se agrupan a las bacterias en 35 grupos, situados en 4 categorías mayores:
1. Eubacterias Gram- (bacterias verdaderas) con 16 grupos; en esta categoría se incluyen a la mayor parte de las bacterias que provocan a la patología humana.
Espiroquetas:
- Familia Leptospiraceae (genero - Leptospira)
- Familia Spirochaetaceae (genero - Borrelia, Treponema)
Helicoidales /vibrioides aerobias - microaerófilas móviles (crecen mejor a bajas presiones de oxígeno):
- Familia Campylobacteriaceae (genero - Campylobacter, Helicobacter)
Bacilos y cocos aerobios - microaerófilos (crecen mejor a bajas presiones de oxígeno):
- Familia Pseudomonadaceae (genero - Pseudomonas, Stenotrophomonas)
- Familia Alcaligenaceae (genero - Bordetella) => bacilos y coco-bacilos
- Familia Legionellaceae (genero - Legionella)
- Familia Neisseriaceae (genero - Neisseria) => diplococos
- Familia Moraxellaceae / Familia Branhamaceae (genero - Moraxella, Branhamella) => diplococos
- Otros generos => Brucella (cocobacilos)
Bacilos anaerobios y facultativos:
- Familia Enterobacteriaceae (genero - Citrobacter, Enterobacter, Escherichia, Klebsiella, Serratia, Hafnia [coliformes] Morganella, Proteus, Providencia, Salmonella, Shigella, Yersinia/peste)
- Familia Vibrionaceae (genero - Vibrio, Aeromonas, Plesiomonas)
- Familia Pasteurellaceae (genero - Haemophilus)
- Otros generos => Gardnerella
Cocos Gram- anaerobios => genero - Veillonella
- Familia Rickettsiaceae (genero Coxiella, Ehrlichia, Rickettsia) - son parásitos intercelulares obligados, altamente pleomórficas cocos/bacilos/hilos
- Familia Chlamydiaceae (genero Chlamydia) - son parásitos intercelulares obligados de forma esférica.
2. Eubacterias Gram+ con 13 grupos (17-29); en este grupo hay los que provocan patologia humana (la mayoria).
Cocos => genero - Staphylococcus y Streptococcus
Bacilos esporulados => genero - Bacillus (aerobio) y Clostridium (anaerobio)
Bacilos regulares no esporulados => genero - Lactobacillus y Listeria
Bacilos irregulares no esporulados:
- Familia Corynebacteriaceae (genero - Corynebacterium)
Micobacterias:
- Familia Mycobacteriaceae (genero - Mycobacterium)
3. Micoplasmas (Mollicutes / bacterias sin pared) de 1 solo grupo (30); dentro de este grupo, los que provocan patología humana => genero Mycoplasma/ Mycoplasma pneumoniae y Ureaplasma.
4. Arqueobacterias con 5 grupos (31-35); todas las bacterias de este grupo no provocan patologia humanas (viven en las situaciones extremas => termofilas/ termogenas)
Taxonomía => la ciencia de la clasificación que agrupa y separa los organismos de acuerdo con su características fenotípicas, estructurales o genéticas para facilitar su estudio; la misión => construir un esquema racional, para clasificar y nombrar los organismos; el sistema jerárquico de la taxonomía se ha formado gradualmente a partir del sistema binomial / binominal / binaria de nomenclatura genero y especie establecida por Linneo en 1758 (un botánico); la taxonomía no es una ciencia estático, goza de gran dinamismo y esta en la relacion con los avances de los procedimientos empleada para su estudio; el termino de sistemática se utiliza como sinónimo de taxonomía; los grupos de taxonomía van de dominio - imperio - reino - tribu - división - clase - orden - familia - genero y especie.
Para la asignación de una bacteria, se siguen las normas recogidas por el código internacional de nomenclatura bacteriana y adquieren validez cuando ha sido publicado por el Int´l Journal of Systematic Bacteriology; bien en un articulo o bien dentro de los sistemas en las listas de las bacterias aprobadas que incluyen sus números; una especie bacteriana, viene definida por un nombre genérico de un nombre especifico latinizado o helenizado y concuerdan gramaticalmente; la inicial de genero va con letra mayúsculas y el de especie con minúsculas; tanto el nombre de genero o especie se escriben con letra cursiva/ italica o en su defecto, subrayado; en la denominación de un especie, la palabra que define genero puede ser abreviada a su inicial seguida de un punto (p.ej. E.coli o E.coli); los nombres de las bacterias no se eligen de manera arbitraria, sino que pueden ser descriptivos, p.ej. Staphilococcus aureus (cocos en forma de racimos - dorados); o pueden dar homenaje a un autor p.ej. Pasteurella, Bacilo de Koch, también puede dar referencia a un acontecimiento p.ej. Legionella; el nombre generico es único; para referirse a un especie o varios especies no determinadas su genero => E.spp/ sp; algunas de las categorías taxonomia superiores, se forman añadiendo las palabras que las asignan distintas terminaciones, p.ej. aceae; para el orden => ales (sufijo) p.ej. Mycoplasmatales; todas las categorías taxonomía se expresa en cursiva o itálica.
FLORAS BACTERIANAS
Flora Normal de la especie humana => la población de microorganismos comensales que normalmente coloniza la piel y las membranas mucosas de las personas adultas sanas; la piel y las mucosas colonizadas por microorganismos dinámicos => cambios cualitativos y cuantitativos constantemente; 2 poblaciones:
1. La flora residente (FR) => un numero relativamente fijo de especies de microorganismos (comensales y oportunistas) en una zona definida (si se producen alteraciones, suelen ser temporales); permanecen intactas; encuentran condiciones fisiológicas y nutritivas adecuadas; no es esencial para la vida, pero es normalmente beneficiosa (produce vitamina K en el intestino y ayudan en la absorción de nutrientes y impide la colonización de microorganismos potencialmente patógenos.
2. La flora transitoria (FT) => microorganismos no patógenos o potencialmente patógenos, que colonizan la piel o las mucosas en periodo corto de tiempo; tiene poca importancia, pero si la flora residente se altera, la flora transitoria puede multiplicarse y producir infecciones.
La supresión de FR => vació ecológico => ocupación de microorganismos ambientales o de otras zonas de cuerpo => infecciones.
FR oportunistas => los que tienen acceso a lugares estériles; algunos ejemplos:
- Streptococcus viridans son comensales del tracto respiratorio superior y de la boca, si alcanza el torrente sanguíneo => si válvula cardíaca dañada => posible endocarditis;
- Bacteroides son comensales del intestino grueso => si apendicitis perforada => posible peritonitis o bacteriémia.
- Infecciones de pacientes inmunodeprimidos por causas diversas (cáncer, leucemias, linfomas, SIDA)
- E.coli es comensal del colon => lugar estéril (o no habitual) a traves de uretra => infección urinaria
Las causas de las interpretaciones erróneas => no se toma en cuenta al microorganismo como patógeno o se le descarta (como mero contaminante); la omisión o inclusión de una especie en una de las categorías no implica que no pueda ser aislada en otra zona del cuerpo o que en condiciones especiales, pueda producir enfermedad.
Flora normal de la piel, boca y vías respiratorias superiores
- Las principales (en faringe y traquea) => Staphylococcus epidermiditis (coagulasa-), Staphylococcus aureus (coagulasa+) en pequeñas cantidades, Micrococcus spp, Neisseria de especies no patógenas, Estreptococos A-hemolíticos y no hemolíticos, las anaerobias facultativas, Candidas.
- FT/no residente se elimina o se disminuye => pH acido, los ácidos grasos de las secreciones sebáceas, lisozima, el sudor y el lavado diario con jabones desinfectantes; se disminuye de forma temporal => la repoblación es muy rápida.
- Al nacer => la boca y faringe son estériles; tras 12 horas => Streptococcus viridas (las mas abundantes en la boca), posteriormente => estafilococos (S.epidermiditis), diplococos Gram-, difteroides (Corynebacterium); salida de dientes => espiroquetas de Bacteroides, Fusobacterium e Actynomicetes, vibrios anaerobios, Lactobacilos y levaduras; Adulto normal => las principales (mira arriba!!)
- Los bronquios, bronquiolos y alvéolos suelen ser estériles.
Flora normal del tracto intestinal
- Al nacer => estéril, posteriormente => colonizado por microorganismos de los alimentos dependiendo de la dieta (p.ej. la leche materna => Estreptococos y Lactobacilos y el biberón => flora mixta con menos Lactobacilos) .
- Adulto normal => el esófago contiene lo que previenen de la saliva y comida; en el estomago hay poco (pH acido protegen la cólera y salmonelosis - excepto Helicobacter pilori que puede causar ulcera péptida, tiene ureasa que alcalina/neutralizar el acidez: degradar la urea => amoniaco); el intestino delgado superior contiene Lactobacilos y enterococos; intestino delgado inferior (íleon y ciego) contiene la flora fecal; el colon contiene >100 especies 96-99% anaerobios facultativo y estricto => Bacteroides spp, Fusobacterium spp, Lactobacilos/ Bifidobacterium spp, Clostridium spp, cocos Gram+ anaerobios (Peptostreptococcus spp).
- La utilidad/beneficio => sintetiza la vitamina K, transformación de los pigmentos biliares en ácidos biliares, absorción y metabolismo primario de nutrientes.
- La administración de anti-microbianos orales => la posible proliferación de cepas resistentes al anti-microbiano administrado y pueden ser diseminada.
- La administración de ATB por vía parenteral en una cirugía intestinal => necesario para reducir al mínimo posible el numero de microorganismo, evitar trauma en el acto quirúrgico y infección peritoneal e diseminada.
Flora normal de la uretra
- Los mas frecuentes son estafilococos, enterococos, Corynebacterias, Neisserias no patógenas, enterobacterias (la mayoría son pobladores de la piel que recubre esta zona).
- En los cultivos de orina, se deben limpiar con cuidado la zona perineal antes de tomar una muestra.
Flora normal de la vagina
- Al nacer, esta colonizada por Lactobacilos aerobios (produce pH acido), posteriormente el pH acido se convierte en neutro y aparece flora mixta de cocos y bacilos, hasta la pubertad.
- En la pubertad esta colonizada por Lactobacilos aerobios y anaerobios que produce ácidos por su metabolismo de hidratos de carbono => cambio a pH acido (protección a los otros microorganismos potencialmente patógenos.
- En la mujer adulta esta colonizada ademas de los anteriores (Lactobacillus acidophillus - aerobios y anaerobios), estreptococos anaerobios (hemoliticos o no hemoliticos) y otros; el moco cervical contiene lisozima con actividad bactericida.
- En la menopausia la flora vaginal cambia, aparece de nuevo una flora mixta de cocos y bacilos.
- La administración de antibióticos de amplio espectro, puede eliminar las especies protectoras, produciéndose una multiplicación excesiva en la vagina de levaduras (candidas) u otras causantes de vaginitis.
Flora normal de la conjuntiva del ojo
Predomina los difteroides (Corynebacterium xerosis), Staphylococcus epidermidis y estreptococos no hemolíticos; pueden estar presentes otras especies; el control de la flora lo ejercen las lagrimas, por su contenido en lisozima.
Nociones de microscopia (repasar apuntes de 1º curso)
Microscopio – instrumento que permite amplificar la imagen de un objeto o de un ser pequeño (micros: pequeño y scopein: ver); inventado 1610 por Galileo, el primer científico italiano observando el exterior de una abeja o Jansen, el holandés.
Fundamento – Si se sitúa entre el ojo y el objeto un sistema óptico capaz de aumentar el angulo visual, se podrá ver el objeto con mayor amplitud y claridad. El sistema de lentes - produce una imagen aumentada de una muestra diminuta. El objetivo - pequeña lente de proyección que aumenta y proyecta la imagen primaria del objeto hacia el extremo superior del tubo del microscopio (imagen aérea). El ocular (lupa) - aumentando la imagen aérea. La imagen final - se forma en la retina del ojo. La imagen virtual (el ojo percibe la imagen final en el plano virtual).
Aumento – es el numero de veces que se ve el tamaño de un objeto por encima de su valor real. En el microscopio óptico compuesto, se calcula multiplicando el aumento individual del objetivo por el aumento individual del ocular. Objetivo - x4, x10, x40, x100. Aumento óptico ocular - x5, x10
Resolución – la capacidad del microscopio para mostrar los detalles más finos de un objeto. Poder de resolución (limite de resolución o distancia resoluble) – la distancia minima entre dos puntos que permite distinguirlos como tales (la capacidad de microscopio para distinguir 2 puntos separados aunque están muy próximos entre si).
Disminuir la distancia resoluble = aumentar el poder de resolución = aumentar la apertura numérica (AN) = disminuir la longitud de onda de la luz empleada = aumentar el ángulo alpha en el espacio objeto = aumentar el índice de refracción (IR) en el espacio objeto (rellenar el espacio existente entre la muestra y el objetivo con una sustancia de mayor índice de refracción, como aceite).
Numero de campo – diámetro de la imagen observada a través del ocular (en mm).
Profundidad de foco – el espesor de la muestra que es posible tener enfocado por completo >< aumento y AN (apertura numérica) de la lente.
El contraste – para mejorarlo, disminuye el cono de iluminación (se controla mediante el diafragma de apertura) procedente del condensador.
Partes de un microscopio óptico compuesto:
Parte mecánica – sistema de soporte o estático (pie, brazo, cabezal); sistema de ajuste (anillo de ajuste de las dioptrías, tornillo de fijación del cabezal, tornillos reguladores de la platina, tornillo de elevación del condensador, tornillos de centrado del condensador, tornillo de seguridad del condensador, control del diafragma de apertura del condensador, anillos de enfoque macro-métrico y micrométrico, control de ajuste de la claridad/ la luz).
Parte óptica – sistema de iluminación (fuente de luz - lampara halogena de intensidad graduable; condensador - dispositivo que contiene una lente que concentra la luz, generada en la lampara, hacia la preparación; diafragma de apertura - el control adecuado del cono de iluminación que atraviesa la muestra y entra en el objetivo = se ajusta AN); lentes (objetivos - generan imagen real, invertida y aumentada del objeto; oculares - captan la imagen formada por el objetivo y la amplian)
Material necesario para la visualización microscópica – portaobjetos esmerilado y biselado, cubreobjetos 22x22, líquido de inmersión (se usa sin cubreobjetos) es imprescindible cuando se observa muestra desecada con objetivo de 100x (tradicionalmente aceite de madera de cedro, actualmente aceites sintético)
Tipos de microscopios:
Microscopio de campo oscuro – si dentro de la muestra hay elementos transparentes, con un indice de refracción diferente al del medio que los circunda, la luz es difractada e incide sobre el objetivo y pueden ser visualizados; permite la observación de seres microscópicos transparentes y no teñidos (Treponema pallidum – preparación en fresco).
Microscopio de fluorescencia – consta de una fuente de luz muy intensa (lámpara de Hg a alta presión), emite una radiación que puede incidir en la muestra desde abajo, tras atravesar un condensador de campo oscuro (iluminación transmitida); se emplea un tipo especial de liquido de inmersión (glicerina); Tipos de fluorescencia: Fluorescencia primaria - fluorescencia natural (auto fluorescencia) - vitamina A-tiamina, vitamina B-riboflavina; Fluorescencia secundaria - colorantes fluorescentes: auramina (demostrar la presencia del bacilo de Koch en esputos), naranja de acridina (detectar Gardnerella vaginalis en los exudados vaginales; Fluorescencia terciaria inmunofluorescencia - fijación del fluorocromo (colorante) como rodamina y ficoeritrina al elemento investigado (a traves de Ac marcado).
Fuente de luz => Filtro primario => Muestra Fluorescente => Filtro secundario => Luz fluorescente
de exitacion (UV) Observador
Microscopios electrónicos de transmisión (TEM) – una gran amplificación y permite la observación de elementos que son demasiado pequeños como para ser vistos en un microscopio óptico, pero no sirve para observar elementos vivos, a causa del vacío que ha de establecerse dentro del tubo y es muy costoso (solo se usa en lab de investigación). El poder de resolucion en microscopio electronico es x1000 > que microscopio óptico; emplean electrones en lugar de unas fotones; microscopio óptico < 200 nm - fotones: 400 - 700 nm longitud de onda.
Microscopio electrónico de barrido (MEB) – no tiene tanto poder de resolución como el de transmisión, pero sin embargo, proporciona una enorme profundidad de campo y genera unas imágenes que producen una gran sensación de tri dimensionalidad. 1973 se comercializo el 3º modelo que une las caracteristicas de los 2 anteriores (la gran resolucion de los TEM y la gran definicion y contraste de los MEB.
Examen en fresco de bacterias vivas (Gota pendiente) - para conocer la movilidad y la disposición bacteriana en una muestra se debe observar los gérmenes vivos a partir de cultivos jovenes (lleva pocas horas), que permiten visualizar mejor su movilidad y su preparación en fresco.
Condiciones que debe cumplir para este fin:
- cantidad de muestra adecuada (ni mucho ni poco)
- la muestra recogida en condiciones de esterilidad
- adecuadamente distribuida en el portaobjetos (amplia y homogénea)
- cantidad de agua o colorante adecuada
- para la fijación por calor => no debe calentarse demasiado (no quemar el dorso de la mano y la gota +/-consumida) => para hacer tincion
- seguir el método o técnica adecuada, se trabaja con limpieza y orden, evitando cualquier contaminación.
Técnicas para observar los microorganismos vivos - examen en fresco, entre portaobjetos y cubreobjetos, sobre gota pendiente en porta excavado (no lo hacemos) y con tinción vital.
Examen en fresco - suspender el microorganismo en agua destilada o SSF colocandolo en un portaobjetos y posteriormente visualizarlo por microscopio su morfología (cocos o bacilos), disposición/agrupación y motilidad; Material => portaobjetos, microscopio, portaobjetos excavado, cubreobjetos, asa de siembra, mechero Bunsen o de alcohol (para flamear el asa de siembra), muestra de microorganismo problema, agua destilada estéril, vaselina (opcional).
Técnica - Método de examen en fresco entre portaobjetos y cubreobjetos:
- preparar portaobjetos y cubreobjetos limpios y desengrasados
- depositar una gota de agua estéril en el portaobjetos (50ul/lambdas)
- con el asa de siembra esterilizada por flameado, tomar un poco de muestra del microorganismo y suspenderla en la gota.
- homogeneizar la muestra, colocar con cuidado sobre la suspensión un cubreobjetos, evitando que se formen burbujas de aire al caer el cubre sobre la suspensión.
- observar al microscopio con objetivo de 40 aumentos.
Método de examen en fresco sobre gota pendiente en porta excavado:
- colocar en el centro de un cubreobjetos una gota de la suspensión microbiana con una asa de siembra estéril.
- colocar vaselina en los bordes del pocillo del porta excavado
- invertir el cubre sobre el porta excavado, colocandolo encima del área cóncava del portaobjetos.
- la vaselina adherirá el cubre al porta formando una cámara evitando su evaporación y corrientes de aire.
- se invertirá la preparación
- observar al microscopio con objetivo de 40 aumentos.
Resultados - es importante no confundirlos con los movimientos brownianos que se producen cuando se desplaza el medio liquido y hace que todos las bacterias siga dicha corriente en dicha dirección; el sellado con vaselina evita este problema.
Coloración vital - es una técnica intermedia entre los exámenes en fresco y las técnicas de tinción después de fijación previa???; consiste en teñir las muestras bacterianas con colorantes muy diluidos, permite al microorganismo acumular parcialmente dichos colorantes; la dilución debe ser muy altas para que no resulten toxicas para las bacterias, evitando la muerte de tales gérmenes; material => microscopio, asa de siembra estéril, portaobjetos, cubreobjetos, mechero, papel de filtro, una suspensión de muestra problema,
aceite de inmersión, altas diluciones de colorantes para disminuir su toxicidad (rojo neutro en solución acuosa al 1:1.000 o 10 lambas : 10 ml y azul de metileno en solución acuosa al 1:1.000 o 1:500).
Técnica (se puede hacer igual como en fresco) - colocar sobre el portaobjetos limpio y desengrasado una gota de suspensión muestra junto con otra gota del colorante diluido utilizado; mezclar bien ambas gotas con el asa de siembra y colocar el cubre objetos con cuidado para evitar que se formen burbujas de aire; observar al microscopio con objetivo de inmersión; resultados => los microorganismos se visualizaran vivos y ligeramente coloreados de rojo, en el caso de haber utilizado como colorante el rojo neutro o de color azul si se utiliza el azul de metileno.
Tema 12 - Las tinciones en bacteriología
La morfología bacteriana (es incolora) puede ser estudiada por visualización de los microorganismos => vivos sin teñir (observar su posible movilidad) y teñidos mediante colorantes con una concentración que matan la bacteria y no permiten observar su movilidad, pero mejora notablemente la visualización de su morfología y estructuras.
Ventajas de las técnicas de tinción:
- observar mas adecuadamente su morfología y permite diferenciar entre los distintos tipos
- dar información complementaria de sus estructuras internas y/o externas que no se observa en fresco.
- al conocer sus características tintoriales, nos orienta hacia un grupo u otro en la clasificación bacteriana.
Factores que afectan a toda técnica de tinción:
- pureza del colorante (a + impurezas => + error y - calidad en la tinción).
- concentración del colorante (valores ideales oscilan entre 0,2 y 2%)
- pH del colorante (en general son neutro +/- 7 o entre 6,8-7,4)
- conservación del colorante
- elaboración (no lo hacemos /vienen preparadas)
- técnica empleada (material limpios y seguir los pasos de la técnica)
- temperatura (en general la ambiental)
- cantidad de muestra (representativa y homogénea)
- realizar correctamente el frotis (fijarlo bien, en general por calor => coagula las proteinas bacterianas, para que no se arrastre con el colorante mordientes y decolorantes)
- soluciones mordientes (ayudar a fijar el colorante a las estructuras microbianas, p.ej. lugol en la Gram)
- tiempos de tinción (según el colorante que usemos)
Principales técnicas de coloración - clasificación de colorantes => [1] según su origen (naturales y artificiales) [2] según su comportamiento químico (ácidos, básicos y neutros).
Colorantes naturales - extraído de plantas como la hematoxilina (del tronco de una planta que por oxidación produce hemateína; el azul de índigo (de una leguminosa); extraído de animales como el carmin (de una cochinilla)
Colorantes artificiales - preparados artificiales y obtenidos de alquitrán de hulla (colorantes anilina ácidos, básicos y neutros en forma de sales) p.ej. cristal violeta, violeta de genciana, fucsina básica, acido pícrico, azul de metileno, etc.
Colorantes según su comportamiento químico - se unirá de forma mas estable a la estructura que tiñe, dependiendo de su estructura físico-química; constituido por un anillo bencénico que unen distintos radicales => radical cromóforo; a+ numero de radicales => +poder colorante de la solución;
[1] colorantes ácidos o aniónicos: la carga del radical colorante es (-) => colorantes citoplasmáticos que son básicos (los componentes citoplasmáticos captan muy bien los colorantes ácidos) => las eosinas, las auraminas.
[2] colorantes básicos o catiónicos: la carga del ion cromóforo es (+) => colorantes de la zona nuclear que son ácidas o ligeramente ácidas => fucsina básica, cristal violeta o violeta de genciana, azul de toloudina, azul de metileno o las tioninas.
[3] colorantes neutros: es una sal compuesta de un colorante acido y un colorante básico => el eosina azul de metileno; es hidro-solubles (posee las propiedades de colorantes ácidos y básicos).
[4] colorantes indiferentes: insolubles en agua y solubles en alcohol, no predomina ni la carga+ ni (-), pero tampoco es de carácter neutro => colorantes de los lípidos como Sudan III, Negro Sudan, etc.
En bacteriología es frecuente la utilización de => fucsina fenicada, violeta de genciana, azul de metileno (son colorantes básicos) y de añadir un mordiente que ayude a fijar dicho colorante; los colorantes ácidos se utiliza como un contraste y los colorante neutros e indiferente como coloraciones particulares; el proceso de tinción => reacción de intercambio de iones entre colorante y sitios activos de la superficie o del interior de la célula (los iones teñidos/colorantes reemplazan iones de los componentes celulares) y esto permite contrastar mucho mas el germen con respecto al medio que le rodea.
Preparación de un frotis - realizar una extensión y fijar la muestra problema para posterior coloración y visualización al microscopio; poner en un portaobjetos, a traves de un asa de siembra una cantidad de microorganismo problema suspendido en medio liquido estéril, extendiéndolo adecuadamente hasta formar una fina película homogénea que posteriormente se fijara generalmente con calor cuando sea requerido, según el método de tinción que se utilizara posteriormente; material => portaobjetos, asa de siembra o platino, agua estéril, muestra problema; técnica => pequeña cantidad de la muestra liquida se deposita y se extiende homogéneamente en el centro del portaobjetos con el asa de siembra para tener una capa fina (según la viscosidad, se puede diluir con unas gotas de agua estéril); si la muestra es solida (una colonia), se deposita primero una gota de agua estéril y se añade con el asa de siembra una pequeña cantidad de la colonia, se extiende homogéneamente; dejar secar al aire; se fija mediante el flameado (en algunos casos se podrá hacer con alcohol) para coagular las proteínas y los gérmenes quedan adheridos al portaobjetos.
Técnica de tinción - los pasos:
-realizar un frotis y fijación por calor (generalmente), con la intensidad de calor adecuada que soporte el dorso de la mano.
-coloración segun el tipo de tincion (generalmente con colorantes basicos que tiñen estructura acida)
-decoloración que permite diferenciar distintos grupos bacterianos (genero Micobacterium son resistentes a la decoloracion ácida/BAAR); Gram- decoloradas con el alcohol 96º/alcohol acetonas, alcohol acido, acidoclorhidrico => micobacterias
-lavado siempre entre paso y paso con agua destilada para evitar interferencias entre un producto y otro.
-coloración de contraste (generalmente ácido), se aplican al final para las estructuras decoloradas con el decolorante, p.ej. safranina.
-observación al microscopio
Tipos de tinciones bacterianas:
(1) Tinción simple => fijación previa, se utiliza 1 solo colorante, permite la visualización de la morfología y la agrupación bacteriana; clasificación => tinciones simples con colorantes básicos, ácidos y neutros; se basa en => la afinidad de los colorantes que suelen ser de tipo básico (azul de metileno, violeta de genciana, azul de toloudina => 1-2 minutos, dan color azul a las celulas o fucsina fenicada diluida => da color rojo a los componentes celulares.
(2) Tinción negativa => es un tinción simple (1 solo colorante => tinta china o solución acuosa de nigrosina al 1%) con diferencias que no necesita fijación previa (no mata las bacterias), permite observar características estructurales de la bacteria ademas de su morfología sobre un fondo oscuro, como es la presencia de capsulas p.ej. los neumococos; se basa en => colorante acido cargado negativamente, los microorganismos no se tiñen (se quedan claros y brillantes sobre un fondo teñido oscuro); para obtener una capa fina (para dejar pasar el paso de luz del microscopio y evitar a formarse grietas al secarse el colorante) se puede hacer una extensión con el borde de otro portaobjetos; resultado => se observan las capsulas (si las tienen) en forma de un halo mas claro que rodea el cuerpo de la bacteria.
(3) Tinciones diferenciales => fijación previa (en general por calor), se utiliza 2 colorantes (el ultimo es de contraste), permite visualizar su morfología y características estructurales (composicion de la pared bacteriana, su resistencia a la decoloración ácida (t.Gram y t.ZhielNeelsen).
(4) Tinciones estructurales => fijación previa (en general por calor), se utiliza al menos 2 colorantes, nos permite observar su morfología y características estructurales como esporas, flagelos, cilios, capsulas, corpúsculos metacromáticos (utiliza 1 solo colorante???).
Tinción diferenciales de Gram => descubierto en 1883 por Cristian Gram, cuando trabajaba con material de biopsias y utilizada a partir de 1886 como tinción diferencial; es mas empleado en bacteriología, para clasificar 2 grandes grupos (Gram+ y Gram-); distinto comportamiento debido a la distinta composicion de la pared de las celulas bacterianas; se emplea como el primer colorante básico (cristal violeta o violeta de genciana) que teñirá de color azul violeta todas las bacterias, posteriormente un mordiente el lugol que aumenta la afinidad del primer colorante a las celulas (lo fijara), finalmente un agente decolorante que decolora solamente un tipo de bacterias (Gram-) que serán teñidas con el colorante de contraste o segundo colorante (la safranina) de color rosa-rojo; si se quedan con el color azul violeta serán Gram+.
Material de la tinción Gram => portaobjetos, pinzas de madera, asa de siembra, mechero de Bunsen, pipeta Pasteur, asa de tinción (punte), frasco lavador, muestra problema, aceite de inmersión, colorantes para la tinción de Gram.
Técnica:
- realizar la preparación de frotis => extender 1 gota de agua destilada estéril + una colonia de la bacteria problema por la superficie de la portaobjeto
- fijación por el calor, pero no quemar las bacterias
- aplicar el colorante cristal violeta durante 1,5 minuto o violeta de genciana durante 2 minutos
- lavar abundantemente con agua para eliminar el exceso de colorante
- añadir un mordiente, el lugol durante 1 minuto (solución iodoiodura de potasio con OH de 96º o con acetona a 5/1 o con OH 50%)
- vuelve a lavar con agua el exceso
- decolorar con solución decolorante (alcohol 90º)
- lavar abundantemente con agua
- cubrir el portaobjetos con la safranina durante 1 minuto
- lavar con agua para arrastrar los restos de colorantes y dejar secar al aire
- observar con objetivo de inmersión (100x).
Tinción de gérmenes del acido alcohol resistentes (BAAR + criptococo)
A. Tinción de Ziehl-Neelsen
Este método fue desarrollado por Ehrlich en 1882 trabajando con bacilo de Koch y mejorado posteriormente por Ziehl-Neelsen; objetivo => diferenciar del resto, las bacterias tipos BAAR (bacterias acido alcohol resistentes, p.ej. Mycobacterium), debido a su gran cantidad de componentes micólicos (lipoideos y cereos/cera) que forman parte de la pared de este tipo de bacteria (los colorantes convencionales no penetran en el interior de estas bacterias); De ahí se necesitan colorantes altamente concentrados y la presencia de calor que facilite su penetración al interior de dichas bacterias; una vez teñidas, su decoloración posterior no es posible (resiste incluso a decoloraciones ácidas); dicha tinción se emplea principalmente para el diagnostico y estudio de enfermedades como tuberculosis y la lepra.
Material => es el mismo que esta descrito en la tinción simple, pero en cuanto los reactivos: 1º colorante - solución fenicada de fucsina básica (carbo fucsina), 2º colorante de contraste - solución hidro-alcohólica de azul de metileno fenicado, 3º decolorante - alcohol acido al 3% (97% alcohol).
Técnica => preparación de frotis y fijación calor; cubrir el frotis con fucsina fenicada básica 5 minutos aplicando en este tiempo calor, hasta la emisión de vapores, evitando que se caliente demasiado o que se seque el colorante; lavar abundantemente con agua destilada hasta arrastrar el colorante; decolorar con alcohol acido para arrastrar restos del colorante (10-30 segundos); lavar abundantemente con agua destilada; cubrir el frotis con colorante de contraste /azul de metileno fenicado 30 segundos sin necesidad de calentar, para teñir aquellas bacterias que no son resistentes a la decoloración (se han decolorado) y resaltar el color rojo de los BAAR+; lavar, secar, rotular y observar con objetivo de inmersión.
Resultados => con el 1º colorante, BAAR- y BAAR+ (ambas) se tiñen de rojo; con el decolorante, BAAR- se decoloran y BAAR+ no se decoloran; con el 2º colorante (de contraste), BAAR- setiñen de azul y BAAR+ permanecen de color rojo/ acido alcohol resistencia+ (bacilos Mycobacterium y algunos Nocardia)
B. Método de Kin Youw modificado (coloración en frió) Reactivos => 1º colorante: fucsina fenicada (con fenol) de KinYouw, decoloración a 3%, 2º colorante: azul de metileno fenicado (con fenol); técnica => idéntica, salvo para la fucsina de KY, dejamos actuar 5 minutos sin calentamiento; existen otras técnicas de tinción de los BAAR => tinción de auramina o de rodamina que usan microscopio de fluorescencia.
Tinción de espiroquetas (para las espiroquetas)
Tinción estructurales => tinción de esporas, de flagelos, de cilios (similar a flagelos, pero corto y se extiende por todo el cuerpo, como pilis), de corpúsculos metacromáticos y de capsulas.
Tinción especiales => tinción de auramina y de naranjo de acridina.
Metabolismo - conjunto de reacciones químicas que tiene lugar en las celulas vivas; necesitan energía que se obtiene por oxidación (perdida de electrones) de sustancias introducidas en forma de alimentos; la gran mayoría de las bacterias (heterótrofas) se nutren de sustancias orgánicas que proceden de otros seres vivos y otras (autótrofas - cianobacterias) se nutren de sustancias orgánicas que sintetizan ellas mismas a partir de sustancias inorgánicas; 3 etapas en metabolismo =>
1ª-catabolismo/hidrólisis/degradación de sustancias nutritivas => compuestos mas sencillos + energía en forma de ATP (adenosin trifosfato)
2ª-anfibolismo/metabolismo intermedio del producto del catabolismo => compuestos de bajo peso molecular
3ª-anabolismo/metabolismo biosintético de sustancias simples => biosíntesis de macromoléculas /moleculas complejas + gasto de energía.
Enzima - catalizadores biológicos (proteínas); cada enzima afecta solo a un sustrato especifico.
Reducción => captan electro nes.
Catabolismo de hidratos de carbono - oxidación de azucares para obtener la energía es muy importante, aunque también se catabolizan lípidos y proteínas; la 1ª etapa de la degradación de la glucosa => oxidación de esta para formar acido pirúvico (glucólisis); 2 procesos => la respiración (necesita O2) o la fermentación (no necesita O2); la glucólisis (no precisa O2) se produce en 3 vías, en función de la dotación enzimática.
1º vía glucolítico/ ruta de Embden-Meyerhof Parna (EMP) fue descubierto por Pasteur => se obtiene 2 moleculas de ATP mediante fosforilación por cada molécula de glucosa que se oxida; este proceso se puede realizar en presencia o no de O2; a partir de la formación de acido pirúvico, las bacterias que usan esta vía, normalmente utilizan la vía fermentativa para acabar transformando este acido pirúvico en ácidos mixtos; degradación/ hidrólisis de glucosa (6C) => acido pirúvico + 2 ATP (fosforilación) => ácidos mixtos (fermentacion); son 9-10 reacciones químicas con un enzima diferente en cada una; utilizados por las bacterias fermentadoras que poseen deshidrogenasas (Clostridium, Enterobacter, Salmonella)
2º vía de las pentosas fosfato /vía fosfoglucónica (vía HMP) - es una ruta mixta y vía alternativa; este ciclo rompe los azucares de 5 carbonos /pentosas y también glucosa, mediante sucesivas reacciones y produce => pentosas intermedias (precursores de síntesis de ácidos nucleicos y ciertos aminoácidos) de gran utilidad para las celulas; ademas de la glucólisis via EMP, muchas bacterias utilizan HMP como una vía alternativa para la oxidación de la glucosa => produce acido láctico o acido mixto + 1ATP (p.ej. Enterobacterias/ E.coli); esta vía es un híbrido de la vía ED y la EMP, ya que en las primeras etapas, la oxidación de la glucosa es similar a la via ED y en las etapas posteriores es similar a la vía EMP, es decir: proporcionan a las bacterias no oxidativas un medio de oxidar la glucosa a acido pirúvico puro, porque no tienen las enzimas necesarios para comenzar la vía EMP, apareciendo en los sistemas analíticos como fermentadoras.
3º vía de Entner-Doudoroff (vía ED/ vía aerobia => requiere O2) - es otra vía por la cual la glucosa se oxida a acido pirúvico; por cada molécula de glucosa se producen 1 molécula de ATP para ser utilizada por la célula en reacciones bio-sintéticas; esta vía requiere enzimas específicos y solo los microorganismos que las poseen pueden utilizarla sin seguir la vía de las pentosas fosfato ni la glucólisis; los microorganismos que la utilizan son Pseudomonas y Neisseria (aerobio estricto), por carecer de las deshidrogenasas necesarias para oxidar el acido pirúvico al acido láctico u otros ácidos; los hidrogeniones se transfieren al ciclo de Krebs y se acabaran obteniendo agua; oxidación de glucosa => acido pirúvico + 1ATP (no producen acido láctico ni acido mixto)
Respiración - es un proceso fosforilación oxidativa de generación de ATP y se caracteriza por el aceptor final de electrones generalmente es una molécula inorgánica (O2); la glucosa se degrada => acido pirúvico se sigue oxidando por la vía de la respiración o la fermentación (en función del sistema enzimático que tienen) => ATP + CO2 + H2O; durante la respiración, cualquier molécula orgánica puede ser degradada /oxidada con un mayor rendimiento que en la fermentación.
Respiración aeróbica - cuando el aceptor final de Hidrógenos (electrones) es el O2; en la respiración, el acido pirúvico producido por la glucólisis se escinde en 2 partes: una parte se unen con CoA => forman acetil CoA que entra en el ciclo de Krebs donde se liberan electrones y protones (H+); la otra parte para biosíntesis???
Cadena de transporte de electrones (se encuentra en la membrana citoplasmática de las celulas procarióticas y en las membranas internas de las mitocondrias en las celulas eucarióticas) - los electrones se mueven desde los coenzimas reducidos hasta una molécula inorgánica como O2 en la respiración aeróbica o hasta una molécula inorgánica diferente del oxigeno NO3- ion nitrato, SO2-4 ion sulfato, etc.; las moleculas transportadoras de electrones son 3 tipos => [1] flavoproteínas - realizan reacciones de oxidación reducción, [2] citocromos - proteínas con un grupo prostéticos (Fe) en forma oxidada, [3] ubiquinonas o coenzima Q - transportadores no proteicos de bajo peso molecular.
Respiración anaeróbica - cuando el aceptor final de electrones (H-) es una sustancia inorgánica distinta del O2, tal como iones nitratos NO-3, sulfatos SO2-4, carbonatos CO2-3. (Pseudomonas y Bacillus)
Fermentación - proceso que se inicia a partir de acido pirúvico formado en la glucólisis de EMP /HMP, en cual el aceptor final de los electrones es un compuesto orgánico y no requiere O2; características principales => (1) no precisa O2, pero se puede ocurrir en su presencia, (2) no necesita el ciclo de Krebs ni cadena transportadora de electrones, (3) utiliza 1 molécula orgánica como aceptor final de electrones, (4) libera energía a partir de azucares y otras moleculas orgánicas (aminoácidos, ácidos orgánicos, purinas, pirimidinas), (5) libera solamente 2 moleculas de ATP por cada molécula del sustrato inicial, (6) los productos finales pueden ser acido láctico, etanol y CO2, acido propiónico, acido acético, CO2 y agua, acido butírico, etc. (compuesto orgánico); cuando el aceptor final de electrones es el lactato, se producirá acido láctico y en general cuando el aceptor final sean otras sales orgánicas, se formaran ácidos mixtos p.ej. acido succínico, que son responsables de la caída de pH en las pruebas empleadas, para la identificación bacteriana; ademas, las bacterias que tienen la dotación enzimática apropiada, pueden seguir degradando estos ácidos mixtos hasta CO2 y otros compuestos orgánicos; es útil el análisis de los productos finales para identificar así los microorganismos; la mayor parte de la energía producida en la fermentación queda almacenada en los productos finales; las fermentadoras => Streptococcus, Lactobacillus, Clostridium, Escherichia, Salmonella, Enterobacter.
Prueba de la B-D Galactosidasa (ONPG) - se basa en la capacidad que tienen los microorganismos de fermentar lactosa, mediante 2 enzimas => Lactosa Permeasa (esta en la membrana celular y es capaz de transportar la lactosa a traves de ella) y B-D-Galactosidasa (esta en el interior de la célula y es capaz de desdobla la lactosa en glucosa y galactosa).
Clasificación de los microorganismos segun su capacidad de fermentar o no la lactosa:
- fermentadores activos de lactosa en 24 horas (poseen ambos enzimas)
- no fermentadores de lactosa (carecen de ambos enzimas, no degradan la lactosa, no penetra en la célula)
- fermentadores tardíos de lactosa (poseen el enzima B-D-Galactosidasa, permeabilizar la lactosa ligeramente cuando la concentración es alta en 2-15 días).
La aplicación fundamental es la diferenciación de Enterobacteriaceae => Escherichia (+) es fermentadora activo, Proteus (-) es no fermentadora y Klebsiella (+) es una fermentadora tardía de lactosa, es decir lactosa (-) y ONPG (+); para detectar la enzima B-D-Galactosidasa => se utiliza un compuesto similar a la lactosa (orto-nitrofenol): al liberarse al medio alcalino por la acción de BDG produce un color amarillo.
Material => 1 tubo de ensayos estériles, baño maría o estufa a 37ºC, asa de siembra, solución fisiológica esteril, discos de ONPG, microorganismo problema
Técnica => una suspensión densa (con muchas colonias) de un cultivo puro en 0,5 ml de suero fisiologico estéril se añade un disco de ONPG y mezclar durante unos segundos, incubar a 37ºC durante 30-60 minutos (en general se vira antes de 30 minutos)
Resultados => en ONPG+ se produce una coloración amarillo y en ONPG- no se produce color (incoloro).
Principal productor de energía => catabolismo de la glucosa y las oxidaciones de proteinas y lípidos (estan relacionados entre si); la hidrólisis de proteínas/ proteína+agua (mediante enzimas proteolíticos extracelulares, secretadas por ciertas bacterias que sirve para su tipificación/tipación) => polipéptidos y aminoácidos; las pruebas bioquímicas investigan fundamentalmente la capacidad de un microorganismo de producir la hidrólisis de la gelatina; catabolismo de proteínas/ proteólisis se realiza mediante proteinasas/proteasas y peptidasas (desaminación) para obtener => ion amonio NH4+ (+) acido orgánico; acido orgánico entrar al ciclo de Krebs y ion amonio NH4+ es secretado de la célula.
Producción de acido sulfhídrico - técnica con indicador incorporado al tubo/a la placa => algunos microorganismos actúan metabolizando proteínas con aminoácidos azufrados (cistina, cisteina) y liberan azufre en forma de gas acido sulfhídrico SH2; el gas es detectado a traves del medio que contiene fuente de hidrógeno (azucar) fuente de azufre (tiosulfato sodio, cistina, cisteina) y un indicador de pH (sales de hierro /citrato férrico amoniacal) => un precipitado negro); se observara la liberación del gas SH2 por algunos microorganismo que poseen enzimas desulfurasas (activada por la fermentación de la glucosa => acidifica/produce ácidos/baja el pH) que actúan sobre los aminoácidos azufrados; la temperatura de incubación (estufa) tiene que oscilar entre 35-36ºC (superior a 37º se inhibiría la producción de SH2).
Material => tubo de cultivo (KIA/kliger iron agar y TSI/triple sugar iron), agujas y asas de siembra, estufa de cultivo, muestras de problema; si se realiza en placa de cultivo (Hektoen y SS);
Técnica => a partir de un cultivo puro y reciente de microorganismo problema se tomara una muestra con una aguja; sembrar en picadura (tubo de KIA o TSI) o con agotamiento en cuadrante (Hektoen o SS); incubar durante 18-24 horas; si la técnica se realiza con Brucella (microaerofila), se debe incubar con una atmósfera de CO2.
Resultados => SH2 positivo (Salmonela y Proteus) se observa a lo largo de la linea de inoculación ennegrecimiento del medio; SH2 negativo (Brucella y Shigella) no se ennegrece el medio.
Bacteria con enzimas desulfurasas (activada por la fermentación de azucar) + indicador de pH/sales de Fe + fuente de S + (H+) => H2S gas + indicador pH => precipitado negro insoluble/ puntos negros (FeS)
Prueba de las descarboxilasas - enzimas que actúan sobre el grupo carbóxilo de los aminoácidos Lisina, Ornitina, Arginina para formar => aminas (alcalinas) y se desprende CO2 (el proceso se realiza en anaerobiosis) => se realiza mediante el sistema multiprueba (API - buscar el código en el libro); estas pruebas se aplican para la identificación de Enterobacteriaceas; se investiga la alcalinización del medio inicialmente de color purpura, se observara el viraje del color del indicador del pH; la presencia del enzima investigado supondrá la alcalinización del medio (sigue el mismo color como el inicio); cada pocillo contiene indicador de pH y amino acido correspondiente al enzima a investigar; cada descarboxilasa actúa sobre un aminoácido especifico; en cada reacción se desprende CO2 y se alcaliniza el medio:
- L-lisina + LDC/lisina descarboxilasa => Cadaverina + CO2
- L-ornitina + ODC/ornitina descarboxilasa => Putrescina + CO2
- L-arginina + ADH/arginina deshidrolasa => L-citrulina + NH3 (descarboxilación) => Putrescina +CO2
Material => pruebas de API, pipeta Pasteur.
Reactivos => caldo de Moller para descarboxilasas (lleva pequeña cantidad en su composicion una pequeña cantidad de glucosa, peptonas y los indicadores rojo cresol y purpura de bromo cresol, pH6); aminoácidos ensayados en forma L, muestra de problema y papel parafina.
Técnica => se añade una gota del inoculo (suspensión microbiana) en cada pocillo de la prueba de API; se incuba a 35ºC durante 18-24 horas.
Resultados => durante las primeras horas de incubación, el caldo vira a amarillo, por la fermentación de glucosa que lleva el medio; pero si el aminoácido es descarboxilado, el pH vuelve a subir, ya que se forma aminas alcalinas que es de color purpura (descarboxilasa+); si se queda amarillo sera descarboxilasa-; gérmenes con descarboxilasa+ (Escherichia no es 100% descarboxilasa+ de Lisina, Arginina y Ornitina):
- Lisina => Klebsiella, Serratia, Salmonella
- Ornitina => Serratia, Proteus, Salmonella
- Arginina => Salmonella, Pseudomonas
Pruebas oxidasa - esta denominación se le da de forma genérica al enzima citocromo oxidasa que participa en la transferencia de electrones en la cadena respiratoria hacia el oxigeno; oxidasa => enzima que cataliza la transferencia de electrones del sustrato al oxigeno; los aerobios o anaerobios facultativos obtienen su energía por la respiración y la almacenan en forma de ATP, el oxigeno es reducido a partir de un sustrato orgánico que procede de la nutrición con la intervención de un sistema de transporte de electrones denominado cadena respiratoria, produciéndose agua o peróxido de hidrógeno según la especie microbiana; los citocromos son hemo-proteínas que contiene Fe y actúan como ultimo eslabón de la
cadena respiratoria aerobio, transferiéndo H+ al O2 con formación de H2O; este sistema se encuentra en los organismos aerobios y anaerobios facultativos, carenciandolo de ello los anaerobios estrictos; se observara el cambio de color de un indicador de pH incoloro cuando esta reducido (p-fenilendiamina=> formar indofenol de color violeta oscuro) y coloreado cuando se oxida;
Aplicación => detectar en el microorganismo estudiado el enzima citocromo oxidasa; diferenciar entre Enterobacteriaceas (oxi-) de Pseudomonadacea (oxid+); diferencia entre géneros Moraxella (oxi+), Neisseria (oxi+) de Acinetobacter (oxi-).
Material => placa sembrada con microorganismo problema, asa de plástico, papel de filtro, porta, reactivo oxidasa de Kovacs.
Técnica => mezclar una pequeña muestra pura con el reactivo en el papel de filtro que se sitúa por encima de una porta, esperar 30-60 segundos y se observar el posible cambio de color; otra manera: se añade directamente el reactivo oxidasa de Kovacs sobre las colonias de la placa Petri con agar sangre y también en otro medio; si son oxidasa positivo toman un color marrón y en seguida pasan a negro parduzco.
Resultados => oxidasa+ aparece un color purpureo en el papel, si se desarrolla el color a los 10-60" se considera oxidasa retardado positivo, después de 60" es negativo; oxidasa- no se produce color.
Pruebas de catalasa
La catalasa es una enzima que se encuentra en la mayoría de los microorganismos aerobios y anaerobios facultativos que contienen citocromo; es un enzima fundamental que actúa sobre el peróxido de hidrógeno /H2O2 (es un producto final de la degradación aerobica oxidativa de los hidratos de carbono); si se acumula H2O2, estos gérmenes morirían; fundamento: si el microorganismo tiene el enzima catalasa y se pone en contacto con H2O2 => se descompone en H2O + O2; aplicación => diferenciación de Streptococcus (-) de Staphylococcus (+) y Micrococcus (+);
Material => portaobjeto, pipeta Pasteur, asas de siembra de plástico (las de platino catalizará la reacción)
Reactivo => H2O2/ agua oxigenada, microorganismo de problema
Técnica => se coloca una gota de H2O2 (agua oxigenada) en un porta objeto, simultáneamente, con una asa se añade una colonia del cultivo del microorganismo de 12-24 horas, homogeneizar y observar.
Resultados => catalasa+ forma burbujas de O2 inmediatamente; catalasa- no aparecen burbujas; se podrán observar falsos positivos si se utilizaran medios de cultivo agar sangre o otros que lleven hematíes (los hematíes contiene catalasa).
Pruebas de Nitrato reductasa o Nitratasa (se realiza con multiprueba de API)
La nitratasa (nitrato reductasa) es el enzima que cataliza el proceso en cual el nitratos son reducidos a nitritos (presentes en algunos microorganismos anaerobios o anaerobios facultativos que utilizan nitrógeno como ultimo aceptor de electrones en el proceso metabólico/ respiración anaeróbica); depende de la especie bacteriana se trate, se pueden producir diversos productos finales; reacción: nitrato/NO-3 + nitratasa => nitrito/NO-2 => N2 (nitrógeno molecular/ gas nitrógeno) o otros => amoniaco / oxido nítrico / oxido nitroso / hidroxil amina; la prueba detecta los productos finales liberados al medio mediante un reactivo colorimétrico API; aplicación => diferenciación de especies de Haemophilus y Neisserias; cuando no se forma color (rojo) al añadir los reactivos, puede significar => [1] no se ha reducido el nitrato, se comprueba añadiendo polvo de zinc que actúa como reductor y si hay un cambio al rojo, es nitratasa (-) y si no hay cambio de color, sera nitratasa (+); [2] la reducción de nitratos ha sido llevada hasta la formación de N2, se observa con la aparición de grietas o burbujas; [3] la reducción de nitratos ha formado otros productos nitrogenados (oxido nítrico, amoniaco, hidroxil-amina, etc.);
Material => multiprueba de API; reactivo => Nit A y Nit B, Zinc en polvo, microorganismo; el medio no debe contener azufre ya que si el microorganismo es productor de H2S (acido sulfhídrico) este impide la formación de color; técnica => hacemos un inoculo a partir de un cultivo puro reciente de 12-24 horas, inoculamos el medio; incubar a 37ºC durante 12-24 horas, agregar 1 gota de Nit A y 1 gota de Nit B, observar si hay un cambio o no antes de 30 segundos (se interpreta rápido, ya que el color puede desaparecer); si no se forma color, se añade al tubo un poco de polvo de Zinc; resultados => hay 2 posibilidades de que sean Nitratasa+ (Haemophilus y Branhamella Catarallis): [1] cuando aparece color rojo o rosado fuerte al añadir el reactivo A y B que indica la reducción de nitratos a nitritos; [2] al añadir polvo de zink no se desarrolla color indica formación de otros productos nitrogenados; Nitratasa- => cuando se forma color rojo o rosado al añadir polvo de zinc en menos de 30 segundos.
Prueba de Ureasa (se hace en manual y con el sistema API) - detecta la presencia de la ureasa en los microorganismos cuando se observa la alcalinización de un medio liquido; la ureasa cataliza la hidrólisis de la urea => carbonato amónico, que sube el pH, con lo que el medio se alcaliniza; aplicación => diferenciar Proteus (+) de otras Enterobacteriaceas / E.coli (-) o positivo retardado (+) como Klebsiella;
Material => tubos de cultivo, asas, pipeta Pasteur, estufa de cultivo o baño maría.
Reactivo => caldo urea de Stuart/ urea-indol (de color ámbar) y microorganismo de problema
Técnica => con el asa estéril se toma una muestra de cultivo puro reciente 18-24 horas; inoculamos el microorganismo en un tubo con caldo urea de Stuart; incubar 37ºC; la reacción se produce entre 1-4 horas
Resultados => en ureasa (+) el caldo de color ámbar vira a rosa fuerte durante el tiempo de reacción (1-4 horas); en ureasa (-) no vira el indicador; algunas cepas de Klebsiella, Enterobacter, Brucella, requieren 6 días de incubación.
Prueba de Coagulasa (se hace con el kit comercial que contiene Acs anti coagulasa) - observar la coagulacion del plasma en forma de grumos o precipitación al ponerse en contacto el microorganismo con el reactivo (si se utiliza el plasma en la prueba); la coagulasa es un enzima producido por microorganismos capaz de coagular en plasma; aplicación => diferenciar Staphylococcus aureus (coco Gram+, catalasa+, beta hemolítico + y coagulasa+) de otro Staphylococcus; esta prueba solo se hace si el germen es coco Gram+, catalasa+, beta hemolítico +; técnica => (usando el kit comercial /prueba de látex) seguir la instrucción de la casa comercial que hacen el reactivo; resultados => coagulasa+ se observa en forma de grumos (si se utiliza un plasma como reactivo => se observara la formación de un hilo de fibrina en la reacción) y en coagulasa- no se forma grumos.
Prueba de Triptófano Desaminasa (TDA) - se basa en la capacidad que tienen algunas bacterias de desaminar el triptófano por la acción de TDA, produciendo => acido indol pirúvico que reacciona con citrato férrico amoniacal y el cloruro férrico que lleva el medio produciendo un color marrón (determina la presencia de la enzima TDA); técnica => en un medio liquido de TDA (color ámbar); se puede utilizar el reactivo urea-indol; añadimos 1 sola colonia de un cultivo puro y 1 gota de reactivo TDA del API, incubar a 37ºC entre 18-24 horas, y leer; resultado => el color marrón/café indica la presencia de TDA+ y sera negativo si no hay cambio de color; los géneros que tienen TDA+ => Proteus, Providencia y Morganella.
Macrotécnicas - sistemas multiprueba que permiten realizar varias pruebas bioquimicas simultáneamente, facilitando notablemente la identificación del microorganismos:
- Kliger Iron Agar (KIA)
- Triple Sugar Iron (TSI)
- Agar Sulfuro Indol Motilidad (ASIM) Motility Indol Agar (MIA)
- IMVIC
- Lisina Iron Agar (LIA)
- Motilidad Indol Ornitina (MIO)
KIA (Kligler Iron Agar) - se pueden realizar 3 pruebas a la vez:
- utilización de azucares (fermentacion glucosa 0,1% y lactosa 1%)
- producción de gas (CO2)
- producción de acido sulfhídrico (SH2)
Por fermentación de azúcares, se producen ácidos, que se detectan por medio del indicador rojo de fenol, el cual vira al color amarillo en medio ácido. El tiosulfato de sodio se reduce a sulfuro de hidrógeno el que reacciona luego con una sal de hierro proporcionando el típico sulfuro de hierro de color negro.
Fundamento => cuando el microorganismo fermenta los azucares, se acidifica el medio porque se forman ácidos orgánicos; si el medio no tienen azucares como fuente de hidratos de carbono, utilizara proteínas que alcalinizan el medio por la formación de aminas; las proteínas en condiciones de aerobiosis (en el pico) se metabolizan mejor por la vía de descarboxilación oxidativa de los aminoácidos que en anaerobiosis (en el fondo); la glucosa se metaboliza mejor que lactosa (la molécula es mas pequeña/sencilla); para metabolizar la lactosa, el microorganismo debe tener B-D galactosidasa y lactosa permeasa.
Material => tubos de cultivo, asa y aguja de siembra, estufa de cultivo
Reactivo => tubo con agar KIA en pico de flauta (color rojo anaranjado), microorganismo
Técnica => es importante tener un tubo de control; se recoge una colonia puro y joven con un aguja; inocular por picadura y estría un tubo de cultivo con medio KIA en pico de flauta; incubar 18-24 horas a 37ºC; la reacción se ha de observar justo después de terminar el periodo de incubación (suficiente tiempo para la fermentación del azucar); si se lee después de 24 horas, se puede dar un falso alcalino, porque el germen habría utilizado la peptona y el medio se alcaliniza; el pH esta ajustado a 7,4 (neutro) e indicador rojo fenol a 6,8 (cualquier cambio de pH va a virar el medio);
Resultados => se observaran los 3 parámetros: cambios de pH/color, producción de gas CO2 (grietas en el medio/ se desplaza) y producción de acido sulfhídrico SH2 (precipitado negro); siempre se compara con un tubo de control no inoculado.
Cambios de pH - [a] resultado final de la fermentación solo de la glucosa => K/A zona superficial roja (reacción alcalina de las aminas) y zona profunda amarillo (reaccion ácida); después de la fermentación de la glucosa, el medio de cultivo inicialmente es amarillo entero, pero posteriormente la parte del pico se alcalina/rojo (había poca cantidad de glucosa) por la descarboxilación oxidativa de los aminoácidos (que forman la peptona) que se produce mejor en aerobiosis; la fermentación de glucosa en el pico es inicialmente mediante la vía EMP, utiliza tanto para los aerobiosis y anaerobiosis, dando un intermedio clave (acido pirúvico), que a su vez el acido pirúvico es degradado mediante el ciclo de Krebs por los aerobiosis o anaerobiosis facultativos dando CO2 + H2O y ATP; en cambio, en el fondo, el acido pirúvico es degradado hacia acido láctico y acido mixtos que mantiene el pH acido de manera estable.; son características de Morganella, Providencia y Shigella; también P.mirabilis, S.typhimurium, S.enteritidis, S.flexneri.
[b] en la fermentación de glucosa y lactosa => A/A zona superficial y profunda son amarillas (características de E.coli y K.pneumoniae);
[c] no metabolizan ni lactosa ni glucosa (pero si la peptona) => K/K todo el tubo es de color rojo (si se trata de anaerobiosis) o si se trata de aerobiosis, la zona profunda es de color naranja (se alcalina mas la zona con mas O2 => Pseudomonas, P.aeruginosa)
[d] si no se consume ni glucosa, ni lactosa ni peptona => no hay cambio de color en el tubo (gérmenes inertes).
Producción de gas CO2 - aparecen burbujas, agrietamiento o desplazamiento del medio del fondo del tubo, debido a la formación de hidrógeno y de anhídrido carbónico (CO2)
Producción de acido sulfhídrico SH2 - se manifiesta por el color negro de la capa profunda o un anillo negro cerca de la parte superior de la capa profunda o un precipitado negro en la capa profunda (que puede enmascarar la acidificación del medio => fermentación de la glucosa activa la desulfurasas); SH2+ => Proteus y Salmonella.
TSI (Triple Sugar Iron) - identificación de Yersinia enterocolitica como sacarolítica (también Proteus, Lactobacillus y Clostridium), ya que el medio lleva el 3er hidrato de carbono (sacarosa al 1%); los fundamentos y la interpretación de los resultados son los mismos que en el método anterior, pero es imposible saber si el azucar utilizado es uno u otro o ambos.
Agar sulfuro-indol-motilidad/ ASIM o motility-indol-agar (MIA) - tal como indica su nombre, sirve para determinar la motilidad de los microorganismos, la produccion de indol y la formacion de acido sulfhidrico; la forma de realizarla es la siguiente => se siembra en picadura y se incuba a 37ºC durante 18-24 horas; la motilidad se vera por la zona del inoculo con un zig-zag (en la picadura); la produccion de indol se vera con un cambio de color a violeta purpura (el medio es de color violeta clarito); la produccion de SH2 se vera por un cambio a negro.
IMVIC (Indol - Motilidad - rojo de Metilo - Voges-Proskauer - Citrato) - se emplean en la identificación de la familia enterobacteriaceas; se hacen de una en una y conjuntamente;
Prueba de indol => estudia el metabolismo proteico/ la capacidad de degradar el triptófano (aminoácido) y de formar según la bacteria: indol y productos indólicos (escatol, acido indol-acético), mediante triptofanasa (enzima intracelular).
Material => tubos de ensayo, asa de siembra, pipeta Pasteur, estufa de cultivo, mechero.
Reactivo => caldo urea-indol de la casa Biomerieux, reactivo indol de Kovacs, microorganismo.
Técnica => Método de Kovacs: en el tubo con 500 lambdas de reactivo urea-indol, se siembra el microorganismo problema, incubar a 37ºC durante 4 horas, añadir al cultivo 2 gotas de reactivo indol de Kovacs (debe ser siempre fresco), agitar suavemente el tubo y dejar unos segundos en reposo.
Resultado => en indol+, aparece un anillo rojo en la superficie del medio (E.coli); en indol-, no hay cambio de color (Klebsiella pneumoniae)
Prueba de rojo de Metilo => muchas enterobacteriaceas con importancia clínica (E.coli, Proteus mirabilis, Yersinia, Salmonella typhimurium, Citrobacter freundii, Sighella, Vibrio) son anaerobios facultativos, que para tener energía para sus reacciones metabólicas, utilizan la fermentación acido-mixta de los hidratos de carbono produciéndose => acido succínico, acido acético, alcohol etílico (ácidos mixtos); en RM positivo, aparecen un color rojo fuerte en la superficie y en RM negativo, no hay cambio en la superficie del medio.
Material => igual que anterior
Reactivo => Medio de Clark y Lubs en tubo (liquido amarillo), solución de rojo de metilo y microorganismo
Técnica => (a) en el tubo del medio Clark y Lubs se siembra el microorganismo problema (b) actualmente se utiliza la modificación de Barry que es poner un inoculo abundante en 0,5 ml de reactivo de Clark y Lubs y dejar incubar entre 18-24 horas (c) a este cultivo se le añaden unas 5 gotas de indicador rojo de metilo que es rojo a pH 4,5 y amarillo a pH 6,3; el medio cambiara de color cuando el pH sea inferior a 4,5.
Resultados => RM+ superficie del medio rojo fuerte y RM- => color amarillo en la superficie del medio
Prueba de Voges Proskauer (2 microbiólogos) - lo podemos hacer en el API => la fermentación butanodiólica/ butilenglicólica/ acetoínica (acetil metil carbinol) que es una vía alternativa de metabolismo de acido pirúvico, se produce => un metabolito neutro (producto intermediario), en presencia de aire y hidróxido potásico 40%/KOH (por oxidación) se forma => diacetilo y añadiendo alfa naftol, se forma un complejo rojo; por reducción, la acetoína forma => 2,3 butanodiol;
Material => multiprueba API y resto igual
Reactivo => Medio de Clark y Lubs (liquido amarillo), solución de alfa naftol (VP2), solución de hidróxido potásico al 40% o hidroxilo sódico al 40% (KOH), microorganismo problema.
Técnica => en un tubo de ensayo que contenga un medio de Clark y Lubs se siembra el microorganismo problema, se incuba 24 horas a 37ºC, se añade 0,2 ml (200 lambdas) solución KOH 40%, luego 0,6 ml de la solución alfa naftol, agitar e inclinar casi horizontalmente el tubo para que se favorezca la oxidación de la acetoína, reposar el tubo 10 minutos e interpretar los resultados.
Resultados => en VP positiva (+), p.ej. Klebsiella pneumoniae y Enterobacter aerogenes, antes de 1 hora aparece coloración rojo rosada en la superficie del medio; VP negativa (-) p.ej. E.coli y Proteus, la superficie del medio queda de color amarillento o cobrizo (la reacción de los reactivos al mezclarse); la mayoría de enterobacteriaceas en VP dan reacciones opuestas a la reacción de RM (VP+ => RM- o VP- => RM+); las bacterias VP+ producen menor cantidad de ácidos mixtos que serán insuficientes para bajar pH del medio con rojo metilo, por ello, cuando una bacteria es RM- => VP+.
Prueba del Citrato => se investiga la capacidad del microorganismo de utilizar el citrato como única fuente de carbono y sales de amonio inorgánicas como fuente de nitrógeno, por el crecimiento de colonias y el viraje de color del indicador incorporado en el medio causado por la alcalinización; los microorganismos que utilizan el citrato, también utilizan las sales de amonio; citrato sódico es una sal de acido cítrico que es uno de los metabolitos del ciclo de Krebs y algunas bacterias pueden obtener energía por una vía diferente a la de la fermentacion de los hidratos de carbono, utilizando al citrato como única fuente de carbono; la alcalinización del medio es producido por la formación de amoniaco a partir de las sales de amonio que había y la formación de carbonatos y bicarbonatos se debe a la degradación del citrato.
Material => igual que anterior
Reactivos => medio solido de Citrato de Simmons en tubo con azul de bromotimol (agar inclinado) y microorganismo de problema
Técnica => inocular un tubo de Citrato de Simmons con microorganismo mediante escobillón, solo la lengüeta y guardar otro tubo que sirve de control negativo; incubar 24-48 horas a 37ºC dejando los tubos destapados para que se desprenda el CO2, leer los resultados a las 18-24 horas de incubación.
Resultados => en Citrato (+) p.ej. Enterobacter aerogenes, aparece color azul intenso en la superficie del medio y crecimiento de colonias en la lengüeta; en Citrato (-) p.ej. E.coli, no aparece cambio de color (verde) ni crecimiento.
Micro-técnicas
1. Sistema en Tiras (API - Biomerieux)
El material y reactivos necesarios para la realización de estas pruebas se encuentran comercializados en kits; fundamento => los medios deshidratados en micro-tubos se re-hidratan mediante una suspensión de 5 ml de agua estéril con 1 colonia bacteriana y se incuban; el proceso metabolismo del microorganismo, genera cambios del color en el medio de cultivo o al añadir reactivos y esos cambios se interpretan mediante tablas de lectura o ordenadores (se deben seguir rigurosamente las instrucciones del fabricante); principalmente se utiliza para la detección de Enterobacteriaceas, bacterias aerobios no-fermentativas, anaerobios, levaduras, estafilococos; después de utilizar todo debe ser incinerado o descontaminado en autoclave o sumergido en un germicida.
2. Sistemas en Tubos (entero-Tube BBL)
Se utiliza para identificación de Enterobacteriaceas y otras aplicaciones; fundamento => un tubo en forma de lápiz con numerosos compartimentos (normalmente son 8 con diferentes medios, donde pueden leer hasta 11 características); este tubo se inocula (con 1 colonia del medio y alambre de la inoculación atraviesa todas las cámaras) y se incuba, produce cambios de color en cada compartimento; mediante un código numérico o colorimétrico, se puede identificar al microorganismo.
3. Sistema rápidos - metodos automatizados
Cuando las muestras son procesadas a traves de metodos automatizados se logran excelentes resultados en tiempo muy cortos (se deben seguir las normas dadas por los fabricantes);
- Para detección primaria del crecimiento (espectrofotometría infrarroja) => detecta los niveles de anhídrido carbónico (CO2), p.ej. BACTEC
- Para identificación (fotometría) => VITECK (crecimiento, identificación y antibiograma)
Tema 17 - Pruebas de sensibilidad a los anti-microbianos
Antibiograma - estudio de la sensibilidad del microorganismo patológico a los antimicrobianos; se debe hacer antes de establecer el tto de una infección microbiana; diferentes metodos de antibiograma => (1) por difusión que daran resultados cualitativos de resistencia, sensibilidad o intermedios a los diferentes ATB (2) por dilución nos dará resultados cuantitativos en base a 2 conceptos (CMI/ Concentración Mínima Inhibitoria y CMB/ CM Bactericida) (3) por detección enzimática, consiste en detectar la enzima del germen que confiere resistencia a los ATB p.ej. detección de betalactamasa, adenilasa, acetilasa, etc.
Clasificación de las sustancias anti-microbianas:
(a) un microorganismo es sensible => cuando ATB alcanza niveles plasmáticos => a CMI en el lugar de la infección; CMI => la mínima cantidad de ATB capaz de inhibir el crecimiento de un germen; CMB => la mínima cantidad de ATB que mataría al germen; normalmente CMI es suficiente para combatir una infección y los mecanismos inmunitarios se encargan de eliminar el microorganismo, siendo por tanto la CMI es el termino mas utilizado.
(b) un microorganismo es resistente => cuando la concentración máxima de ATB que se puede localizar en el lugar de la infección no es suficiente para eliminar el germen, es decir, la concentración de ATB necesario para destruir el germen no se puede elevar mas por efectos tóxicos secundarios.
(c) microorganismo de sensibilidad intermedia => no esta afectado por dosis normales de ATB dadas a intervalos normales, pero con una dosis alta en el lugar de la infección sin llegar a dosis que produzcan efectos tóxicos, puede eliminar el germen.
Casos clínicos => Pseudomonas que da problemas respiratoria/ urinaria y es resistente a casi todos los ATB, se dará una dosis toxico o una combinación de ATB por vía endovenosa.
Normas básicas => no efectuar un antibiograma directamente del producto patológico, ni tampoco utilizar mezclas de gérmenes (se debe realizar un aislamiento por agotamiento en placa), excepto para muestras de orina ambulatoria (normalmente es una infección mono-microbiana); para elegir un ATB se deberá ensayar aquellos que son útiles clínicamente y se encuentran disponibles en el mercado farmacéutico.
Factores a tener en cuenta => (1) características tintoriales del germen (Gram+o-) (2) lugar de la infección (especialmente las vías urinarias y meningitis); es importante porque es necesario que la CMI sea alcanzable en los líquidos corporales para que sea efectivo (3) bacteria investigada.
La selección de ATB representativo de cada grupo para realizar las pruebas de sensibilidad
Normalmente se selecciona un ATB representativo de cada grupo para realizar las pruebas de sensibilidad; habitualmente se acepta que no es necesario hacer pruebas de sensibilidad para un ATB cuando no se han descrito resistencias en esas especies, p.ej. Streptococcus pyogenes.
1. Betalactámicos => todo el grupo tiene en común que presenta un anilla betalactámico y el mecanismo de acción consiste en inhibir la formación de peptidoglicano de la pared celular; son bactericidas.
a. Penicilinas - tiene espectro desigual => aveces es mas efectivo a uno pero no a otro.
* Penicilina G sodica - la forma oral es P V
* Amoxicilina - infección del tracto respiratorio inferior: bronquitis aguda y crónica, neumonías bacterianas y bronconeumonía, producidas por estreptococo, estafilococo sensible, neumococo y H.influenzae. Gastrointestinal: fiebre tifoidea o paratifoidea. Genitourinaria: cistitis, uretritis, pielonefritis, bacteriuria, gonorrea, aborto séptico, sepsis puerperal. De piel y tejido blando (incluida infección de herida quirúrgica), por estreptococo, estafilococo sensible y E. coli.
* Amoxicilina + acido clavulanico (es un inhibidor de las betalactámasas producida por algunas bacterias)
b. Cefalosporinas - actualmente se ha desarrollado la 4ª generación (semi-sintéticos; bacteriostáticas frente a cocos Gram+ y bacilos Gram-)
* Cefotaxima (indicado para gonorrea; profilaxis quirúrgica; epiglotitis y meningitis por Haemophilus)
* Cefuroxima (efectividad contra Neisseria gonorrheae y otras bacterias productoras de penicilinasa; es activa contra Streptococcus pneumoniae, Staphylococcus aureus, Staphylococcus epidermidis y estreptococo beta-hemolítico; son susceptibles Escherichia coli, Klebsiella pneumoniae, Proteus mirabilis)
2. Derivados de betalactámicos:
* Aztreonam - se utiliza comúnmente frente a las infecciones causadas por Pseudomonas aeruginosa, pero su espectro abarca a las enterobacterias (incluida Escherichia coli), como p.ej. Klebsiella, Haemophilus, Citrobacter y Proteus.
3. Aminoglicosidos => en general su mecanismo de acción es la inhibición de la síntesis de proteína en diferentes fases según el ATB; en general derivan de los hongos y son potentes bactericidas; son de amplio espectro y provocan toxicidad renal y audio vestíbular en alta dosis o a las personas susceptible.
* Estreptomicina (tratamiento de infecciones causadas por gérmenes sensibles, como: Mycobacterium tuberculosis, Salmonellas, enterococos, estreptococos, neumococos y algunos Gram- como Haemophilus influenzae; es eficaz en infecciones del tracto respiratorio)
* Gentamicina (Actúa sobre bacterias Gram- aerobias, incluyendo enterobacteriáceas, Pseudomonas y Haemophilus. Actúa también sobre estafilococos (S.aureus y S.epidermidis)
* Tobramicina (Infecciones del tracto respiratorio inferior como neumonía, bronconeumonía y bronquitis aguda causadas por P.aeruginosa, Klebsiella sp., Enterobacter sp., Serratia sp., E.coli y S.aureus)
* Neomicina (es activo in vitro contra Escherichia coli, Klebsiella y contra flora anaeróbica intestinal)
4. Lincosamidas => inhibe la síntesis proteica
* Clindamicina (es un buen ATB frente anaerobios) - Su actividad antibacteriana es similar a la de eritromicina (macrolidos) en contra de estafilococos y estreptococos; además es efectiva en contra de anaerobios, en especial Bacteroides fragilis.
5. ATB polipeptídicos y glucopeptídicos => su mecanismo de acción es inhibir la formación de peptido glicano de la pared celular (bactericidas)
a. Activos frente a Gram+
* Bacitracina - es utilizado para la identificación del estreptococo del grupo A a cual es sensible; es bactericida; se utiliza tópicamente para infecciones cutáneas (por su efecto de nefrotoxicidad) actúa sobre cocos y bacilos Gram+ (Neisseria y Treponema pallidum)
* Vancomicina - por su alta toxicidad renal y óptica, se reservan para infecciones de Gram+ resistentes; es bactericida; tiene acción ante cocos Gram+ y bacilos Gram+
b. Activos frente a Gram- => ambas (polimixinas) se usan tópicamente sobre Gram-, también se usa como ATB de identificación; tienen acción ante entero-bacterias (excepto Proteus, Providencia y Serratia), Pseudomonas aeruginosa, Vibrio, Pasteurella, Haemophillus y Bordetella; son ATB de segunda elección (para bacilos Gram- resistentes a otros ATB)
* Polimixina B
* Polimixina E (Colistina)
c. Activos frente a Mycobacterium tuberculosis
6. Otros
* Fosfomicina - es un ATB de origen español de un amplio espectro que actúa sobre la pared celular (se usa en infección urinaria)
* Acido fucsidico - actúa sobre la síntesis proteica y destaca su acción sobre Staphylococcus aureus.
7. Tetraciclinas - son bacteriostáticas y su mecanismo de acción es inhibir la síntesis de las proteínas; no se deben administrar a menores de 8 años por tener efecto secundarios sobre la dentición y los huesos; también pueden producir toxicidad sobre el tracto gastrointestinal y el higado; son de amplio espectro; origen biológico o semi-sintético; activas frente a cocos y bacilos Gram+ y Gram- aerobios; son fármacos de elección en brucelosis, cólera, granuloma inguinal (ETS).
* Tetraciclina
* Doxiciclina - es el tratamiento de fiebre tifus, fiebre Q, erupciones pustulosas por Ricketsias y fiebre de las montañas rocosas por Ricketsias, infecciones del tracto respiratorio causadas por Mycoplasma pneumoniae; el tratamiento de infecciones causadas por Gram-: chancroide causado por Haemophilus ducreyi, plaga debida a Yersinia pestis (anteriormente Pasteurella pestis), tularemia debida a Francisella tularensis (anteriormente Pasteurella tularensis), cólera causada por Vibrio cholerae (anteriormente Vibrio comma), infecciones por Campylobacter en fetos causadas por Campylobacter fetus (anteriormente Vibrio fetus), brucelosis causada por especies de Brucella (junto con estreptomicina), bartonelosis causada por Bartonella bacilliformis, granuloma inguinal causado por Calymmatobacterium granulomatis.
8. Cloranfenicol - es de amplio espectro; inhibe la síntesis proteica y es toxica a nivel medular; es de origen sintético, bacteriostático, actúa frente a Gram+ y - (especialmente Haemophilus influenzae y Salmonella)
9. Macrolidos y similares - inhiben la síntesis proteica; amplio espectro; se dan cuando es alérgica a penicilina; son bacteriostáticos y bactericidas en alta dosis.
a. Eritromicina (un buen ATB frente neumónia atípica, legionelosis, difteria, tos ferina)
b. Azitromicina - para tratar ciertas infecciones causadas por las bacterias, como la bronquitis; neumonía; enfermedades de transmisión sexual (ETS); y las infecciones en los oídos, pulmones, piel y garganta; no tienen ningún efecto sobre los resfriados, la gripe y otras infecciones virales.
c. Claritomicina - interfiere la síntesis de proteínas en las bacterias sensibles; faringitis, amigdalitis, sinusitis, bronquitis aguda, reagudización de bronquitis crónica, neumonía bacteriana (adquirida en la comunidad), infección de piel y tejidos blandos leve-moderada, foliculitis, celulitis, erisipela, infección localizada o diseminada por Mycobacterium avium o M.intracellulare, infección localizada por M.chelonae, M. fortuitum y M.kansaii. Prevención de infección diseminada por M.avium complex en pacientes con VIH de alto riesgo
10. Quimioterápicos de síntesis
a. Sulfamidas (es bacteriostático, de origen sintetico; inhibe la síntesis de acido fólico; activo frente Gram+ y -, Clamidias, Nocardia)
b. Trimetropin+sulfametoxazol (cotrimoxazol) - inhibe la síntesis de acido fólico; elimina las bacterias que provocan infecciones, incluyendo las infecciones que afectan las vías urinarias, los pulmones (neumonía), oídos e intestinos
c. Quinolonas (6) - inhiben la replicacioón del ADN bacteriano son buenos ATB de amplio espectro, pero se ha abusado mucho.
d. Norfloxacina - infecciones de las vías urinarias y la próstata; inhibe la replicación del ADN bacteriano. La norfloxacina pertenece a una clase de antibióticos llamados fluoroquinolonas; tomar norfloxacina aumenta el riesgo de que desarrolle tendinitis.
e. Ciprofloxacina - inhibe la replicación del ADN bacteriano; para tratar o prevenir determinadas infecciones bacterianas, también se usa para tratar o prevenir el ántrax (una infección grave que se puede propagar en forma intencional como parte de un ataque bioterrorista) en quienes han estado expuestos a los gérmenes del ántrax suspendidos en el aire; tomar ciprofloxacina aumenta el riesgo de que desarrolle tendinitis.
11. Quimioterapia antituberculosa - actualmente se emplea:
* Rifampicina - ATB sistémico, antituberculoso, bactericida. Inhibe la síntesis de ARN bacteriano. Tuberculosis en todas sus formas (asociado a otros tuberculostáticos). Brucelosis. Erradicación de meningococos en portadores asintomáticos, no enfermos. Alérgicos o con contraindicaciones a otros antibióticos o quimioterápicos. Infecciones causadas por estafilococos (S.aureus, S.epidermidis, cepas polirresistentes) y por enterococos (S.faecalis, S.faecium).
* Isoniacida - para tratar la tuberculosis, y para prevenirla en personas que han tenido contacto con las bacterias de la tuberculosis. Elimina sólo las bacterias activas (en crecimiento). Debido a que las bacterias pueden estar en un período de incubación (sin crecimiento) durante largos períodos, la terapia con isoniazida (y otros medicamentos para evitar la tuberculosis) debe hacerse durante mucho tiempo (por lo general entre 6 y 12 meses).
* Etambutol - el tratamiento de tuberculosis pulmonar; debe ser usado en conjunción con otros fármacos antituberculosos.
12. Quimioterapia antimicótica:
* Nistatina
* Miconazol
* Amfotericina B.
* Fluconazol
13. Quimioterapia anti-viral
* Aciclovir - antiviral activo frente al virus herpes humano, inhibe la replicación de ADN viral, interfiriendo con el ADN polimerasa viral.
* Ribavirina - La ribavirina se utiliza con un medicamento interferón, para tratar la hepatitis C en personas que no han sido tratadas con interferón antes. La ribavirina pertenece a una clase de medicamentos antivirales llamados análogos de nucleósidos. Esta actúa impidiendo que el virus que provoca la hepatitis C se propague dentro del cuerpo.
Pruebas de sensibilidad anti-microbiana - técnicas que investigan la actividad anti-microbiana de distintos quimioterápicos frente al microorganismo estudiado; sus principales aplicaciones:
- contribuir a la identificación de los microorganismos (p.ej. sensibilidad del neumococo/S.pneumonia a la optiquina; del S.pyogenes a la Bacitracina)
- constituye una base fundamental para la instauración de una terapia adecuada.
Son técnicas estandarizadas y se ha demostrado que existe un paralelismo entre los resultados de sensibilidad obtenidos in vitro con los efectos terapéuticos in vivo; la prueba mas utilizada es la difusión en medio solido a excepción de los grandes laboratorios que utilizan sistemas multiprueba o métodos automatizados (Vitec, Pasco...)
Antibióticos - un grupo de compuestos químicos terapéuticamente muy útiles y que antaño se caracterizaban por ser subproductos metabólicos de un microorganismo siendo casi siempre letal para otros gérmenes (p.ej. a los hongos); actualmente la mayoría son sintetizados en el laboratorio; uno de los primeros es descubierto en 1927, cuando Alexander Flemming descubrió la penicilina extrayendo-lo de un hongo (Penicillium notatum) siendo en 1929 cuando efectuó los primero ensayos de sensibilidad anti-microbiana (se contaminaron las placas sin querer por un hongo); en 1939 Rose y Miller intentaron estandarizar las múltiples variantes de los análisis de sensibilidad microbiana por difusión en placa y posteriormente en los años 50, Kirby-Bauer y Anderson estandarizaron la técnica que se utiliza actualmente por difusión en medio solido o en placa.
Los principales pruebas para hacer un antibiograma:
a. Manuales
1. Prueba de dilución en medio solido y liquido
2. Prueba de elución en disco
3. Prueba de detección enzimática
4. Prueba de difusión en medio solido (de Kirby-Bauer)
b. Automatizadas
Términos utilizados en las pruebas anti-microbianas:
- Microorganismo sensible o sensibilidad => es inhibido por un ATB a dosis habituales
- Microorganismo de sensibilidad intermedia => el germen "in vitro" no es claramente sensible al ATB, pero si lo seria "in vivo" incrementando la dosis habitual sin llegar a dosis toxicas
- Microorganismo resistente o resistencia => no es sensible al ATB a dosis habituales y es necesario administrar dosis toxicas
- CMI (cantidad mínima inhibitoria) => es la menor concentración de un ATB capaz de inhibir el crecimiento bacteriano de una cepa dada
- CMB (cantidad mínima bactericida) => es la menor concentración de un ATB con la que no quedan bacterias vivas de una cepa dada
Técnicas manuales de realización de las pruebas de sensibilidad anti-microbiana
a. Pruebas de dilución (es una técnica de centros de investigación /lenta /engorrosas) => se basan en el estudio al unisono de diferentes concentraciones de ATB, lo que les da un carácter cuantitativo en base a los conceptos CMB y CMI; 2 tipos => en medio liquido y solido; se utilizan 10 tubos con gérmenes en caldo nutritivo o agar y a cada tubo se le añade una cantidad prefijada de ATB diluido seriadamente, excepto en el tubo de control; se incuban 18-24 horas a 37ºC y se examina la turbidez que indica crecimiento de gérmenes; en el tubo donde no hay turbidez se ha inhibido el crecimiento de los gérmenes; con estos datos estudiamos la CMI y la CMB de los antibióticos.
b. Pruebas de elución en disco (disolver) => se realiza introduciendo discos de un ATB en tubos con caldo nutritivo; el ATB se disuelve en el caldo alcanzando una concentración final conocida, posteriormente se inocula un volumen de una suspensión microbiana y se sigue la misma metodología descrita antes obteniéndose resultados cuantitativos o cualitativos en base a sensibilidad, sensibilidad intermedia o resistencia (no se utilizan habitualmente).
c. Pruebas enzimáticas de detección => fundamentalmente se detectan las beta-lactamasas; un reducido numero de bacterias son resistentes a las penicilinas y cefalosporinas (ATB B-lactámicos) debido a que producen un enzima (b-lactamasa) capaz de inactivar estos ATB, p.ej. los gonococos, pneumococo y algunos estreptococos; consiste en observar el crecimiento de los gérmenes en presencia de dichos ATB; se toma la colonia sospechosa y mezclar-la con un sustrato que si cambia de color nos indica que la colonia es B-lactamasa (+), por lo tanto es resistente a los ATB B-lactamico; se denomina Prueba de NITROCEFIN.
d. Prueba de difusión en medio solido (antibiograma clásico) => estandarizado desde los años 50 (se hace igual en todo el mundo) por Kirby-Bauer y Anderson en todos sus pasos y es mas utilizado actualmente en forma manual; fundamento => depositar discos impregnados de ATB sobre cultivos de microorganismos en placa; la difusión del ATB a traves del medio produce un halo de inhibición del crecimiento cuyo diámetro sera proporcional a la potencia del ATB dando resultados cualitativos de resistencia, sensibilidad o sensibilidad intermedia a los ATB; material => placas de Petri (9cm), pinzas metálicas estériles o dispensador automático, pie de rey o regla milimetrada, medio Mueller-Hinton, discos de ATB, suspensión microbiana al 0,5 escala Mc Farland (10 elevado 8 u.f.c./ml; escala Mc Farland => el 0,5 se prepara añadiendo 0,5 ml de Cl2Ba 0,04 M a 99,5 ml de acido sulfúrico 0,36M); una placa llena => mas de 10 elevado 6.
Técnica => el medio Mueller-Hinton se vierte en placas con un espesor de 4 mm; la siembra utilizada preferentemente (a) la de Kirby-Bauer: se introduce un escobillón en el inoculo preparado al 0,5 Mc Farland (no tenemos) y se siembra en 3 direcciones y se deja aproximadamente 4 minutos la placa semi-abierta e invertida antes de colocar los discos; (b) la de Barry: se hace una inoculación previa al vertido de las placas, se añaden 0,1 ml del inoculo a 25 ml del medio Mueller-Hinton fundido y se vierte en placa (no se usa mas)
Elección de ATB => se debe seleccionar un ATB representativo de cada grupo excepto en los casos donde existan diferencias significativas en los espectros de actividad o resistencia; los aspectos importantes que prevalecen a la hora de seleccionar un ATB => las características tintoriales del germen (Gram+o-), el lugar de la infección (orina, meningitis) y la bacteria investigada.
Concentración de los discos => tiene que estar perfectamente estandarizada siguéndose las normas de la Federación de Drogas y Alimentos/ FDA => la actividad del disco debe estar entre 65% y 150% y de la OMS => entre 75% y 135%; siempre se debe utilizar un control para controlar la actividad de los discos; en general, se escogen discos con una concentración que producen un halo de inhibición entre 20 y 30 mm para organismos tipificados como sensibles y de menos de 10 mm para los resistentes.
Implantación de los discos (papel de filtro grueso de un diámetro 6mm que van impregnados con una concentración determinada de ATB); Manual => se saca el disco de ATB con unas pinzas estériles y se deposita en la placa, la distancia mínima entre los discos es de 24 mm para evitar la superposición de los halos, deben estar situados a 15 mm del borde como mínimo (se colocan 8 discos) una vez depositado el disco se presiona ligeramente con la punta de pinzas; Automática => se utilizan dispensadores automáticos que son unos dispositivos de plástico del tamaño de una placa de Petri con unos orificios guía que permiten la colocación simultanea de todos los discos en el lugar adecuado, y con una pinza se presionan ligeramente los discos para que al girar o invertir la placa no se caigan los discos.
Incubación => 18-24 horas a 35-37ºC (máximo 48 horas)
Lectura e interpretación del antibiograma => los resultados se expresan según el halo de inhibición que aparece alrededor de cada disco; el halo se mide con una regla calibrada o pie de rey midiendo los diámetros, y según cual sea clasificaremos al germen como sensible (la dosis habituales es eficaz), intermedio (se deben incrementar las dosis habituales sin llegar a dosis toxicas) o resistente (ATB es totalmente ineficaz);
Observación al método:
1. preservar la estandarización en todos sus pasos
2. puesto que la difusión del ATB es casi instantánea no debe moverse ningún disco una vez que se ha puesto en contacto con la superficie del agar
3. los discos se tienen que conservar en la nevera
4. procurar que la lectura se haga a las 18-24 horas, evitándose el exceso de incubación
5. Aunque el medio elegido es el Mueller-Hinton, se pueden emplear medios enriquecidos como AS (estreptococo), agar chocolate (Haemophylus) para gérmenes exigentes
6. de vez en cuando hay que colocar controles de calidad
7. cuando el germen sea anaerobio el método es diferente
Método automatizados de identificación y susceptibilidad - actualmente existen diferentes metodos automatizados para realizar el antibiograma; los mas utilizados se basan fundamentalmente en la medida bien fotométrica o bien turbidimétrica del efecto de un ATB sobre el crecimiento de una bacteria en medio liquido comparándolo con el de la misma bacteria en un medio sin ATB; otros metodos se basan en técnicas de impedancia eléctrica microcalorimetría bioluminiscencia, radiometría ...
Los metodos fotométrico y turbidimétrico p.ej. sistema Vitec, se resume:
- se utilizan unas tarjetas desechables del tamaño de un naipe donde se inyecta la muestra ya diluida mediante un modulo inyector; la tarjeta presenta unas perforaciones donde lleva incorporadas diferentes medios selectivos liofilizados;
- la tarjeta se sella y se coloca en un modulo incubador y de lectura, leyéndose de manera automática los resultados cada hora; los datos los almacena un ordenador que los compara con valores umbrales ya almacenados; el ordenador puede dar resultados a las 4 horas (lo normal entre 4 -13 horas)
El sistema Microscan utiliza un sistema semejante al de dilución en caldo pero en miniatura utilizando paneles con caldo de Mueller-Hinton deshidratado (como API); tras la inoculación y re-hidratación con una suspensión estandarizada del microorganismo y su incubación a 35ºC por un mínimo de 16 horas, la CIM o una sensibilidad cualitativa (sensible, intermedio o resistente) para el organismo en prueba se determina observando la menor concentración ATB, que muestre inhibición de crecimiento; esta detección puede hacerse manualmente mediante un visualizador de micro-dilución o mediante un lector conectado a un ordenador; viene en tripletes de un ATB con diferentes concentraciones.
Agentes antimicrobianos (ATB) activos frente a Gram- => Cefuroxima, Cefotaxima, Colistina, Tobramicina, ; frente a Gram+ => Eritromicina, Tetraciclina, Vancomicina, Meticilina, Clindamicina, Doxicilina; frente a ambos Gram+ y - => Ampicilina, Cefalotina, Gentamicina, Cotrimoxazol, Cloranfenicol, Imipenem, Amoxicilina+acido clavulonico.
Clasificación de los antibióticos según su efecto bacteriano
Bactericidas => Penicilinas, Cefalosporinas, Aminoglucósidos, Rifampicina, Quinolonas, Monobactámicos, Polimixinas.
Bacteriostáticos => Tetraciclinas, Eritromicina, Sulfonamida, Novobiocina, Cloranfenicol
Clasificación de los antibióticos según su mecanismo de acción sobre la estructura bacteriana
I. Inhibición de la síntesis de la pared celular
Penicilinas
Cefalosporinas
Vancomicina
Fosfomicina
Tercoplanina
Bacitracina
II. Lesión en la permeabilidad de la membrana celular
Poliomixinas
Colistinas
Nistatina
Anfotericín B
III. Inhibición de la síntesis proteica
Cloranfenicol
Tetraciclina
Aminoglucósidos
Lincomicinas
Eritromicina
IV. Inhibición de la síntesis de ácidos nucleicos
Quinolonas
Sulfonamidas
Rifampicina
Trimetropín
Nota: (*) Penicilina semisintética resistente penicilinasa
Mecanismo de la función renal:
- Filtración glomerular => filtra el plasma desde los capilares que lo envuelven hasta la capsula de Bowman.
- Reabsorción tubular => el producto de la filtración glomerular se modifica su composicion al atravesar la red tubular.
- Secreción tubular => transporte de sustancias, desde la red capilar hacia los túbulos renales; destaca la secreción activa de iones H+, que permite la regulación del equilibrio acido-base en el organismo.
Procedimiento de la recogida de muestra (el personal facultativo determina el tipo de muestra necesaria para el análisis) => informar a la persona del objeto del análisis; indicar el tipo de muestra deseada; orientar acerca de la técnica de obtención de la misma; indicar las pautas de almacenaje y transporte adecuado (si se toma fuera del laboratorio); insistir en la importancia de la limpieza en general y de la higiene antes de la recogida (evitar la contaminación involuntaria); describir el tipo y características mas adecuadas del recipiente a utilizar; tener en cuenta la capacidad del paciente para evacuar la vejiga de forma voluntaria y la necesidad de utilizar técnicas invasivas para obtener la orina en condiciones adecuadas.
Tipos de análisis de orina => análisis elemental, completo, rutinario, anormales y sedimento.
Análisis general de una muestra de orina:
- Físico/macroscópico => cantidad, aspecto/turbidez, color, olor, densidad, pH
- Químico/anormales => proteínas, glucosa, cuerpos cetónicos, sangre/hemoglobina, bilirrubina/ pigmentos biliares, urobilinógeno/ urobilina, nitritos
- Microscópico => estudio de estructuras cristalinas/cristales y de formas amorfas en suspensión, estudio citológico, estudio bacteriológico.
- Microbiológico => urinocultivo, identificación del germen (pruebas bioquímicas), ATB (antibiograma).
- Parasitológico => técnicas especificas de visualización macroscópica de parásitos; estudio microscópico de parásitos en la muestra de orina: parásitos enteros o parte de ellos, huevos, formas de resistencia (quistes).
El orden cronológico de un análisis general => características físicas macroscópica - sedimentación (a 1500 rpm durante 10-15 minutos) - pruebas bioquímicas (tiras reactivas); la muestra sobrante se debe guardar hasta que la analítica haya concluido; hay que revisar los resultados del sedimento concuerdan con las pruebas químicas y comprobar las anomalías detectadas han sido confirmadas.
Examen físico - macroscópico
Pruebas bioquímicas cuantitativas
Examen microscópico de orina - sedimento urinario - estudio de elementos o estructuras de origen y composicion variados que aparecen suspendidos en la orina que proporciona ayuda para el diagnostico y evolución de las enfermedades renales; la muestra debe examinarse antes de transcurridas 3-4 horas desde su recogida (algunas estructuras como celulas y cilindros se lisan fácilmente; obtención del sedimento: homogeneizar bien la muestra, verter 10 ml en un tubo de centrifuga (fondo cónico), centrifugar a 1500 rpm durante 10 minutos; decantar el sobrenadante (quedando solo 1 ml), re-suspender el sedimento residual, montar un fresco (una gota entre porta y cubreobjetos, evitando la formación de burbujas), observar al microscopio a 40x, intensidad lumínica media y condensador a media altura; también se puede observar a 10x en el perímetro de cubre si hay los cilindros hialinos.
Estructuras organizadas
- Hematíes: pueden proceder de cualquier parte del sistema renal; en gran numero indica infección, traumatismos, neoplasias y litiasis renal; presencia normal de 1-2/campo o como una contaminación menstrual; pueden confundirse con levaduras y cristal de oxalato cálcico monohidratado; con tinción Gram se diferenciar => los hematíes son teñidos de rojo, levaduras de violeta y cristales incoloros; es importante distinguir entre macro-hematuria (se ve en el sedimento de color rojizo) y micro-hematuria (únicamente se detecta al microscopio), también si el color rojo observado macroscópicamente procede de hematíes o Hb (al centrifugar el sedimento, el color rojizo de Hb permanece).
- Leucocitos (neutrófilos): pueden proceder de cualquier parte del sistema renal; >50% de ellos se lisan al permanecer mas de 2-3 horas a temperatura ambiente; presencia normal de 1-2/campo (varón) y 1-3/campo (mujer); cifra superior de normal en el sedimento => piuria (>5 leucocitos/campo indica => infección renal en cualquier nivel);
- Espermatozoides: formados por 2 partes cabeza y cola; frecuente en un sedimento del varón (eyaculaciones recientes, poluciones nocturnas, etc.), y en mujer después de haber mantenido relaciones sexuales.
- Bacterias: la composicion de orina es un excelente medio de cultivo para los microorganismos; la mayoría de ocasiones son fruto de una contaminación de la flora saprofita alojada en zonas próximas al meato urinario => anal, perineal, vaginal (sobre todo en mujeres); su presencia en el sedimento, no debe ser tenida en cuenta salvo que vaya acompañada de piuria (aumento de leucocitos).
- Levaduras: su presencia en la gran mayoría debido por una contaminación, salvo acompañada de una piuria; en personas diabéticas, debido a la glucosuria, parecen facilitar el crecimiento micótico; su identificación es sencilla, por su forma ovoidea, frecuentemente con presencia de celulas en gemación; su tamaño es ligeramente mayor que los hematíes (pueden confundirse); su aumento en la orina se trata de vaginitis causada por Candida albicans.
- Parásitos: (1) Protozoos: normalmente se trata de Trichomonas vaginalis (frecuente en sedimentos de mujeres con vaginitis que puede ser asintomático y mas raro en los de hombres); aspecto piriforme de mayor tamaño que los leucocitos y una gran motilidad (por sus flagelos); su identificación es mas complicada cuando la motilidad esta mermada (al ser de un tamaño semejante al de los leucocitos); la piuria que le acompaña puede hacer pensar (erróneamente) en una infección bacteriana y se descarta esta posibilidad al obtener urocultivos negativos;
(2) otros parásitos: su aparición es siempre el resultado de una contaminación de la muestra de orina con materia fecal;
Celulas epiteliales: el árbol urinario esta revestido por 3 tipos de epitelio => (1) columnar /tubular /renales /cuboideo (capsula de Bowman, túbulos distal, proximal y colector) (2) transicional o urotelio (pelvis renal, uréteres, vejiga y uretra) y (3) escamoso (uretra y vejiga); una escasa descamación es normal, pero se puede aumentar por causas => microorganismos, productos químicos, cuerpos extraños, procesos degenerativos, procesos invasivos-destructivos.
- Celulas tubulares /renales /cuboideas: son de tamaño 1/3 mayores que los leucocitos; su forma normal es redonda con núcleo grande y céntrico; un sedimento normal 0-1/campo; aumentado en pielonefritis y glomerulonefritis.
- Celulas de transición (segunda capa de vejiga): el epitelio transicional es pluriestratificado (3 capas => basal, intermedia y superficial); las celulas son de tamaño 2-4 veces mayor que leucocitos; su forma es redondeada, piriforme o raqueta con un núcleo pequeño; un sedimento normal 0-2/campo; su aumento exige un estudio citológico mas completo (p.ej. tinción de Papanicolau), por posibilidad de un carcinoma en cualquier punto entre la pelvis renal y la vejiga.
- Celulas del epitelio escamoso: son planas y tienen abundante citoplasma con nucleo centrico y pequeño; a veces sus bordes aparecen doblados, replegados; un sedimento normal 0-1/campo.
Cilindros: se forma en túbulos colectores y distales; es un resultado de la consolidación de las proteínas en los túbulos de las nefronas; es normal encontrarse algunos (sobre todo hialinos) en el sedimento; se desintegra en la orina a pH alcalino y en presencia de bacterias (con ureasa); la matriz de todos ellos es una muco-proteína (Tamm-Horsfall) segregada en la orina; causantes de su formación => (1) disminución del pH de la orina, (2) aumento de la densidad o concentración de solutos, (3) un grado de estancamiento de la orina (disminución del filtrado glomerular); el lugar de la nefrona en que se forman, determina su tamaño y forma => cilindros estrechos (contorneados) proceden de los túbulos distales y cilindros anchos se originan en los túbulos colectores.
- Cilindros hialinos: se pueden encontrar en grandes cantidades en orinas normales (deshidratación y estrés físico) y también en nefropatías; su aparición en el sedimento no tiene significación clínica (1-2/campo); para visualizar su escasa refringencia, hay que evitar un exceso de iluminación; normalmente sus contornos se aprecian con suficiente nitidez y uno de sus extremos es romo (un dedo de guante); existe también cilindros granulo-hialinos, muy semejante a los hialinos, pero con algunas incrustaciones en su estructura (sin significación clínica);
- Cilindros granulosos: predomina la estructura granular y desaparece el aspecto hialino; 2 tipos => cilindros granulosos finos (semejante a los hialinos en tamaño y forma; tienen mayor refringencia debido a la masiva pequeños gránulos de inclusión) y cilindros granulosos gruesos (estructura totalmente diferente a los hialinos; son de mayor tamaño, aspecto rígido y mayor refringencia; sus borden son contrastados y angulados; en orina normal 0-1/campo; el aumento de su presencia indica una nefropatía.
- Cilindros celulares: la presencia de ellos en la orina nunca es normal; tipos:
(1) Epiteliales - la matriz del cilindro engloba celulas epiteliales que se han desprendido de la luz tubular; gran variedad de nefropatías, lesiones del epitelio tubular (debidas a diversos tóxicos industriales, medicamentos y virus) puede causar la formación de este cilindros.
(2) Hemáticos (eritrocitarios) - aparecen en sedimentos con hematuria; es un signo de lesión a nivel del parénquima renal (vasculares o pielonefritis); la cantidad de estos cilindros suele ser escasa y dificulta su localización.
(3) Leucocitarios - fácil de reconocer porque los leucocitos presentes en su matriz se conservan estables durante el trayecto por los túbulos; su presencia normalmente acompañada por piuria intensa e indica infección localizada en el parénquima renal (pielonefritis) o lesiones de tipo inflamatorio (glomerulonefritis aguda).
(4) Bacterianos - se parecen a los granulosos toscos; generalmente unidos a piuria y muy probablemente se trate de una pielonefritis.
- Cilindros grasos: cilindros granulosos o celulares con pequeñas inclusiones lipídico (gotitas de grasa); muy refringentes y tonalidad amarillenta donde se localizan dichas inclusiones; indica una nefropatía todavía no manifestada.
- Cilindros céreos: son muy refringentes, rígidos, de apariencia dura, superficie rugosa y brillante (como la cera de las velas), los extremos angulados y generalmente de gran tamaño; su presencia es un síntoma claro de una alteración renal importante; suelen estar inmersos en una cilindruria (presencia de la mayoría de los diversos tipos de cilindros).
Estructuras no organizadas
Cristales: en general son productos finales del metabolismo que adoptan formas cristalinas según la condiciones físico-químicas de la orina (la pH sobretodo, densidad, temperatura, etc.) y se excretan a nivel urinario; se diferencian en 3 grupos:
(1) Cristales endogénos normales - no corresponden a alteraciones metabólicas ni funcionales, muy frecuente en el sedimento y pueden aparecer en orinas recién emitidas.
(2) Cristales endogénos patológicos - reflejan trastornos metabólicos o afectación grave de algún órgano o sistema y muy raras veces aparecen en orina.
(3) Cristales exógenos - aparecen en la orina tras la introducción en el organismo (vía enteral o parenteral) diversas sustancias (contrastes radiológicos/ contraste radiopaco vía endovenosa y medicamentos p.ej. sulfonamidas, etc.)
- Cristales de acido úrico: en orinas ácidas; son birrefringentes; de formas variadas (p.ej. agujas); color entre marrón rojizo, el amarillo e incluso incoloros; indica una situación patológica o concentraciones elevadas de acido úrico; un sedimento normal 0-2/campo.
- Cristales de oxalato cálcico mono-hidrato y di hidratado: en orinas ácidas y ligeramente neutras; menos frecuente; de forma prismas incoloros -casi nunca aislados- unidos por un punto intermedio (pesas de gimnasia), la mas frecuente es de forma sobre; también los hay de forma redondeados, finamente estriados, incoloros y con una depresión central (radios de bicicleta); un sedimento normal 0-2/campo.
- Uratos amorfos: en orinas ácidas; se presentan como un precipitado amorfo, coloreado debido a la presencia de pigmentos urinarios de color amarillo-naranja (color ladrillo); no tiene mucha importancia clínica.
- Cistina: en orinas ácidas; tiene significación clínica por si solos => aparecen como consecuencia de cistinuria; aspecto incoloro con forma de placas hexagonales, regulares finas y transparentes; es imprescindible una vez observados en el sedimento, confirmar la concentración de cistina en la orina.
- Leucina y tirosina: en orinas ácidas; raramente se observan; son productos finales del metabolismo proteico y suelen aparecer juntos en situaciones clínicas graves => destrucción o necrosis tisular importante, fundamentalmente de tejido hepático (hepatitis, cirrosis, etc.); los cristales de tirosina forman manojos de agujas finas y los de leucina son como gránulos esféricos de estrías radiales y concéntricas, de aspecto oleoso o graso y muy refringentes; ambas son de color amarillo o marrón.
- Cristales de bilirrubina: en orinas ácidas; de pacientes con bilirrubinemia (bilirrubina alta en sangre); de forma agujas con color marrón-rojizo (flecha verde).
- Uratos amoniacos: en orinas muy alcalinas; de color amarillo/marrón muy intensa; predomina la forma esférica de distinto tamaño; no tienen mucha importancia clínica, pero pueden estar asociados a infecciones del tracto urinario, por bacterias con ureasa+.
- Carbonato cálcico: en orinas alcalinas o neutras; no es frecuente y no tiene mucha importancia clínica (procedencia de ingesta vegetales); de forma amorfo o granular, en ocasiones como pequeños lazos y raramente como pequeñas esferas incoloras;
- Fosfato cálcico (hipurato cálcico): en orina alcalina o neutra; no es frecuente; de forma prismas largos y afilados (agujas), en ocasiones se agrupan formando rosetas o estrellas, también como placas granulares, amorfas e incoloras (similares a acido úrico); no tiene mucha importancia clínica, pero puede ser ligada a hipertrofia de próstata o algunas infecciones urinarias crónicas; cálculos urinarios contienen fosfato cálcico.
- Fosfato triple (amónico-magnesico-cálcico): frecuente en orinas alcalinas o neutras; de forma tapa de ataúd, aunque también puede verse como octaedros (muy variable); no tiene mucha importancia clínica.
- Cristales de creatina: raramente encontrados en orinas de adultas, pero es frecuente en orinas de niños y niñas antes de la pubertad; es un metabolito de la degradación endógena del tejido muscular (su aumento => distrofias musculares, poliomielitis, etc.); de forma pseudo-hexagonal característica.
- Fosfato amorfo: en orinas alcalinas; de semejante forma a uratos amorfos, pero de color blanquecino.
Informe del sedimento urinario
1. debe preceder por el estudio de "anormales" en orina (tiras reactivas => pH, densidad y características patológicas)
2. deben observarse al microscopio optico (40x) al menos 10 campos.
3. debe proporcionar una visión del valor medio de cada elemento o estructura, obtenido en todos los campos observados.
4. debe ser "escueto" y "conciso" (solo hay que poner lo verdaderamente importante)
5. debe seguirse un orden => hay que informar primero el examen realizado de citológico, segundo el de químico y por ultimo el de microbiológico.
Examen citológico:
- celulas hematológicas => se redactan con números y abreviaturas (p.ej. 6-8 L/C = no.leucocitos por campo); se informa si existe piuria y hematuria y si se forma acúmulos.
- celulas epiteliales => se redactan con adjetivos: escasas (algunas 1-3) - moderada (3-4) - abundante (6-8) - intensa (muy abundante 10-12); las importantes son las renales y las de transición; las celulas escamosas (de las vías bajas), se informan cuando son abundantes.
- cilindros: se redactan al igual que las celulas; es importante identificarlos e indicar en el informe el tipo de cilindro.
Examen químico (en un sedimento de orina normales, es frecuente no incluirlos en el informe):
- cristales => se redactan con adjetivos; cuando son muy abundante, se habla de "diatesis".
- compuestos amorfos => se redactan con adjetivos
Examen microbiológico:
- bacterias => se redactan con adjetivos; es necesario especificar el tipo de m.o. y su movilidad
- levaduras => se informa con adjetivos.
Examen microbiológico de una muestra de orina - en condiciones normales carecen totalmente de flora bacteriana; la infección del tracto urinario es frecuente y la mayoría de m.o. patógenos proceden de la flora intestina => Bacilos Gram- (E.coli, Proteus spp, Pseudomonas aeruginosa, Klebsiella pneumoniae); Cocos Gram+ (Streptococcus grupo D y Staphylococcus); Levaduras (Candida spp.); la toma de muestra debe ser obtenida en condiciones asépticas en un recipiente estéril, evitando en todo momento la contaminación; el paciente debe ser instruido de la forma mas adecuada.
Análisis de microbiológico (urinocultivo)
1. Preparación de un "inoculo"
2. Sembrar en medio Cled (la ausencia de electrolitos, impide la invasión por proteus); McConkey (un medio selectivo y diferencia para m.o. Gram-); agar Cetrimide (eficaz para la búsqueda de pseudomonas)
3. Incubar a la temperatura optima de crecimiento de los m.o. buscados (generalmente a 37ºC)
4. Realizar el recuento tras la incubación (presumible-mente han crecido los causantes de la infección) => menos de 10.000 mo/ml de orina es negativo; mas de 100.000 mo/ml hay infección urinaria; entre 10.000 y 100.000 mo/ml el diagnostico es incierto; puede haberse infección no detectada por causas => un tratamiento ATB instaurado, una obstrucción a nivel de las vías renales o la muestra recogida por una punción supra-púbica (sin pasar por la uretra, donde esta la infección).
5. Una vez determinada la infección, hay que resembrar en medios selectivos, para proceder la identificación (tipación) del germen causal de la misma.
Tema 18 - Cocos aerobios y anaerobios facultativos (patología e identificación)
Gram+ => Micrococaceae (Staphylococcus - Micrococcus - Stomatococcus - Planococus); Streptocococeae (Streptococcus - Pediococcus - Gemella - Aerococcus); Peptococaceae
Gram- => Neisseriaceae (Neisseria - Branhamella - Moraxella)
Staphylococcus => cocos Gram+ inmóviles, aerobios y anaerobios facultativos, tamaño +/- 1 um; en forma de racimos, catalasa+, gelatinasa+, nitratasa+, fermentadores de muchas azucares (via EMP); no capsulados y resiste al calor; crecen en medios generales y medios con alto contenido de NaCl (halófilo); resistentes a agentes externos, distribuidas ampliamente en la naturaleza, flora normal de las mucosas y la piel, causante de la intoxicaciones alimentarias, heridas, etc.
Especies importantes (existe >25 especies y varios sub-especies/ cepas)
(1) S. aureus (saprofito de >40% de fosas nasales y 10% de vaginas) => estafilococo dorado (pigmento amarillo); coagulasa+; fermenta el manitol; sensible a la novobiacina.
- 30 Ags (propiedades antifagocitarias y producen estructuras piógenas/ características en las lesiones: polisacárido A es el mas importantes - inducen la formacion de Acs; proteína A - un potente agente antigénico) => se subdividen en tipos según sus caracteres antigénicos;
- Produce toxinas (hemolisinas - lisan eritrocitos y leucocitos; t.exfoliativa/ exotoxina - causa eritemas en la piel; leucopidinas - destruyen pmn y macrófagos; enterotoxina - anula la acción del jugo gástrico y actúa en el centro del vomito, nauseas y diarreas);
- Fermentos/enzimas (coagulasas - activa la protrombina; fibrinolisinas o estafiloquinasas - activador del plasminógeno; penicilinasas o beta-lactamasa - romper el anillo b-lactamico de las penicilinas creando resistencia);
- Hemolisinas alfa - provoca hemólisis beta en AS; hemolisina beta - provoca hemólisis alfa en AS;
- Enterotoxinas tipo A, B (causan intoxicaciones alimentaria) y D causa enterocolitis;
La acción patogena directa => procesos inflamatorios, forunculos, supurativos y de necrosación (en heridas y quemaduras); indirecta => afecta al tubo digestivo por la entero-toxina (gastroenteritis con nauseas, vómitos y diarreas, duración 1-2 días, se trata con sueros orales o anti-diarreicos); la bacteria no llega al intestino (solo su toxina), por eso no se encuentra en las heces; crece muy bien con la temperatura veraniega y en las cremas; infección generalizada (septicemia) => formación de coágulos o trombos intravenosos, artritis, pleuritis, endocarditis, osteomielitis o meningitis en los debilitados (periodo de incubación 1-6 horas).
(2) S.epidermidis y (3) S.saprophyticus son estafilococos oportunistas; distribuidas en el medio ambiente, la piel y mucosas; son patógenas en debilidad; S.saprophyticus puede tener pigmento dorado y puede fermentar Manitol; S.epidermidis sensible a la novobiocina (lo que le diferencia a S.saprophyticus).
Aislamiento de los estafilococos:
- Muestra procede de las heces => medios selectivos Chapman, ricos en NaCl (carácter halófilo), contiene manitol (diferencia S. aureus del resto de Staphylococcus); Otros tipos de muestras => medio AS (observar características de las colonias - color, hemólisis, etc).
Pruebas bioquímicas:
- Los estafilococos degradan muchas azucares (glucosa, sacarosa, fructosa, manosa, etc.); produce gelatinasa+, catalasa+, nitratasa+, crecen muy bien a 37ºC, hemolisina alfa y beta, coagulasa+ (S.aureus).
Diagnóstico bacteriológico:
- Toma muestra con torunda estéril o por punción según los casos en total asepsia; tinción Gram; aislamiento en medio Chapman/manitol salado y AS, tras la incubación observar las colonias; pruebas bioquímicas - coagulasa (S.aureus), fermentación de glucosa, catalasa, gelatinasa, hemolisinas alfa y beta (cepas patógenas), fibrinolisinas, fermentación del manitol (S.aureus); estudio de la sensibilidad a la novobiocina (diferenciar S.epidermidis de S.saprophyticus)
- Diferenciacion del genero Staphylococcus y Micrococcus (en principio no es patogeno) => Staphylococcus sensible a bacitracina y eritromicina; Micrococcus a veces pueden dar oxidasa+.
- Estafilococos coagulasa- es un grupo heterogéneo (+ importante son S.epidermidis y S.saprophyticus) 80% en el pasado no causan infecciones importantes, pero cada vez esta tomando mas importancia; ademas muestra resistencia a varios ATB alternativa de penicilina (meticilina y cloxacilina); pueden producir infecciones urinarias, bacteriemias (por la implantación de cateteres i.v.) y endocarditis.
Streptococcus => cocos Gram+, tamaño pequeño, capsulados, anaerobios facultativos, se agrupan en cadenas, fermentador de glucosa, son saprofitos, oportunistas y algunos patógenos; poseen Ags (polisacárido C - según sus características, se clasifican en grupos A-V de Lancefield; proteína M antifagocitarias, la posee el grupo A)
Clasificacion
A. según el tipo de hemolisis (capacidad de romper hematíes - produce hemólisis alrededor de sus colonias en AS) => gamma hemolítico, alfa hemolíticos/ hemólisis parcial (decoloración parda verdosa - S.viridans); beta hemolíticos/ hemólisis total (halos de transparencia grandes entorno a su colonia) - grupos A, B, C, D (enterococo) G y F; estreptococo NO Beta-hemolíticos - grupo D, S.viridans y S.pneumoniae (alfa y gamma)
B. según sus caracteres bioquímicos (sensibilidad a bacitracina, optoquina, tolerancia a NaCl, degradación de bilis esculina y factor CAMP):
- Sensible a bacitracina (grupo A)
- Crecimiento en NaCl 6,5% (grupo D enterococos)
- Factor CAMP => potenciar la acción hemolítica de S.aureus (lo produce grupo B)
- Pruebas de bilis esculina - hidrolisan este compuesto (grupo D enterococos)
- Sensible a optoquina (S.pneumoniae /neumococo)
- Hidrólisis de hipurato sódico (grupo B)
C. según los caracteres antigénicos (a traves de reacciones serologícas especificas => aglutinación, precipitación, inmunofluorescencia, etc.) => los Ags en la pared celular (péptido glicano - toxica y facilita la unión de ellos a las células epiteliales invadidas; polisacárido C - distintas características que confiere la agrupación de los estreptococos (grupos de Lancefield);
- Grupo A (la + importantes) => la mayoría son Beta-hemolíticos y patogenos al hombre; proteína M se presenta como pelos en el perímetro de la pared celular (anti-fagocitarías).
- En las capsulas del grupos A y C se encuentra enzima hialuronidasa (características anti-fagocitarías)
Acción patógena e Interés clínico:
(1) Streptococcus del grupo A (S.pyogenes) => causan 90% de las infecciones estreptocócicas; muy sensibles a los agentes externos; son floras de la mucosa nasal y faríngea; poseen polisacárido C (proporciona la especificidad de grupo) y proteína M (facilita la adherencia a las células invadidas y protección a la fagocitosis); son Beta-hemolíticas, sensibles a la bacitracina y variable a optoquina
- Poseen hemolisinas estreptocócicas/ estreptolisinas (O y S); estreptolisina S (poco antigénico) => holoproteína toxica responsable de hemólisis en medio AS; estreptolisina O (muy antigénico) => hetero-proteína exotóxica muy activa de efecto hemolítico frente a glóbulos rojos y leucocitos (pmn y macrófagos => alterando la estructura celular); induce a la formación de Acs ASLO.
- Produce toxina eritrogénica responsable del exantema de la fiebre escarlatina;
- Enzimas estreptoquinasas (activador de plasminógeno => plasmina en fibrinolisis); induce a la formación Acs; se utiliza en el hospital en procesos trombo-génicos.
- Enzima desoxirribonucleasa estreptocócica (despolimeriza ADN); son antigénicas y se distingue en 4 grupos (A-B-C-D).
- Enzima Hialuronidasa (hidroliza el acido hialurónico del tejido conjuntivo); facilita su invasión.
- Proteinasa estreptocócica (origina procesos inflamatorios y necrosación)
Patogenicidad de S.pyogenes (grupo A) => Infecciones en la piel o mucosas (+frecuentes - anginas/faringitis sobre todo a niños/contacto directo, otitis y sinusitis) 95% de infecciones naso-faringeas son producidas por estreptococos del grupo A; infecciones NO supuradas/ inmunológica => fiebres reumáticas (complicaciones de tto no adecuados), glomerulonefritis, endocarditis, meningitis, sepsis.
(2) Streptococcus del grupo B (S.agalactiae) => saprofito del hombre en rino-faringe, uro-genital, vaginal e intestinal; produce infecciones oportunistas; hipurato+ (degrada el hipurato sódico) es lo que le diferencia del grupo A; posee factor CAMP (potenciar la acción hemolítica de S.aureus); puede origina meningitis e infecciones pulmonares en el neonato, infecciones del tracto respiratorio, mucosas, piel, etc; son Beta-hemoliticos, resistente a la bacitracina;
(3) Streptococcus del grupo C => es el mas proximo al grupo A; son Beta hemolíticos (también alfa y gamma) y muy sensible a los agentes externos; resistente a la bacitracina; crecen en medios salinos (NaCl 6,5%); posee enzima hialuronidasa; saprofito del hombre en la rinofaringe; puede producir mastitis en vacas, muermo en caballos y sepsis ??? en el hombre.
(4) Streptococcus del grupo D => son alfa, beta y gamma hemolíticos; resistentes a agentes externos y ATB;
- los enterococos => S.faecalis y S.faecium; son saprofitos del intestino del hombre; crecen bien en NaCl 6,5% (a diferencia de los NO enterococos); hidrolizan la bilis esculina; son alfa-beta-gamma hemolíticos; resistente a la bacitracina; puede producir infección urinaria e herida.
- los No enterococos => S.bovis, S.equinus y S.anginosos (afecta vacas y caballos); hidrolizan la bilis esculina; resistente a la bacitracina;
(5) Streptococcus del grupo G, F y E => saprofitos de la rinofaringe, vias genitales e intestino en el hombre; pueden producir infecciones en vias urinarias, heridas; resistente a la bacitracina; son alfa y beta-hemolíticos; crecen variable en medios salinos (NaCl 6,5%)
(6) Streptococcus Alfa hemoliticos (S.viridans) => no son capsulados; producen alfa y gamma hemolisis; saprofitos de la orofaringe, mucosa bucal, placa dental (caries); resistente a la optoquina;
(7) Streptococcus pneumoniae (neumococo) => es un grupo a parte; diplococos, Gram+ y son capsulados; muy sensibles a medios externos; son alfa y gamma hemolíticos; sensibles a optoquina; crecen variable en medios salinos (NaCl 6,5%); saprofito en aparato respiratorio; puede producir neumonias, inflamaciones sinusitis, otitis y meningitis (mas frecuente en adultos);
Aislamiento:
- toma de muestra con total asepsia de la rino-faringe con hisopo estéril, una muestra del pus (si hubiera); se analiza de inmediato (estreptococos son sensibles a medios externos);
- un frotis para la tinción de Gram; si se sospecha S.pneumoniae se realiza una tinción negativa con tinta china y prueba de "Quellung" (determinar Ags de la capsula); se produce una reacción de Quellung cuando un Acs tipo específico se une al polisacárido capsular del neumococo y causa un cambio en el índice refractivo de la cápsula haciéndola aparecer “hinchada” y más visible.
- la siembra en AS-CNA (posibles hemólisis - estreptococos son resistentes a nalidixico que inhibe el crecimiento de otros gérmenes); realizar hemocultivos si se sospecha endocarditis o sepsis; las colonias son grisaceos, redondos de bordes lisos y pequeños; medios selectivo y diferencial con NaCl 6,5% => permite el crecimiento de enterococos del grupo D.
Pruebas bioquímicas:
- pruebas de catalasa-, hemolisis en AS, sensibilidad o no de optoquina y bacitracina; hidrolisis de hipurato (positivo en el grupo B), utilización de bilis esculina.
- identificar los grupos antigénicos según el tipo de sustancia polisacárido C (clasificación de Lancefield) por metodo serológicos => prueba de látex (romper la capsula para sacar la sustancia; reacción inmuno-complejo Ag-Ac).
- los Gram+ en general son sensibles a la vancomicina excepto algunos cocos Gram+, catalasa- que no son estreptococos (Pediococcus es resistente a la vancomicina).
Pruebas serologícas / inmunologicas:
- la búsqueda en el suero (dilución seriadas) del paciente de Acs frente a toxinas y enzimas de estreptococos (sobre todo grupo A) => títulos de Acs antiestreptolisinas O (ASLO); para saber si la infección es aguda o creciendo; en caso de fiebres reumáticas con títulos de ASLO negativos, se determinan los títulos de Acs antiestreptoquinasas (ASK), antihialuronidasas (ASH); pruebas de hinchamiento capsular con suero antineumococico polivalente (prueba de Quellung) muy utilizado para determinar S.pneumonia => se añaden Acs contra Ags capsulados, si hay aglutinación es signo de que esta estreptococo.
Neisseria => cocos Gram-; en forma de diplococos (granos de café), aerobios; son saprofitos de mucosas (genitales, faringe, fosas nasales) y cavidades del hombre y los animales; citocromo-oxidasa y catalasa+; utilizan azucares con metabolismo oxidativa y fermentativa; producen pigmentos carotenoides; nutricional-mente exigentes; sensibles a medios externos.
Especies mas importantes - 4 géneros => Neisseria, Branhamella (B.catharralis), Acinetobacter y Moraxella.
(1) Neisseria meningitidis (meningococo) => es una especie patógena para el hombre; son parásitos obligados del hombre (no se encuentran libre en la naturaleza); es difícil de cultivar si hay competición (acompañadas por otros gérmenes); son capsulados; utiliza glucosa y maltosa; posee fimbrias (facilita su adherencia) y capsulas (contiene polisacáridos con comportamientos serológicos diferentes A,B,C, etc.); crecen a 35-37ºC; son muy sensibles a medios externos; producen meningitis epidémico (contagio por gotas de flugge en contacto íntimos); otros causantes de meningitis => Haemophyllus influenzae, Streptococcus agalactiae, Escherichia coli, Pseudomona aeroginosa, Micobacteria, Neisseria meningitidis, Cryptococcus neoformans y otros.
(2) Neisseria gonorrhoeae (gonococo) => idénticas características que meningococo; utiliza glucosa como fuente de carbono; requieren medios enriquecidos con CO2 5-10% para potenciar su crecimiento a 35-37ºC; son muy sensibles a medios externos y son parásitos estrictos del hombre y produce gonorrea (no se encuentra libre en la naturaleza);
(3) Neisseria saprofitas => saprofitos de la rino-faringe y genitales; son poco exigentes y crecen a 22-35ºC en medios generales; resistentes a medios externos y no son patógenos para el hombre.
Acción patógena e interés clínico
Neisseria meningitidis (meningococo) => diplococos /granos de café; coloniza las mucosas y vías respiratorias (sobre todo superiores); 5-30% son portadores sanos en rino-faríngeo; afectan a niños de 6 meses hasta 5 años (causas mas importantes de mortalidad infantil); también afectan niños mayores y adultos jóvenes de 6 hasta 25 años; estructura antigénica => componentes de su capsula (polisacárido), las fimbrias (facilitar la adherencia y la invasión) y proteínas de la membrana (toxica sobre las celulas invadidas);
Cuadro clínico - comienza con una rino-faringitis de sintomatología leve (sobre todo en niños - en adultos se forman Acs anti meningococo) evoluciona a forma severa, se complica con bronquitis; si el meningococo pasa a la sangre, originara micro-focos en la piel con erupciones petequiales (1-2mm) en el tronco e extremidades inferiores, cefaleas, fiebres altas, artralgias; puede pasar a LCR con fiebres muy altas, cefaleas fuertes, rigidez de nuca, vómitos, diarreas, etc.; se agravan hasta la muerte sin tto efectivo y rápido; el examen LCR es turbio, purulento con abundantes meningococos (debido a acumulación de pmn con meningococo dentro (celulas CLUE); tto con penicilina (G) - el tto del portador es rifampicina.
Neisseria gonorrhoea (gonococo) => idénticas características que el meningococo; su afinidad particular es sobre las mucosas uro-genitales, con fimbrias (adherencia a las celulas epiteliales dificultando la fagocitosis); posee endo-toxina que inactiva Acs próximos; produce gonorrea en hombres y mujeres (ETS);
Cuadro clínico - tras un contacto sexual, los gonococos se adhieren a la superficie de la mucosa gracias a las fimbrias y proteínas de la membrana; posteriormente se penetran a tejidos sub-epiteliales y empiezan a multiplicarse, liberando endo-toxina con efecto toxico a la uretra, cuello del útero, ano (donde colonicen), produce la destrucción de celulas del epitelio y supuración (secreción purulenta) y dolor a la micción; en las mujeres puede ir acompañada por uretritis, vaginitis y 20% salpingitis de las trompas (produce esterilidad en mujeres); 50% de los casos son asintomáticos con lo que la ausencia de tratamiento conduce a la cronificación; puede provocar bacteriémia dando artritis supurativos; tto => penicilina o sus derivados; en neonatos provoca gonococia ocular que conduce a la ceguera - se previene instilando gotas de nitrato de plata - método de "Crede" y (contra Chlamydia es mas efectivo) eritromicina???
Aislamiento - caracteres bioquímicos - diagnostico
N.meningitidis - toma de muestra de LCR (punción lumbar), sangre y/o exudado faringeo; se deben examinar de lo antes posible (sensibilidad al medio externo); se transporta en un medio de Thayer-Martin modificado a 37ºC (en caliente); si la muestra de LCR es turbio o purulento, se divide en 2-3 tubos; 1er tubo se centrifuga y sobre el sedimento se realizan frotis Gram; 2nd tubo se utiliza para la siembra en AS, agar chocolate, Mueller Hinton y Thayer-Martin; 3er tubo se realiza un hemocultivo y recuento celular; meningococo crecen dando colonias transparentes diminutas y no hemolíticas; las placas se incuban a 37ºC en ambiente de CO2 5-10%.
- Pruebas bioquímicas => catalasa+, oxidasa+, prueba de la utilización de glucosa y maltosa por oxidación (aerobio), lactosa-, nitratasa-.
- Estudios serológicos => inmunofluorescencia directa del LCR o el suero, contrainmuno-electroforesis y técnica ELISA.
- Existe sistema de multi-prueba para Neisseria y Haemophylus.
N.gonorrhoeae - toma de muestra a partir de la uretra (hombre), recto en homosexuales y uretra, cuello de útero y recto (mujer), se realizan en el laboratorio (sensibilidad a medio externo), por la mañana antes de la primera micción (al ser posible); se procede de inmediato al estudio directo y la siembra en medios específicos o se transporta en medio TM modificado.
- se realiza la tinción (Gram- en forma de granos de café); en el frotis se ven los pmn con diplococos dentro; la siembra se hará en AS, agar chocolate, Thayer-Martin (con factores de crecimiento y ATB vancomicina, anfotericina, colistina y trimetropin que inhibe el crecimiento de otros gérmenes); en TM los gonococo son colonias pequeñas de color gris y los meningococo son blanquecinas se incuba a 35-37ºC y atmósfera enriquecida de CO2 5-10%;
- Pruebas bioquímicas => utilización de azucares por vía oxidación (glucosa+, lactosa, maltosa+ para meningococo, y sacarosa); oxidasa y catalasa son positivos, nitratasa-.
- Pruebas serologícas => hemo-aglutinación, inmunofluorescencia indirecta, ELISA (mas utilizadas)
- Sistema de identificación multiprueba para Neisseria y Haemophylus.
Neisseria saprofitos (Neisseriaceas) - normalmente son flora de oro-faringe/ naso-faringe; son especies de bajo patogenicidad, aunque a veces implicadas en meningitis y otros; no requieren medios especiales para su crecimiento.
- Branhamella catharralis / Moraxella catharralis => hoy en día la clasificación es confusa (la tendencia - dentro de la familia moraxellacea), otros autores tienden a diferenciarla y la clasifican como familia Branhamellaceae; es Gram-, oxidasa+, catalasa+, nitratasa+ (reducen nitratos a nitritos), no fermentan azucares, crecen bien en medios generales (AS, agar chocolate y Thayer Martin), son aerobias o 5% de CO2; flora normal de naso-faringe, pero a veces se aísla como agente causal en septicemias e infecciones otorrinolaringológicas (sinusitis, otitis).
- Acinetobacter => anteriormente clasificada dentro de la familia Gram- no fermentadoras (pero oxidasa- => bacteria inerte) junto con Pseudomonas; actualmente esta incluido dentro de la familia Moraxellaceae; son microorganismos que pueblan fundamentalmente suelos y aguas y presentes en medios hospitalarios (infección nosocomial); la especie mas importante => A.calcoaceticus (causan neumonías, infecciones urinarias y sepsis); crecen en Mac, AS y otros; en AS producen colonias grises con halos de hemólisis, oxidasa-, catalasa+, son cocobacilos Gram- (se pueden confundir con Neisserias por su tamaño).
- Moraxella => coco-bacilo, Gram-, no fermentador, inmóvil, oxidasa+, catalasa+, difícil de distinguir con Neisseria; en general los no fermentadores son muy difíciles de distinguir y requiere numerosas pruebas bioquímicas para etiquetarlos.
Tema 19 - Entero-bacterias y vibrios (patología e identificación)
Entero-bacterias - bacilos o coco-bacilos Gram-, aerobios y anaerobios facultativos, móviles (flagelación perítrica) o inmóviles, fermentadoras de glucosa (con o sin producción de CO2), oxidasa-, catalasa+; algunos usan metabolismo fermentativo y otros usan metabolismo oxidativo; la mayoría son nitratasa+; algunos son sulfuhidratasa+ (Proteus y Salmonella), indol+ (E.coli); son saprofitas/ flora del tracto gastrointestinal del hombre y de los animales; también se encuentra en el agua y en el suelo; resistentes a medios externos; son potencialmente patógenos en individuos debilitados y produce infecciones oportunistas; algunos son patógenos siempre donde sea se encuentra, otras depende de la muestra donde se aísla y el resto se cuestiona su papel.
Características antigénicas:
- Ag somático / Ag O => es lipo-polisacárido, termo-estables, se encuentra en la pared bacteriana, es una endo-toxina (la parte polisacárido es muy antigénico y la parte lipídica es inactiva bioquímica-mente).
- Ag capsular / Ag K => se encuentra en la capsula bacteriana, es polisacárido, es anti-fagocitarías (relacionado con la virulencia de ciertas especies como E.coli K-1 y Salmonella thyphi).
- Ag flagelar /Ag H => es característico de las cepas móviles, es proteico y responsable de la acción patógena de la bacteria.
Clasificación según su capacidad para fermentar la lactosa:
- Fermentadoras rápidas de lactosa (coliformes) => Escherichia, Enterobacter y Klebsiella (tardía a veces)
- Fermentadoras lentas de lactosa / ONPG+ (coliformes) => Citrobacter, Serratia, Hafnia, Yersinia (patógeno) y Shigella sonnei.
- NO fermentadoras de lactosa (no coliformes) => Salmonella, Shigella, Proteus, Morganella, Providencia y Edwardsiella.
Salmonella - entero-bacterias no coliformes, móviles con flagelación perítrica; bacilos Gram-; en general provocan infecciones entérico febriles (gastroenteritis, entero-colitis o fiebres tifoideas o para-tifoideas).
Especies importantes - S.typhi, S.choleraesuis, S.enteritidis, S.paratyphi A,B y C, S.arizonae.
Acción patógena e interés clínico
- Ag somático O, Ag flagelar H y Ag capsular VI (en S.typhi - Ag termolábil con poder protector frente a los ácidos /ácida gástrica, resistencia y anti-fagocitarías)
- endo-toxina y enterotoxina (efecto irritante y citotóxico sobre el tracto intestinal)
Cuadros clínicos
1. Infecciones entéricas (S.typhi - fiebres tifoideas o S.paratyphi A,B o C - para-tifoideas); Las fiebres tifoideas son transmitidas al hombre vía oral (alimentos crudos, poco hechos, mal conservados y aguas contaminadas), llega al estomago, resiste la acidez gástrica, pasa al intestino delgado (íleon), penetra por endocitosis destruyendo parte de las celulas de la mucosa intestinal; una vez dentro las salmonellas son fagocitadas por macrófagos y transportadas por diferentes vías y provoca bacteriémia => todo sucede en el periodo de incubación (8-15 días); comienzo brusco de signos y sintomas => los macrófagos les transportan hacia el bazo, higado y MO, produciendo multiplicación de nuevas salmonellas, volver al intestino generando placas ulceradas, necrosación de placas de Peyer y en casos mas graves originar perforación y hemorragias.
Las fiebres para-tifoideas son mucho mas leve con un periodo de incubación de entre 7-10 dias con bacteriémia y estado febril que dura varias semanas; no hay perforación intestinal ni hemorragias ni invasión de salmonellas a otros órganos; cuadros clínicos => dolores de cabeza, fiebres altas, anorexia, astenia/ cansancio; preciso un tratamiento que dura 9-10 días.
2. Infecciones gastrointestinales y enterocolitis (S.enteritidis - la mas frecuente, S.choleraesuis, S.typhimurium y otras); periodo de incubación 12-36 horas; se transmite por alimentos contaminados con una concentración de salmonellas de 10 millones a mil millones/ml, depende de tipo de la cepa; el alimento les facilita su llegada a pasar el estomago y llegar al intestino delgado colonizando el íleon y el ciego, se penetran por fagocitosis al epitelio y se multiplican originando una inflamación que genera cuadros diarreicos con dolor abdominal (perdidas de electrolitos y agua), fiebres altas, nauseas, vómitos; re quiere un tratamiento de re-hidratación que dura 6 días - las floras se encargan de eliminarlas.
Aislamiento - pruebas bioquímicas - diagnostico de Salmonella
Salmonelosis => toma muestra de las heces (coprocultivo), análisis del alimento sospechoso; medios de cultivo SS, McConkey, caldo selenito; pruebas bioquímicas: ONPG-, TDA-, Citrato+ (S.cholera-suis y S.enteritidis, tambien son CO2+ y Ornitina descarboxilasa+), SH2+, fermentacion de azucares: Glucosa+, Trehalosa+ (S.typhi y S.enteritidis), etc.
Fiebres tifoideas y para-tifoideas => toma muestra de diferentes localización según la fase de enfermedad; en la fase de incubación se busca en heces (coprocultivos), en orina (urocultivo), sangre (hemocultivo); en la fase inicial de la enfermedad / periodo febril, se realiza hemocultivo; en el periodo posteriores o finales se busca en heces (coprocultivo); medios adecuados; se realiza las pruebas bioquímicas, reacciones de aglutinación cuantitativa (títulos) de Ags O, H y VI a traves de sueros específicos monovalentes y polivalentes, especialmente para Ag VI (pruebas inmunológicas).
Mucaptest => prueba inmunológica utilizando suero polivalente (Acs anti O y anti H), un resultado positivo dara unas colonias fluorescentes (posible Salmonella).
Shigella - bacilo Gram- inmóvil, no fermentador de lactosa (excepto S.sonnei) ; son patógenas para el hombre, provoca afecciones graves y contagiosas sobre el tracto gastrointestinal (disentería bacilar) especialmente en ambientes de salubridad baja.
Acción patógena e interés clínico - se debe a la producción de sustancias toxicas, Ags O y K, plásmidos (facilita la invasión), adhesinas (adherencia a las celulas que invaden), exotoxina con propiedades cito-toxicas (tipo A - origina necrosis celular, ulceras, hemorragias y perforación), neuro-toxicas y entero-invasivas (tipo B - adherencia a las celulas del epitelio gastrointestinal); al llegar al intestino del hombre vía oral (puede resistir el acido gástrico, por la alta cantidad ingerido y también protegido por los alimentos), ejerce su acción toxica, pasar al colon originando necrosis con signos y sintomas características (las toxinas de S.disenteriae no suelen pasar a la sangre); cuadros diarreicos van acompañados de dolor cólico, nausea, vómitos, malestar general y fiebres muy altas con deposiciones sanguinolentas con moco y pus.
Aislamiento - pruebas bioquímicas, diagnostico de Shigella
Toma muestras de heces recién emitidas en los primeros días de la enfermedad (hay mayor numero de shigellas), eligiendo restos de moco y sangre si los hubiera; el estudio riguroso (teniendo en cuenta que Shigella se destruye en medios ácidos y a temperaturas <4ºC; medios de cultivos SS, McConkey, Hektoen, Yersinia CIN, Campylosel, TCBS; pruebas bioquímicas TDA, KIA (K/A para Shigella y A/A para S.sonnei), ONPG (positivo para S.sonnei), fresco, ureasa-, VP-, nitratasa+, manitol (positivo para Shigella y negativo para S.disenteriae); pruebas de aglutinación cuantitativa (titulo) para demostrar Acs en el suero del paciente a traves de sueros específicos mono y polivalentes.
Escherichia - entero-bacterias bacilar o coco-bacilar Gram- móviles, fermentadoras de glucosa y lactosa, produce CO2, aguantan temperaturas altas (la diferencia de otros coliformes), resistente a medios externos, fácil de encontrar en el agua, alimentos (indicativo de contaminación fecal reciente); saprofito de flora aerobia y anaerobia facultativa del tubo digestivo; puede provocar trastornos gastrointestinales de diarrea, infecciones urinarias, meningitis en neonatos y excepcionalmente bacteriémia; la especie mas importante para el hombre es E.coli (según la cepa puede tener Ag somático O, capsular K y flagelar H, fermentos y endo-toxinas).
Acción patógena e interés clínico - los cuadros clínicos son variables según el tipo de toxina que originen; algunas cepas de E.coli forman Ag O y K anti-fagocitarías y resistencia a bactericidas y ATB (alto poder invasivo); otras cepas forman endo-toxinas, causante de cuadros febriles y diarreicos; otras cepas tienen un mecanismo de acción análogo al de Shigella con menor gravedad; a veces la entero-toxina que producen es parecida a la de Vibrio cholerae que causa perdida masiva de agua y electrolitos.
- si la cepa de E.coli forma una entero-toxina citotóxica parecida a Shigella => cuadros diarreicos en brotes epidémicos que afectan a niños y lactantes (E.coli entero-patógena)
- si forma una entero-toxina semejante a Vibrio cholerae => procesos diarreicos en niños, adultos, originándose esporádica-mente brotes epidémicos (diarrea del viajero - E.coli entero-toxígena)
- si forma una entero-toxina citotóxica similar a S.disenteriae => procesos diarreicos graves, hemorragico esporádicamente en brotes (E.coli entero-hemorragica)
- si presenta ciertos plásmidos que incrementan su capacidad de invasión => cuadros diarreicos graves que afectan a niños, adultos con brotes epidémicos en casos aislados (E.coli entero-invasiva)
Las cepas de E.coli se distingue con sueros antigénicos; E.coli también puede provocar infecciones urinarias (cistitis, pielonefritis, etc), infecciones biliares, heridas, meninges (meningitis en neonatos).
Aislamiento, pruebas bioquímicas - diagnostico
Toma de muestra representativa de alimento, agua, heces, exudado; frotis de Gram; medios de cultivo Mc, Levine; pruebas bioquímicas => lactosa+, indol+, citrato-, sensible a la Colistina.
Yersinia - entero-bacterias muy patógenas para el hombre (Y.pestis - causante la peste bubónica); son coco-bacilos Gram-, móviles a 25ºC con flagelación perítrica e inmóviles a 37ºC, fermentadores de glucosa (ONPG variable), capsuladas (Y.pestis) y oxidasa-.
Especies mas importantes - Y.pestis (agente etiológico de la peste bubónica en el hombre) trasmitida a traves de ratas y pulgas, originando enfermedad grave febril, epidémico de alta mortalidad; Y.pseudotuberculosis afecta animales y excepcionalmente al hombre; Y.enterocolitica (sacarosa+ en medio TSI); los 2 últimos afectan mas a animales que al hombre (niños) => originando estados febriles y diarreicos.
Acción patógena e interés clínico de Y.pestis => cuadros agudos y febriles con alta inflamación de los ganglios linfáticos, hemorragias internas, petequias difusas en la piel, en ocasiones septicemia y neumónia; es muy contagiosa, se origina en lugares de salubridad baja; la muerte se produce por shock séptico (fracaso multi sistémico) o por neumónia; factores de virulencia:
- La toxina murina (liberada al medio cuando muera la bacteria) => proteína que bloquea la utilización de O2 por parte de las celulas.
- Endo-toxinas (liberadas en el transcurso de la enfermedad) => origina el proceso febril
- Ag V con propiedades anti-fagocitarías
- Coagulasas y fibrinolisinas
Y.pestis llega al hombre a traves de la picadura de pulga (infectada por ratas con peste), atraviesa los vasos linfáticos, pasa a los ganglios donde se multiplica originando bubones, pasa a la sangre y se disemina por el bazo, higado, pulmones, piel, mucosas, se multiplica provocando lesiones piógenas (toxina murina), hemorrágicas, necrótica y edematosa; en casos graves aparece coagulacion intravascular diseminada (CID) (por la acción de las coagulasas) o diátesis hemorragica (por la acción de las fibrinolisinas), colapso circulatorio, toxemía generalizada y muerte; formas clínicas:
1. Peste bubónica (la mas frecuente); tras el periodo de incubación de 3-7 días después de la picadura, aparecen signos y sintomas con escalofríos, vómitos, formación de bubones en las ingles axilas y/o zonas submaxilares (los tejidos circundantes aparecen inflamados); sin tratamiento se agrava hasta la muerte.
2. Peste pulmonar (es la complicación de peste bubónica); se produce afección pulmonar grave con insuficiencia respiratoria, cianosis; es altamente mortal.
3. Peste septicémica es estadios últimos de la peste en cual quiera de sus formas y es generalmente mortal.
Aislamiento - pruebas bioquímicas - diagnostico
Toma de muestra de exudados purulentos del bubón (por aspiración), de sangre, LCR, tejido pulmonar, nódulos linfáticos o esputo, heces, según los casos; la tinción Gram-, nigrosina (visualización de capsulas); medios de cultivo => Mc, Yersinia CIN (colonias muy pequeñas); pruebas bioquímicas => móvil a 22ºC y inmóvil a 37ºC, Lactosa-, ONPG+, ureasa+, indol y TDA-, oxidasa-, nitratasa+; a veces Y.pestis y Y.pseudotuberculosis son ONPG variable; Y.enterocolitica es sacarosa+.
Entero-bacterias oportunistas - bacilos Gram- aerobios y anaerobios facultativos, poco exigentes nutricional-mente, ampliamente distribuidos en el medio ambiente; son saprofitos de la flora gastrointestinal, resistente a medios externos y ATB; no son patógenos al no ser si el huésped es debilitados, pueden provocar infecciones hospitalario; en la mayoría son lactosa+, bacilos Gram- coliformes;
Principales especies de coliformes/ lactosa+ (Escherichia, Enterobacter, Citrobacter, Serratia, Klebsiella y Hafnia) y no coliformes /lactosa- (Proteus, Morganella y Providencia).
1. Escherichia => Gram- aerobias y anaerobias facultativas, fermentadoras rápidas de lactosa y glucosa, produce CO2, indol+, citrato-, sensible a Colistina, móviles.
2. Enterobacter => fermentadora rápida de lactosa, produce CO2, produce acetoína de la glucosa (VP+), citrato+, móvil, ornitina-descarboxilasa+, son comensales de flora intestinal; puede provocar a individuos debilitados diarreas, infecciones del tracto respiratorio, heridas, etc; especies importantes: E.aerogenes y E.cloacae.
3. Serratia => fermentadora lenta de lactosa (ONPG+) y la glucosa, produce acetoína (VP+), móviles, citrato+, ADNasa+, ornitina-descarboxilasa+, saprofitas del hombre y también en el medio ambiente (agua y otros líquidos), resistentes a ATB y desinfectantes; provoca infecciones urinarias y sepsis a personas debilitadas.
4. Citrobacter (huelen a peste) => fermentadora lenta de lactosa (ONPG+), móvil, fermenta la glucosa y VP- RM+, citrato+; son comensales del tubo digestivo del hombre y puede provocar infecciones urinaria, respiratoria, sepsis, bacteriémias, meningitis a los individuos debilitados; especies importante => C.freundii.
5. Klebsiella => inmóviles, fermentadoras tardía de lactosa, utiliza glucosa y produce acetoína (VP+), citrato+, ureasa+; son comensales del tracto gastrointestinal y vías respiratorias superiores; puede provocar neumonías, rinitis, infecciones urinarias; especies importante => K.pneumoniae (sub especies VP+ y VP-) y K.oxytoca (indol+).
6. Hafnia => móviles a 22ºC y inmóviles a 37ºC, fermentadora lenta de lactosa (ONPG+), citrato+, utiliza glucosa y produce acetoína (VP+); provoca infecciones hospitalarias.
7. Proteus, Morganella y Providencia => NO fermentan la lactosa, pero si glucosa y produce CO2, RM+; móviles, TDA+ (diferenciar del resto entero-bacterias), pueblan aguas residuales, el suelo, materia orgánica y son comensales en la flora intestinal del hombre; pueden provocar infecciones hospitalarias; especies importantes:
- Proteus mirabilis (indol-, ureasa+, TDA+, SH2+), P.vulgaris (indol+, ureasa+, TDA+)
- M.morganii (ureasa+, indol+, TDA+)
- Providencia rettgeri (ureasa-, indol+, TDA+)
P.mirabilis puede provocar infección urinaria, descompone la urea de la orina que genera precipitación de sales cálcicas => formación de cálculos renales; también puede provocar infecciones gastrointestinales, toxinfecciones alimentarias, heridas, etc.
Acción patógena e interés clínico - si el huésped se encuentra debilitado (postoperatorio, tratamiento inmunosupresores) los saprofitos podrían ser patógenos; las infecciones mas frecuentes =>
- tipo urinario (40% de las infecciones hospitalarias - pacientes sondados, encamados, intervencionados quirúrgica-mente) provocado por E.coli, P.mirabilis, P.vulgaris, Klebsiella y Enterobacter, provocando cistitis (de las vías bajas) y pielonefritis (de las vías altas); son infecciones agudas con fiebre, dolor lumbar, polaquiuria o anuria y disuria; es frecuente en los análisis de orina piuria, bacteriuria y proteinuria;
- tipo abdominal son poco frecuente => abscesos y peritonitis debido a perforación intestinal.
- tipo respiratorio (20% de las infecciones hospitalarias) afectando vías respiratorias altas, neumonías y bronco-neumonías (pacientes con afecciones crónicas)
Aislamiento - pruebas bioquímicas - diagnostico
- Toma de muestra según las afecciones o procesos patológicos en condiciones de total asepsia
- Examen directo (fresco y tinción Gram)
- Aislamiento en medios específicos/ selectivos (Hektoen, Mac) que inhiben los Gram+
- Pruebas bioquímicas e inmunológicas
Familia Vibrionaceae - Genero Vibrio, Aeromonas y Pleisomonas (los patogenos)
Especie mas importante y patógeno del genero Vibrio - V.cholerae => bacilos Gram- anaerobios facultativos de morfología curva (pleomórficos), móviles (flagelación lofótrica), crecen bien en medios generales y pH alcalino (sensibles al medios ácidos), oxidasa+ (la diferencia de la enterobacteriaceae), halófilo, catalasa+, afectan al tracto gastrointestinal del hombre; es el agente causal del cólera => provoca diarreas graves hasta llegar a la deshidratación (diarreas masivas), shock hipovolémico, coma y muerte por deshidratación (puede perder hasta 10-15 lt/día de agua y electrolitos); se diferencia de Pseudomonas por la diferencia en el patrón de fermentacion de azucares.
Acción patógena e interés clínico:
- Ag somático O (polisacáridos) se utiliza para su tipación
- Ag flagelar H (no tiene valor para su tipación - común a todas las cepas)
- Exotoxina / entero-toxina proteica (el principal efecto patógeno del cólera - provoca diarrea masiva)
- Adhesina (proteína que tiene afinidad por los azucares) que permite adherirse a la pared intestinal
Para formar cuadros graves es necesario su penetración por vía oral (agua o alimentos contaminados con el bacilo, p.ej. productos marinos crudos), eludir el medio acido del estomago (sucede cuando se ingieren >100 millones de gérmenes - en el caso de epidemias donde se encuentra 1 millón/ ml de agua).
Aislamiento - caracteres bioquímicos - diagnostico
- Toma de muestra a partir de las heces diarreicas, vómitos, procediéndose de inmediato a su identificación (sensible a medios externos); medio de transporte Cary-Blair.
- Aislamiento en medios de cultivo específicos TCBS que impide el crecimiento de gran parte de microorganismos => produce colonias amarillas por la fermentacion de la sacarosa sobre el medio verde y también se siembre en el Mc.
- Pruebas bioquímicas => oxidasa+, catalasa+, sacarosa+ (produce un tipo de acido débiles que no bajara mucho el pH)
- Pruebas serologícas para determinar el titulo de Acs.
Aeromonas - bacilo Gram- no fermentadoras de la misma familia; el especie mas importante Aeromonas hydrophila; catalasa+ y oxidasa+, VP+, lactosa-, ureasa-, indol+, SH2-, móviles; no son halófilo (a diferencia de Vibrio) implicadas en procesos diarreicos.
Plesiomonas - tiene las mismas características bioquímicas que Aeromonas (excepto en pruebas de VP y ornitina descarboxilasa); el especie mas importante Plesiomonas shigelloides (se propone a incluirla a la familia enterobacterias); hay que hacer API para distinguirla de Aeromonas (Plesiomonas - ornitina descarboxilasa+)
Tema 20 - Bacilos y cocobacilos aerobios y anaerobios facultativos (patología e identificación)
Pseudomonas - bacilos pequeño (coco-bacilo) Gram-, móviles (flagelación), en general aerobios estrictos, catalasa y citocromo oxidasa positivos, en general metabolismo glucídico oxidativo; ampliamente distribuidos en el agua y suelo, pasando de aquí a los animales y al hombre; son oportunistas en el ambiente hospitalario (pacientes inmunodeprimidos), en ocasiones resultan muy graves (resistente a muchos ATB - hay que combinar varios).
Los especies mas importantes:
- P. aeroginosa => presenta pigmentos fluorescentes, saprofita en la piel, tubo digestivo??, puede provocar cuadros graves en individuos debilitados y es mortal si se produjese septicemia;
- P. maltophilia (ahora se llama Stenotrophomonas maltophilia) se llama así, porque oxida maltosa (no oxida la glucosa); cogen cada vez mas importancia; oxidasa variable.
Acción patógena e interés clínico - Pseudomonas aeroginosa
- Ag somático O (polisacáridos), Ag flagelar H (proteico), Ag mucoide M (produce exotoxinas => enterotoxina responsables de cuadros diarreicos y toxina eritrodérmica).
- Sustancia => (1) piocina (pigmento azulado de acción bactericida), (2) fluoresceina (pigmento verde amarillo) y (3) pigmento melánico (tiñe de color marrón los cultivos).
- Cuadros graves o muy graves (de carácter oportunista) => sinusitis crónicas, infecciones del aparato respiratorio (neumonías, faringitis, bronco-neumonías); puede producir endocarditis en drogadictos y paciente con SIDA; enterocolitis, pielonefritis y meningitis en neonatos; en grandes quemaduras, agravando la lesión o provoca infección de heridas quirúrgicas; en casos mas graves puede originar bacteriémia (quemaduras graves).
Aislamiento - caracteres bioquímicos - diagnóstico bacteriológico
- Toma de muestra de cualquier producto patológico, especialmente de carácter purulento en total asepsia.
- Examen directo (tinción Gram); si el pus es azulado se sospechara de P.aeroginosa.
- Aislamiento en medios generales (el bacilo piociánico es fácil de cultivar) a temperatura 37ºC; es importante estudiar la presencia de pigmentos que se difunden en el medio; la piocianina es un pigmento responsable de la coloración azul verdosa que puede adquirir el medio y el olor a jabón de las colonias son las características de P.aeroginosa.
- Pruebas bioquímicas de citocromo oxidasa+, catalasa+, gelatinasa+, utilización de la glucosa vía oxidativa (aerobio).
- Pruebas serologícas para buscar Acs anti Pseudomonas.
Brucella - bacilos pequeños (coco-bacilos) Gram- inmóviles, aerobios estrictos, algunas crecen mejor en atmósferas ricas en CO2 (5-10%), su crecimiento es lento, catalasa+, oxidasa+, nitratasa+, ureasa+, sensibles a medios ácidos y se destruyen fácilmente a temperatura de pasteurización.
Especies mas importantes (en función del huésped en el que anidan):
- Brucella melitensis afecta a cabras y ovejas; afecta al hombre a traves de sus leches no esterilizada, quesos frescos, carne cruda o poco hecha.
- Brucella abortus afecta a bóvidos (la mayoría de los casos de brucelosis en España - en menor proporción B.melitensis)
Acción patógena e interés clínico - depende de su estructura antigénica; Brucella es capaz de mantenerse latente en el interior de la celulas que la han fagocitado y posteriormente, empezar a multiplicarse con la consiguiente producción de endo-toxina; penetran en el hombre a traves de heridas y vía digestiva (alimentos procedentes de animales infectados (leche no esterilizada, quesos frescos, carne cruda o poco hecha); posteriormente, pasaran a los ganglios linfáticos, donde serán fagocitadas por neutrófilos (en la sangre) y macrófagos (en los tejidos) y se distribuyen por todo el organismo, volver a pasar al torrente circulatorio originando bacteriémia (brucelosis aguda o fiebres de Malta); se caracteriza por artralgias difusas (dolores de articulaciones), sudoración abundante, esplenomegalia y otras distintas formas clínicas dependientes de la localización de Brucella (orquitis, neumónia brucelar, etc); las fiebres son ondulantes con tendencia a las recidivas (frecuente entre los 3 y 6 meses subsiguientes a la infección por Brucella);
Bordetella - bacilos o coco-bacilos Gram- aerobios estrictos, inmóviles (algunas son móviles), capsulados; son parásitos estrictos (no se encuentran libres en la naturaleza); se transmite por las gotitas de flugge o contacto directo.
Especies mas importantes:
- Bordetella pertussis (bacilo Bordet y Gengou) => la mas patógena y es el agente etiológico de la tosferina
- B.parapertussis => aislada en casos benignos de tosferina y no es estrictamente patógena
- B.bronchiseptica => afecta mas a animales que al hombre; aislada en el hombre excepcionalmente en casos benignos de tosferina.
Acción patógena e interés clínico (Bordetella pertussis) - se infectan a traves de gotitas (flugge) que se producen al hablar; tras periodo de incubación de 1-2 semanas, empiezan a multiplicarse en la superficie de las celulas epiteliales ciliadas de la traquea, bronquios y bronquiolos, originando inflamación en estas zonas, paralización de sus cilios y consiguiente necrosación; presenta una fuerte acción tusígena (tos seca) que puede llegar a agotar debido a la acción de la toxina proteica y incremento de las mucosidades que obstruyen los bronquios (bronco-constricción) lo que facilita un déficit en la ventilación pulmonar; puede originar cianosis, taquicardia y vómitos alimenticios; es altamente contagiosa, pero ya existe vacunas de la tosferina.
Haemophilus - bacilos muy pequeños Gram- aerobios y anaerobios facultativos, inmóviles y patógenos para el hombre y muchos animales; sensibles a medios externos, desecación, el calor y muchos antisépticos; necesita medio de cultivo especifico con sangre como AS o agar chocolate (contiene factores X/hemina o ferroprotoporfirina y factor V/NAD o nicotinamida-adenina-dinucleotido necesarios para el proceso de respiración).
Especies mas importantes (clasificadas en función de los factores que necesitan):
- Haemophilus influenzae (bacilo de Pfeiffer) es el agente etiológico de 10-15% de las meningitis en niños de corte edad en España y de neumonías en ancianos; requiere ambos factores V y X.
- H.parainfluenzae es agente causales en ciertas meningitis, afecciones respiratorias y septicemias; también son saprofitos en fosas nasales y boca; requiere solo factor V.
- H.ducreyi es agente etiológico del chancro blando (enfermedad venérea /ETS); requiere solo factor X.
Acción patógena e interés clínico (Haemophilus influenzae):
- Es capsulada (su capsula esta formada por polisacáridos distintos de A-F) en España es mas frecuente la del tipo B.
- Posee endo-toxina que es responsable de lesiones en la traquea y bronquios en procesos neumónicos
- Suelen afectar a las vías respiratorias originando neumonías, bronquitis aguda en ancianos y adultos debilitados.
- Puede producir meningitis en niños de corta edad; se transmite por vía aérea y mas frecuente en invierno y primavera; comienza como infección de las vías respiratorias altas y posteriormente se extiende via sangre hasta el sistema nervioso produciendo meningitis purulenta con mortalidad alta sin tratamiento a tiempo.
- Existe vacuna para H.influenzae tipo B.
Aislamiento - caracteres bioquímicos - diagnostico de Haemophilus:
- Toma de muestra a partir del exudado faríngeo, esputo o líquidos purulentos (en caso de infección de vías respiratorias), LCR por punción lumbar (en caso de sospechar meningitis).
- Examen directo (tinción Gram, tinción negativa)
- Se cultiva en agar chocolate o AS de conejo/caballo, se añaden discos que contengan factores V y X, ATB como la bacitracina que inhibe a otros gérmenes; se formaran satelitismo según sus necesidades de los factores; incubar en la atmósfera rica en CO2.
- Pruebas bioquímicas => indol+, ureasa+, nitratasa+, oxidasa variable (según la cepa), fermentacion de glucosa positiva, ONPG-.
- Técnicas inmunológicas => determinar el Ags capsular (se realizan por la urgencia del diagnostico)
Legionella - la especie mas importante para el ser humano, es Legionella pneumophila (el agente etiológico de la legionelosis / neumónia atípica por Legionella); un coco-bacilo o bacilo Gram-, aerobio estricto, requiere medios muy específicos para crecer (agar legionella), catalasa+, oxidasa+, en ocasiones puede presentarse de forma filamentosa; en general son móviles, pero algunas cepas son inmóviles.
Acción patógena e interés clínico - se transmite vía aérea a partir de aerosoles procedentes de aguas contaminadas o sistemas de aire acondicionado o humidificadores contaminados con Legionella; tras el periodo de incubación (+/- 1 semana) se produce fiebres altas, astenia, malestar generalizado, tos, anorexia, dolor pleural agudo, disnea (un cuadro típico de una neumónia atípica); se conoce como la enfermedad de los legionarios; el pronostico sera mas severo en ancianos o adultos debilitados aunque con el tratamiento preciso suele remitir sin problema.
Bacillus - de la familia Bacillaceae; el genero Bacillus son bacilos esporulados aerobios o anaerobios facultativos con tamaño entre 1-7 micras Gram+ y en su mayoría móviles; otro genero de la misma familia es Clostridium son bacilos esporulados y anaerobios estrictos, que origina en su mayoría potentes exotoxinas responsables de cuadros clínicos graves.
Especies mas importantes de Bacillus:
- Bacillus anthracis (agente etiológico del ántrax o carbunco)
- Bacillus cereus (responsable en muchas ocasiones de trastornos gastrointestinales)
- otros bacilos son comensales para el hombre o saprofitos del suelo, agua, etc., y que depende del estado inmunitario, puede producir diferentes cuadros clínicos (p.ej. Bacillus subtillis).
Acción patógena e interés clínico de Bacillus anthracis:
- Es un bacilo grande, habitualmente se presenta en forma de cadenas cortas o en parejas, formando fácilmente esporas sobre todo en los cultivos viejos; es inmóvil, presenta capsulas (los patógenos) y exotoxina proteica que proporcionan propiedades anti-fagocitarías.
- En general, el cuadro clínico que produce es el carbunco animal o humano; en el humano tiene lugar tras un primer contacto a partir de animales infectados que tras periodo de incubación de 2-3 días surge una pústula maligna (color negro en la mano) en el punto de contagio (las manos y cabeza); comienza con una pápula eritematosa que se complica a vesícula pruriginosa que se convierte en ulcera o escara, que sin tratamiento puede necrosarse y extenderse en superficie y profundidad; los casos no tratados, podrían ser graves, ya que existe el riesgo de septicemia intensa que en pocas horas podría originar la muerte; lo mas habitual son las formas benignas que curan con facilitad tras un tratamiento.
- En casos excepcionales pueden aparecer formas internas como el carbunco pulmonar ante la inhalación de polvo contaminado con esporas de Bacillus anthracis que da lugar a neumonías graves; también puede producirse carbunco intestinal por la ingestión de alimentos contaminados con las mismas esporas y originara diarreas, vómitos, dolor tipo cólico, fiebre, etc.
Acinetobacter - (también esta descrito en genero de Moraxella/ Neisseriaceas) este genero engloba especies que pueblan la flora de suelos y agua, al igual que Pseudomonas, son bacilos Gram- no fermentadoras, capsuladas y presentes en ambiente hospitalarios donde afectan a pacientes inmunodeprimidos; la especie mas frecuente es Acinetobacter calcoaceticus que produce infección urinaria, neumonías y sepsis; crecen bien en Mc y AS que da colonias grises y B-hemolíticas; se diferencian de Pseudomonas en que Acinetobacter es oxidasa-; son fácilmente confundible con Neisserias porque es bacilo muy pequeño (coco-bacilo); también es muy resistente a los ATB.
Genero Corinebacterium - pequeños bacilos inmóviles a temperatura corporal, se comportan como Gram+, suelen agruparse en formas geométricas parecidas a letras chinas o abecedario (empalizadas); presenta granulaciones metacromáticas, catalasa+, anaerobios facultativos y pueden dar lugar a un velo superficial en medios líquidos; presentan ciertos rasgos comunes con Mycobacterium en su pared bacteriana que es muy rica en ácidos micólicos, arabinosa y galactosa, aunque la tinción de BAAR (Zhiel-Nielssen) para Corinebacterium resulta negativa; la especie mas importante es Corinebacterium diphteriae.
Acción patógena e interés clínico de Corinebacterium diphteriae - el bacilo diftérico llega al hombre por vía respiratoria a traves de gotitas de saliva (pflugge) u objetos recientemente contaminados invadiendo la oro-faringe y las amígdalas; desde aquí se extiende, liberando toxinas y enzimas inhibiendo la síntesis proteica celular, originando necrosis en las celulas epiteliales que invade; este epitelio necrosado junto con leucocitos y fibrina formara una pseudomembrana que cubre las amígdalas, que puede llegar a provocar una obstrucción respiratoria si se extiende por la naso-faringe y laringe; tal pseudomembrana se encuentra fuertemente adherida a las mucosas, de forma que si se intenta arrancar, originaria al paciente una fuerte hemorragia; en general los signos y sintomas de la difteria suelen ser de tipo respiratorio; en casos excepcionales, por vía linfática podría pasar a la sangre difundiéndose al resto del organismo.
La familia Mycobacteriaceae engloba un solo genero Mycobacterium; son pequeños bacilos finos rectos y a veces incurvados, excepcionalmente pueden encontrarse algo filamentosos; son inmóviles con una pared típica y característica no encontrada en ninguna otra familia excepto Nocardia (altamente enriquecida con ácidos micólicos y componentes céreos que se tiñe muy difícilmente - responde a Gram+), se necesitan colorantes con alta capacidad tintorial para su penetración; una vez teñidos son altamente resistentes a la decoloración ácida (AAR+ o acido alcohol resistencia positivo) lo que les diferencia del resto de microorganismos; son muy distribuidos en la naturaleza, pueden ser saprofitos del agua y suelo y puede provocar infecciones graves al hombre y en ocasiones crónicas como la lepra; necesita gran cantidad de oxigeno para sobrevivir (aerobias estrictas).
Las especies mas importantes del genero Mycobacterium (3 importantes grupos):
(1) Bacilos de Mycobacterium cultivables en medios artificiales, de crecimiento lento (>1semana hasta 3 semanas); en función de los cuadros clínicos se subdividen en 2 grupos:
a. especies que producen tuberculosis al hombre y a los animales (Mycobacterium tuberculosis y Mycobacterium bovis).
b. especies de micobacterias atípicas de crecimiento lento, podrían presentar un poder patógeno para el hombre distinto al de la tuberculosis y la lepra (Mycobacterium avium y Mycobacterium marinum).
(2) Micobacterias de crecimiento rápido (<1semana); no tiene interés clínico (no son patógenos) para el hombre.
(3) Bacilos de Mycobacterium no cultivables sobre medios artificiales y patógenos para el hombre (Mycobacterium leprae) y ciertos roedores (Mycobacterium lepraemurium)
Los micobacterias también se pueden clasificar en función de la producción de pigmentos, de las morfologías de las colonias y de la velocidad del crecimiento.
Acción patógena e interés clínico
Mycobacterium tuberculosis - responsables de tuberculosis en el hombre
Muy rica en componentes lipídicos en su pared celular dotándole un carácter tintorial especifico AAR+ que servirá para su identificación y clasificación; contiene proteínas que provocan la formacion de Acs (reacción de la tuberculina /test de Mantoux); es capaz de crecer en el interior de las celulas que constituyen el sistema retículo endotelial, se multiplican dentro de ellas sin ser destruida; en el frotis de baciloscopia se puede observar forma cordones microscópicos.
Llega al hombre por inhalación (excepcionalmente por ingestión de alimentos contaminados con Mycobacterium o a traves de las heridas de la piel); produce una lesión primaria en el pulmón y mas concretamente a nivel de los alvéolos pulmonares, provocando una intensa reacción inflamatoria que da lugar a exudación; estos bacilos pueden llegar hasta los vasos linfáticos y de aquí a los ganglios, retornando a la circulación venosa y originando focos metástasis en distintos órganos; sin tratamiento se va desarrollando evolucionando hacia una necrosis "caseosa" (parecida a queso de caverna); después de 6 semanas o mas va evolucionando hacia una destrucción y desintegración de las celulas pulmonares con la formación de una masa solida, homogénea, parecida al queso (caverna tuberculosa); provocara fiebres mas o menos variables, sudoración por la tarde, adelgazamiento progresivo, tos débil o intensa (a veces con esputos muco-purulentos) y en fases mas avanzada, hemoptisis; en general cualquier parte del organismo podría verse afectada a causa de diseminación (gastrointestinales, genito-urinarias, pericárdicas, etc.)
Mycobacterium leprae - productoras de la lepra en el hombre
Se multiplica con extraordinaria lentitud y su clínica es bastante insidiosa y no ha podido ser cultivado en ningún medio in vitro, por lo que se conocen poco sus características microbiológicas; su único reservorio es el hombre con autentica predilección por las terminaciones nerviosas; es un bacilo inmóvil, rectilíneo, se tiñe con Zhiel-Nielssen (AAR+); suelen encontrarse en la mucosa nasal, en la dermis y en biopsias de lesiones en individuos con lepra;
La vía de entrada es a traves de lesiones en la piel, se propagan a los nervios superficiales próximos, concretamente a las celulas de Schwam; de aquí propagarse via linfática al sistema venoso y disemina a otros órganos (lepra lepromatosa); se multiplica mejor en las partes mas frías del organismo (la cara, extremidades) invadiendo los nervios mas superficiales; el bacilo se multiplica en el interior de los macrófagos de la piel y las celulas de Schwam, originando inflamación y perdida de sensibilidad; en estado grave también aparece en órganos mas profundos y su pronostico es mas complicado; su periodo de incubación es muy difícil de determinar, puede durar muchos años; su periodo de invasión es muy insidioso, sintomas raros y no asociables a lepra (picor, hormigueo y perdida de sensibilidad en las manos/pies; a partir de aquí, de forma lenta y progresiva aparecen lesiones cutáneas (maculas prominentes en extremidades y cara); su periodo durara toda la vida y su evolución mas o menos grave dependerá del grado de inmunidad del huésped; tto => ATB sistemico.
Micobacterias atípicas - producido por Mycobacterium avium y Mycobacterium marinum
Las micobacterias atípicas son m.o. patógeno para el hombre, frecuentemente de carácter pulmonar, a veces confundido con Mycobacterium tuberculosis ya que la sintomatología es similar => tras una invasión, se producen formación de tubérculos y consiguiente necrosis caseosa con formación de cavernas, diseminación y cuadros de fibrosis pulmonar con rara aparición de focos extra-pulmonares; la gravedad de lesiones depende del estado inmunológico del paciente; los gérmenes invadirá especialmente individuos inmunodeprimidos; la vía de entrada es muy variable (respiratoria o mucosas).
Aislamiento - caracteres bioquímicos - diagnostico
a)- Aislamiento de Mycobacterium tuberculosis
- Muestras puede proceder de esputo, aspirado bronquial, aspirado gástrica; LCR e orina; la muestra de esputo han de someterse a una descontaminación, homogenización y concentración (mediante centrifuga) previa al cultivo; LCR, orina, etc. se puede sembrar directamente, pero lo mejor seria centrifugar-lo antes.
- Se realizara un examen microscópico del frotis previa tinción de Zhiel-Nielssen (AAR); también se pueden utilizar tinciones fluorescentes (auramina, rojo de tiacina, naranja de acridina), cuando se sospecha que hay pocos bacilos (todo se trabaja bajo la campana de flujo laminar).
- Para aislar el bacilo de Koch de muestras estériles (LCR, orina) se utilizara medios líquidos como Proskauer-Beck; si pretendemos hacerlos crecer en medios sólidos (esputo), existe medios específicos como Lowenstein-Jensen o Coletsos, que contienen huevo, aminoácidos, sales minerales y verde malaquita (inhibe los gérmenes contaminantes) cuyo crecimiento es lento (2-4 semanas); también existe agar Middlebrook que se suele emplear junto con el anterior para completar su identificación; Micobacterias son muy exigentes en su crecimiento => incubar a 37ºC, en la oscuridad, en el ambiente con CO2 de 5-10% (en 1ª semana) y en atmósfera normal a partir de la 2ª semana; los tubos desenroscados hasta que se evaporen el agua (sin secar el medio); la mayoría tardan entre 3-6 semanas en crecer (algunos aun mas); si hay crecimiento, se hará la identificación de su morfología mediante tinción de Zhiel-Nielssen y pigmentos.
- Pruebas bioquímicas => la mas importante es la prueba de la niacina+ (todas las micobacterias producen ácido nicotínico durante su crecimiento; M.tuberculosis no metabolizan el ácido nicotínico y por ello lo acumulan y es excretada al medio, sobre todo en medios con base de huevo, del cual puede ser extraída y detectada); es nitratasa+ y catalasa+ (solo algunas cepas de Mycobacterium tuberculosis no tienen la catalasa; en general tienen catalasa termolábil (a temperatura alta no tienen catalasa).
- Pruebas serologícas => la mas utilizada es la técnica ELISA; actualmente la identificación se hace con el PCR, posteriormente se realiza la hibridación con las sondas genéticas (ADN) de M.tuberculosis marcadas.
- Pruebas de alergia /la prueba de la tuberculina (Mantoux); tuberculina es un extracto proteico de bacilo tuberculoso; es solo toxico para individuos que han estado en contacto con dicho germen, originando una reacción intradérmica en la cara anterior del brazo intensa; este eritema endurado (pápula de >10mm es positivo) se debe leer hacia 48-72 horas (se mide la pápula no la zona roja); después de las 4-6 semanas posteriores al contacto, la prueba del Mantoux dará de por vida positiva.
b)- Aislamiento de Mycobacterium leprae
- Muestras a partir de heridas sospechosas en piel y otras localizaciones.
- Se realiza una tinción de Zhiel-Nielssen o AAR, que deberá dar positiva
- No podrá ser cultivada en medios de cultivo
- Se realizara un diagnostico serológico (un estudio de la inmunidad celular y humoral del individuo)
- Pruebas cutáneas: (depende del resultado, se hace los 3 pruebas o solo algunos).
1. reacción de la lepromina => para conocer el tipo de lepra que posee ese individuo (prueba de intra-dermorreacción /Ag de bacterias inactivadas); Las personas que no tienen lepra tendrán poca o ninguna reacción de la piel al Ag. Los pacientes con un tipo particular de lepra, llamado lepra lepromatosa, no tendrán ninguna reacción de la piel al Ag; una reacción positiva de la piel se puede observar en pacientes con lepra tuberculoide y lepra dimorfa tuberculoide.
2. test de pilocarpina => para buscar la ausencia de sudoración de la piel lesionada después de una inyección de clorhidrato de pilocarpina.
3. test de la histamina => inyectar histamina de tal forma que en una piel sana aparecerá una reaccion alérgica característica, mientras que en las lesiones lepromatosas esto no sucede debido a que los nervios periféricos están lesionados y no aparecerá ninguna reacción alérgica.
c)- Aislamiento de Micobacterias atípicas
- Recogida de muestra de los lugares sospechosos en total asepsia
- Tinción de Zhiel-Nielssen (positiva); tinción fluorescencia con auramina, rojo de tiacina, naranja de acridina.
- Cultivos en medios Lowenstein-Jensen, Coletsos o caldo Middlebrook, donde se puede observar el aspecto de las colonias, su velocidad de crecimiento y la presencia de pigmentos.
- Pruebas bioquímicos: niacina- (la diferencia de Mycobacterium tuberculosis), catalasa+, nitratasa+.
- Pruebas serologícas de ELISA
Actualmente en grandes laboratorios, se utilizan medios de cultivos radiométrico (Bactec TB) de deteccion mas rapida que contiene liquido de soporte (agar Middlebrook) con ATB para inhibir los demas gérmenes y el sustrato marcado con un isótopo del carbono C14; las micobacterias al crecer metabolizan el sustrato y liberan gas CO2 marcado radioactivamente que es detectada automáticamente por el Bactec y una vez que se ha detectado crecimiento en alguno de los medios, se realiza la tinción de Ziehl-Neelsen para ver si lo que ha crecido son BAAR o no.
Baciloscopias - las extensiones para baciloscopias se deben hacer previamente a la descontaminación (CHNa 2-4%) de las muestras y homogenización (N-acetil cisteina) , posteriormente su concentración por centrifugación; la preparación del frotis del esputo ha de hacerse seleccionando la parte mas purulenta que es donde hay mas micobacterias; cuando se lleva acabo la tinción de los frotis, se debe evitar el contacto físico entre las portas para evitar contaminación cruzada; es importante cuantificar el numero de bacilos encontrados ya que esta directamente relacionado con el grado de contagiosidad del paciente y con la gravedad de la infección.
El genero Nocardia - corresponde a actinomicetos aerobios que forman micelio vegetativo que tiende a fragmentarse originando estructuras bacilares o coco-bacilares; Gram+ inmovil, aerobios estrictos y AAR+ (tiene características análogas al Mycobacterium) poseen gran cantidad de acidos micolicos de cadena larga en su pared bacteriana; poseen ademas glicolípidos y fosfolípidos que sirve para su identificacion y diferenciación; algunas especies son patógenas para el hombre.
Acción patógena e interés clínico
Gran parte de nocardiosis son infecciones de carácter oportunista; no produce toxinas, pero contiene en su pared bacteriana alta proporción de lípidos que le confiere una resistencia a los sistemas de defensa (macrófagos, linfocitos, etc.); tiene capacidad de crecer y multiplicarse en el interior de los tejidos (macrófagos) como parásito intracelular y solo crece cuando las defensas del individuo se encuentran bajas; las manifestaciones clínicas mas frecuentes son:
A. Nocardiosis pulmonar - causada sobretodo por Nocardia asteroides que produce lesiones pulmonares con abscesos, inflamación diseminada semejante a la tuberculosis; pueden surgir áreas de necrosis y diseminarse por sangre a otros órganos provocando septicemia.
B. Micetomas (lesiones granulomatosas) de carácter crónico originadas en el tejido subcutáneo donde se producen tumefacción, abscesos y pústulas y/o nódulos que al abrirse presentan exudados sero-sanguinolentos; generalmente causados por Nocardia brasiliensis y es frecuente en las extremidades inferiores y superiores; presenta periodos de remisión y es característico de climas tropicales;
Anaerobias - todas aquellas bacterias incapaces de crecer y/o mantenerse en contacto con O2 a la presion atmosférica; presentan un metabolismo anoxibiótico => incapaz de utilizar O2 de la atmósfera como aceptor final de electrones; en su lugar utilizan sustratos orgánicos como aceptores finales de electrones (respiración anaeróbica /fermentacion); la presencia de O2 puede ser (1) bactericida /toxica /letal directa o bacteriostático (crecerán de nuevo cuando las condiciones son favorables); (2) inhibir ciertos sistemas enzimáticos o la función reguladora primordial del metabolismo celular; (3) generan producto tóxicos al interaccionar sus componentes propios con O2; los anaerobios son las bacterias predominantes en la flora normal humana y en algunas partes p.ej. boca o intestino están en proporción de 1000:1 con respecto a la flora aerobia, por tanto, la mayoría de la infección que provoca los anaerobios son endógenas; dentro de los anaerobios se distingue => anaerobios estrictos y anaerobios aero-tolerantes /microaerofílicos (puede crecer a 2-8% de O2).
Genero Clostridium - bacterias anaerobias esporuladas; son bacilos Gram+, anaerobios estrictos, forman esporas a nivel terminal o subterminal, presentan flagelación perítrica, móviles, no presentan capsulas excepto Clostridium perfringes; ampliamente distribuidas en el suelo, agua, etc. y altamente resistente a medios externos; responsable de infecciones e intoxicaciones muy graves (tétanos, botulismo, gangrena gaseosa, etc.); las especies mas patógenos actúan mediante la formación de toxina con poder toxico sobre el huésped; algunos podrían formar parte de la flora normal del hombre y animales.
Las especies mas importantes
A. Clostridium que originan toxinas cuyo mecanismo de acción es neuro-toxico => Clostridium tetanii - el agente etiológico de tétanos y Clostridium botulinum - agente etiológico del botulismo.
B. Clostridium que originan toxinas que actúan sobre tejidos provocando histo-toxicidad => Clostridium perfringes - agente etiológico de la gangrena gaseosa; para su penetración en el organismo se requieren lesiones previas.
C. Clostridium que originan toxinas que actúan sobre el tracto digestivo (clostridios entero-toxicos) => Clostridium difficile - responsable de trastornos gastrointestinales no graves.
D. Clostridium responsables de cuadros purulentos (clostridios piógenos) => Clostridium perfringes; es frecuente la presencia ademas, de otras bacterias anaerobias.
Acción patógena e interés clínico
A. Clostridium que ejercen acción neuro-toxica sobre las personas (C.tetanii y C.botulinum)
Clostridium tetanii - es un bacilo Gram+ pequeño, formadora de esporas (aspecto de tambor o cerilla), habitan la tierra y el intestino del hombre y animales; produce 3 toxinas responsables del cuadro típico del tétanos que son transportadas vía sanguínea o humoral hasta SNC bloqueando la liberación de neurotransmisores, originan hiperactividad de las neuronas motoras que da lugar a convulsiones y parálisis espástica o espasmo muscular a nivel periférico; se ve alterado el sistema muscular variando el ciclo de contracción-relajación de forma que este entra en fase de contracción y no se recupera (rigidez tetánica / epistótonos).
Para que se produzca el tétanos es necesario una serie de condiciones tales como que el microorganismo germine (condiciones adecuadas de anaerobiosis); tras una herida profunda (cortante, punzante, mordeduras, arañazos, partos, abortos, quemaduras, ulceras por decubito) o herida superficiales (rozaduras) se pueden infectar y formar costra que facilita la infección anaerobia; en las condiciones favorables de anaerobiosis, las esporas de Clostridium tetanii en el ambiente pasan a la herida, germinan y tras un periodo de incubación (5-7 días), se origina su acción patógena; es rara que se produzca de forma local en la zona de entrada; la forma generalizada es mas habitual y mas grave; es importante la detección precoz y medidas profilácticas (vacunación se renueva cada 10 años).
Clostridium botulinum - bacilos Gram+ anaerobios estrictos, grandes, móviles por su flagelación y presentan esporas; es capaz de formar neuro-toxinas peligrosas y potentes sobre las personas que originan parálisis o debilidad muscular; las esporas son distribuidas ampliamente en el aire, suelo, ciertos alimentos (conservas, pescados, etc.); si las condiciones en el ambiente son de anaerobiosis, germinaran; su accion patógena sobre el organismo sera neuro-paralizante y con una dosis de 10 elevado a -8 (10 nanogramos) de su toxina es suficiente para causar la muerte (es el veneno mas potentes hasta ahora), que solo se producen en condiciones adecuadas de anaerobiosis, temperatura en torno a 30ºC, pH neutro o ligeramente acido y permiten que germine la espora; sus toxinas son de carácter proteico y termolábiles (se destruyen a temperatura 100ºC durante 5 minutos o 70ºC de 30-60 minutos).
El mecanismo de acción de las toxinas botulínicas => a traves de los alimentos contaminados llega esta neuro-toxina al tubo digestivo del hombre y producirá toxinfección alimentaria inicialmente; de aquí via sanguínea y linfática llega hasta sistema nervioso periférico donde actúa en las terminaciones nerviosas, originando parálisis en el musculo esquelético y otras manifestaciones neurológicas como visión borrosa, fotofobia, sequedad de boca, lengua y faringe, disfagia, disartria (dificultad al hablar), debilidad de los musculos (flacidez) incluyendo los respiratorios que puede llegar mortal por fallo respiratorio y arritmias cardíacas (depende de la cantidad de toxina o del germen); su periodo de incubación en torno 18-36 horas después de la ingestión del alimento contaminado y los cuadros mas graves se originan en un periodo de incubación inferior a 24 horas.
B. Clostridium que ejercen acción histo-toxica en múltiples tejidos
Clostridium perfringes - ejercen un efecto toxico importante pero no actúan sobre SNC; son Gram+, anaerobia estricta, la única especie capsuladas, ampliamente distribuida en el suelo; de aquí a traves de heridas profundas, puede pasar al hombre produciendo gangrena gaseosa; también puede encontrarse en la flora intestinal; capaz de formar toxinas que actúan sobre los tejidos, entero-toxina, hemolisina, neuroaminidasa.
El mecanismo de acción => tras la vía de entrada (heridas) en condición anaerobiosis adecuadas, germinan las esporas y proliferan; es frecuente que se contaminen con otro tipo de bacterias aerobias que consiguen agotar el oxigeno aumentando las condiciones de anaerobiosis, se disminuye el pH aumentando el acido láctico y facilitando la liberación de las enzimas proteolíticas y sustancias toxicas; se producirán los efectos lesivos y graves sobre los tejidos extendiéndose a los vecinos, se romperán las estructuras celulares a nivel de sus membranas, se destruirán las celulas hemáticas, las celulas endoteliales, las membranas de las celulas musculares originando procesos de dermo-necrosis con daño tisular (gangrena).
Ademas de provocar la gangrena gaseosa a traves de heridas infectadas, C.perfringes es también el agente etiológico de una toxo-infección alimentaria producida por la ingestión de carne contaminada provocando cuadros diarreicos y dolor abdominal leve; existen otros casos mas excepcionales y graves que da lugar a cuadros diarreicos muy acuosos y sanguinolentos, vómitos y estado de shock producido por C.difficile.
Aislamiento - caracteres bioquímicos - diagnostico
- Toma de muestra representativa, adecuada y estéril en medios específicos de transporte anaerobiosis con sustancias reductoras (bolsas generadoras de CO2) que crean atmósferas sin O2 o en una jeringa sin aire (tapando la aguja).
- Se hará un examen directo (tinción de Gram) donde se pueden apreciar las formas de esporas (palillos de tambor); también se puede realizar tinción de esporas.
- Se cultivaran en medios de cultivos específicos como ASA (agar sangre anaerobio); incubación a 37ºC en 48 horas en condición anaerobisis, utilizando una campana con un sobre generador de gas CO2, da lugar a la liberación de H y CO2; el O2 que existe en el anterior de la campana, se une al H, forman H2O que se depositan en forma de gotitas en las paredes, también hay que introducir un indicador de anaerobiosis (una tira reactiva).
- Pruebas bioquímicas => cuando existe crecimiento en el medio anaerobio, se monta directamente el API en un recipiente/ una caja, también anaerobio.
Bacterias anaerobias no formadoras de esporas - crecen en ambientes de bajo potencial oxido reductor o ambientes microaerófilos; son ampliamente distribuidos en la naturaleza y muy pocas capaces de producir cuadros patógenos graves al hombre; gran parte de ellos forman parte de la flora gastrointestinal, vaginal o bucal del hombre, no ejerciendo efecto patógeno alguno.
Las especies mas importantes
A. Bacilos Gram+ no esporulados:
- Lactobacillus => microaerófilos, crecen mejor en anaerobiosis; son flora habitual de la boca, vagina e intestino del hombre; son de gran utilidad a nivel industrial (produce acido láctico para los yogures); no intervienen en ningún proceso patógeno para el hombre.
- Propionibacterium => son anaerobios, pueden crecer en ambientes microaerófilos; forman parte de la flora normal intestinal, tracto urinario y piel.
- Bifidobacterium => es flora intestinal del hombre y no son patógenos.
B. Bacilos Gram- no esporulados:
- Bacteroides => son flora intestinal, vaginal y bucal del hombre y se ha asociado en ocasiones a procesos gastrointestinales, especialmente Bacteroides fragilis que actúa como oportunista.
- Fusobacterium => solo la especie Fusobacterium nucleatum se asocia a algunos procesos patógenos en el aparato respiratorio y tracto genital femenino, de carácter oportunista.
C. Cocos Gram+ no esporulados:
- Ciertos Streptococcus anaerobios que se encuentran frecuentemente en la flora gastrointestinal y bucal; no son patógenos.
- Peptococcus => no produce efecto patógeno sobre el hombre
D. Cocos Gram- no esporulados:
- Veillonella => forma parte de la flora intestinal y bucal y no son patógenos para el hombre.
Acción patógena e interés clínico
Salvo excepciones, no son relacionados con procesos patógenos y la patogenicidad que pudiera desencadenar alguno de ellos depende sobre todo de las circunstancias del huésped (oportunistas); pueden producir infecciones post-quirúrgicas, complicaciones de escaras o ulceras por decubito, complicaciones de herida en general.
Aislamiento - caracteres bioquímicos - diagnostico
- Toma de muestra en condiciones adecuada (anaerobiosis)
- Examen directo (tinción de Gram)
- Se aislaran en medios anaerobiosis (ASA/ANA - agar sangre anaerobio)
- Pruebas bioquímicas se realiza con API en condición anaerobia
Tema 24 - Espiroquetas (Treponema, Borella y Leptospira); patología e identificación
La familia Espiroquetaceas (con interés clínico para el hombre) - Treponema, Borrelia y Leptospira; corresponden a especies bacterianas cuya morfología es filamentosa, helicoidal o espiral con filamentos axiales relacionados con su movilidad; presenta una pared celular fina y flexible de lipo-polisacárido y lipo-proteica donde se encuentran la mayoría de Ags específicos de estas; son Gram- (difícilmente se tiñe), también se pueden visualizar por el microscopio de contraste de fases; presentan un metabolismo oxidativo y/o fermentativo (aerobias o anaerobias facultativas); difundidas en las aguas, el suelo y como agentes comensales en las mucosas del hombre y animales.
La familia Espiroquetaceae se divide en 5 generos:
- Genero Espiroqueta => espiroquetas mas grandes y no existen especies patógenas para el hombre.
- Genero Cristispira => son de tamaño algo menor que el Espiroqueta y no es patógeno para el hombre.
- Genero Treponema => son espiroquetas muy helicoidales, muy finas, pequeñas y móviles; son microaerofílicas y presentan un metabolismo fermentativo; existen especies patógenas para el hombre - Treponema pallidum (el agente etiológico de la sífilis).
- Genero Borrelia => son espiroquetas mas grandes que Treponema; son microaerofílicas y presentan pocas espiras que son amplias e irregulares; su metabolismo es fermentativo y son difíciles de cultivar en medios artificiales; pueden provocar fiebres recurrentes al hombre transmitido por artrópodos.
- Genero Leptospira => son espiroquetas largas, muy finas y con numerosas espiras, profundas y regulares; es difícil su visualización aunque se suele utilizar microscopia de contraste de fases; son aerobias con un metabolismo oxidativo; se cultivan con facilidad en medios artificiales; ampliamente distribuidas en la naturaleza, especialmente en las aguas; pueden parasitar al hombre provocando leptospirosis.
Genero Treponema - son espiroquetas pequeñas, finas con un numero de espiras entre 5-20 distribuidas de forma regular, con gran movilidad; se tiñe difícilmente con Gram y se tiñe mejor con Giemsa o tincion de plata y se visualiza con la microscopia de campo oscuro y de contraste de fases; no crece en medios de cultivo in vitro y requiere un medio de cultivo in vivo para crecer (testículo de conejo); crece bien en situaciones de bajo potencial oxido-reductor (microaerofila), presentando en ocasiones una respiración anaerobia y un metabolismo fermentativo; el especie patógena para el hombre es Treponema pallidum que transmite la sífilis por contacto directo; existen dentro del genero Treponema especies comensales de las mucosas, tracto urinario, vaginal, tubo digestivo, etc. que no son patógenos para el hombre y se pueden cultivar.
Treponema pallidum es la especie mas importante por su difusión cosmopolitana; es el agente causal de sífilis; no son capaces de vivir fuera del organismo humano, ya que mueren por desecación; su transmisión es por contacto directo (vía sexual) y si no se detecta a tiempo puede durar toda la vida; mecanismo de acción:
- Periodo primario de la sífilis => comienza tras un primer contacto con lesiones ricas en treponemas presentes en las mucosas; periodo de incubación 10-90 días (termino medio de 21 días) aparece en la zona genital un chancro primario con abundantes treponemas, se van diseminando vía hemática y linfática a otras localizaciones convirtiendo-se en una enfermedad sistémica; es frecuente su multiplicación en ganglios próximos a la zona genital originando pequeñas tumoraciones (adenopatias); transcurrido un tiempo corto de 2-6 semanas estos signos desaparecen espontáneamente y entra en una fase silente.
- Periodo secundario o sífilis florida => surge después de un tiempo entre 2 meses y 2 años de la fase silente; de forma súbita se produce una espiroquetemia en general muy florida por las manchas en la piel y en las mucosas, muy ricas en treponemas y altamente infecciosas; también puede surgir excepcionalmente una forma eruptiva como lesiones en otros órganos, fiebre en ocasiones, pústulas o pápulas muy ricas en treponemas; este cuadro clínico de carácter sistémico remite a las pocas semanas (2-6 semanas), volviendo a entrar en una nueva fase de latencia.
- Periodo terciario o sífilis terciaria => surge tras la fase de latencia entre 3-30 años, una forma muy grave con mal pronostico; el numero de treponemas en sangre es muy escaso y muy abundante en ganglios, bazo, huesos, sistema nervioso (neuro-sífilis) y aparato cardiovascular; es frecuente la formación de granulomas, necrosis, gomas, parálisis general progresiva, aneurisma aórtico, etc.
Resumen de la evolución de sífilis => Incubación 10-90 días (termino medio 21 días) - Periodo primario (2-6 semanas) - fase silente (2 meses - 2 años) - Periodo secundario/ sífilis florida (2-6 semanas) - fase latente (3-30 años) - Periodo terciario/ Neuro-sífilis forma muy grave con mal pronostico.
Aislamiento - caracteres bioquímicos - diagnostico del genero Treponema pallidum
- Treponema pallidum se aísla muy difícilmente, no crece en medios in vitro, solo lo hace en medios in vivo (testículos de conejo) y el diagnostico de la infección se establece durante los periodos primario y secundario mediante muestras de exudados, condilomas, etc.
- Examen directo al microscopio de campo oscuro o microscopio de contraste de fases o microscopio de fluorescencia de una tinción de Giemsa o tinción Nitrato de plata (sales de plata; es una técnica difícil de efectuar, reservada a los laboratorios especializados, útil en la detección de Pneumocytis carinii, Legionella, Treponema, hongos, Rickettsias).
- Pruebas serologícas => se realiza la prueba de la presencia de Acs anti Treponema pallidum en el suero del paciente con Ags específicos de Treponema pallidum que presentan una sensibilidad y fiabilidad del 100%; los resultados dependen del periodo de sífilis en el que se encuentre; también se incluyen las inmunofluorescencia indirecta, así como las de hemo-aglutinación pasiva partiendo de hematíes tratados con Treponema pallidum que es muy sensible y económica.
Diagnostico serológico de las sífilis - existe 2 tipos de pruebas (no treponémicas y treponémicas)
a) No treponémicas => son de gran sensibilidad y fácil de hacer; se usa para prueba de screening y si resulta (+), hay que confirmar con pruebas treponémicas; también se utiliza como un seguimiento de la enfermedad; se le llama también prueba de WASSERMANN; consiste en enfrentar el suero del paciente con sustancia lipídica "cardiolipina" que no es Ags treponémicos; si existen Acs anti Tp en el suero, reaccionaran con la cardiolipina (+); pero al no ser la cardiolipina un Ags treponémicos, puede dar lugar falsos positivo con otras enfermedades; 2 tipos de pruebas => VDRL (Venereal Disease Research Laboratory) y RPR (reagina plasmática rápida) son pruebas de aglutinación con partículas de carbón (darán grumitos grises).
b) Treponémicas => se utilizan como prueba confirmativas con varias técnicas: (1) FTA (técnica fluorescencia de Acs anti Tp) enfrentando Ags de Tp con posibles Acs anti Tp en el suero del paciente; (2) FTA abs donde previamente se absorben posibles Acs naturales anti Tp saprofitos; (3) TPHA (Tp Haemagglutination Assay) que tiene como base hemaglutinación y sencillo de realizar (no se necesita microscopio fluorescencia); (4) también se puede utilizar pruebas de ELISA para detectar IgM y IgG; todas son pruebas muy especificas; no se utilizan para el seguimiento, porque sera siempre resulta (+).
Genero Borrelia - son espiroquetas de mayor tamaño con espiras mas amplias e irregulares con extremos afilados y son móviles; las especies patógenas para el hombre y los animales, originan fiebres recurrentes endémicas y epidémicas; es microaerofílica con un metabolismo fermentativo; se tiñen con facilidad de Gram- y se puede cultivar in vitro, pero requiere medios muy específicos; las especies mas importantes del genero Borrelia, se transmiten por piojos y por garrapatas.
Acción patógena e interés clínico - las fiebres recurrentes son una enfermedad muy cosmopolita, en ocasiones endémica a condiciones de salubridad muy baja; tras la picadura del vector, ya sea garrapata o piojo, pasan las borrelias a la sangre del huésped, ayudadas por el rascado que provoca el aplastamiento del piojo /garrapata, que dará lugar a micro-traumas en la piel y facilitan el paso de dichas borrelias; después de unos 7 días de incubación se originan fiebres, dolores musculares, cefalea, etc; clínica que dura unos 10 días y luego desaparecer, produciendo posteriormente recurrencias; no es una enfermedad grave y es fácil de tratar, especialmente con tetraciclinas.
Genero Leptospira - son espiroquetas muy finas con espiras regulares, muy numerosas y apretadas, con sus extremos ligeramente incurvados y móviles; se tiñen débilmente con Gram, también se pueden teñir con Giemsa; su metabolismo es oxidativo (crecimiento aerobio); existe en la naturaleza leptospiras saprofitas y parásitas; puede originar de forma casual leptospirosis en el hombre con cuadros febriles; el reservorio son animales, consideradas como zoonosis.
Genero Rickettsia - son parásitos celulares estrictos (porque su dotación enzimática es muy escasa) de los artrópodos (crecen muy bien en el citoplasma); son coco-bacilos Gram-; producen en el hombre enfermedades transmitidas por piojos, garrapatas, pulgas y ácaros.
Especies mas importantes de la familia Rickettsiaceae - hay 3 géneros importantes => Rickettsia, Rochalimaea y Coxiella (Coxiella burnetti es coco-bacilo Gram+ que origina la fiebre Q).
Acción patógena e interés clínico:
(1) Tifus exantemático epidémico - producido por R.prowazekii; mediante la picadura de piojo; tras el periodo de incubación de 1-2 semanas, aparecen escalofríos, fiebres altas (40ºC), cefaleas, dolores generalizados, nódulos inflamatorio de los capilares, arteriolas, vénulas, la piel y musculos (dificulta la corriente sanguínea y en casos graves puede provocar gangrena en las extremidades); es frecuente la formación de maculas rosadas y posteriormente pápulas y petequiales.
(2) Tifus murino o endémico - producido por R.typhi mediante la picadura de la pulga, garrapatas y ácaros; tras el periodo de incubación de 4-15 días, se produce fiebres altas, cefaleas, artralgias y mialgias generalizadas con un cuadro clínico leve sin complicaciones ni recidivas como el tifus exantemático.
(3) Fiebres manchadas de las montañas rocosas - producida por R.rickettsii trasmitidas por las garrapatas; tras el periodo de incubación de 3-6 días, aparecen fiebres altas, mialgias generalizadas y una mancha negra en la zona de la picadura; en España la especie mas extendidas es R.conorii, el agente de la fiebre botonosa o exantemática mediterránea, transmitida al hombre por la garrapata (sobre todo del perro); tras el periodo de incubación de 2-6 días provoca una mancha negra a modo de botón en el lugar de la picadura, fiebre, artralgias, mialgias generalizada y manchas maculo-papulosas; no se suelen complicar y responden bien al tratamiento.
(4) Fiebre Q - producida por Coxiella burnetii mediante inhalación de esta u otras (presencia de artrópodos), la vía de entrada no se conocen hasta la fecha; tras el periodo de incubación de 3 semanas, se produce un estado febril con mialgias generalizadas y cuadro clínico leve.
Aislamiento - caracteres bioquímicos - diagnostico del genero Rickettsia
Se toma 2 muestras de sangre en estadios febriles (cuando hay mas Rickettsia):
- La 1ª se centrifuga para obtener un sedimento sanguíneo (concentración alta de Rickettsia); se usa para realizar varias tinciones p.ej. May-Grunwald-Giemsa (las rickettsias aparecen de color purpura), tinción Gram (resulta negativo para Rickettsia y positiva para Coxiella burnetii), tinción inmunofluorescencia y estudios de microscopia electrónica (para observar); el sedimento también se usa para sembrar en medios de cultivo celular o embriones.
- De la 2ª se obtiene sueros para pruebas serologícas (buscando títulos de Acs), con tecnicas inmunofluorescencia, seroaglutinación o ELISA.
Genero Chlamydia - se consideran mas próximos a virus que a bacterias; son parásitos intracelulares estrictos (carecen de mecanismo biosintético auto-suficiente) del hombre y animales; son cocos pequeños de Gram-, inmóviles; poseen ADN y ARN y su multiplicación es por división binaria (a diferencia de virus); es capaz de vivir en medios intracelulares durante mucho tiempo sin presentar una sintomatología clara lo que facilita la cronificación de procesos infecciosos.
Especies mas importantes - dentro de la familia Chlamydiaceae:
- Chlamydia psittaci => parásito intracelular de animales y excepcionalmente del hombre (tras la inhalación de heces de pájaros infectados), provocando brotes neumónicos de distinta gravedad.
- Chlamydia trachomatis => parásito intracelular del hombre, provocando infecciones sistémicas o locales de distinta gravedad y afectando especialmente a los genitales y a los ojos.
Acción patógena e interés clínico - se multiplican en el citoplasma de la célula que parásita, presentando un ciclo con 2 tipos celulares diferentes:
- En 1er periodo formara una célula densa o corpúsculo elemental con gran resistencia a la sequedad, lo que permitirá la dispersión de Chlamydia; es la forma infectiva.
- En 2nd periodo formara una célula mas grande de menor densidad o corpúsculo reticulado, que es responsable de la división binaria y por tanto de crecimiento clamidias.
El proceso del ciclo => la forma infectiva (corpúsculo elemental) penetra en la célula que va a parasitar ayudado por los Ags específicos, se produce infección celular, se forma una vesícula citoplasmática que bloqueara los mecanismos de defensa de la propia célula; a partir de aquí este corpúsculo elemental aumenta su tamaño, su pared se hace mas fina y permeable permitiendo el paso de complejos enzimáticos, ATP y otras sustancias que van a necesitar de la célula que parasitan; el citoplasma de la clamidia se hace mas denso y esponjoso y aparece la segunda forma, donde comienza a multiplicarse por división binaria.
Cuadros clínicos de Chlamydia trachomatis:
- Tracoma => tras un contacto directo se produce una infección crónica en el epitelio conjuntival y corneal, siendo frecuentes las recaídas y sobre infecciones con evolución lenta hacia la ceguera; frecuente en edades infantiles.
- Conjuntivitis neonatal => aparece entre la primera y la segunda semana después del nacimiento; surge una conjuntivitis purulenta al neonato, asociada a infecciones genitales por clamidias en la madre; puede evolucionar positivamente o hacia lesiones análogas al Tracoma.
- Linfogranuloma venéreo => es una infección que se trasmite por contacto venéreo.
Aislamiento - caracteres bioquímicos - diagnostico del genero Chlamydia
Debido al elevado riesgo de infección en el laboratorio al manipular clamidias se suelen utilizar metodos indirectos (serológicos) a veces tambien se realiza examenes citologicos en cultivos específicos.
- Se toman muestras de secreciones oculares y/o genitales
- Se realiza un examen directo que incluyen una tinción de Giemsa y de Gram.
- Se realizan técnicas citológicas
- Se realizaran exámenes indirectos mediante técnicas serologícas (la mas frecuente ELISA) que son mas seguras y fiables; existe un kit para buscar clamidias.
Genero Micoplasma - es uno de los microorganismos mas pequeños existentes en bacteriología y se caracteriza por no contener pared celular => sensible a la presión omotica del medio (se lisan facilmente), su morfología es pleomorfismo y resistente a ciertos antibióticos cuya mecanismo de acción se establece en la pared bacteriana; se dividen por división binaria y vivir de forma independiente y crece bien in vitro a partir de medios artificiales enriquecidos; se encuentra extendidos en la naturaleza; son comensales de la mucosa del hombre; existe especies patógenas como Micoplasma pneumoniae que afecta al aparato respiratorio.
Especies mas importantes - dentro de la familia Micoplasmataceae están los géneros Micoplasma y Ureaplasma; solo unas 10 especies pueden producir algún efecto patógeno en las membranas celulares de las mucosas oro-faríngeas y uro-genitales; la mas importante para el hombre es Micoplasma pneumoniae (produce neumonías); el Ureaplasma urealyticum es otra especie patógeno que se asocia a ETS junto con el Micoplasma hominis.
Acción patógena e interés clínico
- Su infectividad se relaciona con su adherencia (debido a una glicoproteína especifica) a los epitelios de las mucosas; su pleomorfismo puede adoptar formas filamentosas y alargadas que aumenta la superficie de contacto a las estructuras epiteliales a las que se une; una vez adherida, los cilios de las celulas epiteliales que tapizan la mucosa se paralizan y provoca alteraciones metabólicas en dichas celulas epiteliales.
- Cuadros clínicos => cuadro pulmonares y mas raramente cuadros genitales o uro-genitales, siendo Micoplasma pneumonia es mas importante como el agente causal mas frecuente de las neumonías atípicas.
- En casos excepcionales se han podido aislar Micoplasma hominis y Ureaplasma urealyticum en procesos uretrales y genitales como salpingitis, vaginitis, prostatitis, cervicitis, etc. (son casos muy raros)
Aislamiento - caracteres bioquímicos - diagnostico
- Se toman muestras de la mucosa faríngea, secreciones uretrales, exudados, muestras de esputo, de sangre, etc según la patología.
- Se realiza un frotis de la muestra que se puede observar en campo oscuro con nigrosina, al microscopio de contraste de fases o con la tinción de Giemsa (se tiñe débilmente).
- Se siembra en medios específicos y con un alto grado de humedad para evitar la desecación.
- Se realiza pruebas bioquímicas => fermentacion de glucosa, prueba de arginina, ureasa, etc.; existe un kit de la detección micoplasmas.
- Metodos serológicos son mas rápidos, mas fiables y mas utilizados en la actualidad (inmunofluorescencia y ELISA).
Genero Campylobacter - son bacilos Gram- cortos con forma de coma, espiral o alas de gaviota (en cultivos jóvenes); son microaerofílicos, móviles por un único flagelo polar; no fermentan los carbohidratos, oxidasa+ y catalasa+; habitan el tracto gastrointestinal de muchos animales; en el hombre se asocian a infecciones gastrointestinales (via de entrada oral/ digestiva), fundamentalmente, y cada vez en mayor grado a infecciones extra-intestinales (meningitis, endocarditis, artritis séptica), especialmente en pacientes con SIDA.
Especies clínicamente importantes para el hombre - C.jejuni, C.coli y C. laridis son agentes etiológicos de diarrea; C.fetus subsp. fetus produce septicemia en pacientes inmuno-suprimidos.
Aislamiento a partir de "heces" - la siembra inmediata en medios selectivos a la toma de muestra; si se tiene que posponer, se utilizaran medios de transporte especiales (Cary-Blair o Campy-Thio) donde se mantiene viables; el cultivo de campylobacter tiene que cumplir 3 requisitos =>
(1) empleo de medios selectivos p.ej. "Campylosel" contiene sangre de cordero con ATB y antifúngico o "Skirrow" contiene sangre de caballo con ATB
(2) uso de atmósfera reducida de O2/ microaerofílica se consigue mediante sistema de evacuación-reemplazo hasta lograr 5% de O2, 10% de CO2 y 85% de N2 o campanas anaerobios con sobres comerciales que generan la atmósfera deseada.
(3) temperatura de 42ºC en aislamiento inicial entre 24-48 horas (para inhibir la flora fecal acompañante), después pasa a 37ºC el 3º día; las placas han de incubar hasta 72 horas antes de descartarse como negativas; a esta temperatura se consigue el máximo aislamiento de C.jejuni y C.coli.
Si pretende aislar otras especies de campylobacter distintas a C.coli y C.jejuni => ha de emplear medios selectivos sin cefalosporinas, incubación a 37ºC, atmósfera microaerofílica, incubación de 7 días.
Identificación - los campylobacter termofílicos dan lugar a colonias grises, incoloras, mucosa y no hemolíticas; se les hace una tinción Gram (bacilos Gram- con forma de S en cultivo joven y en cultivo viejo pueden dar formas cocoideas); se monta un fresco para observar la movilidad; son oxidasa y catalasa positivos; para diferenciar entre las especies se puede montar un API o se realizan varias pruebas => (1) crecimiento a distintas temperaturas, (2) sensibilidad al acido nalidixico y a la cefalotina (3) hidrólisis del hipurato (se introduce una tableta dentro de un tubo inoculado, dará + si cambia a color amarillo).
Campylobacter jejuni => crecimiento a 42ºC, hipurato+, sensibilidad a Nalidixico y resistente a Cefalotina
Campylobacter coli => crecimiento a 42ºC, hipurato-, sensibilidad a Nalidixico y resistente a Cefalotina
Campylobacter fetus => no crecen a 42ºC, hipurato-, resistente a Nalidixico y sensible a Cefalotina
Campylobacter laridis => crecimiento a 42ºC, hipurato-, resistente a ambos Nalidixico y Cefalotina
Patogenia y patologia - C.jejuni es la especie con mayor frecuencia se asocia a infeccion en el hombre (gastroenteritis con eliminación de sangre en heces), se adquiere por via oral (comida y bebidas contaminadas) o por contacto con animales infectados; sensible a pH gástrico (debe ingerirse una concentración elevada de ellos para que se produzca infeccion); se multiplica en el intestino delgado, invade el epitelio y produce inflamación; en ocasiones puede pasar al torrente circulatorio y desarrollarse un cuadro de fiebre entérica; la diarrea acompañada de dolor abdominal agudo, dolor de cabeza y fiebre; la infección es autolimitada resolviendose en una semana sin necesidad de ATB; los casos graves se trata con eritromicina.
Helicobacter Pylori - se aislaron por 1ª vez (1982) del estomago de pacientes con lesiones gástricas y ulcera péptica; son bacilos curvados Gram- con forma de espiral y gran actividad ureasa; se les denomino Campylobacter pyloridis, posteriormente se rectifico a Campylobacter pylori y cuando demostraron que difería morfologicamente del genero Campylobacter, se propuso la creación de un nuevo genero Helicobacter que se incluyo la especie de Helicobacter pylori; se trata de una especie de reciente descubrimiento, implicada en procesos de infección gástrica.
Metodos de detección de H.pylori
- Metodos directos => las muestras mas idóneas para el aislamiento de H.pylori son las biopsias de las zonas pliegues de la mucosa gástrica del antro, cuerpo y fundos; se remitirán directamente al laboratorio para proceder a su cultivo inmediato en medios específicos para H.pylori; una porción de la biopsia se invertirá en la realización de un frotis para la tinción Gram o Giemsa.
- Incubación => las placas deben incubarse en condiciones reducidas de O2 (5%), de 10% CO2 y 85% N2. Se consigue mediante sistema de evacuación-reemplazo o usando jarras de anaerobios con sobres comerciales que generan dicha atmósfera; la temperatura optima es de 37ºC (no se desarrolla a 25ºC, 30ºC ni 42ºC); en aislamiento primario, es conveniente incubar las placas hasta 7 días; Las colonias son de 1-2 mm de diámetro, translucidas y poco hemolíticas.
- Identificación => son oxidasa+, catalasa+, ureasa+, hipurato- (algunas cepas son capaces de virar la urea de Christensen en minutos); es sensible a la cefalotina y resistente al nalidixico (algunas cepas pueden ser sensibles); no son fermentadora de carbohidrato; crece a 37ºC.
Metodos indirectos:
- Prueba de la urea rápida (de Christensen) => un trozo de biopsia se inocula en un medio con alta concentración de urea y un indicador de pH.
- Prueba de la urea respiratoria => el paciente ingiere urea marcada y tras un periodo de tiempo se mide el nivel de CO2 espirado; se puede emplear urea marcada con C13, que se detecta con un espectrofotómetro de masas y urea marcada con C14 detectada con un contador de centelleo (un método diagnostico rápido y no invasivo, pero requiere un equipo especial par al lectura).
- Prueba serología => para detectar Acs utilizando la técnica de ELISA.
Patología - existen pruebas claras de que H.pylori esta implicado en diversas patologías gástricas, pero se cuestiona como la causa de dichas infección; parece claro que es agente etiológico de gastritis aguda; se piensa que también pueda tener un papel en la gastritis crónica activa; en las ulceras pépticas se aísla 100% de pacientes con ulcera duodenal y 77% de ulcera gástrica; parece ser que su presencia no es suficiente para desarrollar la ulcera; no esta claro el papel que desempeña en la dispepsia no ulcerosa, en el reflujo gastro-esofágico y en el carcinoma gástrico; hasta 50% de la población adulta de >60 años es portadora de este microorganismo; se desconoce su modo de transmisión; se ha propuesto una posible adquisición del mismo por contacto con animales, región periodontal y transmisión persona-persona (ninguno están demostrados)
Sensibilidad antibiótica - H.pylori es sensible in vitro a un gran numero de ATB, pero, el tratamiento in vivo es difícil; nunca se emplea mono-terapia porque no es eficaz, suelen administrarse varios fármacos juntos y aun así no se consigue erradicar al m.o. por lo que son frecuentes las recaídas tras la supresión de la terapia.
Introducción - virus es un parásito intracelular estricto que requiere infestar una célula para sintetizar sus componentes y ensamblar nuevos viriones; son de muy pequeños tamaños (filtrables) y se caracteriza por su mecanismo de replicación, organización y composicion; virología clínica se remonta al siglo XX y la composicion de un virus fue determinada por Schlesinger en 1933; en los últimos años se han descubierto otros agentes infecciosos mas simples como los viroides y los priones;
- los viroides => moleculas circulares de ARN de bajo Pm sin cubierta proteica que causan enfermedades a las plantas, infectar a los hombres y animales;
- los priones => son proteínas que parecen estar codificadas por genes celulares y actúan como señales reguladoras en las celulas que invaden, resistentes a los procesos físico-químicos que inactivan a los virus y no producen respuesta inmune o inflamatoria en el huésped; provocan prurigo lumbar de las ovejas y cabras (scrapie), encefalopatía espongiforme en las vacas y enfermedades neuro-degenerativas transmisibles en el hombre (p.ej. Creutzfeldt-Jacob /encefalopatía espongiforme progresiva y síndrome de Gerstman-Straussler-Streinker y el kuru); la patogenia (de todas) se caracterizan por desordenes progresivos como ataxia (dificultad motórica), demencia, deterioro cognitivo y motor; tras un periodo de incubación largo (meses o años), aparecerá los sintomas clínicos; el tropismo de la infectividad es SNC, seguido por el bazo y nódulos linfáticos; en el cerebro se detecta acumulación anormal de proteína-prion en el genoma del huésped; los priones son resistentes a las proteasas e induce una degeneración neuronal.
Concepto de virus - es un bloque de material genético (ADN o ARN) rodeado de una cubierta proteína (cápside) que le sirve como vehículo para su transmisión; algunos presenta membrana lipídica (envuelta) que se adquieren de la membrana citoplasmática de la célula infectada durante el proceso de salida; los virus envueltos tienen un matriz proteica que sirve como puente entre la nucleocápside y la envoltura; carecen de organelas citoplasmáticas para crecer y multiplicarse, por lo que necesitan la maquinaria de una célula huésped, pero si poseen algunos enzimas (nucleasas, transcriptasas, etc.); virión es la partícula viral completa (genoma + nucleocápside); se clasifican por el tipo de huésped que parasitan (virus animales, vegetales, bacteriófagos)
Estructura y morfología de los virus - son de tamaño entre 20-25 nm hasta 200-300 nm; su observación requiere un microscopio electrónico.
- Estructura del genoma => ADN o ARN mono-catenario o bicatenario; la mayoría de virus ARN tienen genomas mono-catenaria excepto los reovirus/rotavirus (bicatenario); los virus ADN suelen ser bicatenario, excepto parvovirus (mono-catenario); los genomas (core o núcleo) pueden ser moleculas lineales o circulares únicas o segmentadas en varios fragmentos.
- Estructura de la cápside => su función es de proteger el genoma del medio extracelular y facilitar la entrada al interior de la célula; están compuestas de subunidades proteicas repetidas (capsómeros) que a su vez están compuestas de moleculas proteicas (protómeros); según la disposición que adopten los capsómeros /la cápside, se clasifican en virus de simetría helicoidal (normalmente son virus ARN), icosaedrica (20 caras triangulares y 12 vértices) y compleja.
- Estructura de la envoltura => los lípidos de la envoltura es lipoprotéica y procede de la membrana célula infectada, pero las proteínas suelen ser virales desplazados a las proteínas celulares originales; en algunos casos, las proteínas incluyen una matriz (proteína M) que contacta/ engancha con la nucleocápside; los virus envueltos tienen estructuras glucoprotéicas (espículas) importantes para los procesos de adsorción y penetración al interior de la célula.
Ciclo vital de los virus - las estrategias de replicación varían dependiendo de la estructura del virus y de su material genómico, pero en general conlleva pasos de => adsorción/ adherirse - penetración - decapsidación - replicación - ensamblaje - liberación.
- Adsorción => la unión de la partícula viral a la superficie de la célula; no requiere energía y no depende de la temperatura; intervienen moleculas proteicas de la superficie del virión (proteínas de unión) y proteínas de la superficie de la membrana de la célula diana (proteínas receptoras); en los virus envueltos, la proteína de adherencia viral son las espículas de la capa externa de la envoltura.
- Penetración => tras ser adherido, se penetra el virión completo o solo el genoma y las polimerasas entran en el citoplasma celular, esto se lleva a cabo por 3 mecanismos: penetración directa, endocitosis o fusión; penetración directa => la membrana solo permite la entrada del genoma viral (ocurre en virus sin envuelta p.ej. fagos); endocitosis => los viriones adsorbidos, quedan rodeados por la membrana citoplasmática de la célula huésped formándose una vesícula endosómica (mecanismo mas utilizados de los virus sin envuelta); fusión => utilizado por los virus envueltos; existen 2 maneras de fusión: en los paramyxovirus, su envuelta se fusiona con la membrana citoplasmática directamente y la nucleocápside se libera al interior del citoplasma; en el resto de virus envueltos, la envoltura viral se fusiona con la membrana celular formándose una vesícula endosómica que posteriormente libera la partícula viral hacia el citoplasma.
- Decapsidación => se degrada la cápside viral para que el genoma viral pueda liberarse e iniciar la transcripción y la traducción; en la mayoría la penetración y la decapsidación se produce a la vez.
- Replicación => es la fase donde se produce la síntesis de todas las macro-moleculas virales; la célula huésped debe proporcionar la energía y los medios suficientes que a veces puede afectar su propio metabolismo celular, pero en otros casos apenas se alteran; es esencial que los ARNm transcriban la información viral y la replicación de la información genética y que posteriormente mediante los componentes celulares se traducen para fabricar proteínas que se necesitan.
a. Replicación de virus ADN bicatenario => tras la adsorción y la penetración, el ADN viral es liberado y penetra en el núcleo + ARN polimerasas celulares => ARNm transcrito y traducido para la síntesis ADN viral; para el proceso de traducción => ARNm emigra al citoplasma celular y es traducido para formar las proteínas de la cápside => que posteriormente son transportadas al núcleo para ensamblar el virión completo que serán liberados por lisis celular; la excepción dará al virus ADN poxvirus (grande y de simetría compleja) que realiza el proceso de transcripción y traducción en el citoplasma celular utilizando su propia ARN polimerasa dependiente del ADN viral, ya que no pueden utilizar ARN de la célula huésped que se localiza en el núcleo.
b. Replicación de virus ADN mono-catenario (fagos, parvovirus) => necesitan un intermediario replicativo para formar ADN bicatenario que puede transcriben el ARNm (ARN polimerasa celular necesita como plantilla una ADN bicatenario); como resumen: ADN mono-catenario + ADN polimerasas de la célula huésped => produce ADN bicatenario + ARN polimerasas celulares => forma ARNm
c. Replicación de virus ARN mono-catenario de polaridad (+) => ARN viral penetrado en el citoplasma de la célula huésped es reconocida de inmediato como ARNm por los ribosomas, los cuales la captan e inician su traducción a proteínas virales y también un enzima RNA polimerasa (transcriptasa); RNA polimerasa producida + ARN viral (se utiliza como molde) => replicación del ARN viral (todo ocurre en el citoplasma independientes del ADN del huésped).
d. Replicación de virus ARN mono-catenario de polaridad (-) => su ARN de polaridad (-) complementa el ARNm que es de polaridad (+); mediante su propio ARN polimerasas sintetizara el ARNm que después le servirá de molde para la síntesis de nuevo ARN de polaridad (-) y también para la traducción de sus proteínas utilizando la maquinaria celular.
e. Un caso especial de Retrovirus => virus ARN mono-catenario de polaridad (+) que poseen un enzima transcriptasa de reversión (transcriptasa inversa / retro-transcriptasa); su genoma ARN + retro-transciptasa => produce ADN de polaridad (-) + (la misma) retrotranscriptasa => origina ADN bicatenario que se integran al ADN celular y permanece alli durante tiempo prolongado; En un momento dado el ADN integrado se reactiva y es transcrito a ARNm vírico por la polimerasa del huésped y entonces, se completa el ciclo replicativo.
- Ensamblaje y liberación => se puede producir tanto en el núcleo como en el citoplasma, tras la replicación del genoma viral y la transcripción de las proteínas virales, los viriones se ensambla y se libera de la célula huésped; consiste en la unión ordenada del acido nucleico y de las proteínas para formar la nucleocápside, dando lugar a un virión viable; la liberación de los virus sin envuelta (desnudos) se produce por lisis celular; en caso de virus envueltos, salen al exterior por gemación de una zona de la membrana nuclear o citoplasmática (depende si son virus ADN o ARN); la zona de la membrana por donde se producirá la gemación, adquiere primero las espículas y las proteína de la matriz (codificadas por el virus), que atrae a la nucleocápside, fusionándose a la membrana, formándose la envuelta y liberándose el virión al exterior; en caso de poxvirus (mas grandes y complejos), estos pueden sintetizar sus propias envueltas; en caso de retrovirus, el virus no se libera de la célula sino que se integra en su genoma y permanecer así largo tiempo o de por vida; el proceso de ensamblaje y liberación es a veces ineficaz, formándose partículas no infectivas.
Taxonomía vírica - los virus se dividen en familias, genero, especie o tipo y según su forma del genoma, tamaño, forma, estructura, sintomatología clínica que producen, tropismo celular, etc; según el tipo de genoma que contienen y su estructura => se clasifica en virus ARN y virus ADN.
Virus ARN
1. De simetría cubica o icosaedrica sin envuelta - mono-catenario de polaridad (+) que utiliza su propio ARN como mensajero (pueden ser inmediatamente traducidos por la célula huésped ya que no se necesita transcribir ARNm) con la excepción de Reoviridae (bicatenarios) que utilizan su propia ARN polimerasa para transcribir ARNm; todos se ensamblan en el citoplasma de la célula huésped y son resistentes al éter.
- Familia Reo-viridae => tamaño intermedio (60-80 nm de diámetro), los únicos bicatenarios; el mas importante para el hombre es el Rotavirus (provoca problemas diarreicos), tiene forma redonda.
- Familia Calici-viridae => son pequeños (35-39 nm), tienen poca importancia en microbiología clínica; el mas importante /patógeno para el hombre es el virus de Norwalk (productor de gastroenteritis) y el virus de Hepatitis E (su inclusión no es definitiva)
- Familia Picorna-viridae => son pequeños (20-30 nm); los géneros mas importantes son los Enterovirus (>70 enterovirus que incluyen el Poliovirus, Echovirus, Cosxackievirus y el virus de la hepatitis A) y los Rhinovirus (>100 rhinovirus).
2. De simetría cubica o icosaedrica con envuelta - mono-catenario de polaridad (+), todos se ensamblan en el citoplasma de la célula huésped y son sensibles al éter.
- Familia Retro-viridae => son grandes +/- 100nm, de elevado Pm, contienen trazas de ADN y poseen transcriptasa inversa (retro-transcriptasa) en su dotación; adquieren su envoltura en la membrana citoplasmática de la célula huésped; se engloban todos los virus ARN tumorales; se divide 3 subfamilias: Oncoviridae (causan tumores y canceres), Spumaviride y Lentiviridae (dentro de esta estaría VIH).
- Familia Toga-viridae => son de 40-70 nm y adquieren su envoltura en la membrana citoplasmática; se incluyen la mayoría de los arbovirus (transmitidos por artrópodos - los arbovirus pertenecen a numerosas familias como Togaviridae, Flaviviridae, Arenaviridae, Reoviridae); se incluyen también los no arbovirus: Alphavirus con virus Sindbis su principal tipo, Pestivirus con el virus de la diarrea mucosa como su principal tipo y Rubivirus con rubeolavirus su principal tipo.
- Familia Flavi-viridae => son de 40-50 nm y adquieren su envoltura en las membranas intra-citoplasmáticas (antes se incluyen dentro de la familia Togaviridae y los han separado por su menor tamaño y por el lugar de su ensamblaje que ocurre en el retículo endo-plasmático); incluyen 2 géneros de importancia clínica: (1) Flavivirus (antes llamados arbovirus del grupo B) que destaca el virus de la fiebre amarilla y del dengue; (2) virus de la Hepatitis C; actualmente se incluye de manera no definitiva al virus de la hepatitis G.
3. De simetría helicoidal - todos son envueltos, mono-catenario de polaridad (-) que utiliza su propia transcriptasa (ARN polimerasa) para transcribir ARNmensajero; se ensamblan en el citoplasma y son sensibles al éter.
- Familia Rhabdo-viridae => de forma bala o bastón; el diámetro del cilindro +/- 70nm con longitud de 175nm; adquieren su envuelta en la membrana citoplasmática; el genero mas importante es virus de la rabia.
- Familia Paramyxo-viridae => de tamaño 150-300nm, son pleomórficos predominando formas esféricas rugosas y filamentosas; adquieren su envuelta en la membrana citoplasmático; se incluyen 3 géneros: Paramyxovirus (virus de la parotiditis/paperas, parainfluenza tipos 1,2,3,4A,4B...), los Morbilivirus (virus del sarampión, entre otros) y los Pneumovirus (virus sincitial respiratorio - causan bronquiolitis en niños pequeños).
- Familia Orthomyxo-viridae => morfológicamente semejante a la familia Paramyxoviridae pero mas pequeños 80-120nm, parecidos también a la familia Rhabdoviridae (los 3 proceden de un ancestro común); adquieren su envoltura en la membrana citoplasmática; se incluyen 2 géneros: los virus de la influenza o de la gripe tipos A, B y C.
- Familia Arena-viridae => de tamaño 50-300nm, adquieren su envoltura de la membrana citoplasmática; algunos producen infecciones virales "lentas"; el mas importante es virus de la fiebre de Lassa (en Africa).
- Familia Bunya-viridae => de tamaño 80-100nm, de forma esférica, adquieren su envoltura en el aparato de Golgi; la mayoría de los géneros son arbovirus.
- Familia Corona-viridae => de tamaño 80-130nm, morfológicamente se parecen a Orthomyxovirus, pero sus proyecciones en la superficie a modo de pétalos o "corona solar"; adquieren su envoltura en las membranas intra-citoplasmáticas; la mayoría de los géneros son virus respiratorios de vías altas.
Virus ADN
a. De simetría cubica o icosaedrica sin envuelta - su genoma es ADN bicatenario con excepción de Parvo-viridae (mono-catenario); todos se ensamblan en el núcleo y son resistentes al éter
- Familia Adeno-viridae => de tamaño mediano 70-90nm; se conocen 34 tipos que afectan al hombre y mucho de ellos afectan el tracto respiratorio.
- Familia Parvo-viridae => de tamaño muy pequeño 18-26nm con genoma ADN mono-catenario; la mayoría no tienen importancia clínica, excepto parvovirus B19, pertenece al genero Parvovirus que causa eritema infeccioso.
- Familia Papova-viridae => son de tamaño pequeños 45-55nm con ADN de tira circular; el genero mas importante es el Papilomavirus o virus de las verrugas con 66 tipos de papilomavirus humanos (PVH); los Papovavirus en general producen enfermedades latentes y crónicas y algunos son oncogénicos.
b. De simetría cubica o icosaedrica con envuelta - son bicatenarios y todos se ensamblan en el núcleo con excepción de Irido-viridae que se ensamblan en el citoplasma.
- Familia Herpes-viridae => de tamaño medio +/-100nm, adquieren su envoltura en la membrana nuclear y son sensibles al eter; de los 80 virus que existen, solo 8 tienen interés clínico para el hombre y se divide en 3 subfamilias: (1) Alphaherpesviridae con géneros importantes el virus Herpes simples tipo 1 y 2 y el virus Varicella-zoster; (2) Betaherpesviridae con géneros Citomegalovirus al citomegalovirus humano (Herpesvirus humano tipo 5) y al Herpesvirus humano tipo6, y al genero Roseolovirus con el herpesvirus humano tipo 7; (3) Gammaherpesvirus que incluyen virus de Epstein-Barr (herpesvirus humano tipo 4) que provoca enfermedad de Beso, pertenece al genero Limphocriptovirus.
- Familia Hepadna-viridae => de tamaño 40-50nm, adquieren su envoltura en el citoplasma, son resistentes al éter y poseen un genoma ADN parcialmente bicatenario; el mas importante es el virus de la hepatitis B.
- Familia Irido-viridae => de tamaño grande 130-300nm, sensibles al éter, adquieren su envoltura en la membrana citoplasmática y también se ensamblan en el citoplasma (a diferencia de otros); no tienen importancia clínica para el hombre, pero si en veterinaria como el virus de la fiebre porcina africana.
c. De simetría compleja
- Familia Pox-viridae => son virus animales mas grandes 230x400nm de forma ladrillo o ovoide; se caracteriza como la única familia de virus ADN que se replica y ensambla en el citoplasma, pues contienen una RNA polimerasa ADN dependiente (no necesita la maquina nuclear), de hecho su replicación es posible en celulas a-nucleadas (sin núcleo); son resistentes al éter y poseen una doble envuelta (una la adquieren en el aparato Golgi y la otra en la membrana citoplasmática; los mas importante son virus de la viruela, virus de la vacuna o vaccinia y virus del molluscum contagiosum.
Principales familias de virus de interés clínico
1. Virus ARN (mono-catenario)
1.1. Familia Reo-viridae (tamaño mediano 60-80nm - icosaedrico - sin envuelta - se ensamblan en el citoplasma) - contiene 6 géneros, únicamente cabe destacar Rotavirus)
Rotavirus (forma de rueda - el único bicatenario) => descubiertos en 1973 en niños con gastroenteritis; el único con importancia clínica (agente causal de gastroenteritis esporádica y epidémica en lactantes y niños; la infección suele ser asintomática en neonatos; afecta principalmente a niños entre 6-24 meses; la prevalencia máxima en invierno y raramente en verano; periodo de incubación 1-3 días, precediendo los vómitos a la diarrea que suele mantenerse de 4-5 días; el virus se detecta en heces (dura bastante horas fuera del huésped)
1.2. Familia Calici-viridae (pequeños 35-40 nm - icosaedrica - sin envuelta - de polaridad+) - se ensamblan en el citoplasma) => tiene poca importancia en clínica, posibles agentes causales de gastroenteritis en cualquier día del año y a cualquier edad; es el agente Norwalk (virus que causan gastroenteritis en EEUU) que ahora esta dentro de Parvovirus - Parvoviridae; se incluye de forma no definitiva el virus de Hepatitis E.
1.3. Familia Picorna-viridae (virus muy pequeños 20-30nm - icosaedrica - sin envuelta - de polaridad+) - es una familia importante y una de las que mayor numero de virus presenta, destacando 2 géneros Enterovirus y Rhinovirus.
Enterovirus - se asocian con distintos síndromes clínicos como parálisis, meningitis aséptica, encefalitis, miocarditis, pericarditis, pleurodinia, herpangina, infecciones agudas del tracto respiratorio y fiebre aftosa; son habitantes transitorios del tracto digestivo humano; existen >70 sero-tipos, siendo el tipo 72 es el virus de la Hepatitis A; todos se diseminan por vía fecal-oral y la mayoría son asintomáticas; los mas importantes son Poliovirus, Echovirus y Coxsackievirus;
- Los virus de poliomielitis /Poliovirus son tres (tipos 1,2 y 3), mas temidos normalmente por la parálisis flácida (de cintura para-bajo) y deformidades aunque son complicación infrecuente; la vacuna es de Sabin (virus atenuados), también Salk (virus inactivados); la vacuna de poliomielitis se administra a los niños de 2-4-6-18 meses.
- Los virus Echo y Coxsackie tienen distintas manifestaciones (muy ubicuo/ de todo tipo).
Para el diagnostico debe recurrirse al cultivo; el aislamiento de un enterovirus de heces o de faringe no indica necesariamente una relacion causal con el cuadro clínico, y deben descartarse otras causas; por el contrario si se trata de LCR.
Rhinovirus - agentes etiológicos mas frecuentes del resfriado común (rinitis agudas); existen >100 tipos
1.4. Familia Toga-viridae y Familia Flavi-viridae (toga=envuelta - icosaedrica - de polaridad+ - se ensamblan en el citoplasma); ambos son de forma icosaedrico, virus de RNA mono-catenario con envuelta; se incluyen la mayoría de los arbovirus; los v.Togaviridae (pequeño 40-70 nm, adquiere su envuelto en la membrana citoplasmática de la célula mientras los v.Flaviviridae (40-50 nm, lo adquieren de retículo endo-plasmático; dentro de Togaviridae están los arbovirus y los géneros no arbovirus como Alphavirus (sindbis), Pestivirus y Rubivirus (rubeola) dentro de Flaviviridae esta el virus Hepatitis C y otros que producen enfermedades como fiebre amarilla, dengue, de genero flavivirus que pertenecen a los arbovirus tipo B (transmitidos por artrópodos).
Virus de la Rubeola del genero Rubivirus (no es un arbovirus) - descrito hace >200 años; consta la importancia como agente causal de malformaciones congénitas desde la epidemia de 1940 en Australia (un oftalmólogo australiano constato un elevado numero de cataratas congénitas y ceguera asociados a esta enfermedad); la infección suele ser benigna y auto-limitada; sintomas => procesos respiratorios superiores leves, erupción eritematosa y linfadenopatía sub-occipital y retro-auriculares; en adultos se puede complicar con artritis transitoria o artralgias; rara vez produce encefalitis o purpura trombocitopénica; muy importante la infección en gestantes por posibles aparición de sordera neuro-sensitiva, alteraciones cardíacas, cataratas, retraso del crecimiento y sintomas encefalíticos; la incubación dura 14-21 días; diagnostico por método serológico (técnica de ELISA) para detectar IgG y sobre todo IgM en las embarazadas y un resultado positivo indica inmunización frente al virus; actualmente es poco frecuente debido a la vacuna obligatoria que se incluye en la triple vírica (paperas, sarampión y rubeola) que se pone a los niños de15 meses (suele dar inmunidad permanente) y una dosis de recuerdo a los 6 años (solo las niñas); a los 11 años solo se dan vacuna de varicela.
Clínica de Rubeola => empieza con eritema en la cara y se extiende hacia abajo (es un eritema maculo papuloso); es menos llamativo que de la sarampión; dura +/- 3 días y puede haber enantema palatino.
1.5. Familia Retro-viridae (de tamaño grande +/- 100nm - icosaedrica - con envuelta - de polaridad+ - se ensamblan en el citoplasma) => poseen enzima transcriptasa inversa / retro-transcriptasa; a esta familia pertenece el virus de la inmuno-deficiencia humana VIH que se estudia aparte.
1.6. Familia Orthomyxo-viridae (de tamaño 80-120nm - helicoidal - envuelta - de polaridad (-) y se ensamblan en el citoplasma) - en1918 tras la Guerra Mundial, mato mas personas que la propia guerra; esta compuesta por los distintos tipos de virus influenza/ Gripe (tipo A, B y C).
Virus Influenza /la gripe española (empezó en España) - causan gripe, infección respiratoria aguda epidémica normalmente durante mes de noviembre-abril; la vía de transmisión es aérea, periodo de incubación 1-4 días, seguido de clínicas tipo respiratorias superior, mas grave en los ancianos; se realizan campañas de vacunación todos los años (sobre todo a los ancianos y pacientes bronco-pulmonares), ya que presentan gran variabilidad antigénica segun el serotipo que causa la epidemia (tiene gran poder mutagénico); existe 3 tipos => A, B y C (A y B causan epidemias de importancia); los influenza A se subdividen según la diferente composicion antigénica (en la envoltura) de la hemaglutinina y la neuraminidasa; el diagnostico es clínico; recientemente se introduce metodos de diagnostico de muestras clínicas de antígenos virales; el de mayor importancia clínica es virus respiratorio sincitial (VRS); para el diagnostico rápido se usa la inmuno-fluerescencia directa en aspirados naso-faringeos, esputos o biopsia de pulmón; existe un kit con Ags virales para detectarlos.
1.7. Familia Paramyxo-viridae (de tamaño grande 150-300nm - helicoidal - envuelta - de polaridad (-) y se ensamblan en el citoplasma) => morfológicamente parecida al de anterior/ Orthomyxoviridae; todos ellos son causas importantes de enfermedad respiratoria en los niños; se incluyen 3 géneros Paramyxovirus (virus de la parotiditis/paperas y parainfluenza), Morbilivirus (virus del sarampión), Pneumovirus (virus sincitial respiratorio)
Virus Parainfluenzae (VPI) del genero Paramyxovirus - los 5 tipos de VPI producen infecciones del tracto respiratorio, siendo el 1 y el 2 los principales causantes de laringo-traqueobronquitis, el 3 de bronquiolitis y neumónia en niños (segundo agente después del VRS), el 4 y el 5 causan infecciones mas suaves; el diagnostico es clínico.
Virus respiratorio sincitial (VRS) del genero Pneumovirus - es la causa mas importante de neumónia y bronquiolitis en niños y recién nacidos; produce un amplio espectro de infecciones, siendo la mas frecuente es el resfriado común con abundante rinorrea; VRS es muy contagioso y se manifiesta en forma de brotes invernales; la inmunidad no es completa por lo que se dan las re-infecciones (mas suaves); Es importante que la excreción de virus se mantenga durante 2 o 3 semanas (mas tiempo para los inmunodeprimidos), por lo que al ingresar un niño en el hospital durante 1 o 2 semanas, puede ser contagioso todavía (es el agente mas frecuente de infección nosocomial en pediatría); las infecciones graves se trata con la ribavirina (inhibe la síntesis del ARN viral); el diagnostico rápido es la inmunofluorescencia en secreciones respiratorias.
Virus del Sarampión - causa una enfermedad aguda, febril, exantemática, de gravedad variable que afecta a niños de 5-9 años, se contagia por vía respiratoria y conjuntival; sintomas clínico => los primeros días como un catarro naso-oculo-faringo-laringeo, luego aparece fiebre, cara rubicunda, congestión de mucosa y a los 3-4 días aparece "manchas Koplik" (manchas blanquecinas diminutas delante del 1º y 2º molar) dura un par de días; empieza aparecer exantema, primero retro-auricularmente, despues se extiende a todo el cuerpo, las palmas y las plantas de los pies mas tenue en zonas distales, sube a la fiebre y el exantema tenue se hace muy eritematoso; tras 2-3 días mejora bruscamente y desapareciendo los signos en el orden del aparecimiento (dará inmunidad permanente); el diagnostico es por metodos serológicos.
Virus de la parotiditis - es una enfermedad endémica con incidencia todo el año; es rara en niños < 1 año, gracias a la inmunidad de la madre; afecta a niños de 5-14 años, se transmite por vía aérea y por objetos introducidos a la boca (dará inmunidad permanente); clínica => tras 24horas de clínica inespecifica, aparecerán dolor y tumefacción de retro-parotidia y oído, aumento de fiebre, puede haber afectación de nervio facial leve y bilateral; complicación => meningitis, orquitis, pancreatitis o artritis; diagnostico es por vía serológico; el diagnostico es por metodos serológicos.
1.8. Familia Rhabdo-viridae (de tamaño grande en forma de bastón, diámetro 70nm y longitud 175nm - helicoidal - con envuelta - de polaridad (-) y se ensamblan en el citoplasma) => característica típica de su morfología es forma de "bala"; el mas importante es el causante de la rabia o hidrofobia (se atraganta con el agua).
Virus de la rabia - causa enfermedad infecciosa aguda del SNC, de gran importancia histórica por los trabajos de Pasteur; existe la obligación de vacunar todos los años a perros y gatos, ya que es una zoonosis en la que el hombre es un eslabón irrelevante; existen 2 formas epidemiológicas => urbana (lo adquieren perros y gatos no inmunizados) y salvática (los zorros); normalmente el virus esta presente en la saliva de animales rabiosos, transmitiéndose por mordeduras (son fuentes de infección humana); el diagnostico solía realizarse postmortem, mediante la observación de los cuerpos de Negri (cerebro); también se pueden cultivar en laboratorio; clínica de animales => cambian de carácter, se vuelven caprichosos, pierden apetito, ingerir objetos no engullibles autllan con ronca, irritabilidad creciente y muerden a personas y animales; mueren en 2 semanas; clínica de humanos => la incubación 1-3 meses depende del lugar de la mordedura; el virus se propaga por los nervios a una velocidad 1mm/hora; comienza con la alteración del sueño, dolor de la mordedura, también parestesias/ hormigueos de la zona, trastornos respiratorios (en la voz), posteriormente aparece espasmos faríngeos tras la ingestión de líquidos o solo de verlo (hidrofobia), salivación espumosa y espasmos en las extremidades (basta con pequeños estímulos de luz o ruidos, para provocar lo); las personas suelen morir por parálisis en pocas horas tras la afectación de bulbo-raquídeo; el cuadro normal es de 3-6 días, después mueren.
1.9. Familia Corona-viridae (de tamaño 80-130nm - helicoidal - envuelta - de polaridad (-) y se ensamblan en el citoplasma) => adquieren su envoltura (con proyecciones a modo de pétalos/ corona solar) en las membranas intra-citoplasmáticas; escasa importancia en patología, únicamente causan el resfriado común y pueden estar involucrados en cuadros de gastroenteritis.
2. VIRUS ADN (bicatenario)
2.1. Familia Parvo-ridae (de tamaño muy pequeño 18-26nm - icosaedrico - sin envuelta - se ensamblan en el núcleo - resistentes al eter) => son de tamaño muy pequeño y son los únicos que presentan ADN de una sola hebra (mono-catenario); algunos tienen importancia en veterinaria y solo destaca uno como patógeno humano (Parvovirus B19).
Parvovirus B19 (estaban incluidos en virus Norwalk) - fue vinculado al eritema infeccioso en 1983; es benigna y afecta niños en edad escolar; presentan una erupción eritematosa en las mejillas (cara enbofetada) y un exantema en extremidades y tronco (respeta a las palmas, las plantas y los labios); los adultos son propensos a artropatía asociada, que se resuelve en 2-4 semanas; diagnostico por método serológico y metodos de ELISA.
2.2. Familia Papova-viridae (de tamaño pequeño 45-55nm - ADN de tira circular - icosaedrico - sin envuelta - se ensamblan en el núcleo - resistente al éter) => son unos viruses oncogénicos (efecto cancerígeno), producen enfermedades latentes y crónicas, causantes verrugas genitales o condilomas (se asocian a carcinoma de cérvix) y papilomas (Papilomavirus/ virus Papiloma humano); el diagnostico es de tipo clínico y serológico; prevención => se vacunan a las niñas de < 14 años.
2.3. Familia Adeno-viridae (de tamaño mediano 70-90nm - icosaedrico - sin envuelta - se ensamblan en el núcleo - resistente al éter) => producen principalmente patología al tracto respiratorio, ocular y gastroenteritis; las infecciones respiratorias solo son significativas en niños <6 años; el diagnostico se realiza mediante clínicas y técnicas serologícas.
2.4. Familia Hepadna-viridae (de tamaño pequeño 40-50nm - ADN parcialmente bicatenario - icosaedrico - envueltos - se ensamblan en el núcleo - resistentes al éter) => su envuelta se adquiere en la membrana citoplasmática y se ensamblan en el núcleo; en esta familia se encuentra virus hepatitis B que se estudiara a parte.
2.5. Familia Herpes-viridae (de tamaño medio +/-100nm - icosaedrico - envueltos - se ensamblan en el núcleo - sensibles al éter) => adquiere su envuelta de la membrana nuclear y se ensamblan en el núcleo; destaca 3 subfamilias => Alphaherpesviridae (VHS 1y2, virus Varicella-Zooster), Betaherpesviridae (CMV y Roseolovirus), Gammaherpesvirus (VEB/Limphocriptovirus); todos los virus producen infecciones latentes, capaces de reactivarse.
Virus Herpes Simple (VHS) - producen infecciones latentes que se reactivan con o sin lesiones que sirven de fuente de infección para individuos susceptibles (los virus de Herpes no se cura, solo se acantona y se puede reactivar); existen 2 tipos => VHS-1 (tropismo por lesiones por encima de la cintura y suele ser leve) y VHS-2 (se encuentra principalmente en los genitales, transmitiéndose por vía venérea); cada individuo tiene un tropismo estable; suele ser bucal, comienza con hormigueo y luego aparecen vesículas, costra y desaparece en +/- 1 semana; VHS-1 se transmite por secreción oral, infección a nivel peri-oral, también otras zonas como los ojos; VHS-2 normalmente daran infección genital y se contrae por vía sexual; en EEUU en ciertas capas sociales, es la enfermedad venérea mas frecuente; en mujer gestante se puede transmitir al bebe vía placenta o canal de parto o en los primeros días de vida; en general estos virus tienen capacidad oncogénicos como VEB (virus Epstein-Barr), puede producir cáncer cervical; el diagnostico se realiza mediante la tinción de Giemsa de celulas raspadas de lesiones herpéticas, para observar las características de las celulas gigantes multi-nucleadas; también se cultivan en SHELL-VIAL.
Citomegalovirus (CMV) - producen infección asintomática, pero con gran importancia en huéspedes inmuno-comprometidos; las infecciones se pueden clasificar en congénitas, peri-natales o pos-natales (antes o después del parto); es la causa mas frecuente de infección congénita; el CMV se ha detectado en saliva, orina, leche materna, semen, por lo que su transmisión es variada; también se transmite por transfusiones o trasplantes; en pacientes inmuno-competentes, normalmente son asintomática, si da clínica va a ser semejante a mononucleosis infecciosa (virus Epstein-Barr), como fiebre, adenopatias, hepatomegalia; en paciente inmunodeprimidos es diferente, en general dará fiebre, neumonitis, colitis, esofagitis, hepatitis, infección congénita y perinatal, puede dar retraso mental, ictericia y sordera; el diagnostico => por serología buscando Acs anti CMV (metodos ELISA), cultivo en SHELL-VIAL (artificial) ya que no se pueden cultivar en celulas vivas.
Virus Varicela-Zóster (VVZ) - la varicela y el herpes zóster representan diferentes manifestaciones clínicas de un mismo virus; la varicela es mas frecuente en niños y se caracteriza por fiebre y exantema vesicular generalizado; es una infección primaria mientras su re-activación producirá el herpes zóster, aparece normalmente en adultos (cuando hay una disminución de la inmunidad) que consiste en una erupción dolorosa circunscrita de lesiones vesiculares, acompañada de inflamación de las raíces dorsales de los nervios raquídeos o de los ganglios sensitivos craneales; los estadios son => macula - pápula - vesícula - umbilicación - costra; característicamente existe estados evolutivos todos mezclado a la vez y prurito sobre todo en el tronco y cara (menos en las extremidades); el diagnostico sera tipo clínico y también por los distintos metodos en laboratorio => examen directo previa tinción Giemsa por microscopio electrónica, por serología (ELISA) y por cultivo celular.
Virus de Epstein-Barr (VEB) - es uno de los virus humanos mas ubicuos, linfotrópico y oncogénico; la infección primaria suele pasar en la infancia, aumentando su sero-prevalencia 60-70% en jóvenes y 80-90% en adultos; el síndrome clínico mas frecuente es la mononucleosis infecciosa (enfermedad de beso) que presenta fiebre, adenopatias, faringitis y linfocitosis con linfocitos atípicos; VEB también se ha asociado a carcinoma naso-faríngeo y al linfoma de Burkitt; diagnostico => la prueba de Paul Bunnell es la detección de Acs heterofilos y también por método de ELISA.
Herpesvirus Humano 6 (HHV-6) - es un virus de muy reciente aparición, se ha aislado en síndromes linfo-proliferativos y se ha vinculado al exantema súbito (elevación brusca de la temperatura hasta 40ºC de 2-4 días, seguida de un descenso rápido que coincide con la aparición de un exantema maculo-papular que persiste 1-2 días; el diagnostico sera clínico y serológico.
Herpesvirus Humano 7 - se descubrió en 1989 (reciente); tiene tropismo por los linfocitos T, provocando exantema súbito; se investiga si tiene relacion con síndrome de fatiga crónica (que lo padecen sobre todo mujeres mayores).
2.6. Familia Pox-viridae (ADN bicatenario - doble membrana) - son de tamaño grande 230-400nm, con forma de ladrillo, se replica en citoplasma y se ensamblan en el citoplasma; el mas importante es el virus de la viruela, virus de Moluscum Contagiosum y virus de la Vaccinia;
- Viruela se contagia por inhalación y tras 15 días aparece fiebre, mialgias y erupción pápula vesicular dura y luego evoluciona a pústulas y a la curación; a veces puede provocar muerte por exantema hemorragica o una sobre infección bacteriana.
- Virus de la Vaccinia es muy próximo al virus de la viruela; en individuos inmunodeprimidos puede provocar complicaciones, pero en los inmuno-competentes es auto-limitado; es importante en los principios de la vacunación (Jennen); últimamente se investiga su utilización como vector para actuar como vacuna contra virus de Hepatitis B, Herpes simple y VIH, ya que su genoma es susceptible de poder insertarle secuencias de genes que codifiquen proteínas de otros virus y que se expresarían posteriormente cuando el virus se replique, con lo cual tendríamos Acs contra estos virus.
- Virus de Moluscum Contagiosum - provoca enfermedad cutánea benigna, contagiosa que pueda adquirir por compartir objetos o contacto sexual; aparece en epidermis lesiones nodulares blancas de aspecto nacarado de 2-10 mm que son indoloras; cualquier traumatismo provoca su contagio; desaparece entre 2 meses y 1 año.
Esquema de Virus Respiratorio
HEPATITIS VIRAL - es una enfermedad sistémica que afecta fundamentalmente el Hígado; se conocen 7 virus de la hepatitis, denominados A,B,C,D,E,F y G que pertenecen cada uno a familias y géneros distintos, pero que tienen todos un tropismo hepático (no tienen relación taxonómica); existen además otros virus que producen hepatitis, como Citomegalo virus y el virus de Epstein-Barr; se pueden clasificar según la principal vía de transmisión y la tendencia a la cronicidad en 2 grandes grupos (1) transmisión fecal-oral y no cronifican: VHA, VHE y VHF (2) transmisión parenteral y pueden cronificar: VHB, VHC, VHD y VHG.
[c] Agar Campylosel => crecerá Campylobacter spp (bacilos Gram- con flagelos) como colonias pequeñas translucidas, sensibles a Nalidixico (especies C. coli y C.jejuni) resistente a Nalidixico el C. fetus, en fresco aparecen en coma/en S, ureasa (+) oxidasa (+) catalasa (+); al hacer la prueba del hipurato C.jejuni seran (+) y C.coli (-); P. hipurato => un procedimiento cualitativo para determinar la capacidad de las bacterias de hidrolizar enzimáticamente (hipuricasa) el hipurato sódico que da lugar a acido benzoico y glicina un compuesto de color morado.
[d] Caldo Selenito => caldo enriquecido para los géneros Salmonella y Shigella. el selenito de sodio inhibe la flora Gram+ y la mayoría de la flora entérica excepto Salmonella spp.
[e] Agar McConkey (solo en algunos protocolos) => los coliformes aparecerán como colonias rojas por ser lactosas (+); no es necesario???
[f] Agar TCBS /tiosulfato citrato bilis sacarosa (detectar Vibrio cholerae) => aparecen colonias de color amarillo sacarosa (+), oxidasa (+) y son bacilos Gram- pleomórficos; el extracto de levadura y la peptona proporcionan el nitrógeno y las vitaminas. El citrato sódico, el tiosulfato sódico, la bilis de buey y un pH alcalino fuerte inhiben los organismos Gram+ y suprimir los coliformes (inhibidor para la mayoría de las entero-bacterias), favoreciendo el crecimiento de Vibrio cholerae porque este organismo es sensible a los entornos ácidos. La alta concentración de sodio favorece el crecimiento de Vibrio cholerae que es halotolerante (tolera el medio salado) y de otras especies de Vibrio, cuya mayoría es halofílica. La sacarosa (+) es un carbohidrato fermentable, y el cloruro sódico estimula el crecimiento. El tiosulfato sódico es una fuente de azufre y actúa con el citrato férrico como indicador para detectar la producción de ácido sulfhídrico/SH2. El azul de bromotimol y el azul de timol son indicadores de pH. En Mc, Vibrio Cholerae es lactosa (-).
3. Exudados vaginal y uretral (la muestra llegara en uno o varios escobillones; se siembra por agotamiento en cuadrantes).
[a] Agar Sangre (medio general) => buscamos Streptococcus B hemoliticos del grupo B (S.agalactiae), que aparecerán como colonias pequeñas translucidas con un halo de B hemólisis alrededor de la colonia; son cocos Gram+, catalasa y oxidasa (-), anaerobio facultativo, prueba de látex (+).
[b] Agar chocolate => buscamos Haemophilus spp como colonias muy pequeñas grisáceas que crecen bien por ser gérmenes exigentes en su crecimiento que requieren factor X y/o V (proceden de la degradación de la Hb); también podemos colocar discos de factor X y/o V y mirar el satelitismo; al fresco como coco-bacilos inmóviles, Gram-; oxidasa y catalasa variable.
[c] Agar Thayer Martin o New York => buscamos N.gonorrhoeae o N.meningitis que aparecerán como colonias de color gris; son diplococos Gram-, catalasa (+), oxidasa (+) que fermentan la glucosa pero no el resto de los azucares.
[d] Agar Gardnerella => buscamos Gardnerella vaginalis, como colonias B-hemolíticas y al fresco como bacilo pequeño, Gram variable, anaerobio facultativo, oxidasa (-) y catalasa (-). La presencia de sangre humana favorece el crecimiento de las especies estudiadas, ya que producen ß-hemólisis alrededor de las colonias. La ß-hemólisis en agar con sangre humana es altamente indicativa de presencia de G.vaginalis. Los antibióticos incluidos en el medio inhiben la mayoría de los contaminantes Gram- y de las levaduras.
[e] Vagicult o Roiron (medio liquido) => crecen levaduras (Candidas spp) y Trichomonas (protozoo unicelular flagelado).
[f] Agar Sabouraud (se puede incluir para detectar Candidas spp)
[g] Medio de detección de Micoplasmas y Chlamydias
4. Semen - la muestra llegara en contenedor estéril/ bote de orina; se siembra por agotamiento en cuadrante en medios: Cled, McConkey , Agar Sangre, Agar chocolate, Thayer Martin o New York, Roiron, y cultivo de Clamydias, buscando en cada caso los mismos gérmenes que en el caso del exudado vaginal.
5. Esputo - la muestra ha de llegar en contenedor esteril y conservarse menos de 24H a 4ºC; antes de sembrar se observa por el microscopio si la muestra es valida/ no esta contaminada por saliva; se siembra por agotamiento en cuadrantes; solo se siembra cuando en el Gram, el cociente leucocitos/ celulas epiteliales sea > 2,5 (recuento en fresco/al microscopio); si es < a 1,5 es dudoso. Cuando sean muestras de UCI o provenientes de neumonías se siembran siempre.
[a] Agar Sangre => buscamos colonias de Streptococcus pneumoniae o Branhamella catharralis; S.pneumoniae >> colonias verdosas (alfa hemólisis) y al fresco como coco Gram+, catalasa (-), sensible a la Optoquina; Branhamella catarralis >> colonias blanco-grisáceas y al fresco como cocos Gram-, oxidasa (+), catalasa (+) que no utiliza ningún azucar (no es fermentadora), pero reduce los nitratos a nitritos/ nitratasa+ (lo que le diferencia del genero Neisseria que ademas es fermentadora de glucosa y maltosa).
[b] Agar chocolate => buscamos Haemophilus spp como colonias puntiformes translucidas, que al fresco como coco-bacilos, Gram-, catalasa y oxidasa variable; agar chocolate polyvitex (contiene factor V/ NAD y factor X /hemina procedente de la degradación de Hb)
[c] Agar McConkey => donde creceran Enterobacterias y otros bacilos Gram-.
[d] Medio de Lowestein-Jensen (o Coletsos) => para rescatar Mycobacterium tuberculosis, bacilos acido alcohol resistente (Zhiel Neelsen+) de crecimiento muy lento; los niveles bajos de la penicilina y el ácido nalidíxico también están presentes en el medio de LJ para inhibir el crecimiento de lo Gram+ y Gram-, con el fin de limitar el crecimiento de especies de micobacterias solamente. Presencia de verde malaquita en el medio inhibe las floras mayoría acompañante; que se desinfecta y se solidifica mediante un proceso de espesamiento; el Glicerol mejora el crecimiento de Mycobacterium tuberculosis.
[e] Medio Legionella => muestras de UCI; la Legionella pneumophila es bacilo Gram- (en realidad, se tiñe muy mal, aerobio exigente, movil; en general, no fermenta ni oxida los azucares, sino que utiliza los aminoacidos; es hipurato+ => un procedimiento cualitativo para determinar la capacidad de las bacterias de hidrolizar enzimáticamente (hipuricasa) el hipurato sódico; necesita L-cisteina para crecer y también iones férricos Fe. La inhibición del crecimiento de las bacterias Gram+, la mayoría de las bacterias Gram-, levaduras y mohos, a través de una combinación optimizada de 3 antibióticos. Las colonias que crecen en medio Agar Legionella y no crecen en medio AS deben considerarse, con alta probabilidad, colonias de Legionella.
6. Cepillado bronquial (la muestra vendrá en el cepillo y se conservara a 4ºC < de 24H); se siembra en los mismos medios que en el caso anterior (esputo) añadiendo ademas: agar sangre anaerobios (ASA) o medio AKV (agar sangre kanamicina-vancomicina), selectivo para bacilos Gram- anaerobios y Bacteroides (bacilo Gram-, anaerobio estricto).
7. Exudado faringeo y oral (la muestra viene en torunda, se sembrara por agotamiento en cuadrante).
[a] Agar sangre => crecera todo tipo de gérmenes (medio general enriquecido)
[b] Agar chocolate => crecera todo tipo de gérmenes
[c] Agar Mac Conkey => creceran las Enterobacterias y otros bacilos Gram- poco exigentes.
[d] Agar CNA /agar sangre (de cordero) colistina nalidixico, medio selectivo para Gram+/ inhibe los Gram- => para deteccion de Streptococcus B-hemoliticos, Enterococcus y Staphylococcus??
[e] Agar Sabouraud (solo en orales) => deteccion de Candidas spp.
8. Exudados varios - abscesos heridas ... (se sembrara por agotamiento en cuadrantes. La muestra ha de llegar en tubo estéril y se conservara a 4ºC menos de 24H.
[a] Agar sangre => crecerá todo tipo de gérmenes
[b] Agar chocolate => idem
[c] Agar Mac Conkey => crecerán las Entero-bacterias y otros bacilos Gram (-) poco exigentes.
[d] Agar CNA /agar sangre (de cordero) colistina nalidixico, medio selectivo para Gram+/ inhibidor Gram- => crecerán bien los Steptococcus B-hemolíticos.
[e] Agar ANA (agar sangre anaerobios/ASA, aunque también puede utilizarse agar AKV, agar sangre kanamicina y vancomicina) => medios selectivos para bacilos Gram- anaerobios (estrictos) y Bacteroides.
[f] Caldo Tioglicolato => crecen bien todo tipo de bacterias aerobias o anaerobias; permite el desarrollo de una amplia variedad de microorganismos, incluidos los nutricional-mente exigentes. Además, se observa que las bacterias estrictamente aerobias, crecen en la parte superior, mientras que las anaerobias facultativas o anaerobias estrictas crecen en las profundidades del medio.
RELACION DE LAS BACTERIAS CON EL OXIGENO EN TIOGLICOLATO En base a la relación de las bacterias con el oxígeno, estas se pueden clasificar en :
1. Aerobio estricto: Un organismo el cual requiere utilizar el oxígeno como aceptador terminal de electrones , puede tolerar un nivel del oxígeno equivalente o mayor de una atmósfera de aire (oxígeno del 21%), y tiene un tipo terminantemente respiratorio de metabolismo (Mycobacterium tuberculosis, Bacillus).
2. Anaerobio o Aerobio facultativo: Un organismo que puede crecer bien en ausencia del oxígeno y en la presencia de un nivel de oxígeno equivalente a una atmósfera del aire (oxígeno de 21%) => Enterobacterias, Vibrio spp, Haemophilus spp..
3. Microaerofílico (anaerobio aerotolerante): Un organismo que es capaz de un crecimiento oxígeno-dependiente, pero no puede crecer en la presencia de un nivel del oxígeno equivalente a una atmósfera de aire (oxígeno de <21%) => Campylobacter fetus, Pseudomonas y Neisseria.
4. Anaerobio estricto: Un organismo que es incapaz de crecimiento oxígeno-dependiente y no puede crecer en la presencia de una concentración de oxígeno equivalente a una atmósfera de aire (oxígeno de 21% - nada de O2). (Clostridium botulinum).
5. Anaerobios aero-tolerantes: Pueden crecer con o sin oxígeno pero su metabolismo es siempre fermentativo (Lactobacillus)
9. Liquido cefalorraquídeo - se siembra por agotamiento en cuadrante del sedimento del tubo centrifugado a 1500 rpm a 3000 rpm durante 20 minutos, si en el tubo hay mas de 1 ml de muestra. Sino, vortear el tubo. La muestra se ha de procesar de inmediato y si no es posible, conservarse a 37ºC.
[a] Agar sangre => buscamos Neisseria meningitidis, como pequeñas colonias no hemolíticas y al fresco se ve como diplococos, Gram-, oxidasa (+), catalasa (+), fermentador de glucosa y maltosa (la fermentación de este azucar le diferencia del gonococo; también puede crecer Streptococcus pneumoniae (neumococo) que aparecen como colonias verdosas (Alfa hemolisis) y al fresco como cocos Gram+, catalasa (-), sensible a la optoquina.
[b] Agar chocolate => ídem y ademas pueden crecer Haemophilus spp como colonias puntiformes translucidas, que al fresco aparecerá, como coco-bacilos, Gram-, catalasa y oxidasa variable.
[c] Agar Thayer-Martin => medio selectivo para Neisserias, crecerán bien los meningococos /N.meningitidis.
[d] Medio tioglicolato (caldo) => medios para anaerobios y aerobios.
(f) Ademas se hará una extensión para Gram.
10. Otros líquidos estériles (sinovial, pleural, pericardio...) - se siembran por agotamiento; la muestra ha de llegar en tubo estéril y su conservación no se ha de demorar mas de 24H a 4ºC.
[a] Agar sangre => crecerán casi todo tipo de microorganismos, con características hemolíticas de algunos de ellos.
[b] Agar chocolate => crecerán casi todo tipo de gérmenes, sobre todo exigentes.
[c] Agar McConkey => crecerán Enterobacterias y otros bacilos Gram- poco exigentes.
[d] Agar CNA => agar columbia colistina nalidixico (sangre de cordero), selectivo para Gram (+)
[e] Agar ASA => agar sangre anaerobios selectivo para bacilos Gram- anaerobios y Bacteroides.
11. Cateteres y sondas - se siembra mediante la técnica de Maki (rodamiento del cateter)
[a] Agar chocolate => crecerán casi todo tipo de gérmenes, y podrán crecer bien algunos exigentes como el Haemophillus.
[b] Agar sangre => crecerán bien casi todo tipo de gérmenes y podrá verse sus características hemolíticas si las tuvieran.
[c] Caldo tioglicolato => si se observa crecimiento se hará un pase por Agar chocolate.
[d] También puede ponerse en una placa de agar MacConkey.
12. Hemocultivos - la muestra se introduce en el vial de hemocultivos, conservando a 37ºC en el Bactec (detecta CO2) hasta su identificación.
Tema 6 - Medios de Cultivo en bacteriología clínica (Clasificación y Preparación)
Medios de cultivo - compuesto por distintos nutrientes requeridos para cultivar gérmenes como las bacterias, hongos y parásitos según sus necesidades nutricionales de cada uno; en función de sus requerimientos, existen grandes diferencias entre los medios de cultivo que nos sirven para diferenciar cada tipo de microorganismo que podrá crecer en unos medios de cultivo y no en otros.
Función de medios cultivo:
- separar y aislar distintas especies microbiales presentes en una muestra.
- paso previo para el estudio de identificación de un microorganismo problema.
- conocer el metabolismo en función del nutriente o sustrato que utiliza (lactosa) o metabolito que produce (indol).
- estudios macroscópicos => visualizar las características de las colonias en medios sólidos.
- realizar antibiogramas determinando la sensibilidad (mayor/menor) de la bacteria problema a distintos antibióticos.
- pruebas de CMI (concentración minima inhibitoria)
- conservar las especies microbiales o muestras.
Requerimientos energéticos y no energéticos de los medios de cultivo - fuente de energia (fuente de carbono y de nitrogeno) y fuente no energética (azufre, fósforo, iones metálicos, factores de crecimiento, f. de arranque y inhibidores) necesarios para el desarrollo (crecimiento) de cultivos microbiales; fuente de carbono => acido acetico, alcohol, citrato sódico, azucares (mono o disacáridos incluso almidón => glucosa, lactosa, maltosa), CO2 (bacterias fotosintetizantes y quimiolitotrofas); conocer el tipo de azucar utilizado => útil para su identificación bioquímica y clasificación taxonómica; fuente de nitrógeno (menos energética) => proteínas completas (gelatina - determinar actividad proteolítica/gelatinasa; extractos de carne y sales de amonio), péptidos/polipeptidos (peptonas - extractos de levadura, caseína - trípsica de caseína/triptófano => formación de indol) o aminoácidos y otros => nitratos, nitrogeno organico, amoniaco, sales de amonio, aminoacidos; conocer la fuente nitrogenada => util para clasificación taxonómica; fuente de azufre => sulfatos, tiosulfatos, aminoacidos (metionina, cisteina, tiamina); fuente de fosforo => fosfatos; iones metalico => hierro, potasio, sodio, magnesio y en concentraciones mas bajas => cinc, manganeso, cobre, cobalto, etc;
Otros requerimientos no energéticos:
Factores de crecimiento => componentes que muchas bacterias no son capaces de fabricar por si solas para su crecimiento (aminoácidos => cisteina; factor X y factor V procedente de la degradación Hb; vitaminas, bases puricas y pirimidicas); factores de arranque => sustancias que permite a la bacteria salir de su fase de latencia y comenzar su fase de crecimiento exponencial (fuentes de energía => glucosa; iones metálicos que estimula el crecimiento); factores inhibidores => componentes que bloquar el proceso metabólicos de algun microbio; muy útiles para la identificación y tipificación bioquímica de las bacterias
(azida sodica => impide Gram-; antibióticos => inhibidores y destructores; colorantes la eosina azul de metileno utilizado por medio Levine; cristal violeta en medio Mac-Conkey => impide Gram+).
Condiciones que ha de cumplir un medio de cultivo:
1. Una composición de nutrientes adecuada (requerimientos energéticos y no energéticos)
2. Condiciones físico-químicas apropiadas:
- Temperatura optima/ideal (según la especie microbiana => psicrófilas <20ºC; mesófilas 18-45ºC; termófilas > 45ºC; las bacterias patógenas del hombre 35-37ºC; fuera de estas no crecen o crecen mucho mas despacio;) e.j.: Yersinia 22ºC, Campylobacter 45ºC (los dos son gastrointestinales)
- Grado de humedad (cantidad de agua que necesita para crecer)
- pH adecuado es en general cercano a la neutralidad +/- 7(estabilizante de pH => buffers o tampones que facilitan el crecimiento); pH acido => Tiobacilos (cerca a 0); pH alcalino => bacilos ureasa positivo/ Proteus (en torno a 8) y Vibrio cholerae (pH 9)
- Presión osmótica en general isotónia (300 miliosmoles)
- Presencia o ausencia de oxigeno; la mayoría de las bacterias aerobias y anaerobias son facultativos que se desarollan bien con y sin O2; existen pocos anaerobios estrictos; bacterias microaerofílica => produce mas CO2.
Principales tipos de medios de cultivo
- según su proporción de agua / su consistencia (sólidos, líquidos, caldo)
- según su uso / su utilización (para aislamiento, crecimiento en general /recuento, identificacion, mantenimiento de cepas, para antibiogramas)
- según su origen del que proceden (naturales, sintéticos y semi-sintéticos, complejos)
- según su presentación (deshidratados o liofilizados, sólidos en placa petri, sólidos en tubo, líquidos en tubo, semi-sólidos en tubo, doble fase en frasco o tubo).
Medios de cultivo según su proporción en agua:
- Medios sólidos > 15% de agar; para aislamiento, identificación, elaboración de antibiogramas) =>1881 Koch utiliza la gelatina (inconveniente => se funde a 24oC y existen bacterias gelatinasa positiva que destruiran tal medio); posteriormente Hesse su alumno usa el agar (medio inerte).
- Medios líquidos/caldos => contiene agua, fuente de carbono, sales minerales y algunos lleva factores de crecimiento, vitaminas, peptonas y aminoácidos.
- Medios semisolidos => agar semi-sólidos (<5% de agar)
Medios de cultivo según su uso o utilización:
- Medios para aislamiento => {a} medios enriquecidos (componentes basicos + caseina soja, triptofano para microorganismo exigente; e.j. agar sangre/chocolate {b} medios selectivos (componentes basicos + componentes que impiden el crecimiento de algún tipo bacteriano para seleccionar) e.j. medio Rothe (para aislar Streptococcus faecalis /Gram+) contiene azida sódica que impide Gram-; la mayoria de medios selectivos son también medios diferenciales {c} medios diferenciales (= medios selectivos + sustancias resalta las caracteristicas microbiales de algunas; e.j. medio Levine (contiene eosina y azul de metileno que inhibe Gram+ y algunas Gram-, facilita a las enterobacterias y lactosa (para las fermentadoras)
- Medios para crecimiento en general => liquida o solida sirve para el crecimiento de la mayor parte de las bacterias (componentes basicos + sales y agua) ; e.j. el caldo comun (contiene extracto de carne, peptona, glucosa, cloruro sodico y agua); el caldo Tioglicolato.
- Medios de identificación (= medios diferenciales) => sirve para clasificar taxonómica-mente el microoganismo; e.j. agua peptonada = indol positivo; caldo Stuart urea-indol = ureasa; glucosa = fermentación de glucosa (sacarolitico = sacarosa positivo).
- Medios de mantenimiento de cepas => mantener las cepas vivas durante periodos de tiempo relativamente largos a temperaturas bajas para impedir su crecimiento; e.j. leche descremada congelada
- Medios para antibiogramas; e.j. Proctor (antibiogramas fungicas), Mueller Hinton (a.b.bacterianas), Wilkins-Chapman (a.b. bacteriana anaerobicas).
Medios de cultivo según su origen
- Medios naturales => poco utilizados, se preparan artesanalmente, constituidos por ciertos tejidos, liquidos organicos (leche, huevo, patata, suero sanguineo)
- Medios semi-sintéticos => parte de su composicion son extractos naturales (levadura, malta, patata, sagre, leche) + constituyentes sintéticos
- Medios sintéticos => estructuras sintéticas mas o menos puras y químicamente definidas disueltas en agua destilada (los mas utilizados en bacteriologia y en general); contiene: fuente de carbono o azucar, fuente de nitrógeno inorgánica como iones NO-3, NH+4 o orgánica como peptona, aminoácidos, aminas, etc., compuestos minerales como oligoelementos, factores de crecimiento (vitaminas, aminoacidos, bases puricas o pirimidínicas).
- Medios complejos => son los primeros que se utilizaron en bacteriología; en actualidad se uss mas en parasitología y virología; se preparan de forma compleja (tejidos animales/carne de musculo, higado, corazon, yema de huevo, azucares, pepetonas, vegetales, etc.
Medios de cultivo segun su presentacion
- Medios deshidratados o liofilizados
- Medios ya preparados
- Medios solidos en placa Petri
- Medios solidos en tubo
- Medios liquidos en tubo
- Medios semisolidos en tubo
- Medios de doble fase en frasco
Principales medios utilizados en microbiología
1. Agua peptonada (peptona en medio acuoso con pH 7 a 37ºC 24-48 horas) => determinación de la producción de indol debido a su alto contenido en triptófano; tras la adición de 5/6 gotas de reactivo Kovacs en hidróxido potásico (KOH 40%) => anillo rojo en la superficie indicara indol positivo.
2. Medio Chapman (selectivo y diferencial) => aislamiento de Staphylococcus (halófilos) S.aureus (coagulasa+); Comp: alto contenido de cloruro sódico 75 gr (agar manitol salado); 15 gr de D-manitol (diferencial => azucar utilizado por algunos estafilococos), 25 gr de rojo fenol (indicador positivo de pH a 37ºC 24-48 horas => amarillo dorado); es orientativa, se debe completar la prueba con pruebas bioquímicas (coagulasa/latex); S.epidermidis no fermentan el manitol, por tanto el color sigue rojizo o purpureo.
3. Agar de Thayer y Martin (Agar New York City) => no permite el crecimiento de muchos microorganismos, pero si permite aislar gonococos y meningococos (Neisseria); Comp: agar chocolate/ sangre calentado + formula polyvitex (vitaminas y aminoácidos) + VCAT (vancomicina => inhibe los Gram+, colistina => inhibe los coliformes /Gram-, anfotericina => antifúngico, trimetropinsulfametroxazol => antibiótico de amplio espectro).
4. Agar chocolate Polyvitex => medio general enriquecidos donde crecen la mayoría de bacteria y Haemophyllus); Comp: agar chocolate + formula polyvitex (vitaminas y aminoácidos) incluyendo factores X (hemina) y V (NAD/ nicotinamida adenina dinucleótido) proporcionados por la hemoglobina y PolyViteX.
5. Medio base Christensen (líquidos y sólidos) => para la prueba de la ureasa; ureasa+ de rojo => rosa; gérmenes con ureasa+ => Proteus y Helicobacter pilory
6. Medio citrato de Simmons (agar solido) => prueba de citrato (como fuente de energía) para la investigación de bacilos Gram- (la diferenciación entre coliformes y coliformes fecales. Los coliformes fecales (E.coli) no fueron capaces de utilizar el citrato como fuente de carbono ni a las sales de amonio como fuente de nitrógeno. Los coliformes no fecales como Enterobacter aerogenes o Salmonella enteritidis podían utilizar el citrato en este medio dando una reacción alcalina); Comp: citrato sódico, azul de bromotimol (indicador pH, de que el citrato esta consumido /se alcalina; verde => azul); gérmenes con citrato permeasa => Klebsiella pneumoniae, Salmonella, Enterobacter aerogenes.
7. Medio Clark y Lubs (caldo/ liquido) => para diferenciar entero-bacterias mediante prueba de Voges-Proskauer (producción de acetoína/ acetil metil carbinol => por reducción a 2,3 butanodiol o por oxidación a diacetilo); y prueba de Rojo de Metilo (acidificación del medio con pH <4,5 y cambio de color a rojo); gérmenes con VP+ => Klebsiella pneumoniae y Enterobacter aerogenes; gérmenes con RM+ => Proteus, E.coli y Salmonella.
8. Medio Cled/Cystine-Lactose-Electrolyte-Deficient (solido) => recuento e identificación de gérmenes en las vías urinarias; Comp: lactosa en alta cantidad, azul de bromotimol (indicador del consume lactosa verde => amarillo); las colonias mas frecuente => E.coli (amarilla L+), Proteus (azul L-), Klebsiella (amarilla azulada y muy mucosa (L+), Pseudomonas aeruginosa (verde L-), Streptococcus faecalis (amarilla L+), Staphylococcus aereus (amarilla L+).
9. Agar sangre (se comercializa con nombre TSA => tripticasa, soja, agar) => investigación de microorganismos hemolíticos (consume hematíes); es un medio general enriquecida; Comp: sangre de cordero (agar columbia) o caballo o ternero => estériles y desfibrinadas; alfa hemólisis/ neumococo (parcial) => halo verdoso/difuso alrededor de la colonia; beta hemólisis/ Streptococcus B-hemolítico y Staphylococcus aureus que causan anginas (total) => halo transparente; gamma hemólisis/ Pseudomona causa gastro intestinales (no hemolizar) => sin halo.
10. Medio eosina azul de metileno /EMB (Medio Levine) => selectivo y diferencial, para aislamiento de entero-bacterias Gram- (E.coli, Enterobacter, Salmonella, Shigella, Proteus, Klebsiella) Comp: alto contenido de lactosa (indicador fermentadora), eosina azul de metileno (indicador de pH y inhibidor los Gram+ y las floras de Gram- fastidiosas).
11. Medio de agar Hektoen (diferencial y selectivo) => aislamiento de entero-bacterias patógenas Gram-; Comp: sales biliares (inhibe Gram+), lactosa (indicador de L+ => amarillo/naranja) sacarosa, peptona, tiosulfato sódico y citrato férrico amoniacal (indicador de la producción SH2/H2S => puntos negro), azul de bromotimol, fuschsina ácida (indicadores de pH); en condición normal es verde => fermentacion de lactosa/acidificación => vira a amarillo/naranja (características de fermentadora L+ Escherichia, Serratia, Klebsiella, Citrobacter, Enterobacter y Vibrio cholerae); cuando se consume lactosa + peptona (se acidifican primero, y después se basifican) => verde; cuando se consume azufre/ disulfurasas+ => precipita el hierro y la colonia se vuelve negro (característica de Salmonella y Proteus vulgaris).
12. Medio Kliger o KIA (Kliger Iron Agar) => medio solido en tubo (color caramelo); muy semejante y mas utilizado es TSI (triple sugar, iron) + 10 gr de sacarosa; muy utilizado para la identificación de entero-bacterias, pruebas de la lactosa, glucosa, gas y SH2; Comp: lactosa (indicador de L+), peptonas, glucosa, citrato férrico amoniacal y tiosulfato sódico (componentes para producir SH2), rojo fenol (indicador de pH); los gérmenes productor de SH2+ => Proteus, Salmonella y Citrobacter; los productores del gas CO2+ => Salmonella y Citrobacter y E.coli.
13. Medio MacConckey (color rosa) => aislamiento e identificación de entero-bacterias Gram-/ poco exigentes; Comp: sales biliares (inhibidor Gram+), lactosa (indicador L+), cloruro sodico, rojo neutro, cristal violeta (inhibidor los cocos de Gram+); L+ (consumidor de lactosa) => rojo (E.coli y Enterobacter aerogenes), L- (no fermentador)=> Salmonella, Shigella y Pseudomonas; Gram- exigentes => Neisseria, Haemophyllus.
14. Medio Mueller Hinton (general) => para la realizacion de antibiograma por el método de Bauer-Kirby
15. Medio Ornitina Movilidad/ MIO (preparado en tubo/ semisolido) => identificación de la movilidad bacteriana (entero-bacterias), capacidad para descarboxilar la ornitina (orinitina descarboxilasa /está dada por un color púrpura/ alcalinidad del medio y la producción de indol (al añadir reactivo de Kovacs); La movilidad se demuestra por un enturbiamiento del medio o por crecimiento que difunde mas allá de la línea de inoculación; el germen que da resultado positivo de los 3 pruebas => E.coli.
16. Medio caldo F-Selenito (selectivo) => medio enriquecido con fosfato para el aislamiento de Salmonella; Comp: selenito sódico (inhibidor de flora Gram+ y Gram- excepto Salmonella); después también se hace cultivo con agar SS.
17. Medio agar S-S (color caramelo) => aislamiento de las bacterias patógenas importantes Salmonella y Shigella; Comp: lactosa (indicador fermentadora de L), tiosulfato sódico y citrato de hierro (indicador de SH2), sales biliares y verde brillante (inhibidor bacillos Gram+), rojo neutro (indicador de pH); L+ (coliformes - E.Coli y Klebsiella) => rojas o rosadas; L- y SH2- => incoloras (típico de Shigella); L- y SH2+ con la precipitación de hierro => negro (típico de Salmonella).
18. Medio Agar XLD (agar xilosa-lisina-desoxicolato) => se utiliza para el aislamiento y diferenciación de bacilos entéricos Gram-, especialmente del género Salmonella y especialmente Shigella (entero-bacterias patógenas); Comp.: xilosa (la fermentan los entéricos menos Shigella), sacarosa y lactosa, desoxicolato de sodico (inhibe Gram+); se puede utilizar para la identificación de lactasa+, lisina descarboxilasa+ => Salmonella que alcaliniza el medio y SH2+ (tiosulfato sódico + citrato de hierro amoniacal).
19. Medio caldo Columbia => caldos para hemocultivos.
20. Medio Castañeda (caldo y solido) => búsqueda de gérmenes Brucella, Vibrios y Pasteurella en sangre (hemocultivos).
21. Medio de Lowenstein-Jensen (selectivo) => cultivo de Mycobacterium tuberculosis y otras micobacterias; Comp: fécula de patata, verde malaquita => inhibidor de la mayoría de gérmenes; la prueba se confirma con tinción de acido alcohol resistencia (Con la tinción de Ziehl-Neelsen las micobacterias se observan como bacilos de color rojo); micobacterias patógenas crecen muy lenta (+ 7 días); los niveles bajos de la penicilina y el ácido nalidíxico también están presentes en el medio de LJ para inhibir el crecimiento de Gram+ y Gram-, con el fin de limitar el crecimiento => único de micobacterias.
22. Medio Sabouraud => para el aislamiento e identificación de hongos micelares y levaduriformes.
23. Medio Sabouraud gentamicina tetrazolium => para el aislamiento e identificación de Candida (levaduriformes); La gentamicina inhibe el crecimiento de la mayoría de las bacterias Gram- y Gram+.
24. Medio Schaedler con vitamina K3 (caldo o agar solido) => para cultivo de anaerobios (estrictos y facultativos); La presencia de factores de crecimiento como el extracto de levadura, la hemina y la vitamina K3 y la adición de sangre de cordero permite el crecimiento incluso de las especies más exigentes.
El agente reductor (L-cistina) y la elevada concentración de dextrosa en el medio favorecen el crecimiento
de especies anaerobias p.ej. Lactobacillus, Streptococcus, Clostridios y Bacteroides.
25. Medio CPS cromogénico (agar/ solido) => es un medio de aislamiento y de identificación destinado a las muestras urinarias; permite realizar (1) el recuento microbiano (método de inoculación estandarizado); (2) identificación de: Escherichia coli, Enterococcus del grupo D, KES (Klebsiella, Enterobacter, Serratia), Proteeae (Proteus, Providencia, Morganella); la concentración elevada de agar evita el crecimiento invasivo de Proteus; el medio se inocua directamente a partir de la orina, respetando técnicas adecuadas de toma de muestras y su transporte; permite la identificacion directa de:
a. E.coli => coloración espontanea (rosa a burdeos) de las colonias productores de B-glucuronidasa (B-GUR) y coloración azul revelada por el reactivo indol cuando la cepa genera triptofanasa.
b. Enterococcus y KES => coloración espontanea azul-verde de las cepas que producen B-glucosidasa (B-GLU).
c. Proteeae => coloración marrón revelada por el reactivo TDA cuando la cepa genera triptófano desaminasa (sin reactivo es incoloro).
Modo operativo - dejar atemperar las placas a temperatura ambiente; inocular la muestra con el asa calibrada de 10ul => sumergir el asa en la orina, mantenerlo verticalmente; descargar el asa al realizar una estría sobre un radio de la placa; realizar estrías perpendiculares muy apretadas sobre toda la superficie de la placa; incubar en la estufa con la tapa hacia abajo a 37ºC en aerobiosis; se examinan los cultivos después de 24 horas de incubación.
Lectura e interpretación:
Recuento - estimar la concentración bacteriana comparando la densidad de las colonias presentes sobre la mitad superior de la placa con la del esquema; <1000 (negativo), entre 1000 - 100.000 (dudoso), mas de 100.000 (positivo)
Identificación - observar las colonias
(1) Colonias de color rosa a burdeos o translucidas con centro rosa a burdeos => presunción de E.coli; confirmar mediante una detección de indol (depositar una colonia sobre un disco de papel previamente embebido de una gota de reactivo R1 del envase ID Indol TDA) => indol+ da una coloración azul (E.coli); la ausencia de color azul (indol-) se debe proceder a la pruebas de API.
(2) Colonias de color azul-verdoso y observación de cocos Gram+ mediante examen directo => Enterococcus; si no cumple esta condición, se debe proceder a las pruebas de API.
(3) Colonias de color azul-verdoso y observación de bacilos Gram- mediante examen directo => grupo KES; la identificación se debe proseguir mediante pruebas bioquímicas (ureasa+ => Klebsiella; ornitina descarboxilasa+ => Enterobacter; gelatinasa+ => Serratia).
(4) Colonias incoloras a marrón-anaranjado => efectuar TDA (depositar sobre algunas colonias idénticas, una gota de reactivo R2 del envase ID Indol TDA), observar la coloración después de unos 30 segundos => TDA+ da una coloración marrón +/- oscuro; efectuar indol => indol+ da color azul (Proteus, Providencia o Morganella); ausencia de coloración azul es indol- (Proteus mirabilis); TDA- da una coloración amarilla y la identificación se debe proceder a las pruebas de API.
Tema 7 - Metodos de Siembra (cultivo de las cepas)
Sembrar - cultivar la muestra utilizando técnica y medios adecuados para conseguir el objetivo (identificar el microorganismo).
Preparación de inóculos (pequeña parte de muestra)
- Muestras viscosas o concentradas (análisis cuantitativo) => suspender un cultivo joven y puro o un producto patológico (muestra biológica) en 5 ml de solución diluyente (caldo de cultivo, suero fisiológico estéril o agua destilada estéril.
- Ajustar con la escala con un gradiente de turbidez (tecnica de Kirby-Bauer) => tubos numerados como patrón de referencia según la concentración de microorganismos; se ajusta mediante comparación visual aproximada o mediante la absorbancia de espectrofotometría; escala de Mcfarland => una serie de tubos con precipitación blanco de sulfato de bario por reacción de acido sulfúrico + cloruro de bario (escala 0,5 = 1,5 x 10.6/ml de microorganismos en el inoculo; escala 1 = 3 x 10.6 /ml; escala 2 = 6 x10.6./ml.
Metodos de inoculación y aislamiento de microorganismos
1. Metodos de siembra - inoculación:
{a} En medio liquido; con asa => se sumerge el asa cargada en el medio y se agita; con pipeta => se vierte el contenido de la pipeta sobre el medio de cultivo y se homogeneiza; con escobillón = con asa.
{b} En medio solido (en placa):
- Inoculación previa al vertido en placa (técnica de Barry - no se utiliza mucho) => 0,1 ml de inoculo + 25 ml de medio cultivo => fundido/ atemperado a 45-55ºC para no esterilizar => homogeneizar => verter en la placa de Petri.
- Inoculación sobre la superficie del medio solidificado (técnica de Kirby-Bauer) => se prepara el inoculo en un tubo estéril; se introduce un escobillón estéril impregnando; se elimina el exceso presionando el escobillón con movimiento de rotación contra las paredes del tubo; se siembra la placa emplenando la técnica de los tres giros distribuyendo uniformemente el inoculo; se deja secar la placa 4-5 minutos en posicion semiabierta e invertida, quedando lista para ser utilizada (en los antibiogramas).
{c} En medio solido (en tubo):
- Siembra por estria en superficie inclinada => se toma la muestra con el asa /hisopo; se introduce en el tubo que contiene el medio; desde el fondo y en progresión ascendente se desliza el asa en movimiento de zig-zag (se utiliza para pruebas bioquímicas y renovar cepas).
- Siembra en picadura (para ver la movilidad de los gérmenes en la zona de punción + pruebas bioquímicas) => se toma la muestra con la aguja o hilo; se punciona en el centro del medio introduciendo la punta de la aguja hasta 2-3 mm del fondo del tubo; se extrae la aguja por la misma linea que se introdujo; medio solido inclinado => puede realizarse tambien una siembra en estría por la superficie del medio con la misma aguja; agar semi-solido => puede usar el asa en lugar de la aguja.
2. Metodos de siembra - aislamiento (para obtener cepas puras/ bien aisladas) :
{a} Siembra en estria o zig-zag => se deposita el inoculo en el extremo superior de la placa; se siembra con el asa o con hisopo, a partir del inoculo, con un movimiento en zig-zag cada vez mas amplio de lado a lado de la placa; el estriado ha de hacerse sin presionar el medio, suavemente, sin levantar el asa y sin flamearla; las colonias mas aisladas las obtendremos en la zona mas distal del inoculo, es decir al acabar la siembra.
{b} Siembra en tres direcciones => se deposita el inoculo en el extremo superior de la placa dejando deslizar hacia el centro para ello inclinaremos la placa (también se puede arrastras con el asa); mediante asa o escobillón, haremos movmientos laterales de un lado a otro de la placa, dejando las estrias muy juntas; giramos la placa 90º y realizamos la misma operación, sin flamear o cambiar de asa; volvemos a girar la placa haciendo lo mismo; al final nos queda una placa muy bien tapizada. Se realiza en urinocultivos para el contaje de las colonias.
{c} Siembra en estría multiple => se deposita el inoculo en un extremo de la placa; con el asa se reparte en varios tramos, siguiendo el borde de la placa; entre cada tramo se ha de flamear o cambiar el asa; los segmentos seguidos describen un poliedro regular y el ultimo tramo se efectua hacia el interior en el que se obtendran colonias aisladas.
{d} Técnica por agotamiento en cuadrantes (lo que usamos) => es muy similar a la anterior pero sin flamear el asa y estriando mas los cuadrantes, aprovechando mas la placa.
{e} Técnica de los 4 cuadrantes => se divide la placa en 4 cuadrantes (pueden rotularse por la parte posterior); se deposita el inoculo en el extremo superior de uno de los cuadrantes y se siembra en estría; sin flamear el asa, se realiza la misma operacion sucesivamente en los otros 3 cuadrantes; en cada uno de ellos se sembrara el inoculo que queda adherido al asa, tras la siembra del anterior; en el ultimo de los cuadrantes sembrado, se encuentran las colonias aisladas.
{f} Técnica de los tres giros => se siembra en estría la mitad de la placa; flamear el asa; se gira la placa 90º, sembrando en estría la mitad superior de la misma; se repite la operación, es decir se ha de flamear el asa, se gira la placa y se estría; la colonia aisladas aparecerá en la zona sembrada en ultimo lugar.
Tema 8 - Características biológicas de la bacteria (Morfología)
Bacterias - organismos unicelulares de tamaño 0,2-2 um, relativamente sencillos, cuya material genético no esta rodeado por una membrana nuclear especial (procariotas).
Estructura - constituidos por elementos obligados (presentes en todas las bacterias e indispensables para su vida => pared celular, membrana plasmática, citoplasma, ribosomas y la región nuclear); elementos facultativos (son elementos de supervivencia y virulencia que pueden estar o no presentes en la bacteria => capsula, flagelos, pelos/pilis, endosporas e inclusiones citoplásmicas)
Pared celular - es el limite externo de la célula con estructura rígida, parecida a la pared celular de las células vegetales; funciones => protegerse de cambios externos adversos, mantener la morfología de la célula, proporciona la resistencia a los antibióticos, dar un paso selectivo de algunas sustancias, proporciona la especificidad de grupo y de tipo (clasificación), implicada en la patogenicidad; dar el color en la tinción de Gram, violeta oscuro => Gram+ y color rosa => Gram-.
Estructura y composicion de la pared celular - Gram+ => mono-estratificada y gruesa, compuesta por mureina (peptidoglicano - mono-capa, 50% peso seco/mucha cantidad), polisacáridos, proteínas y ácidos teicoicos; Gram- => biestratificada y fina (1ª capa es mureina en poca cantidad y 2ª capa formada por polisacáridos proteínas, fosfolipidos y lípidos, no tiene ácidos teicoicos); las bacterias que no son sensibles a la tinción de Gram => BAAR/ acido alcohol resistentes (micobacterias); las que sin pared celular => los de genero mycoplasma/ patógenas; la que tienen (formas S), pero la pierden (formas L).
Membrana plasmática - estructura delgada que se extiende por dentro de la pared celular, encerrando al citoplasma; funciones => actúa como barrera selectiva, interviene en la degradación de nutrientes y producción de energía, en algunas se encuentran pigmentos y enzimas para la fotosíntesis; estructura y composición => fosfolípidos, proteínas y glicolípidos; mesosomas => plegamientos hacia dentro de la membrana plasmática, irregulares (no existen en las celulas eucarióticas), se encargan de dirigir la duplicación del ADN bacteriano y realizar la respiración.
Citoplasma - es todo lo que hay en el interior de la membrana plasmática; función => engloba los orgánulos celulares (región nuclear, ribosomas, inclusiones/depósitos de reserva, vacuolas); no tienen ni aparato golgi, ni retículo endotelial plasmática, ni mitocondria; composicion => 80% de agua, enzimas, iones y principios inmediatos.
Región nuclear - una zona en el interior del citoplasma donde se acumula el acido nucleico; funciones => el acido nucleico transmite la información genética de la célula sobre estructuras y funciones celulares; estructura y composicion => es un núcleo difuso que contiene 1 molécula ADN bicatenario, formando N cromosomas (enroscada en forma de anillo); plásmidos => estructuras que pueden existir ademas de ADN cromosómico (formadas por moleculares de ADN extra-cromosómico bicatenario, pueden estar libres o unidos al ADN cromosómico /episomas), se replican independientemente, se transmite por conjugación, portan genes muy importantes que determinan la resistencia a antibióticos, tolerancia a metales tóxicos y síntesis de enzima.
Ribosomas - son orgánulos celulares muy abundantes (presentes en eucariotas y procariotas) dan aspecto granuloso a su citoplasma; funciones = > síntesis de proteínas; estructura y composicion => en grupos de 3 o 4 unidos por un filamento de ARN mensaje (polirribosomas), cada ribosoma tiene 2 subunidades de 30 y 50 Svedberg (velocidad relativa de sedimentación), procariotas - 70S y eucariotas - 80S; comp: 60%ARNr y 40% proteínas.
Elementos facultativos (algunos no tienen - variables) - son elementos de supervivencia y virulencia
Inclusiones citoplásmicas - aparecen en el citoplasma y no tienen una estructura uniforme; funciones => depósitos de reserva e intervienen en funciones de regulación; Tipos: (1) Gránulos de reserva => lipídicos, corpúsculos metacromáticos (fosfato inorgánico), polisacáridos (glucógeno y almidón), gránulos de azufre; (2) Vacuolas => acúmulos de gases o líquidos rodeados de membrana (donde se fija CO2).
Flagelos - largos apéndices filamentosos frecuentes solo en los bacilos (su presencia es rara); funciones => responsable de la movilidad (elementos patogénico: facilitar la difusión de las bacterias a traves de las
membranas); estructura => tres partes (filamento, codo y corpúsculo basal); tipos => monótricas (1 solo flagelo en un extremo), lofótricas (2 o mas en un extremo), anfítricos (un grupo de flagelos en un extremo y otro grupo en el otro extremo), perítricos (flagelos distribuidos en toda la superficie de la bacteria);
Pelos /pilis o fimbrias - elementos rígidos constituidos por una proteína (pilina); cortos, muy numerosos, distribuidos sobre la superficie, mas frecuentes en Gram- que en Gram+; funciones => capacidad de fijación a superficies (pelos comunes), proporcionan pelos comunes y sexuales (son morfológicamente iguales), sistema de intercambio de información genética por conjugación (pelos sexuales).
Endosporas - solo en bacilos (Bacillus aerobio estricto y Clostridium anaerobio estricto); una forma de resistencia que adoptan algunas bacterias ante situaciones adversas (deficiencia nutricional, desecación, frio, temperaturas elevadas, agentes químicos); se forman por un proceso de esporulación /esporogénesis, pueden permanecer latentes durante cientos de años y volver a una forma vegetativa por un proceso germinación; localización => zona central, subterminal o terminal (depende de su tamaño, pueden o no deformar el bacilo); la espora => célula en reposo con capacidad de resistencia a la desecación, calor y agentes químicos; esporulación => la producción de estructuras, enzimas y metabolitos nuevos y la desaparición de muchos componentes celulares; Morfológicamente comienza con el aislamiento del núcleo y elementos energéticos mediante el crecimiento en vaginante de la membrana; los elementos esenciales para la vida quedan protegidos en esa nueva estructura (endosporas); la bacteria queda en estado latente esperando una condición externas favorables para resurgir.
Capsula - estructura que rodea la pared bacteriana; se visualiza con tinción negativa (tinta china); funciones => regula el intercambio de agua, iones y nutrientes, sirve como almacén externo de nutrientes, defensa frente a Acs, fagos y celulas fagocíticas (elemento virulencia), protege de la desecación (contiene agua), formación de colonias (habitualmente engloba mas de una bacteria); estructura y composición => polisacáridos y proteínas.
Tamaño y Morfología de las Bacterias - 0,2 - 2 um; es preciso utilizar el microscopio óptico; la morfología => información primaria sobre el tipo de bacteria, pero no de forma concluyente (viene dada por la rigidez de la pared; formas => esférica/coco, coco-bacilo, bastoncillo/cilíndrica/bacilo, helicoidal/espirilo, en coma/vibrio, espiral/espiroqueta, estrella y cuadrangular /forma de hifas de hongos (actinomyces/ streptomyces - productor de muchos ATB, ATF y inmunosupresores); agrupación de los cocos => aislados, en parejas/diplococos (granos de cafe - típico de neisserias/meningitis), en cadenas/estreptococos, tetradas o tretacocos (4 celulas => micrococcus/micrococacceae), en racimos/estafilococos, en formas cubicas de 8 elementos/sarcinas (sarcinas ventriculi - tolerancia al medio ácida/ estomago); agrupación de los bacilos => aislados, en parejas/diplobacilos, en cadena/estreptobacilos, algunos se parecen a cocos/cocobacilos (E.coli), en forma empalizada/letra china (corynebacterium - algunos son saprofitos de la piel y también causante de difteria).
Aroma típicos => Pseudomonas aureginosa (olor a jabón); Haemophyllus (olor a semen/yeso); Citrobacter (olor a fétido); Proteus (olor a amoniacal); Klebsiella y E. coli (olor a levadura de pan).
Tema 10 - Fisiología de las bacterias
Morfología macroscópica - estudio de la forma y estructura de las colonias (masas constituidas por muchos millones de bacterias, se aprecian a simple vista y originadas a partir de una bacteria en el medio solido); reconocible en función de => 1. características o tipo de medio de cultivo solido donde se ha desarrollado (un microorganismo puede dar lugar a distintos tipos de colonias) 2. tipo de microorganismo (mayor movilidad => colonias extendidas y planas); la verificación de las colonias (siempre en medios sólidos sembrándolo por estría) => en placa y en tubo con agar inclinado.
Las colonias en placa - sembrándolo por estría
El tamaño y el aspecto de cada colonia son bastante constante para cada genero y especies, hecho que se puede utilizar como característica diferencial; tamaño => 1-2 mm (E.coli); 4-6mm (stafilococcus en agar sangre); extendidas en forma de velo invadiendo toda la superficie del medio (Proteus en AS); puntiformes +/- 0,5 mm o inferiores (stafilococos en AS); forma => según el espesor (planas, elevadas, semiconvexas, cóncavas semicóncavas, semiesféricas, en meseta); según los bordes (lobuladas, onduladas, rizoides, redondeadas, filamentosas, especuladas); superficie de la colonia/ elevación/ aspecto => lisa, rugosa (con capsulas), plana, acuminada, umbilicada, mucosa, seca; consistencia de la colonia => duras, viscosas, mucosas, secas, muy secas, cremosas; transparencia y coloración => debido a la elaboración de algún tipo de pigmento, formación de alguna sustancia por parte de la bacteria o la utilización de algún sustrato del medio que se acidifique o basifique; la presencia o no de halos de transparencia => generado por la prueba de la gelatinasa (+) en placa y también por la actividad hemolítica de ciertas bacterias con hemolisinas (estreptococos hemolíticos tipo alfa, beta y gamma).
Las colonias en tubo, con agar inclinado - sembrándolo por estría
Las colonias presentan las mismas características que en placa, pero su visualización es mucho peor (menor superficie); aspecto => filiforme, rizoide, arborescente, filamentoso, difuso, perlado, equinulada, arrosariada.
Morfología microscópica - estudio de la estructura fina de las bacterias
1. Estudio de su forma como célula procariota individual:
oval/esférica => coco/cocoidea; cilíndrica/bastón => bacilo; espiral/helicoidal => espirilo/sacacorchos /espiroquetas; filamentosa/forma de hifas de hongos => filamentosas (actinomyces/ streptomyces), formas intermedias => vibrio, coco-bacilos; bacterias helicoidales => Borrelia (poca espiras y amplitud), Treponema (tiene mas espiras) y Leptospira (muy apretadas y enroladas).
2. Estudio de su agrupación bacteriana (no todas las formas bacterianas se agrupan, p.ej. los espirilos y los actinomicetos) => los mas frecuentes son las formas cocoideas y las bacilares son menos frecuentes; las cocoideas => diplococos (parejas /granos de café => neisserias y neumococos); estreptococos (paralelos/cadenas => streptococcus); tetradas o tretacocos (4 celulas => micrococcus/micrococacceae); estafilococos (racimos => staphylococcus/ micrococcus); sarcinas (cuboidales de 8 celulas o mas; sarcina ventriculi y también stafilococcus); las bacilares => diplobacilos/parejas, estreptobacilos/ cadenas y formas irregulares/en empalizada/letra china (corinebacterium).
TAXONOMÍA - CLASIFICACIÓN DE LAS BACTERIAS
La clasificación definitiva de las bacterias esta aun por establecer; los que se utilizan actualmente deben considerarse como provisionales o transitiva; la mas utilizada suelen ser recogidas de las manuales BERGEY'S en la 9ª edición de Bergey's Manual of Determinative Bacteriology de 1994, se agrupan a las bacterias en 35 grupos, situados en 4 categorías mayores:
1. Eubacterias Gram- (bacterias verdaderas) con 16 grupos; en esta categoría se incluyen a la mayor parte de las bacterias que provocan a la patología humana.
Espiroquetas:
- Familia Leptospiraceae (genero - Leptospira)
- Familia Spirochaetaceae (genero - Borrelia, Treponema)
Helicoidales /vibrioides aerobias - microaerófilas móviles (crecen mejor a bajas presiones de oxígeno):
- Familia Campylobacteriaceae (genero - Campylobacter, Helicobacter)
Bacilos y cocos aerobios - microaerófilos (crecen mejor a bajas presiones de oxígeno):
- Familia Pseudomonadaceae (genero - Pseudomonas, Stenotrophomonas)
- Familia Alcaligenaceae (genero - Bordetella) => bacilos y coco-bacilos
- Familia Legionellaceae (genero - Legionella)
- Familia Neisseriaceae (genero - Neisseria) => diplococos
- Familia Moraxellaceae / Familia Branhamaceae (genero - Moraxella, Branhamella) => diplococos
- Otros generos => Brucella (cocobacilos)
Bacilos anaerobios y facultativos:
- Familia Enterobacteriaceae (genero - Citrobacter, Enterobacter, Escherichia, Klebsiella, Serratia, Hafnia [coliformes] Morganella, Proteus, Providencia, Salmonella, Shigella, Yersinia/peste)
- Familia Vibrionaceae (genero - Vibrio, Aeromonas, Plesiomonas)
- Familia Pasteurellaceae (genero - Haemophilus)
- Otros generos => Gardnerella
Cocos Gram- anaerobios => genero - Veillonella
- Familia Rickettsiaceae (genero Coxiella, Ehrlichia, Rickettsia) - son parásitos intercelulares obligados, altamente pleomórficas cocos/bacilos/hilos
- Familia Chlamydiaceae (genero Chlamydia) - son parásitos intercelulares obligados de forma esférica.
2. Eubacterias Gram+ con 13 grupos (17-29); en este grupo hay los que provocan patologia humana (la mayoria).
Cocos => genero - Staphylococcus y Streptococcus
Bacilos esporulados => genero - Bacillus (aerobio) y Clostridium (anaerobio)
Bacilos regulares no esporulados => genero - Lactobacillus y Listeria
Bacilos irregulares no esporulados:
- Familia Corynebacteriaceae (genero - Corynebacterium)
Micobacterias:
- Familia Mycobacteriaceae (genero - Mycobacterium)
3. Micoplasmas (Mollicutes / bacterias sin pared) de 1 solo grupo (30); dentro de este grupo, los que provocan patología humana => genero Mycoplasma/ Mycoplasma pneumoniae y Ureaplasma.
4. Arqueobacterias con 5 grupos (31-35); todas las bacterias de este grupo no provocan patologia humanas (viven en las situaciones extremas => termofilas/ termogenas)
Taxonomía => la ciencia de la clasificación que agrupa y separa los organismos de acuerdo con su características fenotípicas, estructurales o genéticas para facilitar su estudio; la misión => construir un esquema racional, para clasificar y nombrar los organismos; el sistema jerárquico de la taxonomía se ha formado gradualmente a partir del sistema binomial / binominal / binaria de nomenclatura genero y especie establecida por Linneo en 1758 (un botánico); la taxonomía no es una ciencia estático, goza de gran dinamismo y esta en la relacion con los avances de los procedimientos empleada para su estudio; el termino de sistemática se utiliza como sinónimo de taxonomía; los grupos de taxonomía van de dominio - imperio - reino - tribu - división - clase - orden - familia - genero y especie.
Para la asignación de una bacteria, se siguen las normas recogidas por el código internacional de nomenclatura bacteriana y adquieren validez cuando ha sido publicado por el Int´l Journal of Systematic Bacteriology; bien en un articulo o bien dentro de los sistemas en las listas de las bacterias aprobadas que incluyen sus números; una especie bacteriana, viene definida por un nombre genérico de un nombre especifico latinizado o helenizado y concuerdan gramaticalmente; la inicial de genero va con letra mayúsculas y el de especie con minúsculas; tanto el nombre de genero o especie se escriben con letra cursiva/ italica o en su defecto, subrayado; en la denominación de un especie, la palabra que define genero puede ser abreviada a su inicial seguida de un punto (p.ej. E.coli o E.coli); los nombres de las bacterias no se eligen de manera arbitraria, sino que pueden ser descriptivos, p.ej. Staphilococcus aureus (cocos en forma de racimos - dorados); o pueden dar homenaje a un autor p.ej. Pasteurella, Bacilo de Koch, también puede dar referencia a un acontecimiento p.ej. Legionella; el nombre generico es único; para referirse a un especie o varios especies no determinadas su genero => E.spp/ sp; algunas de las categorías taxonomia superiores, se forman añadiendo las palabras que las asignan distintas terminaciones, p.ej. aceae; para el orden => ales (sufijo) p.ej. Mycoplasmatales; todas las categorías taxonomía se expresa en cursiva o itálica.
FLORAS BACTERIANAS
Flora Normal de la especie humana => la población de microorganismos comensales que normalmente coloniza la piel y las membranas mucosas de las personas adultas sanas; la piel y las mucosas colonizadas por microorganismos dinámicos => cambios cualitativos y cuantitativos constantemente; 2 poblaciones:
1. La flora residente (FR) => un numero relativamente fijo de especies de microorganismos (comensales y oportunistas) en una zona definida (si se producen alteraciones, suelen ser temporales); permanecen intactas; encuentran condiciones fisiológicas y nutritivas adecuadas; no es esencial para la vida, pero es normalmente beneficiosa (produce vitamina K en el intestino y ayudan en la absorción de nutrientes y impide la colonización de microorganismos potencialmente patógenos.
2. La flora transitoria (FT) => microorganismos no patógenos o potencialmente patógenos, que colonizan la piel o las mucosas en periodo corto de tiempo; tiene poca importancia, pero si la flora residente se altera, la flora transitoria puede multiplicarse y producir infecciones.
La supresión de FR => vació ecológico => ocupación de microorganismos ambientales o de otras zonas de cuerpo => infecciones.
FR oportunistas => los que tienen acceso a lugares estériles; algunos ejemplos:
- Streptococcus viridans son comensales del tracto respiratorio superior y de la boca, si alcanza el torrente sanguíneo => si válvula cardíaca dañada => posible endocarditis;
- Bacteroides son comensales del intestino grueso => si apendicitis perforada => posible peritonitis o bacteriémia.
- Infecciones de pacientes inmunodeprimidos por causas diversas (cáncer, leucemias, linfomas, SIDA)
- E.coli es comensal del colon => lugar estéril (o no habitual) a traves de uretra => infección urinaria
Las causas de las interpretaciones erróneas => no se toma en cuenta al microorganismo como patógeno o se le descarta (como mero contaminante); la omisión o inclusión de una especie en una de las categorías no implica que no pueda ser aislada en otra zona del cuerpo o que en condiciones especiales, pueda producir enfermedad.
Flora normal de la piel, boca y vías respiratorias superiores
- Las principales (en faringe y traquea) => Staphylococcus epidermiditis (coagulasa-), Staphylococcus aureus (coagulasa+) en pequeñas cantidades, Micrococcus spp, Neisseria de especies no patógenas, Estreptococos A-hemolíticos y no hemolíticos, las anaerobias facultativas, Candidas.
- FT/no residente se elimina o se disminuye => pH acido, los ácidos grasos de las secreciones sebáceas, lisozima, el sudor y el lavado diario con jabones desinfectantes; se disminuye de forma temporal => la repoblación es muy rápida.
- Al nacer => la boca y faringe son estériles; tras 12 horas => Streptococcus viridas (las mas abundantes en la boca), posteriormente => estafilococos (S.epidermiditis), diplococos Gram-, difteroides (Corynebacterium); salida de dientes => espiroquetas de Bacteroides, Fusobacterium e Actynomicetes, vibrios anaerobios, Lactobacilos y levaduras; Adulto normal => las principales (mira arriba!!)
- Los bronquios, bronquiolos y alvéolos suelen ser estériles.
Flora normal del tracto intestinal
- Al nacer => estéril, posteriormente => colonizado por microorganismos de los alimentos dependiendo de la dieta (p.ej. la leche materna => Estreptococos y Lactobacilos y el biberón => flora mixta con menos Lactobacilos) .
- Adulto normal => el esófago contiene lo que previenen de la saliva y comida; en el estomago hay poco (pH acido protegen la cólera y salmonelosis - excepto Helicobacter pilori que puede causar ulcera péptida, tiene ureasa que alcalina/neutralizar el acidez: degradar la urea => amoniaco); el intestino delgado superior contiene Lactobacilos y enterococos; intestino delgado inferior (íleon y ciego) contiene la flora fecal; el colon contiene >100 especies 96-99% anaerobios facultativo y estricto => Bacteroides spp, Fusobacterium spp, Lactobacilos/ Bifidobacterium spp, Clostridium spp, cocos Gram+ anaerobios (Peptostreptococcus spp).
- La utilidad/beneficio => sintetiza la vitamina K, transformación de los pigmentos biliares en ácidos biliares, absorción y metabolismo primario de nutrientes.
- La administración de anti-microbianos orales => la posible proliferación de cepas resistentes al anti-microbiano administrado y pueden ser diseminada.
- La administración de ATB por vía parenteral en una cirugía intestinal => necesario para reducir al mínimo posible el numero de microorganismo, evitar trauma en el acto quirúrgico y infección peritoneal e diseminada.
Flora normal de la uretra
- Los mas frecuentes son estafilococos, enterococos, Corynebacterias, Neisserias no patógenas, enterobacterias (la mayoría son pobladores de la piel que recubre esta zona).
- En los cultivos de orina, se deben limpiar con cuidado la zona perineal antes de tomar una muestra.
Flora normal de la vagina
- Al nacer, esta colonizada por Lactobacilos aerobios (produce pH acido), posteriormente el pH acido se convierte en neutro y aparece flora mixta de cocos y bacilos, hasta la pubertad.
- En la pubertad esta colonizada por Lactobacilos aerobios y anaerobios que produce ácidos por su metabolismo de hidratos de carbono => cambio a pH acido (protección a los otros microorganismos potencialmente patógenos.
- En la mujer adulta esta colonizada ademas de los anteriores (Lactobacillus acidophillus - aerobios y anaerobios), estreptococos anaerobios (hemoliticos o no hemoliticos) y otros; el moco cervical contiene lisozima con actividad bactericida.
- En la menopausia la flora vaginal cambia, aparece de nuevo una flora mixta de cocos y bacilos.
- La administración de antibióticos de amplio espectro, puede eliminar las especies protectoras, produciéndose una multiplicación excesiva en la vagina de levaduras (candidas) u otras causantes de vaginitis.
Flora normal de la conjuntiva del ojo
Predomina los difteroides (Corynebacterium xerosis), Staphylococcus epidermidis y estreptococos no hemolíticos; pueden estar presentes otras especies; el control de la flora lo ejercen las lagrimas, por su contenido en lisozima.
Tema 11 - Examen Microscópico (observación de microorganismos vivos)
Nociones de microscopia (repasar apuntes de 1º curso)
Microscopio – instrumento que permite amplificar la imagen de un objeto o de un ser pequeño (micros: pequeño y scopein: ver); inventado 1610 por Galileo, el primer científico italiano observando el exterior de una abeja o Jansen, el holandés.
Fundamento – Si se sitúa entre el ojo y el objeto un sistema óptico capaz de aumentar el angulo visual, se podrá ver el objeto con mayor amplitud y claridad. El sistema de lentes - produce una imagen aumentada de una muestra diminuta. El objetivo - pequeña lente de proyección que aumenta y proyecta la imagen primaria del objeto hacia el extremo superior del tubo del microscopio (imagen aérea). El ocular (lupa) - aumentando la imagen aérea. La imagen final - se forma en la retina del ojo. La imagen virtual (el ojo percibe la imagen final en el plano virtual).
Aumento – es el numero de veces que se ve el tamaño de un objeto por encima de su valor real. En el microscopio óptico compuesto, se calcula multiplicando el aumento individual del objetivo por el aumento individual del ocular. Objetivo - x4, x10, x40, x100. Aumento óptico ocular - x5, x10
Resolución – la capacidad del microscopio para mostrar los detalles más finos de un objeto. Poder de resolución (limite de resolución o distancia resoluble) – la distancia minima entre dos puntos que permite distinguirlos como tales (la capacidad de microscopio para distinguir 2 puntos separados aunque están muy próximos entre si).
Disminuir la distancia resoluble = aumentar el poder de resolución = aumentar la apertura numérica (AN) = disminuir la longitud de onda de la luz empleada = aumentar el ángulo alpha en el espacio objeto = aumentar el índice de refracción (IR) en el espacio objeto (rellenar el espacio existente entre la muestra y el objetivo con una sustancia de mayor índice de refracción, como aceite).
Numero de campo – diámetro de la imagen observada a través del ocular (en mm).
Profundidad de foco – el espesor de la muestra que es posible tener enfocado por completo >< aumento y AN (apertura numérica) de la lente.
El contraste – para mejorarlo, disminuye el cono de iluminación (se controla mediante el diafragma de apertura) procedente del condensador.
Partes de un microscopio óptico compuesto:
Parte mecánica – sistema de soporte o estático (pie, brazo, cabezal); sistema de ajuste (anillo de ajuste de las dioptrías, tornillo de fijación del cabezal, tornillos reguladores de la platina, tornillo de elevación del condensador, tornillos de centrado del condensador, tornillo de seguridad del condensador, control del diafragma de apertura del condensador, anillos de enfoque macro-métrico y micrométrico, control de ajuste de la claridad/ la luz).
Parte óptica – sistema de iluminación (fuente de luz - lampara halogena de intensidad graduable; condensador - dispositivo que contiene una lente que concentra la luz, generada en la lampara, hacia la preparación; diafragma de apertura - el control adecuado del cono de iluminación que atraviesa la muestra y entra en el objetivo = se ajusta AN); lentes (objetivos - generan imagen real, invertida y aumentada del objeto; oculares - captan la imagen formada por el objetivo y la amplian)
Material necesario para la visualización microscópica – portaobjetos esmerilado y biselado, cubreobjetos 22x22, líquido de inmersión (se usa sin cubreobjetos) es imprescindible cuando se observa muestra desecada con objetivo de 100x (tradicionalmente aceite de madera de cedro, actualmente aceites sintético)
Tipos de microscopios:
Microscopio de campo oscuro – si dentro de la muestra hay elementos transparentes, con un indice de refracción diferente al del medio que los circunda, la luz es difractada e incide sobre el objetivo y pueden ser visualizados; permite la observación de seres microscópicos transparentes y no teñidos (Treponema pallidum – preparación en fresco).
Microscopio de fluorescencia – consta de una fuente de luz muy intensa (lámpara de Hg a alta presión), emite una radiación que puede incidir en la muestra desde abajo, tras atravesar un condensador de campo oscuro (iluminación transmitida); se emplea un tipo especial de liquido de inmersión (glicerina); Tipos de fluorescencia: Fluorescencia primaria - fluorescencia natural (auto fluorescencia) - vitamina A-tiamina, vitamina B-riboflavina; Fluorescencia secundaria - colorantes fluorescentes: auramina (demostrar la presencia del bacilo de Koch en esputos), naranja de acridina (detectar Gardnerella vaginalis en los exudados vaginales; Fluorescencia terciaria inmunofluorescencia - fijación del fluorocromo (colorante) como rodamina y ficoeritrina al elemento investigado (a traves de Ac marcado).
Fuente de luz => Filtro primario => Muestra Fluorescente => Filtro secundario => Luz fluorescente
de exitacion (UV) Observador
Microscopios electrónicos de transmisión (TEM) – una gran amplificación y permite la observación de elementos que son demasiado pequeños como para ser vistos en un microscopio óptico, pero no sirve para observar elementos vivos, a causa del vacío que ha de establecerse dentro del tubo y es muy costoso (solo se usa en lab de investigación). El poder de resolucion en microscopio electronico es x1000 > que microscopio óptico; emplean electrones en lugar de unas fotones; microscopio óptico < 200 nm - fotones: 400 - 700 nm longitud de onda.
Microscopio electrónico de barrido (MEB) – no tiene tanto poder de resolución como el de transmisión, pero sin embargo, proporciona una enorme profundidad de campo y genera unas imágenes que producen una gran sensación de tri dimensionalidad. 1973 se comercializo el 3º modelo que une las caracteristicas de los 2 anteriores (la gran resolucion de los TEM y la gran definicion y contraste de los MEB.
Examen en fresco de bacterias vivas (Gota pendiente) - para conocer la movilidad y la disposición bacteriana en una muestra se debe observar los gérmenes vivos a partir de cultivos jovenes (lleva pocas horas), que permiten visualizar mejor su movilidad y su preparación en fresco.
Condiciones que debe cumplir para este fin:
- cantidad de muestra adecuada (ni mucho ni poco)
- la muestra recogida en condiciones de esterilidad
- adecuadamente distribuida en el portaobjetos (amplia y homogénea)
- cantidad de agua o colorante adecuada
- para la fijación por calor => no debe calentarse demasiado (no quemar el dorso de la mano y la gota +/-consumida) => para hacer tincion
- seguir el método o técnica adecuada, se trabaja con limpieza y orden, evitando cualquier contaminación.
Técnicas para observar los microorganismos vivos - examen en fresco, entre portaobjetos y cubreobjetos, sobre gota pendiente en porta excavado (no lo hacemos) y con tinción vital.
Examen en fresco - suspender el microorganismo en agua destilada o SSF colocandolo en un portaobjetos y posteriormente visualizarlo por microscopio su morfología (cocos o bacilos), disposición/agrupación y motilidad; Material => portaobjetos, microscopio, portaobjetos excavado, cubreobjetos, asa de siembra, mechero Bunsen o de alcohol (para flamear el asa de siembra), muestra de microorganismo problema, agua destilada estéril, vaselina (opcional).
Técnica - Método de examen en fresco entre portaobjetos y cubreobjetos:
- preparar portaobjetos y cubreobjetos limpios y desengrasados
- depositar una gota de agua estéril en el portaobjetos (50ul/lambdas)
- con el asa de siembra esterilizada por flameado, tomar un poco de muestra del microorganismo y suspenderla en la gota.
- homogeneizar la muestra, colocar con cuidado sobre la suspensión un cubreobjetos, evitando que se formen burbujas de aire al caer el cubre sobre la suspensión.
- observar al microscopio con objetivo de 40 aumentos.
Método de examen en fresco sobre gota pendiente en porta excavado:
- colocar en el centro de un cubreobjetos una gota de la suspensión microbiana con una asa de siembra estéril.
- colocar vaselina en los bordes del pocillo del porta excavado
- invertir el cubre sobre el porta excavado, colocandolo encima del área cóncava del portaobjetos.
- la vaselina adherirá el cubre al porta formando una cámara evitando su evaporación y corrientes de aire.
- se invertirá la preparación
- observar al microscopio con objetivo de 40 aumentos.
Resultados - es importante no confundirlos con los movimientos brownianos que se producen cuando se desplaza el medio liquido y hace que todos las bacterias siga dicha corriente en dicha dirección; el sellado con vaselina evita este problema.
Coloración vital - es una técnica intermedia entre los exámenes en fresco y las técnicas de tinción después de fijación previa???; consiste en teñir las muestras bacterianas con colorantes muy diluidos, permite al microorganismo acumular parcialmente dichos colorantes; la dilución debe ser muy altas para que no resulten toxicas para las bacterias, evitando la muerte de tales gérmenes; material => microscopio, asa de siembra estéril, portaobjetos, cubreobjetos, mechero, papel de filtro, una suspensión de muestra problema,
aceite de inmersión, altas diluciones de colorantes para disminuir su toxicidad (rojo neutro en solución acuosa al 1:1.000 o 10 lambas : 10 ml y azul de metileno en solución acuosa al 1:1.000 o 1:500).
Técnica (se puede hacer igual como en fresco) - colocar sobre el portaobjetos limpio y desengrasado una gota de suspensión muestra junto con otra gota del colorante diluido utilizado; mezclar bien ambas gotas con el asa de siembra y colocar el cubre objetos con cuidado para evitar que se formen burbujas de aire; observar al microscopio con objetivo de inmersión; resultados => los microorganismos se visualizaran vivos y ligeramente coloreados de rojo, en el caso de haber utilizado como colorante el rojo neutro o de color azul si se utiliza el azul de metileno.
Tema 12 - Las tinciones en bacteriología
La morfología bacteriana (es incolora) puede ser estudiada por visualización de los microorganismos => vivos sin teñir (observar su posible movilidad) y teñidos mediante colorantes con una concentración que matan la bacteria y no permiten observar su movilidad, pero mejora notablemente la visualización de su morfología y estructuras.
Ventajas de las técnicas de tinción:
- observar mas adecuadamente su morfología y permite diferenciar entre los distintos tipos
- dar información complementaria de sus estructuras internas y/o externas que no se observa en fresco.
- al conocer sus características tintoriales, nos orienta hacia un grupo u otro en la clasificación bacteriana.
Factores que afectan a toda técnica de tinción:
- pureza del colorante (a + impurezas => + error y - calidad en la tinción).
- concentración del colorante (valores ideales oscilan entre 0,2 y 2%)
- pH del colorante (en general son neutro +/- 7 o entre 6,8-7,4)
- conservación del colorante
- elaboración (no lo hacemos /vienen preparadas)
- técnica empleada (material limpios y seguir los pasos de la técnica)
- temperatura (en general la ambiental)
- cantidad de muestra (representativa y homogénea)
- realizar correctamente el frotis (fijarlo bien, en general por calor => coagula las proteinas bacterianas, para que no se arrastre con el colorante mordientes y decolorantes)
- soluciones mordientes (ayudar a fijar el colorante a las estructuras microbianas, p.ej. lugol en la Gram)
- tiempos de tinción (según el colorante que usemos)
Principales técnicas de coloración - clasificación de colorantes => [1] según su origen (naturales y artificiales) [2] según su comportamiento químico (ácidos, básicos y neutros).
Colorantes naturales - extraído de plantas como la hematoxilina (del tronco de una planta que por oxidación produce hemateína; el azul de índigo (de una leguminosa); extraído de animales como el carmin (de una cochinilla)
Colorantes artificiales - preparados artificiales y obtenidos de alquitrán de hulla (colorantes anilina ácidos, básicos y neutros en forma de sales) p.ej. cristal violeta, violeta de genciana, fucsina básica, acido pícrico, azul de metileno, etc.
Colorantes según su comportamiento químico - se unirá de forma mas estable a la estructura que tiñe, dependiendo de su estructura físico-química; constituido por un anillo bencénico que unen distintos radicales => radical cromóforo; a+ numero de radicales => +poder colorante de la solución;
[1] colorantes ácidos o aniónicos: la carga del radical colorante es (-) => colorantes citoplasmáticos que son básicos (los componentes citoplasmáticos captan muy bien los colorantes ácidos) => las eosinas, las auraminas.
[2] colorantes básicos o catiónicos: la carga del ion cromóforo es (+) => colorantes de la zona nuclear que son ácidas o ligeramente ácidas => fucsina básica, cristal violeta o violeta de genciana, azul de toloudina, azul de metileno o las tioninas.
[3] colorantes neutros: es una sal compuesta de un colorante acido y un colorante básico => el eosina azul de metileno; es hidro-solubles (posee las propiedades de colorantes ácidos y básicos).
[4] colorantes indiferentes: insolubles en agua y solubles en alcohol, no predomina ni la carga+ ni (-), pero tampoco es de carácter neutro => colorantes de los lípidos como Sudan III, Negro Sudan, etc.
En bacteriología es frecuente la utilización de => fucsina fenicada, violeta de genciana, azul de metileno (son colorantes básicos) y de añadir un mordiente que ayude a fijar dicho colorante; los colorantes ácidos se utiliza como un contraste y los colorante neutros e indiferente como coloraciones particulares; el proceso de tinción => reacción de intercambio de iones entre colorante y sitios activos de la superficie o del interior de la célula (los iones teñidos/colorantes reemplazan iones de los componentes celulares) y esto permite contrastar mucho mas el germen con respecto al medio que le rodea.
Preparación de un frotis - realizar una extensión y fijar la muestra problema para posterior coloración y visualización al microscopio; poner en un portaobjetos, a traves de un asa de siembra una cantidad de microorganismo problema suspendido en medio liquido estéril, extendiéndolo adecuadamente hasta formar una fina película homogénea que posteriormente se fijara generalmente con calor cuando sea requerido, según el método de tinción que se utilizara posteriormente; material => portaobjetos, asa de siembra o platino, agua estéril, muestra problema; técnica => pequeña cantidad de la muestra liquida se deposita y se extiende homogéneamente en el centro del portaobjetos con el asa de siembra para tener una capa fina (según la viscosidad, se puede diluir con unas gotas de agua estéril); si la muestra es solida (una colonia), se deposita primero una gota de agua estéril y se añade con el asa de siembra una pequeña cantidad de la colonia, se extiende homogéneamente; dejar secar al aire; se fija mediante el flameado (en algunos casos se podrá hacer con alcohol) para coagular las proteínas y los gérmenes quedan adheridos al portaobjetos.
Técnica de tinción - los pasos:
-realizar un frotis y fijación por calor (generalmente), con la intensidad de calor adecuada que soporte el dorso de la mano.
-coloración segun el tipo de tincion (generalmente con colorantes basicos que tiñen estructura acida)
-decoloración que permite diferenciar distintos grupos bacterianos (genero Micobacterium son resistentes a la decoloracion ácida/BAAR); Gram- decoloradas con el alcohol 96º/alcohol acetonas, alcohol acido, acidoclorhidrico => micobacterias
-lavado siempre entre paso y paso con agua destilada para evitar interferencias entre un producto y otro.
-coloración de contraste (generalmente ácido), se aplican al final para las estructuras decoloradas con el decolorante, p.ej. safranina.
-observación al microscopio
Tipos de tinciones bacterianas:
(1) Tinción simple => fijación previa, se utiliza 1 solo colorante, permite la visualización de la morfología y la agrupación bacteriana; clasificación => tinciones simples con colorantes básicos, ácidos y neutros; se basa en => la afinidad de los colorantes que suelen ser de tipo básico (azul de metileno, violeta de genciana, azul de toloudina => 1-2 minutos, dan color azul a las celulas o fucsina fenicada diluida => da color rojo a los componentes celulares.
(2) Tinción negativa => es un tinción simple (1 solo colorante => tinta china o solución acuosa de nigrosina al 1%) con diferencias que no necesita fijación previa (no mata las bacterias), permite observar características estructurales de la bacteria ademas de su morfología sobre un fondo oscuro, como es la presencia de capsulas p.ej. los neumococos; se basa en => colorante acido cargado negativamente, los microorganismos no se tiñen (se quedan claros y brillantes sobre un fondo teñido oscuro); para obtener una capa fina (para dejar pasar el paso de luz del microscopio y evitar a formarse grietas al secarse el colorante) se puede hacer una extensión con el borde de otro portaobjetos; resultado => se observan las capsulas (si las tienen) en forma de un halo mas claro que rodea el cuerpo de la bacteria.
(3) Tinciones diferenciales => fijación previa (en general por calor), se utiliza 2 colorantes (el ultimo es de contraste), permite visualizar su morfología y características estructurales (composicion de la pared bacteriana, su resistencia a la decoloración ácida (t.Gram y t.ZhielNeelsen).
(4) Tinciones estructurales => fijación previa (en general por calor), se utiliza al menos 2 colorantes, nos permite observar su morfología y características estructurales como esporas, flagelos, cilios, capsulas, corpúsculos metacromáticos (utiliza 1 solo colorante???).
Tinción diferenciales de Gram => descubierto en 1883 por Cristian Gram, cuando trabajaba con material de biopsias y utilizada a partir de 1886 como tinción diferencial; es mas empleado en bacteriología, para clasificar 2 grandes grupos (Gram+ y Gram-); distinto comportamiento debido a la distinta composicion de la pared de las celulas bacterianas; se emplea como el primer colorante básico (cristal violeta o violeta de genciana) que teñirá de color azul violeta todas las bacterias, posteriormente un mordiente el lugol que aumenta la afinidad del primer colorante a las celulas (lo fijara), finalmente un agente decolorante que decolora solamente un tipo de bacterias (Gram-) que serán teñidas con el colorante de contraste o segundo colorante (la safranina) de color rosa-rojo; si se quedan con el color azul violeta serán Gram+.
Material de la tinción Gram => portaobjetos, pinzas de madera, asa de siembra, mechero de Bunsen, pipeta Pasteur, asa de tinción (punte), frasco lavador, muestra problema, aceite de inmersión, colorantes para la tinción de Gram.
Técnica:
- realizar la preparación de frotis => extender 1 gota de agua destilada estéril + una colonia de la bacteria problema por la superficie de la portaobjeto
- fijación por el calor, pero no quemar las bacterias
- aplicar el colorante cristal violeta durante 1,5 minuto o violeta de genciana durante 2 minutos
- lavar abundantemente con agua para eliminar el exceso de colorante
- añadir un mordiente, el lugol durante 1 minuto (solución iodoiodura de potasio con OH de 96º o con acetona a 5/1 o con OH 50%)
- vuelve a lavar con agua el exceso
- decolorar con solución decolorante (alcohol 90º)
- lavar abundantemente con agua
- cubrir el portaobjetos con la safranina durante 1 minuto
- lavar con agua para arrastrar los restos de colorantes y dejar secar al aire
- observar con objetivo de inmersión (100x).
Tinción de gérmenes del acido alcohol resistentes (BAAR + criptococo)
A. Tinción de Ziehl-Neelsen
Este método fue desarrollado por Ehrlich en 1882 trabajando con bacilo de Koch y mejorado posteriormente por Ziehl-Neelsen; objetivo => diferenciar del resto, las bacterias tipos BAAR (bacterias acido alcohol resistentes, p.ej. Mycobacterium), debido a su gran cantidad de componentes micólicos (lipoideos y cereos/cera) que forman parte de la pared de este tipo de bacteria (los colorantes convencionales no penetran en el interior de estas bacterias); De ahí se necesitan colorantes altamente concentrados y la presencia de calor que facilite su penetración al interior de dichas bacterias; una vez teñidas, su decoloración posterior no es posible (resiste incluso a decoloraciones ácidas); dicha tinción se emplea principalmente para el diagnostico y estudio de enfermedades como tuberculosis y la lepra.
Material => es el mismo que esta descrito en la tinción simple, pero en cuanto los reactivos: 1º colorante - solución fenicada de fucsina básica (carbo fucsina), 2º colorante de contraste - solución hidro-alcohólica de azul de metileno fenicado, 3º decolorante - alcohol acido al 3% (97% alcohol).
Técnica => preparación de frotis y fijación calor; cubrir el frotis con fucsina fenicada básica 5 minutos aplicando en este tiempo calor, hasta la emisión de vapores, evitando que se caliente demasiado o que se seque el colorante; lavar abundantemente con agua destilada hasta arrastrar el colorante; decolorar con alcohol acido para arrastrar restos del colorante (10-30 segundos); lavar abundantemente con agua destilada; cubrir el frotis con colorante de contraste /azul de metileno fenicado 30 segundos sin necesidad de calentar, para teñir aquellas bacterias que no son resistentes a la decoloración (se han decolorado) y resaltar el color rojo de los BAAR+; lavar, secar, rotular y observar con objetivo de inmersión.
Resultados => con el 1º colorante, BAAR- y BAAR+ (ambas) se tiñen de rojo; con el decolorante, BAAR- se decoloran y BAAR+ no se decoloran; con el 2º colorante (de contraste), BAAR- setiñen de azul y BAAR+ permanecen de color rojo/ acido alcohol resistencia+ (bacilos Mycobacterium y algunos Nocardia)
B. Método de Kin Youw modificado (coloración en frió) Reactivos => 1º colorante: fucsina fenicada (con fenol) de KinYouw, decoloración a 3%, 2º colorante: azul de metileno fenicado (con fenol); técnica => idéntica, salvo para la fucsina de KY, dejamos actuar 5 minutos sin calentamiento; existen otras técnicas de tinción de los BAAR => tinción de auramina o de rodamina que usan microscopio de fluorescencia.
Tinción de espiroquetas (para las espiroquetas)
Tinción estructurales => tinción de esporas, de flagelos, de cilios (similar a flagelos, pero corto y se extiende por todo el cuerpo, como pilis), de corpúsculos metacromáticos y de capsulas.
Tinción especiales => tinción de auramina y de naranjo de acridina.
Tema 13 - Pruebas bioquímicas para la detección del metabolismo hidrocarbonado de las bacterias.
Metabolismo - conjunto de reacciones químicas que tiene lugar en las celulas vivas; necesitan energía que se obtiene por oxidación (perdida de electrones) de sustancias introducidas en forma de alimentos; la gran mayoría de las bacterias (heterótrofas) se nutren de sustancias orgánicas que proceden de otros seres vivos y otras (autótrofas - cianobacterias) se nutren de sustancias orgánicas que sintetizan ellas mismas a partir de sustancias inorgánicas; 3 etapas en metabolismo =>
1ª-catabolismo/hidrólisis/degradación de sustancias nutritivas => compuestos mas sencillos + energía en forma de ATP (adenosin trifosfato)
2ª-anfibolismo/metabolismo intermedio del producto del catabolismo => compuestos de bajo peso molecular
3ª-anabolismo/metabolismo biosintético de sustancias simples => biosíntesis de macromoléculas /moleculas complejas + gasto de energía.
Enzima - catalizadores biológicos (proteínas); cada enzima afecta solo a un sustrato especifico.
Reducción => captan electro nes.
Catabolismo de hidratos de carbono - oxidación de azucares para obtener la energía es muy importante, aunque también se catabolizan lípidos y proteínas; la 1ª etapa de la degradación de la glucosa => oxidación de esta para formar acido pirúvico (glucólisis); 2 procesos => la respiración (necesita O2) o la fermentación (no necesita O2); la glucólisis (no precisa O2) se produce en 3 vías, en función de la dotación enzimática.
1º vía glucolítico/ ruta de Embden-Meyerhof Parna (EMP) fue descubierto por Pasteur => se obtiene 2 moleculas de ATP mediante fosforilación por cada molécula de glucosa que se oxida; este proceso se puede realizar en presencia o no de O2; a partir de la formación de acido pirúvico, las bacterias que usan esta vía, normalmente utilizan la vía fermentativa para acabar transformando este acido pirúvico en ácidos mixtos; degradación/ hidrólisis de glucosa (6C) => acido pirúvico + 2 ATP (fosforilación) => ácidos mixtos (fermentacion); son 9-10 reacciones químicas con un enzima diferente en cada una; utilizados por las bacterias fermentadoras que poseen deshidrogenasas (Clostridium, Enterobacter, Salmonella)
2º vía de las pentosas fosfato /vía fosfoglucónica (vía HMP) - es una ruta mixta y vía alternativa; este ciclo rompe los azucares de 5 carbonos /pentosas y también glucosa, mediante sucesivas reacciones y produce => pentosas intermedias (precursores de síntesis de ácidos nucleicos y ciertos aminoácidos) de gran utilidad para las celulas; ademas de la glucólisis via EMP, muchas bacterias utilizan HMP como una vía alternativa para la oxidación de la glucosa => produce acido láctico o acido mixto + 1ATP (p.ej. Enterobacterias/ E.coli); esta vía es un híbrido de la vía ED y la EMP, ya que en las primeras etapas, la oxidación de la glucosa es similar a la via ED y en las etapas posteriores es similar a la vía EMP, es decir: proporcionan a las bacterias no oxidativas un medio de oxidar la glucosa a acido pirúvico puro, porque no tienen las enzimas necesarios para comenzar la vía EMP, apareciendo en los sistemas analíticos como fermentadoras.
3º vía de Entner-Doudoroff (vía ED/ vía aerobia => requiere O2) - es otra vía por la cual la glucosa se oxida a acido pirúvico; por cada molécula de glucosa se producen 1 molécula de ATP para ser utilizada por la célula en reacciones bio-sintéticas; esta vía requiere enzimas específicos y solo los microorganismos que las poseen pueden utilizarla sin seguir la vía de las pentosas fosfato ni la glucólisis; los microorganismos que la utilizan son Pseudomonas y Neisseria (aerobio estricto), por carecer de las deshidrogenasas necesarias para oxidar el acido pirúvico al acido láctico u otros ácidos; los hidrogeniones se transfieren al ciclo de Krebs y se acabaran obteniendo agua; oxidación de glucosa => acido pirúvico + 1ATP (no producen acido láctico ni acido mixto)
Respiración - es un proceso fosforilación oxidativa de generación de ATP y se caracteriza por el aceptor final de electrones generalmente es una molécula inorgánica (O2); la glucosa se degrada => acido pirúvico se sigue oxidando por la vía de la respiración o la fermentación (en función del sistema enzimático que tienen) => ATP + CO2 + H2O; durante la respiración, cualquier molécula orgánica puede ser degradada /oxidada con un mayor rendimiento que en la fermentación.
Respiración aeróbica - cuando el aceptor final de Hidrógenos (electrones) es el O2; en la respiración, el acido pirúvico producido por la glucólisis se escinde en 2 partes: una parte se unen con CoA => forman acetil CoA que entra en el ciclo de Krebs donde se liberan electrones y protones (H+); la otra parte para biosíntesis???
Cadena de transporte de electrones (se encuentra en la membrana citoplasmática de las celulas procarióticas y en las membranas internas de las mitocondrias en las celulas eucarióticas) - los electrones se mueven desde los coenzimas reducidos hasta una molécula inorgánica como O2 en la respiración aeróbica o hasta una molécula inorgánica diferente del oxigeno NO3- ion nitrato, SO2-4 ion sulfato, etc.; las moleculas transportadoras de electrones son 3 tipos => [1] flavoproteínas - realizan reacciones de oxidación reducción, [2] citocromos - proteínas con un grupo prostéticos (Fe) en forma oxidada, [3] ubiquinonas o coenzima Q - transportadores no proteicos de bajo peso molecular.
Respiración anaeróbica - cuando el aceptor final de electrones (H-) es una sustancia inorgánica distinta del O2, tal como iones nitratos NO-3, sulfatos SO2-4, carbonatos CO2-3. (Pseudomonas y Bacillus)
Fermentación - proceso que se inicia a partir de acido pirúvico formado en la glucólisis de EMP /HMP, en cual el aceptor final de los electrones es un compuesto orgánico y no requiere O2; características principales => (1) no precisa O2, pero se puede ocurrir en su presencia, (2) no necesita el ciclo de Krebs ni cadena transportadora de electrones, (3) utiliza 1 molécula orgánica como aceptor final de electrones, (4) libera energía a partir de azucares y otras moleculas orgánicas (aminoácidos, ácidos orgánicos, purinas, pirimidinas), (5) libera solamente 2 moleculas de ATP por cada molécula del sustrato inicial, (6) los productos finales pueden ser acido láctico, etanol y CO2, acido propiónico, acido acético, CO2 y agua, acido butírico, etc. (compuesto orgánico); cuando el aceptor final de electrones es el lactato, se producirá acido láctico y en general cuando el aceptor final sean otras sales orgánicas, se formaran ácidos mixtos p.ej. acido succínico, que son responsables de la caída de pH en las pruebas empleadas, para la identificación bacteriana; ademas, las bacterias que tienen la dotación enzimática apropiada, pueden seguir degradando estos ácidos mixtos hasta CO2 y otros compuestos orgánicos; es útil el análisis de los productos finales para identificar así los microorganismos; la mayor parte de la energía producida en la fermentación queda almacenada en los productos finales; las fermentadoras => Streptococcus, Lactobacillus, Clostridium, Escherichia, Salmonella, Enterobacter.
Prueba de la B-D Galactosidasa (ONPG) - se basa en la capacidad que tienen los microorganismos de fermentar lactosa, mediante 2 enzimas => Lactosa Permeasa (esta en la membrana celular y es capaz de transportar la lactosa a traves de ella) y B-D-Galactosidasa (esta en el interior de la célula y es capaz de desdobla la lactosa en glucosa y galactosa).
Clasificación de los microorganismos segun su capacidad de fermentar o no la lactosa:
- fermentadores activos de lactosa en 24 horas (poseen ambos enzimas)
- no fermentadores de lactosa (carecen de ambos enzimas, no degradan la lactosa, no penetra en la célula)
- fermentadores tardíos de lactosa (poseen el enzima B-D-Galactosidasa, permeabilizar la lactosa ligeramente cuando la concentración es alta en 2-15 días).
La aplicación fundamental es la diferenciación de Enterobacteriaceae => Escherichia (+) es fermentadora activo, Proteus (-) es no fermentadora y Klebsiella (+) es una fermentadora tardía de lactosa, es decir lactosa (-) y ONPG (+); para detectar la enzima B-D-Galactosidasa => se utiliza un compuesto similar a la lactosa (orto-nitrofenol): al liberarse al medio alcalino por la acción de BDG produce un color amarillo.
Material => 1 tubo de ensayos estériles, baño maría o estufa a 37ºC, asa de siembra, solución fisiológica esteril, discos de ONPG, microorganismo problema
Técnica => una suspensión densa (con muchas colonias) de un cultivo puro en 0,5 ml de suero fisiologico estéril se añade un disco de ONPG y mezclar durante unos segundos, incubar a 37ºC durante 30-60 minutos (en general se vira antes de 30 minutos)
Resultados => en ONPG+ se produce una coloración amarillo y en ONPG- no se produce color (incoloro).
Tema 14 - Pruebas bioquímicas para la detección del metabolismo proteico de las bacterias
Principal productor de energía => catabolismo de la glucosa y las oxidaciones de proteinas y lípidos (estan relacionados entre si); la hidrólisis de proteínas/ proteína+agua (mediante enzimas proteolíticos extracelulares, secretadas por ciertas bacterias que sirve para su tipificación/tipación) => polipéptidos y aminoácidos; las pruebas bioquímicas investigan fundamentalmente la capacidad de un microorganismo de producir la hidrólisis de la gelatina; catabolismo de proteínas/ proteólisis se realiza mediante proteinasas/proteasas y peptidasas (desaminación) para obtener => ion amonio NH4+ (+) acido orgánico; acido orgánico entrar al ciclo de Krebs y ion amonio NH4+ es secretado de la célula.
Producción de acido sulfhídrico - técnica con indicador incorporado al tubo/a la placa => algunos microorganismos actúan metabolizando proteínas con aminoácidos azufrados (cistina, cisteina) y liberan azufre en forma de gas acido sulfhídrico SH2; el gas es detectado a traves del medio que contiene fuente de hidrógeno (azucar) fuente de azufre (tiosulfato sodio, cistina, cisteina) y un indicador de pH (sales de hierro /citrato férrico amoniacal) => un precipitado negro); se observara la liberación del gas SH2 por algunos microorganismo que poseen enzimas desulfurasas (activada por la fermentación de la glucosa => acidifica/produce ácidos/baja el pH) que actúan sobre los aminoácidos azufrados; la temperatura de incubación (estufa) tiene que oscilar entre 35-36ºC (superior a 37º se inhibiría la producción de SH2).
Material => tubo de cultivo (KIA/kliger iron agar y TSI/triple sugar iron), agujas y asas de siembra, estufa de cultivo, muestras de problema; si se realiza en placa de cultivo (Hektoen y SS);
Técnica => a partir de un cultivo puro y reciente de microorganismo problema se tomara una muestra con una aguja; sembrar en picadura (tubo de KIA o TSI) o con agotamiento en cuadrante (Hektoen o SS); incubar durante 18-24 horas; si la técnica se realiza con Brucella (microaerofila), se debe incubar con una atmósfera de CO2.
Resultados => SH2 positivo (Salmonela y Proteus) se observa a lo largo de la linea de inoculación ennegrecimiento del medio; SH2 negativo (Brucella y Shigella) no se ennegrece el medio.
Bacteria con enzimas desulfurasas (activada por la fermentación de azucar) + indicador de pH/sales de Fe + fuente de S + (H+) => H2S gas + indicador pH => precipitado negro insoluble/ puntos negros (FeS)
Prueba de las descarboxilasas - enzimas que actúan sobre el grupo carbóxilo de los aminoácidos Lisina, Ornitina, Arginina para formar => aminas (alcalinas) y se desprende CO2 (el proceso se realiza en anaerobiosis) => se realiza mediante el sistema multiprueba (API - buscar el código en el libro); estas pruebas se aplican para la identificación de Enterobacteriaceas; se investiga la alcalinización del medio inicialmente de color purpura, se observara el viraje del color del indicador del pH; la presencia del enzima investigado supondrá la alcalinización del medio (sigue el mismo color como el inicio); cada pocillo contiene indicador de pH y amino acido correspondiente al enzima a investigar; cada descarboxilasa actúa sobre un aminoácido especifico; en cada reacción se desprende CO2 y se alcaliniza el medio:
- L-lisina + LDC/lisina descarboxilasa => Cadaverina + CO2
- L-ornitina + ODC/ornitina descarboxilasa => Putrescina + CO2
- L-arginina + ADH/arginina deshidrolasa => L-citrulina + NH3 (descarboxilación) => Putrescina +CO2
Material => pruebas de API, pipeta Pasteur.
Reactivos => caldo de Moller para descarboxilasas (lleva pequeña cantidad en su composicion una pequeña cantidad de glucosa, peptonas y los indicadores rojo cresol y purpura de bromo cresol, pH6); aminoácidos ensayados en forma L, muestra de problema y papel parafina.
Técnica => se añade una gota del inoculo (suspensión microbiana) en cada pocillo de la prueba de API; se incuba a 35ºC durante 18-24 horas.
Resultados => durante las primeras horas de incubación, el caldo vira a amarillo, por la fermentación de glucosa que lleva el medio; pero si el aminoácido es descarboxilado, el pH vuelve a subir, ya que se forma aminas alcalinas que es de color purpura (descarboxilasa+); si se queda amarillo sera descarboxilasa-; gérmenes con descarboxilasa+ (Escherichia no es 100% descarboxilasa+ de Lisina, Arginina y Ornitina):
- Lisina => Klebsiella, Serratia, Salmonella
- Ornitina => Serratia, Proteus, Salmonella
- Arginina => Salmonella, Pseudomonas
Tema 15 - Pruebas bioquímicas para la detección de la actividad enzimática de las bacterias
Pruebas oxidasa - esta denominación se le da de forma genérica al enzima citocromo oxidasa que participa en la transferencia de electrones en la cadena respiratoria hacia el oxigeno; oxidasa => enzima que cataliza la transferencia de electrones del sustrato al oxigeno; los aerobios o anaerobios facultativos obtienen su energía por la respiración y la almacenan en forma de ATP, el oxigeno es reducido a partir de un sustrato orgánico que procede de la nutrición con la intervención de un sistema de transporte de electrones denominado cadena respiratoria, produciéndose agua o peróxido de hidrógeno según la especie microbiana; los citocromos son hemo-proteínas que contiene Fe y actúan como ultimo eslabón de la
cadena respiratoria aerobio, transferiéndo H+ al O2 con formación de H2O; este sistema se encuentra en los organismos aerobios y anaerobios facultativos, carenciandolo de ello los anaerobios estrictos; se observara el cambio de color de un indicador de pH incoloro cuando esta reducido (p-fenilendiamina=> formar indofenol de color violeta oscuro) y coloreado cuando se oxida;
Aplicación => detectar en el microorganismo estudiado el enzima citocromo oxidasa; diferenciar entre Enterobacteriaceas (oxi-) de Pseudomonadacea (oxid+); diferencia entre géneros Moraxella (oxi+), Neisseria (oxi+) de Acinetobacter (oxi-).
Material => placa sembrada con microorganismo problema, asa de plástico, papel de filtro, porta, reactivo oxidasa de Kovacs.
Técnica => mezclar una pequeña muestra pura con el reactivo en el papel de filtro que se sitúa por encima de una porta, esperar 30-60 segundos y se observar el posible cambio de color; otra manera: se añade directamente el reactivo oxidasa de Kovacs sobre las colonias de la placa Petri con agar sangre y también en otro medio; si son oxidasa positivo toman un color marrón y en seguida pasan a negro parduzco.
Resultados => oxidasa+ aparece un color purpureo en el papel, si se desarrolla el color a los 10-60" se considera oxidasa retardado positivo, después de 60" es negativo; oxidasa- no se produce color.
Pruebas de catalasa
La catalasa es una enzima que se encuentra en la mayoría de los microorganismos aerobios y anaerobios facultativos que contienen citocromo; es un enzima fundamental que actúa sobre el peróxido de hidrógeno /H2O2 (es un producto final de la degradación aerobica oxidativa de los hidratos de carbono); si se acumula H2O2, estos gérmenes morirían; fundamento: si el microorganismo tiene el enzima catalasa y se pone en contacto con H2O2 => se descompone en H2O + O2; aplicación => diferenciación de Streptococcus (-) de Staphylococcus (+) y Micrococcus (+);
Material => portaobjeto, pipeta Pasteur, asas de siembra de plástico (las de platino catalizará la reacción)
Reactivo => H2O2/ agua oxigenada, microorganismo de problema
Técnica => se coloca una gota de H2O2 (agua oxigenada) en un porta objeto, simultáneamente, con una asa se añade una colonia del cultivo del microorganismo de 12-24 horas, homogeneizar y observar.
Resultados => catalasa+ forma burbujas de O2 inmediatamente; catalasa- no aparecen burbujas; se podrán observar falsos positivos si se utilizaran medios de cultivo agar sangre o otros que lleven hematíes (los hematíes contiene catalasa).
Pruebas de Nitrato reductasa o Nitratasa (se realiza con multiprueba de API)
La nitratasa (nitrato reductasa) es el enzima que cataliza el proceso en cual el nitratos son reducidos a nitritos (presentes en algunos microorganismos anaerobios o anaerobios facultativos que utilizan nitrógeno como ultimo aceptor de electrones en el proceso metabólico/ respiración anaeróbica); depende de la especie bacteriana se trate, se pueden producir diversos productos finales; reacción: nitrato/NO-3 + nitratasa => nitrito/NO-2 => N2 (nitrógeno molecular/ gas nitrógeno) o otros => amoniaco / oxido nítrico / oxido nitroso / hidroxil amina; la prueba detecta los productos finales liberados al medio mediante un reactivo colorimétrico API; aplicación => diferenciación de especies de Haemophilus y Neisserias; cuando no se forma color (rojo) al añadir los reactivos, puede significar => [1] no se ha reducido el nitrato, se comprueba añadiendo polvo de zinc que actúa como reductor y si hay un cambio al rojo, es nitratasa (-) y si no hay cambio de color, sera nitratasa (+); [2] la reducción de nitratos ha sido llevada hasta la formación de N2, se observa con la aparición de grietas o burbujas; [3] la reducción de nitratos ha formado otros productos nitrogenados (oxido nítrico, amoniaco, hidroxil-amina, etc.);
Material => multiprueba de API; reactivo => Nit A y Nit B, Zinc en polvo, microorganismo; el medio no debe contener azufre ya que si el microorganismo es productor de H2S (acido sulfhídrico) este impide la formación de color; técnica => hacemos un inoculo a partir de un cultivo puro reciente de 12-24 horas, inoculamos el medio; incubar a 37ºC durante 12-24 horas, agregar 1 gota de Nit A y 1 gota de Nit B, observar si hay un cambio o no antes de 30 segundos (se interpreta rápido, ya que el color puede desaparecer); si no se forma color, se añade al tubo un poco de polvo de Zinc; resultados => hay 2 posibilidades de que sean Nitratasa+ (Haemophilus y Branhamella Catarallis): [1] cuando aparece color rojo o rosado fuerte al añadir el reactivo A y B que indica la reducción de nitratos a nitritos; [2] al añadir polvo de zink no se desarrolla color indica formación de otros productos nitrogenados; Nitratasa- => cuando se forma color rojo o rosado al añadir polvo de zinc en menos de 30 segundos.
Prueba de Ureasa (se hace en manual y con el sistema API) - detecta la presencia de la ureasa en los microorganismos cuando se observa la alcalinización de un medio liquido; la ureasa cataliza la hidrólisis de la urea => carbonato amónico, que sube el pH, con lo que el medio se alcaliniza; aplicación => diferenciar Proteus (+) de otras Enterobacteriaceas / E.coli (-) o positivo retardado (+) como Klebsiella;
Material => tubos de cultivo, asas, pipeta Pasteur, estufa de cultivo o baño maría.
Reactivo => caldo urea de Stuart/ urea-indol (de color ámbar) y microorganismo de problema
Técnica => con el asa estéril se toma una muestra de cultivo puro reciente 18-24 horas; inoculamos el microorganismo en un tubo con caldo urea de Stuart; incubar 37ºC; la reacción se produce entre 1-4 horas
Resultados => en ureasa (+) el caldo de color ámbar vira a rosa fuerte durante el tiempo de reacción (1-4 horas); en ureasa (-) no vira el indicador; algunas cepas de Klebsiella, Enterobacter, Brucella, requieren 6 días de incubación.
Prueba de Coagulasa (se hace con el kit comercial que contiene Acs anti coagulasa) - observar la coagulacion del plasma en forma de grumos o precipitación al ponerse en contacto el microorganismo con el reactivo (si se utiliza el plasma en la prueba); la coagulasa es un enzima producido por microorganismos capaz de coagular en plasma; aplicación => diferenciar Staphylococcus aureus (coco Gram+, catalasa+, beta hemolítico + y coagulasa+) de otro Staphylococcus; esta prueba solo se hace si el germen es coco Gram+, catalasa+, beta hemolítico +; técnica => (usando el kit comercial /prueba de látex) seguir la instrucción de la casa comercial que hacen el reactivo; resultados => coagulasa+ se observa en forma de grumos (si se utiliza un plasma como reactivo => se observara la formación de un hilo de fibrina en la reacción) y en coagulasa- no se forma grumos.
Prueba de Triptófano Desaminasa (TDA) - se basa en la capacidad que tienen algunas bacterias de desaminar el triptófano por la acción de TDA, produciendo => acido indol pirúvico que reacciona con citrato férrico amoniacal y el cloruro férrico que lleva el medio produciendo un color marrón (determina la presencia de la enzima TDA); técnica => en un medio liquido de TDA (color ámbar); se puede utilizar el reactivo urea-indol; añadimos 1 sola colonia de un cultivo puro y 1 gota de reactivo TDA del API, incubar a 37ºC entre 18-24 horas, y leer; resultado => el color marrón/café indica la presencia de TDA+ y sera negativo si no hay cambio de color; los géneros que tienen TDA+ => Proteus, Providencia y Morganella.
Tema 16 - Pruebas bioquímicas simultaneas (macro-técnicas, micro-técnicas, sistemas rápidos, otros métodos)
Macrotécnicas - sistemas multiprueba que permiten realizar varias pruebas bioquimicas simultáneamente, facilitando notablemente la identificación del microorganismos:
- Kliger Iron Agar (KIA)
- Triple Sugar Iron (TSI)
- Agar Sulfuro Indol Motilidad (ASIM) Motility Indol Agar (MIA)
- IMVIC
- Lisina Iron Agar (LIA)
- Motilidad Indol Ornitina (MIO)
KIA (Kligler Iron Agar) - se pueden realizar 3 pruebas a la vez:
- utilización de azucares (fermentacion glucosa 0,1% y lactosa 1%)
- producción de gas (CO2)
- producción de acido sulfhídrico (SH2)
Por fermentación de azúcares, se producen ácidos, que se detectan por medio del indicador rojo de fenol, el cual vira al color amarillo en medio ácido. El tiosulfato de sodio se reduce a sulfuro de hidrógeno el que reacciona luego con una sal de hierro proporcionando el típico sulfuro de hierro de color negro.
Fundamento => cuando el microorganismo fermenta los azucares, se acidifica el medio porque se forman ácidos orgánicos; si el medio no tienen azucares como fuente de hidratos de carbono, utilizara proteínas que alcalinizan el medio por la formación de aminas; las proteínas en condiciones de aerobiosis (en el pico) se metabolizan mejor por la vía de descarboxilación oxidativa de los aminoácidos que en anaerobiosis (en el fondo); la glucosa se metaboliza mejor que lactosa (la molécula es mas pequeña/sencilla); para metabolizar la lactosa, el microorganismo debe tener B-D galactosidasa y lactosa permeasa.
Material => tubos de cultivo, asa y aguja de siembra, estufa de cultivo
Reactivo => tubo con agar KIA en pico de flauta (color rojo anaranjado), microorganismo
Técnica => es importante tener un tubo de control; se recoge una colonia puro y joven con un aguja; inocular por picadura y estría un tubo de cultivo con medio KIA en pico de flauta; incubar 18-24 horas a 37ºC; la reacción se ha de observar justo después de terminar el periodo de incubación (suficiente tiempo para la fermentación del azucar); si se lee después de 24 horas, se puede dar un falso alcalino, porque el germen habría utilizado la peptona y el medio se alcaliniza; el pH esta ajustado a 7,4 (neutro) e indicador rojo fenol a 6,8 (cualquier cambio de pH va a virar el medio);
Resultados => se observaran los 3 parámetros: cambios de pH/color, producción de gas CO2 (grietas en el medio/ se desplaza) y producción de acido sulfhídrico SH2 (precipitado negro); siempre se compara con un tubo de control no inoculado.
Cambios de pH - [a] resultado final de la fermentación solo de la glucosa => K/A zona superficial roja (reacción alcalina de las aminas) y zona profunda amarillo (reaccion ácida); después de la fermentación de la glucosa, el medio de cultivo inicialmente es amarillo entero, pero posteriormente la parte del pico se alcalina/rojo (había poca cantidad de glucosa) por la descarboxilación oxidativa de los aminoácidos (que forman la peptona) que se produce mejor en aerobiosis; la fermentación de glucosa en el pico es inicialmente mediante la vía EMP, utiliza tanto para los aerobiosis y anaerobiosis, dando un intermedio clave (acido pirúvico), que a su vez el acido pirúvico es degradado mediante el ciclo de Krebs por los aerobiosis o anaerobiosis facultativos dando CO2 + H2O y ATP; en cambio, en el fondo, el acido pirúvico es degradado hacia acido láctico y acido mixtos que mantiene el pH acido de manera estable.; son características de Morganella, Providencia y Shigella; también P.mirabilis, S.typhimurium, S.enteritidis, S.flexneri.
[b] en la fermentación de glucosa y lactosa => A/A zona superficial y profunda son amarillas (características de E.coli y K.pneumoniae);
[c] no metabolizan ni lactosa ni glucosa (pero si la peptona) => K/K todo el tubo es de color rojo (si se trata de anaerobiosis) o si se trata de aerobiosis, la zona profunda es de color naranja (se alcalina mas la zona con mas O2 => Pseudomonas, P.aeruginosa)
[d] si no se consume ni glucosa, ni lactosa ni peptona => no hay cambio de color en el tubo (gérmenes inertes).
Producción de gas CO2 - aparecen burbujas, agrietamiento o desplazamiento del medio del fondo del tubo, debido a la formación de hidrógeno y de anhídrido carbónico (CO2)
Producción de acido sulfhídrico SH2 - se manifiesta por el color negro de la capa profunda o un anillo negro cerca de la parte superior de la capa profunda o un precipitado negro en la capa profunda (que puede enmascarar la acidificación del medio => fermentación de la glucosa activa la desulfurasas); SH2+ => Proteus y Salmonella.
TSI (Triple Sugar Iron) - identificación de Yersinia enterocolitica como sacarolítica (también Proteus, Lactobacillus y Clostridium), ya que el medio lleva el 3er hidrato de carbono (sacarosa al 1%); los fundamentos y la interpretación de los resultados son los mismos que en el método anterior, pero es imposible saber si el azucar utilizado es uno u otro o ambos.
Agar sulfuro-indol-motilidad/ ASIM o motility-indol-agar (MIA) - tal como indica su nombre, sirve para determinar la motilidad de los microorganismos, la produccion de indol y la formacion de acido sulfhidrico; la forma de realizarla es la siguiente => se siembra en picadura y se incuba a 37ºC durante 18-24 horas; la motilidad se vera por la zona del inoculo con un zig-zag (en la picadura); la produccion de indol se vera con un cambio de color a violeta purpura (el medio es de color violeta clarito); la produccion de SH2 se vera por un cambio a negro.
IMVIC (Indol - Motilidad - rojo de Metilo - Voges-Proskauer - Citrato) - se emplean en la identificación de la familia enterobacteriaceas; se hacen de una en una y conjuntamente;
Prueba de indol => estudia el metabolismo proteico/ la capacidad de degradar el triptófano (aminoácido) y de formar según la bacteria: indol y productos indólicos (escatol, acido indol-acético), mediante triptofanasa (enzima intracelular).
Material => tubos de ensayo, asa de siembra, pipeta Pasteur, estufa de cultivo, mechero.
Reactivo => caldo urea-indol de la casa Biomerieux, reactivo indol de Kovacs, microorganismo.
Técnica => Método de Kovacs: en el tubo con 500 lambdas de reactivo urea-indol, se siembra el microorganismo problema, incubar a 37ºC durante 4 horas, añadir al cultivo 2 gotas de reactivo indol de Kovacs (debe ser siempre fresco), agitar suavemente el tubo y dejar unos segundos en reposo.
Resultado => en indol+, aparece un anillo rojo en la superficie del medio (E.coli); en indol-, no hay cambio de color (Klebsiella pneumoniae)
Prueba de rojo de Metilo => muchas enterobacteriaceas con importancia clínica (E.coli, Proteus mirabilis, Yersinia, Salmonella typhimurium, Citrobacter freundii, Sighella, Vibrio) son anaerobios facultativos, que para tener energía para sus reacciones metabólicas, utilizan la fermentación acido-mixta de los hidratos de carbono produciéndose => acido succínico, acido acético, alcohol etílico (ácidos mixtos); en RM positivo, aparecen un color rojo fuerte en la superficie y en RM negativo, no hay cambio en la superficie del medio.
Material => igual que anterior
Reactivo => Medio de Clark y Lubs en tubo (liquido amarillo), solución de rojo de metilo y microorganismo
Técnica => (a) en el tubo del medio Clark y Lubs se siembra el microorganismo problema (b) actualmente se utiliza la modificación de Barry que es poner un inoculo abundante en 0,5 ml de reactivo de Clark y Lubs y dejar incubar entre 18-24 horas (c) a este cultivo se le añaden unas 5 gotas de indicador rojo de metilo que es rojo a pH 4,5 y amarillo a pH 6,3; el medio cambiara de color cuando el pH sea inferior a 4,5.
Resultados => RM+ superficie del medio rojo fuerte y RM- => color amarillo en la superficie del medio
Prueba de Voges Proskauer (2 microbiólogos) - lo podemos hacer en el API => la fermentación butanodiólica/ butilenglicólica/ acetoínica (acetil metil carbinol) que es una vía alternativa de metabolismo de acido pirúvico, se produce => un metabolito neutro (producto intermediario), en presencia de aire y hidróxido potásico 40%/KOH (por oxidación) se forma => diacetilo y añadiendo alfa naftol, se forma un complejo rojo; por reducción, la acetoína forma => 2,3 butanodiol;
Material => multiprueba API y resto igual
Reactivo => Medio de Clark y Lubs (liquido amarillo), solución de alfa naftol (VP2), solución de hidróxido potásico al 40% o hidroxilo sódico al 40% (KOH), microorganismo problema.
Técnica => en un tubo de ensayo que contenga un medio de Clark y Lubs se siembra el microorganismo problema, se incuba 24 horas a 37ºC, se añade 0,2 ml (200 lambdas) solución KOH 40%, luego 0,6 ml de la solución alfa naftol, agitar e inclinar casi horizontalmente el tubo para que se favorezca la oxidación de la acetoína, reposar el tubo 10 minutos e interpretar los resultados.
Resultados => en VP positiva (+), p.ej. Klebsiella pneumoniae y Enterobacter aerogenes, antes de 1 hora aparece coloración rojo rosada en la superficie del medio; VP negativa (-) p.ej. E.coli y Proteus, la superficie del medio queda de color amarillento o cobrizo (la reacción de los reactivos al mezclarse); la mayoría de enterobacteriaceas en VP dan reacciones opuestas a la reacción de RM (VP+ => RM- o VP- => RM+); las bacterias VP+ producen menor cantidad de ácidos mixtos que serán insuficientes para bajar pH del medio con rojo metilo, por ello, cuando una bacteria es RM- => VP+.
Prueba del Citrato => se investiga la capacidad del microorganismo de utilizar el citrato como única fuente de carbono y sales de amonio inorgánicas como fuente de nitrógeno, por el crecimiento de colonias y el viraje de color del indicador incorporado en el medio causado por la alcalinización; los microorganismos que utilizan el citrato, también utilizan las sales de amonio; citrato sódico es una sal de acido cítrico que es uno de los metabolitos del ciclo de Krebs y algunas bacterias pueden obtener energía por una vía diferente a la de la fermentacion de los hidratos de carbono, utilizando al citrato como única fuente de carbono; la alcalinización del medio es producido por la formación de amoniaco a partir de las sales de amonio que había y la formación de carbonatos y bicarbonatos se debe a la degradación del citrato.
Material => igual que anterior
Reactivos => medio solido de Citrato de Simmons en tubo con azul de bromotimol (agar inclinado) y microorganismo de problema
Técnica => inocular un tubo de Citrato de Simmons con microorganismo mediante escobillón, solo la lengüeta y guardar otro tubo que sirve de control negativo; incubar 24-48 horas a 37ºC dejando los tubos destapados para que se desprenda el CO2, leer los resultados a las 18-24 horas de incubación.
Resultados => en Citrato (+) p.ej. Enterobacter aerogenes, aparece color azul intenso en la superficie del medio y crecimiento de colonias en la lengüeta; en Citrato (-) p.ej. E.coli, no aparece cambio de color (verde) ni crecimiento.
Micro-técnicas
1. Sistema en Tiras (API - Biomerieux)
El material y reactivos necesarios para la realización de estas pruebas se encuentran comercializados en kits; fundamento => los medios deshidratados en micro-tubos se re-hidratan mediante una suspensión de 5 ml de agua estéril con 1 colonia bacteriana y se incuban; el proceso metabolismo del microorganismo, genera cambios del color en el medio de cultivo o al añadir reactivos y esos cambios se interpretan mediante tablas de lectura o ordenadores (se deben seguir rigurosamente las instrucciones del fabricante); principalmente se utiliza para la detección de Enterobacteriaceas, bacterias aerobios no-fermentativas, anaerobios, levaduras, estafilococos; después de utilizar todo debe ser incinerado o descontaminado en autoclave o sumergido en un germicida.
2. Sistemas en Tubos (entero-Tube BBL)
Se utiliza para identificación de Enterobacteriaceas y otras aplicaciones; fundamento => un tubo en forma de lápiz con numerosos compartimentos (normalmente son 8 con diferentes medios, donde pueden leer hasta 11 características); este tubo se inocula (con 1 colonia del medio y alambre de la inoculación atraviesa todas las cámaras) y se incuba, produce cambios de color en cada compartimento; mediante un código numérico o colorimétrico, se puede identificar al microorganismo.
3. Sistema rápidos - metodos automatizados
Cuando las muestras son procesadas a traves de metodos automatizados se logran excelentes resultados en tiempo muy cortos (se deben seguir las normas dadas por los fabricantes);
- Para detección primaria del crecimiento (espectrofotometría infrarroja) => detecta los niveles de anhídrido carbónico (CO2), p.ej. BACTEC
- Para identificación (fotometría) => VITECK (crecimiento, identificación y antibiograma)
Tema 17 - Pruebas de sensibilidad a los anti-microbianos
Antibiograma - estudio de la sensibilidad del microorganismo patológico a los antimicrobianos; se debe hacer antes de establecer el tto de una infección microbiana; diferentes metodos de antibiograma => (1) por difusión que daran resultados cualitativos de resistencia, sensibilidad o intermedios a los diferentes ATB (2) por dilución nos dará resultados cuantitativos en base a 2 conceptos (CMI/ Concentración Mínima Inhibitoria y CMB/ CM Bactericida) (3) por detección enzimática, consiste en detectar la enzima del germen que confiere resistencia a los ATB p.ej. detección de betalactamasa, adenilasa, acetilasa, etc.
Clasificación de las sustancias anti-microbianas:
(a) un microorganismo es sensible => cuando ATB alcanza niveles plasmáticos => a CMI en el lugar de la infección; CMI => la mínima cantidad de ATB capaz de inhibir el crecimiento de un germen; CMB => la mínima cantidad de ATB que mataría al germen; normalmente CMI es suficiente para combatir una infección y los mecanismos inmunitarios se encargan de eliminar el microorganismo, siendo por tanto la CMI es el termino mas utilizado.
(b) un microorganismo es resistente => cuando la concentración máxima de ATB que se puede localizar en el lugar de la infección no es suficiente para eliminar el germen, es decir, la concentración de ATB necesario para destruir el germen no se puede elevar mas por efectos tóxicos secundarios.
(c) microorganismo de sensibilidad intermedia => no esta afectado por dosis normales de ATB dadas a intervalos normales, pero con una dosis alta en el lugar de la infección sin llegar a dosis que produzcan efectos tóxicos, puede eliminar el germen.
Casos clínicos => Pseudomonas que da problemas respiratoria/ urinaria y es resistente a casi todos los ATB, se dará una dosis toxico o una combinación de ATB por vía endovenosa.
Normas básicas => no efectuar un antibiograma directamente del producto patológico, ni tampoco utilizar mezclas de gérmenes (se debe realizar un aislamiento por agotamiento en placa), excepto para muestras de orina ambulatoria (normalmente es una infección mono-microbiana); para elegir un ATB se deberá ensayar aquellos que son útiles clínicamente y se encuentran disponibles en el mercado farmacéutico.
Factores a tener en cuenta => (1) características tintoriales del germen (Gram+o-) (2) lugar de la infección (especialmente las vías urinarias y meningitis); es importante porque es necesario que la CMI sea alcanzable en los líquidos corporales para que sea efectivo (3) bacteria investigada.
La selección de ATB representativo de cada grupo para realizar las pruebas de sensibilidad
Normalmente se selecciona un ATB representativo de cada grupo para realizar las pruebas de sensibilidad; habitualmente se acepta que no es necesario hacer pruebas de sensibilidad para un ATB cuando no se han descrito resistencias en esas especies, p.ej. Streptococcus pyogenes.
1. Betalactámicos => todo el grupo tiene en común que presenta un anilla betalactámico y el mecanismo de acción consiste en inhibir la formación de peptidoglicano de la pared celular; son bactericidas.
a. Penicilinas - tiene espectro desigual => aveces es mas efectivo a uno pero no a otro.
* Penicilina G sodica - la forma oral es P V
* Amoxicilina - infección del tracto respiratorio inferior: bronquitis aguda y crónica, neumonías bacterianas y bronconeumonía, producidas por estreptococo, estafilococo sensible, neumococo y H.influenzae. Gastrointestinal: fiebre tifoidea o paratifoidea. Genitourinaria: cistitis, uretritis, pielonefritis, bacteriuria, gonorrea, aborto séptico, sepsis puerperal. De piel y tejido blando (incluida infección de herida quirúrgica), por estreptococo, estafilococo sensible y E. coli.
* Amoxicilina + acido clavulanico (es un inhibidor de las betalactámasas producida por algunas bacterias)
b. Cefalosporinas - actualmente se ha desarrollado la 4ª generación (semi-sintéticos; bacteriostáticas frente a cocos Gram+ y bacilos Gram-)
* Cefotaxima (indicado para gonorrea; profilaxis quirúrgica; epiglotitis y meningitis por Haemophilus)
* Cefuroxima (efectividad contra Neisseria gonorrheae y otras bacterias productoras de penicilinasa; es activa contra Streptococcus pneumoniae, Staphylococcus aureus, Staphylococcus epidermidis y estreptococo beta-hemolítico; son susceptibles Escherichia coli, Klebsiella pneumoniae, Proteus mirabilis)
2. Derivados de betalactámicos:
* Aztreonam - se utiliza comúnmente frente a las infecciones causadas por Pseudomonas aeruginosa, pero su espectro abarca a las enterobacterias (incluida Escherichia coli), como p.ej. Klebsiella, Haemophilus, Citrobacter y Proteus.
3. Aminoglicosidos => en general su mecanismo de acción es la inhibición de la síntesis de proteína en diferentes fases según el ATB; en general derivan de los hongos y son potentes bactericidas; son de amplio espectro y provocan toxicidad renal y audio vestíbular en alta dosis o a las personas susceptible.
* Estreptomicina (tratamiento de infecciones causadas por gérmenes sensibles, como: Mycobacterium tuberculosis, Salmonellas, enterococos, estreptococos, neumococos y algunos Gram- como Haemophilus influenzae; es eficaz en infecciones del tracto respiratorio)
* Gentamicina (Actúa sobre bacterias Gram- aerobias, incluyendo enterobacteriáceas, Pseudomonas y Haemophilus. Actúa también sobre estafilococos (S.aureus y S.epidermidis)
* Tobramicina (Infecciones del tracto respiratorio inferior como neumonía, bronconeumonía y bronquitis aguda causadas por P.aeruginosa, Klebsiella sp., Enterobacter sp., Serratia sp., E.coli y S.aureus)
* Neomicina (es activo in vitro contra Escherichia coli, Klebsiella y contra flora anaeróbica intestinal)
4. Lincosamidas => inhibe la síntesis proteica
* Clindamicina (es un buen ATB frente anaerobios) - Su actividad antibacteriana es similar a la de eritromicina (macrolidos) en contra de estafilococos y estreptococos; además es efectiva en contra de anaerobios, en especial Bacteroides fragilis.
5. ATB polipeptídicos y glucopeptídicos => su mecanismo de acción es inhibir la formación de peptido glicano de la pared celular (bactericidas)
a. Activos frente a Gram+
* Bacitracina - es utilizado para la identificación del estreptococo del grupo A a cual es sensible; es bactericida; se utiliza tópicamente para infecciones cutáneas (por su efecto de nefrotoxicidad) actúa sobre cocos y bacilos Gram+ (Neisseria y Treponema pallidum)
* Vancomicina - por su alta toxicidad renal y óptica, se reservan para infecciones de Gram+ resistentes; es bactericida; tiene acción ante cocos Gram+ y bacilos Gram+
b. Activos frente a Gram- => ambas (polimixinas) se usan tópicamente sobre Gram-, también se usa como ATB de identificación; tienen acción ante entero-bacterias (excepto Proteus, Providencia y Serratia), Pseudomonas aeruginosa, Vibrio, Pasteurella, Haemophillus y Bordetella; son ATB de segunda elección (para bacilos Gram- resistentes a otros ATB)
* Polimixina B
* Polimixina E (Colistina)
c. Activos frente a Mycobacterium tuberculosis
6. Otros
* Fosfomicina - es un ATB de origen español de un amplio espectro que actúa sobre la pared celular (se usa en infección urinaria)
* Acido fucsidico - actúa sobre la síntesis proteica y destaca su acción sobre Staphylococcus aureus.
7. Tetraciclinas - son bacteriostáticas y su mecanismo de acción es inhibir la síntesis de las proteínas; no se deben administrar a menores de 8 años por tener efecto secundarios sobre la dentición y los huesos; también pueden producir toxicidad sobre el tracto gastrointestinal y el higado; son de amplio espectro; origen biológico o semi-sintético; activas frente a cocos y bacilos Gram+ y Gram- aerobios; son fármacos de elección en brucelosis, cólera, granuloma inguinal (ETS).
* Tetraciclina
* Doxiciclina - es el tratamiento de fiebre tifus, fiebre Q, erupciones pustulosas por Ricketsias y fiebre de las montañas rocosas por Ricketsias, infecciones del tracto respiratorio causadas por Mycoplasma pneumoniae; el tratamiento de infecciones causadas por Gram-: chancroide causado por Haemophilus ducreyi, plaga debida a Yersinia pestis (anteriormente Pasteurella pestis), tularemia debida a Francisella tularensis (anteriormente Pasteurella tularensis), cólera causada por Vibrio cholerae (anteriormente Vibrio comma), infecciones por Campylobacter en fetos causadas por Campylobacter fetus (anteriormente Vibrio fetus), brucelosis causada por especies de Brucella (junto con estreptomicina), bartonelosis causada por Bartonella bacilliformis, granuloma inguinal causado por Calymmatobacterium granulomatis.
8. Cloranfenicol - es de amplio espectro; inhibe la síntesis proteica y es toxica a nivel medular; es de origen sintético, bacteriostático, actúa frente a Gram+ y - (especialmente Haemophilus influenzae y Salmonella)
9. Macrolidos y similares - inhiben la síntesis proteica; amplio espectro; se dan cuando es alérgica a penicilina; son bacteriostáticos y bactericidas en alta dosis.
a. Eritromicina (un buen ATB frente neumónia atípica, legionelosis, difteria, tos ferina)
b. Azitromicina - para tratar ciertas infecciones causadas por las bacterias, como la bronquitis; neumonía; enfermedades de transmisión sexual (ETS); y las infecciones en los oídos, pulmones, piel y garganta; no tienen ningún efecto sobre los resfriados, la gripe y otras infecciones virales.
c. Claritomicina - interfiere la síntesis de proteínas en las bacterias sensibles; faringitis, amigdalitis, sinusitis, bronquitis aguda, reagudización de bronquitis crónica, neumonía bacteriana (adquirida en la comunidad), infección de piel y tejidos blandos leve-moderada, foliculitis, celulitis, erisipela, infección localizada o diseminada por Mycobacterium avium o M.intracellulare, infección localizada por M.chelonae, M. fortuitum y M.kansaii. Prevención de infección diseminada por M.avium complex en pacientes con VIH de alto riesgo
10. Quimioterápicos de síntesis
a. Sulfamidas (es bacteriostático, de origen sintetico; inhibe la síntesis de acido fólico; activo frente Gram+ y -, Clamidias, Nocardia)
b. Trimetropin+sulfametoxazol (cotrimoxazol) - inhibe la síntesis de acido fólico; elimina las bacterias que provocan infecciones, incluyendo las infecciones que afectan las vías urinarias, los pulmones (neumonía), oídos e intestinos
c. Quinolonas (6) - inhiben la replicacioón del ADN bacteriano son buenos ATB de amplio espectro, pero se ha abusado mucho.
d. Norfloxacina - infecciones de las vías urinarias y la próstata; inhibe la replicación del ADN bacteriano. La norfloxacina pertenece a una clase de antibióticos llamados fluoroquinolonas; tomar norfloxacina aumenta el riesgo de que desarrolle tendinitis.
e. Ciprofloxacina - inhibe la replicación del ADN bacteriano; para tratar o prevenir determinadas infecciones bacterianas, también se usa para tratar o prevenir el ántrax (una infección grave que se puede propagar en forma intencional como parte de un ataque bioterrorista) en quienes han estado expuestos a los gérmenes del ántrax suspendidos en el aire; tomar ciprofloxacina aumenta el riesgo de que desarrolle tendinitis.
11. Quimioterapia antituberculosa - actualmente se emplea:
* Rifampicina - ATB sistémico, antituberculoso, bactericida. Inhibe la síntesis de ARN bacteriano. Tuberculosis en todas sus formas (asociado a otros tuberculostáticos). Brucelosis. Erradicación de meningococos en portadores asintomáticos, no enfermos. Alérgicos o con contraindicaciones a otros antibióticos o quimioterápicos. Infecciones causadas por estafilococos (S.aureus, S.epidermidis, cepas polirresistentes) y por enterococos (S.faecalis, S.faecium).
* Isoniacida - para tratar la tuberculosis, y para prevenirla en personas que han tenido contacto con las bacterias de la tuberculosis. Elimina sólo las bacterias activas (en crecimiento). Debido a que las bacterias pueden estar en un período de incubación (sin crecimiento) durante largos períodos, la terapia con isoniazida (y otros medicamentos para evitar la tuberculosis) debe hacerse durante mucho tiempo (por lo general entre 6 y 12 meses).
* Etambutol - el tratamiento de tuberculosis pulmonar; debe ser usado en conjunción con otros fármacos antituberculosos.
12. Quimioterapia antimicótica:
* Nistatina
* Miconazol
* Amfotericina B.
* Fluconazol
13. Quimioterapia anti-viral
* Aciclovir - antiviral activo frente al virus herpes humano, inhibe la replicación de ADN viral, interfiriendo con el ADN polimerasa viral.
* Ribavirina - La ribavirina se utiliza con un medicamento interferón, para tratar la hepatitis C en personas que no han sido tratadas con interferón antes. La ribavirina pertenece a una clase de medicamentos antivirales llamados análogos de nucleósidos. Esta actúa impidiendo que el virus que provoca la hepatitis C se propague dentro del cuerpo.
Pruebas de sensibilidad anti-microbiana - técnicas que investigan la actividad anti-microbiana de distintos quimioterápicos frente al microorganismo estudiado; sus principales aplicaciones:
- contribuir a la identificación de los microorganismos (p.ej. sensibilidad del neumococo/S.pneumonia a la optiquina; del S.pyogenes a la Bacitracina)
- constituye una base fundamental para la instauración de una terapia adecuada.
Son técnicas estandarizadas y se ha demostrado que existe un paralelismo entre los resultados de sensibilidad obtenidos in vitro con los efectos terapéuticos in vivo; la prueba mas utilizada es la difusión en medio solido a excepción de los grandes laboratorios que utilizan sistemas multiprueba o métodos automatizados (Vitec, Pasco...)
Antibióticos - un grupo de compuestos químicos terapéuticamente muy útiles y que antaño se caracterizaban por ser subproductos metabólicos de un microorganismo siendo casi siempre letal para otros gérmenes (p.ej. a los hongos); actualmente la mayoría son sintetizados en el laboratorio; uno de los primeros es descubierto en 1927, cuando Alexander Flemming descubrió la penicilina extrayendo-lo de un hongo (Penicillium notatum) siendo en 1929 cuando efectuó los primero ensayos de sensibilidad anti-microbiana (se contaminaron las placas sin querer por un hongo); en 1939 Rose y Miller intentaron estandarizar las múltiples variantes de los análisis de sensibilidad microbiana por difusión en placa y posteriormente en los años 50, Kirby-Bauer y Anderson estandarizaron la técnica que se utiliza actualmente por difusión en medio solido o en placa.
Los principales pruebas para hacer un antibiograma:
a. Manuales
1. Prueba de dilución en medio solido y liquido
2. Prueba de elución en disco
3. Prueba de detección enzimática
4. Prueba de difusión en medio solido (de Kirby-Bauer)
b. Automatizadas
Términos utilizados en las pruebas anti-microbianas:
- Microorganismo sensible o sensibilidad => es inhibido por un ATB a dosis habituales
- Microorganismo de sensibilidad intermedia => el germen "in vitro" no es claramente sensible al ATB, pero si lo seria "in vivo" incrementando la dosis habitual sin llegar a dosis toxicas
- Microorganismo resistente o resistencia => no es sensible al ATB a dosis habituales y es necesario administrar dosis toxicas
- CMI (cantidad mínima inhibitoria) => es la menor concentración de un ATB capaz de inhibir el crecimiento bacteriano de una cepa dada
- CMB (cantidad mínima bactericida) => es la menor concentración de un ATB con la que no quedan bacterias vivas de una cepa dada
Técnicas manuales de realización de las pruebas de sensibilidad anti-microbiana
a. Pruebas de dilución (es una técnica de centros de investigación /lenta /engorrosas) => se basan en el estudio al unisono de diferentes concentraciones de ATB, lo que les da un carácter cuantitativo en base a los conceptos CMB y CMI; 2 tipos => en medio liquido y solido; se utilizan 10 tubos con gérmenes en caldo nutritivo o agar y a cada tubo se le añade una cantidad prefijada de ATB diluido seriadamente, excepto en el tubo de control; se incuban 18-24 horas a 37ºC y se examina la turbidez que indica crecimiento de gérmenes; en el tubo donde no hay turbidez se ha inhibido el crecimiento de los gérmenes; con estos datos estudiamos la CMI y la CMB de los antibióticos.
b. Pruebas de elución en disco (disolver) => se realiza introduciendo discos de un ATB en tubos con caldo nutritivo; el ATB se disuelve en el caldo alcanzando una concentración final conocida, posteriormente se inocula un volumen de una suspensión microbiana y se sigue la misma metodología descrita antes obteniéndose resultados cuantitativos o cualitativos en base a sensibilidad, sensibilidad intermedia o resistencia (no se utilizan habitualmente).
c. Pruebas enzimáticas de detección => fundamentalmente se detectan las beta-lactamasas; un reducido numero de bacterias son resistentes a las penicilinas y cefalosporinas (ATB B-lactámicos) debido a que producen un enzima (b-lactamasa) capaz de inactivar estos ATB, p.ej. los gonococos, pneumococo y algunos estreptococos; consiste en observar el crecimiento de los gérmenes en presencia de dichos ATB; se toma la colonia sospechosa y mezclar-la con un sustrato que si cambia de color nos indica que la colonia es B-lactamasa (+), por lo tanto es resistente a los ATB B-lactamico; se denomina Prueba de NITROCEFIN.
d. Prueba de difusión en medio solido (antibiograma clásico) => estandarizado desde los años 50 (se hace igual en todo el mundo) por Kirby-Bauer y Anderson en todos sus pasos y es mas utilizado actualmente en forma manual; fundamento => depositar discos impregnados de ATB sobre cultivos de microorganismos en placa; la difusión del ATB a traves del medio produce un halo de inhibición del crecimiento cuyo diámetro sera proporcional a la potencia del ATB dando resultados cualitativos de resistencia, sensibilidad o sensibilidad intermedia a los ATB; material => placas de Petri (9cm), pinzas metálicas estériles o dispensador automático, pie de rey o regla milimetrada, medio Mueller-Hinton, discos de ATB, suspensión microbiana al 0,5 escala Mc Farland (10 elevado 8 u.f.c./ml; escala Mc Farland => el 0,5 se prepara añadiendo 0,5 ml de Cl2Ba 0,04 M a 99,5 ml de acido sulfúrico 0,36M); una placa llena => mas de 10 elevado 6.
Técnica => el medio Mueller-Hinton se vierte en placas con un espesor de 4 mm; la siembra utilizada preferentemente (a) la de Kirby-Bauer: se introduce un escobillón en el inoculo preparado al 0,5 Mc Farland (no tenemos) y se siembra en 3 direcciones y se deja aproximadamente 4 minutos la placa semi-abierta e invertida antes de colocar los discos; (b) la de Barry: se hace una inoculación previa al vertido de las placas, se añaden 0,1 ml del inoculo a 25 ml del medio Mueller-Hinton fundido y se vierte en placa (no se usa mas)
Elección de ATB => se debe seleccionar un ATB representativo de cada grupo excepto en los casos donde existan diferencias significativas en los espectros de actividad o resistencia; los aspectos importantes que prevalecen a la hora de seleccionar un ATB => las características tintoriales del germen (Gram+o-), el lugar de la infección (orina, meningitis) y la bacteria investigada.
Concentración de los discos => tiene que estar perfectamente estandarizada siguéndose las normas de la Federación de Drogas y Alimentos/ FDA => la actividad del disco debe estar entre 65% y 150% y de la OMS => entre 75% y 135%; siempre se debe utilizar un control para controlar la actividad de los discos; en general, se escogen discos con una concentración que producen un halo de inhibición entre 20 y 30 mm para organismos tipificados como sensibles y de menos de 10 mm para los resistentes.
Implantación de los discos (papel de filtro grueso de un diámetro 6mm que van impregnados con una concentración determinada de ATB); Manual => se saca el disco de ATB con unas pinzas estériles y se deposita en la placa, la distancia mínima entre los discos es de 24 mm para evitar la superposición de los halos, deben estar situados a 15 mm del borde como mínimo (se colocan 8 discos) una vez depositado el disco se presiona ligeramente con la punta de pinzas; Automática => se utilizan dispensadores automáticos que son unos dispositivos de plástico del tamaño de una placa de Petri con unos orificios guía que permiten la colocación simultanea de todos los discos en el lugar adecuado, y con una pinza se presionan ligeramente los discos para que al girar o invertir la placa no se caigan los discos.
Incubación => 18-24 horas a 35-37ºC (máximo 48 horas)
Lectura e interpretación del antibiograma => los resultados se expresan según el halo de inhibición que aparece alrededor de cada disco; el halo se mide con una regla calibrada o pie de rey midiendo los diámetros, y según cual sea clasificaremos al germen como sensible (la dosis habituales es eficaz), intermedio (se deben incrementar las dosis habituales sin llegar a dosis toxicas) o resistente (ATB es totalmente ineficaz);
Observación al método:
1. preservar la estandarización en todos sus pasos
2. puesto que la difusión del ATB es casi instantánea no debe moverse ningún disco una vez que se ha puesto en contacto con la superficie del agar
3. los discos se tienen que conservar en la nevera
4. procurar que la lectura se haga a las 18-24 horas, evitándose el exceso de incubación
5. Aunque el medio elegido es el Mueller-Hinton, se pueden emplear medios enriquecidos como AS (estreptococo), agar chocolate (Haemophylus) para gérmenes exigentes
6. de vez en cuando hay que colocar controles de calidad
7. cuando el germen sea anaerobio el método es diferente
Método automatizados de identificación y susceptibilidad - actualmente existen diferentes metodos automatizados para realizar el antibiograma; los mas utilizados se basan fundamentalmente en la medida bien fotométrica o bien turbidimétrica del efecto de un ATB sobre el crecimiento de una bacteria en medio liquido comparándolo con el de la misma bacteria en un medio sin ATB; otros metodos se basan en técnicas de impedancia eléctrica microcalorimetría bioluminiscencia, radiometría ...
Los metodos fotométrico y turbidimétrico p.ej. sistema Vitec, se resume:
- se utilizan unas tarjetas desechables del tamaño de un naipe donde se inyecta la muestra ya diluida mediante un modulo inyector; la tarjeta presenta unas perforaciones donde lleva incorporadas diferentes medios selectivos liofilizados;
- la tarjeta se sella y se coloca en un modulo incubador y de lectura, leyéndose de manera automática los resultados cada hora; los datos los almacena un ordenador que los compara con valores umbrales ya almacenados; el ordenador puede dar resultados a las 4 horas (lo normal entre 4 -13 horas)
El sistema Microscan utiliza un sistema semejante al de dilución en caldo pero en miniatura utilizando paneles con caldo de Mueller-Hinton deshidratado (como API); tras la inoculación y re-hidratación con una suspensión estandarizada del microorganismo y su incubación a 35ºC por un mínimo de 16 horas, la CIM o una sensibilidad cualitativa (sensible, intermedio o resistente) para el organismo en prueba se determina observando la menor concentración ATB, que muestre inhibición de crecimiento; esta detección puede hacerse manualmente mediante un visualizador de micro-dilución o mediante un lector conectado a un ordenador; viene en tripletes de un ATB con diferentes concentraciones.
Agentes antimicrobianos (ATB) activos frente a Gram- => Cefuroxima, Cefotaxima, Colistina, Tobramicina, ; frente a Gram+ => Eritromicina, Tetraciclina, Vancomicina, Meticilina, Clindamicina, Doxicilina; frente a ambos Gram+ y - => Ampicilina, Cefalotina, Gentamicina, Cotrimoxazol, Cloranfenicol, Imipenem, Amoxicilina+acido clavulonico.
Clasificación de los antibióticos según su efecto bacteriano
Bactericidas => Penicilinas, Cefalosporinas, Aminoglucósidos, Rifampicina, Quinolonas, Monobactámicos, Polimixinas.
Bacteriostáticos => Tetraciclinas, Eritromicina, Sulfonamida, Novobiocina, Cloranfenicol
Clasificación de los antibióticos según su mecanismo de acción sobre la estructura bacteriana
I. Inhibición de la síntesis de la pared celular
Penicilinas
Cefalosporinas
Vancomicina
Fosfomicina
Tercoplanina
Bacitracina
II. Lesión en la permeabilidad de la membrana celular
Poliomixinas
Colistinas
Nistatina
Anfotericín B
III. Inhibición de la síntesis proteica
Cloranfenicol
Tetraciclina
Aminoglucósidos
Lincomicinas
Eritromicina
IV. Inhibición de la síntesis de ácidos nucleicos
Quinolonas
Sulfonamidas
Rifampicina
Trimetropín
Estudio de la orina
Función del riñón:
- La eliminación de nuestro organismo de una importante cantidad de residuos metabólicos, muchos de ellos inútiles, y de otros que incluso pueden comportarse como tóxicos.
- La regulación de la composición de los fluidos de nuestro organismo facilitando así, tanto la supervivencia de las células como el optimo desarrollo de todos los procesos metabólicos.
- El control hormonal de la presión arterial (adrenalina, noradrenalina)
- El control de los niveles orgánicos del calcio (mineral corticoides aldosterona, 1,25 dihidroxicolecalciferol)
- El control de la eritropoyesis (eritropoyetina)
Nefronas - son unidades funcionales básicas consiste de 2 partes => el glomerulo (dentro de la cavidad "capsula de Bowman") y la red tubular.
El glomerulo - rodeado de una cavidad (capsula de Bowman) y dispone de una extensa red vascular; filtrar/ depurar el plasma 25 ml de sangre por minuto (150 litros de plasma/ dia); se filtra agua, urea, creatinina, aminoácidos, ácido úrico, glucosa, proteínas de bajo pm.
La red tubular - el filtrado por el glomerulo es recogido en la capsula de Bowman y se dirige hacia la red tubular donde se lleva a cabo un proceso de reabsorción selectiva => reabsorber agua, ciertos elementos útiles para el organismo y que deben ser recuperadas (glucosa, agua, sodio, cloruro, potasio, bicarbonato, urea, aminoácidos, proteina) y permite la secreción de otras que, por su toxicidad, deben ser posteriormente eliminadas mediante la micción (amonio, urea, hidrogeniones/H+); se elimina 1 ml de orina por minuto (1500 ml diarios); la red tubular esta formada por => túbulo contorneado proximal, asa de Henle, túbulo contorneado distal y túbulo colector.
Mecanismo de la función renal:
- Filtración glomerular => filtra el plasma desde los capilares que lo envuelven hasta la capsula de Bowman.
- Reabsorción tubular => el producto de la filtración glomerular se modifica su composicion al atravesar la red tubular.
- Secreción tubular => transporte de sustancias, desde la red capilar hacia los túbulos renales; destaca la secreción activa de iones H+, que permite la regulación del equilibrio acido-base en el organismo.
Procedimiento de la recogida de muestra (el personal facultativo determina el tipo de muestra necesaria para el análisis) => informar a la persona del objeto del análisis; indicar el tipo de muestra deseada; orientar acerca de la técnica de obtención de la misma; indicar las pautas de almacenaje y transporte adecuado (si se toma fuera del laboratorio); insistir en la importancia de la limpieza en general y de la higiene antes de la recogida (evitar la contaminación involuntaria); describir el tipo y características mas adecuadas del recipiente a utilizar; tener en cuenta la capacidad del paciente para evacuar la vejiga de forma voluntaria y la necesidad de utilizar técnicas invasivas para obtener la orina en condiciones adecuadas.
Recogida de muestras de orina
- Micción espontanea => paciente responsable de la misma para obtener muestra sin contaminación; prevención: eliminar la primera porción de la micción y asegurar el lavado minucioso previo de los genitales; indicaciones: análisis fisico-químico, estudio del sedimento, concentración de creatina y microbiologia (en ocasiones).
- Cateterismo vesical/ sondaje (realizada por personal enfermería) => pacientes que presentan dificultades de la micción, mujeres para evitar la contaminación vaginal.
- Punción supra-púbica (realizada por personal facultativo) => diagnostico de infección por microorganismos extraños en niños.
Tipos de muestras para un análisis de orina (sin supervisión - micción espontanea):
- Primera orina de la mañana => se recomienda porque la concentración de solutos es variable a lo largo del día y esta en relación con la ingesta de liquidos.
- Orina tomada al azar => muestra valida para cultivos microbiologicos
- Orina minutada (fraccionada, de 2 horas, de 24 horas) => gran utilidad para el paciente diabeticos
Análisis de orina - procedimiento técnico encaminado a examinar los componentes que la integran, su cantidad y la proporción en que se encuentran; su estudio proporciona gran información acerca de múltiples alteraciones orgánicas y de muy diversa etiología (riñon, procesos metabólicos) => permite detectar alteraciones patológicas, estados fisiológicos particulares no patológicos (embarazo) y un buen funcionamiento renal.
Objetivos:
Objetivos:
- obtener información del estado general del riñon y las lesiones que pudieran afectarlo
- detectar la existencia de una alteración a nivel de las vías urinarias
- teniendo en cuenta aquellos productos que se eliminan vía urinaria, detectar alteraciones funcionales de otros órganos
- detectar las alteraciones metabólicas de diversa etiologia
- se intenta encontrar sustancias o componentes que normalmente no se encuentran en la orina
- detectar alguna alteración en la concentración (por defecto o por exceso) de componentes que habitualmente se encuentran en la orina
Tipos de análisis de orina => análisis elemental, completo, rutinario, anormales y sedimento.
Parámetro bioquímico => Densidad - Bilirrubina - Cuerpos cetónicos - Proteínas - Urobilinogeno - Glucosa - Hemoglobina - Nitritos - pH - Hematíes - Leucocitos (actualmente se utiliza determinación por química seca / tiras reactivas).
Análisis general de una muestra de orina:
- Físico/macroscópico => cantidad, aspecto/turbidez, color, olor, densidad, pH
- Químico/anormales => proteínas, glucosa, cuerpos cetónicos, sangre/hemoglobina, bilirrubina/ pigmentos biliares, urobilinógeno/ urobilina, nitritos
- Microscópico => estudio de estructuras cristalinas/cristales y de formas amorfas en suspensión, estudio citológico, estudio bacteriológico.
- Microbiológico => urinocultivo, identificación del germen (pruebas bioquímicas), ATB (antibiograma).
- Parasitológico => técnicas especificas de visualización macroscópica de parásitos; estudio microscópico de parásitos en la muestra de orina: parásitos enteros o parte de ellos, huevos, formas de resistencia (quistes).
El orden cronológico de un análisis general => características físicas macroscópica - sedimentación (a 1500 rpm durante 10-15 minutos) - pruebas bioquímicas (tiras reactivas); la muestra sobrante se debe guardar hasta que la analítica haya concluido; hay que revisar los resultados del sedimento concuerdan con las pruebas químicas y comprobar las anomalías detectadas han sido confirmadas.
Examen físico - macroscópico
Es orientativo => para diagnosticar una patología, hay que confirmar con otros análisis complementarios; hay que tener en cuenta situaciones fisiológicas (menstruación, grado de hidratación, etc.) que pueden alterar las características de la muestra;
1)- Cantidad / diuresis normal 1200-2000 ml/24H; alteración => oliguria/inferior, poliuria/superior, anuria/falta de eliminación (<300 ml/24H)
1)- Cantidad / diuresis normal 1200-2000 ml/24H; alteración => oliguria/inferior, poliuria/superior, anuria/falta de eliminación (<300 ml/24H)
2)- Aspecto / turbidez; recién emitida: clara y transparente; almacenada: sedimento blanco/fosfatos y carbonatos, sedimento rojizo (uratos desaparecer al calentar la orina a 60ºC);
3)- Color amarillo / ámbar (en función de la concentración)
4)- Olor aromático, ligeramente amoniacal
5)- Densidad 1.010-1.030 (se determina mediante tiras reactivas);
6)- pH normal 5,5-6 (ligeramente ácida); pH alcalino => posible contenido de gérmenes con ureasa.
Pruebas bioquímicas cuantitativas
Proteínas - en condiciones normales las proteínas se encuentran 130-150 mg/día en función del volumen de orina eliminado; en recién nacidos 2-8 mg/100 ml; cantidad de proteína (con peso molecular menor)=> (a) albumina 1/3 del total (fisiológica); (b) globulinas; (c) proteína de Tamm-Horsfall (T-H) es muco-proteína viscosa que no se encuentra en el plasma - se forma en el tubulo contorneado distal, constituye la matriz de los cilindros; (d) transferrina; (e) IgA.
Proteinuria => eliminación de proteina en orina superando los VN
- intensa (>4 g/día) indica un daño renal grave; se dan en síndrome nefrótico, glomerulonefritis (aguda y crónica), congestión venosa renal;
- moderada (de 0,5 - 4g/día) indica un daño renal menos graves; se dan en pielonefritis con hipertensión, nefropatía diabética, mieloma multiple.
- leve (<0,5 g/día) se dan en riñones poliquísticos, lesiones renales incipientes.
Proteinuria => eliminación de proteina en orina superando los VN
- intensa (>4 g/día) indica un daño renal grave; se dan en síndrome nefrótico, glomerulonefritis (aguda y crónica), congestión venosa renal;
- moderada (de 0,5 - 4g/día) indica un daño renal menos graves; se dan en pielonefritis con hipertensión, nefropatía diabética, mieloma multiple.
- leve (<0,5 g/día) se dan en riñones poliquísticos, lesiones renales incipientes.
- de patrón glomerular => pierde su selectividad en la filtración.
- de patrón tubular => cuando hay lesión tubular
- de forma intermitente o transitoria => puede ser fisiológica (hay que comprobarlo)
- de forma persistente => suele cursar con hematuria y su pronostico es peor.
Glucosa - la orina normal carece casi por completo de glucosa (filtrado y absorbido); normoglucemia => 6-120 mg/dl; umbral renal 160 mg/dl; glucosuria => aumento de la concentración de glucosa en orina por encima de los VN, causada por (1) aumento de la glucemia por encima de umbral renal (2) alteración renal (tubulopatía)
- de patrón tubular => cuando hay lesión tubular
- de forma intermitente o transitoria => puede ser fisiológica (hay que comprobarlo)
- de forma persistente => suele cursar con hematuria y su pronostico es peor.
Glucosa - la orina normal carece casi por completo de glucosa (filtrado y absorbido); normoglucemia => 6-120 mg/dl; umbral renal 160 mg/dl; glucosuria => aumento de la concentración de glucosa en orina por encima de los VN, causada por (1) aumento de la glucemia por encima de umbral renal (2) alteración renal (tubulopatía)
Cuerpos cetónicos (compuesto por acido acetilacetico/diacetico, acido beta-hidroxibutirico, acetona) - en personas sanas, los CC se sintetizan en el hígado y se metabolizan por completo, de forma que en la orina aparecen en concentraciones mínimas (indetectables); cetonuria => aparición de cuerpos cetónicos detectables en orina; la presencia de cetonuria y el aumento de cetonemia implica que no se realiza correctamente el catabolismo oxidativo de los ácidos grasos; las causas de cetonuria:
- sobrecarga de lipidos en la dieta
- diabetes mellitus (coma diabetico)
- vómitos (en niños y embarazadas)
- bajo consumo de hidratos de carbono o alteración en su metabolismo
- ayuno prolongado
Hemoglobina - no aparece en orinas normales; hemoglobinuria => presencia de Hb en orina (si la cantidad es alta, se puede ver a simple vista); causas => enfermedad renal de vías altas, anemias hemolíticas, reacciones transfusionales, infecciones (malaria, paludismo)
Pigmentos biliares (bilirrubina y biliverdina) - se forman en bazo, higado y MO por degradación fisiológica de Hb; 2 tipos => BB-Albumina / indirecta y BB-Glucurónico /directa; aparece BB en orina, siempre que aumente la BB directa en sangre por causas => enfermedad obstructiva (ictericia obstructiva/ acumulación en sangre), lesiones hepáticas (hepatitis, hepato-toxicidad).
Urobilinógeno - BB directa con la bilis, pasa al intestino delgado donde por acción de la flora bacteriana se transforma en urobilinógeno o estercobilinógeno (se elimina en mayoría con las heces y la orina en menor concentración); la cantidad de urobilinógeno aumenta en la orina en las hepatitis y las anemias hemolíticas; la determinación de urobilinógeno debe realizarse rápidamente en orina, ya que se transforma en urobilina + O2 (falso negativo).
Nitritos - su aparición en la orina indica crecimiento bacteriano (bacteriuria), de germenes capaces de reducir los nitratos ingeridos con la dieta, hasta nitritos (entero-bacterias); un resultado negativo de la prueba de los nitritos, no indica ausencia de microorganismos, ya que puede haber bacterias que no son productores de nitritos o ausencia de nitratos ingeridos en la dieta.
Examen microscópico de orina - sedimento urinario - estudio de elementos o estructuras de origen y composicion variados que aparecen suspendidos en la orina que proporciona ayuda para el diagnostico y evolución de las enfermedades renales; la muestra debe examinarse antes de transcurridas 3-4 horas desde su recogida (algunas estructuras como celulas y cilindros se lisan fácilmente; obtención del sedimento: homogeneizar bien la muestra, verter 10 ml en un tubo de centrifuga (fondo cónico), centrifugar a 1500 rpm durante 10 minutos; decantar el sobrenadante (quedando solo 1 ml), re-suspender el sedimento residual, montar un fresco (una gota entre porta y cubreobjetos, evitando la formación de burbujas), observar al microscopio a 40x, intensidad lumínica media y condensador a media altura; también se puede observar a 10x en el perímetro de cubre si hay los cilindros hialinos.
Estructuras organizadas
- Hematíes: pueden proceder de cualquier parte del sistema renal; en gran numero indica infección, traumatismos, neoplasias y litiasis renal; presencia normal de 1-2/campo o como una contaminación menstrual; pueden confundirse con levaduras y cristal de oxalato cálcico monohidratado; con tinción Gram se diferenciar => los hematíes son teñidos de rojo, levaduras de violeta y cristales incoloros; es importante distinguir entre macro-hematuria (se ve en el sedimento de color rojizo) y micro-hematuria (únicamente se detecta al microscopio), también si el color rojo observado macroscópicamente procede de hematíes o Hb (al centrifugar el sedimento, el color rojizo de Hb permanece).
- Leucocitos (neutrófilos): pueden proceder de cualquier parte del sistema renal; >50% de ellos se lisan al permanecer mas de 2-3 horas a temperatura ambiente; presencia normal de 1-2/campo (varón) y 1-3/campo (mujer); cifra superior de normal en el sedimento => piuria (>5 leucocitos/campo indica => infección renal en cualquier nivel);
- Espermatozoides: formados por 2 partes cabeza y cola; frecuente en un sedimento del varón (eyaculaciones recientes, poluciones nocturnas, etc.), y en mujer después de haber mantenido relaciones sexuales.
- Bacterias: la composicion de orina es un excelente medio de cultivo para los microorganismos; la mayoría de ocasiones son fruto de una contaminación de la flora saprofita alojada en zonas próximas al meato urinario => anal, perineal, vaginal (sobre todo en mujeres); su presencia en el sedimento, no debe ser tenida en cuenta salvo que vaya acompañada de piuria (aumento de leucocitos).
- Levaduras: su presencia en la gran mayoría debido por una contaminación, salvo acompañada de una piuria; en personas diabéticas, debido a la glucosuria, parecen facilitar el crecimiento micótico; su identificación es sencilla, por su forma ovoidea, frecuentemente con presencia de celulas en gemación; su tamaño es ligeramente mayor que los hematíes (pueden confundirse); su aumento en la orina se trata de vaginitis causada por Candida albicans.
- Parásitos: (1) Protozoos: normalmente se trata de Trichomonas vaginalis (frecuente en sedimentos de mujeres con vaginitis que puede ser asintomático y mas raro en los de hombres); aspecto piriforme de mayor tamaño que los leucocitos y una gran motilidad (por sus flagelos); su identificación es mas complicada cuando la motilidad esta mermada (al ser de un tamaño semejante al de los leucocitos); la piuria que le acompaña puede hacer pensar (erróneamente) en una infección bacteriana y se descarta esta posibilidad al obtener urocultivos negativos;
(2) otros parásitos: su aparición es siempre el resultado de una contaminación de la muestra de orina con materia fecal;
Celulas epiteliales: el árbol urinario esta revestido por 3 tipos de epitelio => (1) columnar /tubular /renales /cuboideo (capsula de Bowman, túbulos distal, proximal y colector) (2) transicional o urotelio (pelvis renal, uréteres, vejiga y uretra) y (3) escamoso (uretra y vejiga); una escasa descamación es normal, pero se puede aumentar por causas => microorganismos, productos químicos, cuerpos extraños, procesos degenerativos, procesos invasivos-destructivos.
- Celulas tubulares /renales /cuboideas: son de tamaño 1/3 mayores que los leucocitos; su forma normal es redonda con núcleo grande y céntrico; un sedimento normal 0-1/campo; aumentado en pielonefritis y glomerulonefritis.
- Celulas de transición (segunda capa de vejiga): el epitelio transicional es pluriestratificado (3 capas => basal, intermedia y superficial); las celulas son de tamaño 2-4 veces mayor que leucocitos; su forma es redondeada, piriforme o raqueta con un núcleo pequeño; un sedimento normal 0-2/campo; su aumento exige un estudio citológico mas completo (p.ej. tinción de Papanicolau), por posibilidad de un carcinoma en cualquier punto entre la pelvis renal y la vejiga.
- Celulas del epitelio escamoso: son planas y tienen abundante citoplasma con nucleo centrico y pequeño; a veces sus bordes aparecen doblados, replegados; un sedimento normal 0-1/campo.
- Cilindros hialinos: se pueden encontrar en grandes cantidades en orinas normales (deshidratación y estrés físico) y también en nefropatías; su aparición en el sedimento no tiene significación clínica (1-2/campo); para visualizar su escasa refringencia, hay que evitar un exceso de iluminación; normalmente sus contornos se aprecian con suficiente nitidez y uno de sus extremos es romo (un dedo de guante); existe también cilindros granulo-hialinos, muy semejante a los hialinos, pero con algunas incrustaciones en su estructura (sin significación clínica);
- Cilindros granulosos: predomina la estructura granular y desaparece el aspecto hialino; 2 tipos => cilindros granulosos finos (semejante a los hialinos en tamaño y forma; tienen mayor refringencia debido a la masiva pequeños gránulos de inclusión) y cilindros granulosos gruesos (estructura totalmente diferente a los hialinos; son de mayor tamaño, aspecto rígido y mayor refringencia; sus borden son contrastados y angulados; en orina normal 0-1/campo; el aumento de su presencia indica una nefropatía.
- Cilindros celulares: la presencia de ellos en la orina nunca es normal; tipos:
(1) Epiteliales - la matriz del cilindro engloba celulas epiteliales que se han desprendido de la luz tubular; gran variedad de nefropatías, lesiones del epitelio tubular (debidas a diversos tóxicos industriales, medicamentos y virus) puede causar la formación de este cilindros.
(2) Hemáticos (eritrocitarios) - aparecen en sedimentos con hematuria; es un signo de lesión a nivel del parénquima renal (vasculares o pielonefritis); la cantidad de estos cilindros suele ser escasa y dificulta su localización.
(3) Leucocitarios - fácil de reconocer porque los leucocitos presentes en su matriz se conservan estables durante el trayecto por los túbulos; su presencia normalmente acompañada por piuria intensa e indica infección localizada en el parénquima renal (pielonefritis) o lesiones de tipo inflamatorio (glomerulonefritis aguda).
(4) Bacterianos - se parecen a los granulosos toscos; generalmente unidos a piuria y muy probablemente se trate de una pielonefritis.
- Cilindros grasos: cilindros granulosos o celulares con pequeñas inclusiones lipídico (gotitas de grasa); muy refringentes y tonalidad amarillenta donde se localizan dichas inclusiones; indica una nefropatía todavía no manifestada.
- Cilindros céreos: son muy refringentes, rígidos, de apariencia dura, superficie rugosa y brillante (como la cera de las velas), los extremos angulados y generalmente de gran tamaño; su presencia es un síntoma claro de una alteración renal importante; suelen estar inmersos en una cilindruria (presencia de la mayoría de los diversos tipos de cilindros).
Estructuras no organizadas
Cristales: en general son productos finales del metabolismo que adoptan formas cristalinas según la condiciones físico-químicas de la orina (la pH sobretodo, densidad, temperatura, etc.) y se excretan a nivel urinario; se diferencian en 3 grupos:
(1) Cristales endogénos normales - no corresponden a alteraciones metabólicas ni funcionales, muy frecuente en el sedimento y pueden aparecer en orinas recién emitidas.
(2) Cristales endogénos patológicos - reflejan trastornos metabólicos o afectación grave de algún órgano o sistema y muy raras veces aparecen en orina.
(3) Cristales exógenos - aparecen en la orina tras la introducción en el organismo (vía enteral o parenteral) diversas sustancias (contrastes radiológicos/ contraste radiopaco vía endovenosa y medicamentos p.ej. sulfonamidas, etc.)
- Cristales de acido úrico: en orinas ácidas; son birrefringentes; de formas variadas (p.ej. agujas); color entre marrón rojizo, el amarillo e incluso incoloros; indica una situación patológica o concentraciones elevadas de acido úrico; un sedimento normal 0-2/campo.
- Cristales de oxalato cálcico mono-hidrato y di hidratado: en orinas ácidas y ligeramente neutras; menos frecuente; de forma prismas incoloros -casi nunca aislados- unidos por un punto intermedio (pesas de gimnasia), la mas frecuente es de forma sobre; también los hay de forma redondeados, finamente estriados, incoloros y con una depresión central (radios de bicicleta); un sedimento normal 0-2/campo.
- Uratos amorfos: en orinas ácidas; se presentan como un precipitado amorfo, coloreado debido a la presencia de pigmentos urinarios de color amarillo-naranja (color ladrillo); no tiene mucha importancia clínica.
- Cistina: en orinas ácidas; tiene significación clínica por si solos => aparecen como consecuencia de cistinuria; aspecto incoloro con forma de placas hexagonales, regulares finas y transparentes; es imprescindible una vez observados en el sedimento, confirmar la concentración de cistina en la orina.
- Leucina y tirosina: en orinas ácidas; raramente se observan; son productos finales del metabolismo proteico y suelen aparecer juntos en situaciones clínicas graves => destrucción o necrosis tisular importante, fundamentalmente de tejido hepático (hepatitis, cirrosis, etc.); los cristales de tirosina forman manojos de agujas finas y los de leucina son como gránulos esféricos de estrías radiales y concéntricas, de aspecto oleoso o graso y muy refringentes; ambas son de color amarillo o marrón.
- Cristales de bilirrubina: en orinas ácidas; de pacientes con bilirrubinemia (bilirrubina alta en sangre); de forma agujas con color marrón-rojizo (flecha verde).
- Uratos amoniacos: en orinas muy alcalinas; de color amarillo/marrón muy intensa; predomina la forma esférica de distinto tamaño; no tienen mucha importancia clínica, pero pueden estar asociados a infecciones del tracto urinario, por bacterias con ureasa+.
- Carbonato cálcico: en orinas alcalinas o neutras; no es frecuente y no tiene mucha importancia clínica (procedencia de ingesta vegetales); de forma amorfo o granular, en ocasiones como pequeños lazos y raramente como pequeñas esferas incoloras;
- Fosfato cálcico (hipurato cálcico): en orina alcalina o neutra; no es frecuente; de forma prismas largos y afilados (agujas), en ocasiones se agrupan formando rosetas o estrellas, también como placas granulares, amorfas e incoloras (similares a acido úrico); no tiene mucha importancia clínica, pero puede ser ligada a hipertrofia de próstata o algunas infecciones urinarias crónicas; cálculos urinarios contienen fosfato cálcico.
- Fosfato triple (amónico-magnesico-cálcico): frecuente en orinas alcalinas o neutras; de forma tapa de ataúd, aunque también puede verse como octaedros (muy variable); no tiene mucha importancia clínica.
- Cristales de creatina: raramente encontrados en orinas de adultas, pero es frecuente en orinas de niños y niñas antes de la pubertad; es un metabolito de la degradación endógena del tejido muscular (su aumento => distrofias musculares, poliomielitis, etc.); de forma pseudo-hexagonal característica.
- Fosfato amorfo: en orinas alcalinas; de semejante forma a uratos amorfos, pero de color blanquecino.
1. debe preceder por el estudio de "anormales" en orina (tiras reactivas => pH, densidad y características patológicas)
2. deben observarse al microscopio optico (40x) al menos 10 campos.
3. debe proporcionar una visión del valor medio de cada elemento o estructura, obtenido en todos los campos observados.
4. debe ser "escueto" y "conciso" (solo hay que poner lo verdaderamente importante)
5. debe seguirse un orden => hay que informar primero el examen realizado de citológico, segundo el de químico y por ultimo el de microbiológico.
Examen citológico:
- celulas hematológicas => se redactan con números y abreviaturas (p.ej. 6-8 L/C = no.leucocitos por campo); se informa si existe piuria y hematuria y si se forma acúmulos.
- celulas epiteliales => se redactan con adjetivos: escasas (algunas 1-3) - moderada (3-4) - abundante (6-8) - intensa (muy abundante 10-12); las importantes son las renales y las de transición; las celulas escamosas (de las vías bajas), se informan cuando son abundantes.
- cilindros: se redactan al igual que las celulas; es importante identificarlos e indicar en el informe el tipo de cilindro.
Examen químico (en un sedimento de orina normales, es frecuente no incluirlos en el informe):
- cristales => se redactan con adjetivos; cuando son muy abundante, se habla de "diatesis".
- compuestos amorfos => se redactan con adjetivos
Examen microbiológico:
- bacterias => se redactan con adjetivos; es necesario especificar el tipo de m.o. y su movilidad
- levaduras => se informa con adjetivos.
Examen microbiológico de una muestra de orina - en condiciones normales carecen totalmente de flora bacteriana; la infección del tracto urinario es frecuente y la mayoría de m.o. patógenos proceden de la flora intestina => Bacilos Gram- (E.coli, Proteus spp, Pseudomonas aeruginosa, Klebsiella pneumoniae); Cocos Gram+ (Streptococcus grupo D y Staphylococcus); Levaduras (Candida spp.); la toma de muestra debe ser obtenida en condiciones asépticas en un recipiente estéril, evitando en todo momento la contaminación; el paciente debe ser instruido de la forma mas adecuada.
Análisis de microbiológico (urinocultivo)
1. Preparación de un "inoculo"
2. Sembrar en medio Cled (la ausencia de electrolitos, impide la invasión por proteus); McConkey (un medio selectivo y diferencia para m.o. Gram-); agar Cetrimide (eficaz para la búsqueda de pseudomonas)
3. Incubar a la temperatura optima de crecimiento de los m.o. buscados (generalmente a 37ºC)
4. Realizar el recuento tras la incubación (presumible-mente han crecido los causantes de la infección) => menos de 10.000 mo/ml de orina es negativo; mas de 100.000 mo/ml hay infección urinaria; entre 10.000 y 100.000 mo/ml el diagnostico es incierto; puede haberse infección no detectada por causas => un tratamiento ATB instaurado, una obstrucción a nivel de las vías renales o la muestra recogida por una punción supra-púbica (sin pasar por la uretra, donde esta la infección).
5. Una vez determinada la infección, hay que resembrar en medios selectivos, para proceder la identificación (tipación) del germen causal de la misma.
Tema 18 - Cocos aerobios y anaerobios facultativos (patología e identificación)
Gram+ => Micrococaceae (Staphylococcus - Micrococcus - Stomatococcus - Planococus); Streptocococeae (Streptococcus - Pediococcus - Gemella - Aerococcus); Peptococaceae
Gram- => Neisseriaceae (Neisseria - Branhamella - Moraxella)
Staphylococcus => cocos Gram+ inmóviles, aerobios y anaerobios facultativos, tamaño +/- 1 um; en forma de racimos, catalasa+, gelatinasa+, nitratasa+, fermentadores de muchas azucares (via EMP); no capsulados y resiste al calor; crecen en medios generales y medios con alto contenido de NaCl (halófilo); resistentes a agentes externos, distribuidas ampliamente en la naturaleza, flora normal de las mucosas y la piel, causante de la intoxicaciones alimentarias, heridas, etc.
Especies importantes (existe >25 especies y varios sub-especies/ cepas)
(1) S. aureus (saprofito de >40% de fosas nasales y 10% de vaginas) => estafilococo dorado (pigmento amarillo); coagulasa+; fermenta el manitol; sensible a la novobiacina.
- 30 Ags (propiedades antifagocitarias y producen estructuras piógenas/ características en las lesiones: polisacárido A es el mas importantes - inducen la formacion de Acs; proteína A - un potente agente antigénico) => se subdividen en tipos según sus caracteres antigénicos;
- Produce toxinas (hemolisinas - lisan eritrocitos y leucocitos; t.exfoliativa/ exotoxina - causa eritemas en la piel; leucopidinas - destruyen pmn y macrófagos; enterotoxina - anula la acción del jugo gástrico y actúa en el centro del vomito, nauseas y diarreas);
- Fermentos/enzimas (coagulasas - activa la protrombina; fibrinolisinas o estafiloquinasas - activador del plasminógeno; penicilinasas o beta-lactamasa - romper el anillo b-lactamico de las penicilinas creando resistencia);
- Hemolisinas alfa - provoca hemólisis beta en AS; hemolisina beta - provoca hemólisis alfa en AS;
- Enterotoxinas tipo A, B (causan intoxicaciones alimentaria) y D causa enterocolitis;
La acción patogena directa => procesos inflamatorios, forunculos, supurativos y de necrosación (en heridas y quemaduras); indirecta => afecta al tubo digestivo por la entero-toxina (gastroenteritis con nauseas, vómitos y diarreas, duración 1-2 días, se trata con sueros orales o anti-diarreicos); la bacteria no llega al intestino (solo su toxina), por eso no se encuentra en las heces; crece muy bien con la temperatura veraniega y en las cremas; infección generalizada (septicemia) => formación de coágulos o trombos intravenosos, artritis, pleuritis, endocarditis, osteomielitis o meningitis en los debilitados (periodo de incubación 1-6 horas).
(2) S.epidermidis y (3) S.saprophyticus son estafilococos oportunistas; distribuidas en el medio ambiente, la piel y mucosas; son patógenas en debilidad; S.saprophyticus puede tener pigmento dorado y puede fermentar Manitol; S.epidermidis sensible a la novobiocina (lo que le diferencia a S.saprophyticus).
Aislamiento de los estafilococos:
- Muestra procede de las heces => medios selectivos Chapman, ricos en NaCl (carácter halófilo), contiene manitol (diferencia S. aureus del resto de Staphylococcus); Otros tipos de muestras => medio AS (observar características de las colonias - color, hemólisis, etc).
Pruebas bioquímicas:
- Los estafilococos degradan muchas azucares (glucosa, sacarosa, fructosa, manosa, etc.); produce gelatinasa+, catalasa+, nitratasa+, crecen muy bien a 37ºC, hemolisina alfa y beta, coagulasa+ (S.aureus).
Diagnóstico bacteriológico:
- Toma muestra con torunda estéril o por punción según los casos en total asepsia; tinción Gram; aislamiento en medio Chapman/manitol salado y AS, tras la incubación observar las colonias; pruebas bioquímicas - coagulasa (S.aureus), fermentación de glucosa, catalasa, gelatinasa, hemolisinas alfa y beta (cepas patógenas), fibrinolisinas, fermentación del manitol (S.aureus); estudio de la sensibilidad a la novobiocina (diferenciar S.epidermidis de S.saprophyticus)
- Diferenciacion del genero Staphylococcus y Micrococcus (en principio no es patogeno) => Staphylococcus sensible a bacitracina y eritromicina; Micrococcus a veces pueden dar oxidasa+.
- Estafilococos coagulasa- es un grupo heterogéneo (+ importante son S.epidermidis y S.saprophyticus) 80% en el pasado no causan infecciones importantes, pero cada vez esta tomando mas importancia; ademas muestra resistencia a varios ATB alternativa de penicilina (meticilina y cloxacilina); pueden producir infecciones urinarias, bacteriemias (por la implantación de cateteres i.v.) y endocarditis.
Streptococcus => cocos Gram+, tamaño pequeño, capsulados, anaerobios facultativos, se agrupan en cadenas, fermentador de glucosa, son saprofitos, oportunistas y algunos patógenos; poseen Ags (polisacárido C - según sus características, se clasifican en grupos A-V de Lancefield; proteína M antifagocitarias, la posee el grupo A)
Clasificacion
A. según el tipo de hemolisis (capacidad de romper hematíes - produce hemólisis alrededor de sus colonias en AS) => gamma hemolítico, alfa hemolíticos/ hemólisis parcial (decoloración parda verdosa - S.viridans); beta hemolíticos/ hemólisis total (halos de transparencia grandes entorno a su colonia) - grupos A, B, C, D (enterococo) G y F; estreptococo NO Beta-hemolíticos - grupo D, S.viridans y S.pneumoniae (alfa y gamma)
B. según sus caracteres bioquímicos (sensibilidad a bacitracina, optoquina, tolerancia a NaCl, degradación de bilis esculina y factor CAMP):
- Sensible a bacitracina (grupo A)
- Crecimiento en NaCl 6,5% (grupo D enterococos)
- Factor CAMP => potenciar la acción hemolítica de S.aureus (lo produce grupo B)
- Pruebas de bilis esculina - hidrolisan este compuesto (grupo D enterococos)
- Sensible a optoquina (S.pneumoniae /neumococo)
- Hidrólisis de hipurato sódico (grupo B)
C. según los caracteres antigénicos (a traves de reacciones serologícas especificas => aglutinación, precipitación, inmunofluorescencia, etc.) => los Ags en la pared celular (péptido glicano - toxica y facilita la unión de ellos a las células epiteliales invadidas; polisacárido C - distintas características que confiere la agrupación de los estreptococos (grupos de Lancefield);
- Grupo A (la + importantes) => la mayoría son Beta-hemolíticos y patogenos al hombre; proteína M se presenta como pelos en el perímetro de la pared celular (anti-fagocitarías).
- En las capsulas del grupos A y C se encuentra enzima hialuronidasa (características anti-fagocitarías)
Acción patógena e Interés clínico:
(1) Streptococcus del grupo A (S.pyogenes) => causan 90% de las infecciones estreptocócicas; muy sensibles a los agentes externos; son floras de la mucosa nasal y faríngea; poseen polisacárido C (proporciona la especificidad de grupo) y proteína M (facilita la adherencia a las células invadidas y protección a la fagocitosis); son Beta-hemolíticas, sensibles a la bacitracina y variable a optoquina
- Poseen hemolisinas estreptocócicas/ estreptolisinas (O y S); estreptolisina S (poco antigénico) => holoproteína toxica responsable de hemólisis en medio AS; estreptolisina O (muy antigénico) => hetero-proteína exotóxica muy activa de efecto hemolítico frente a glóbulos rojos y leucocitos (pmn y macrófagos => alterando la estructura celular); induce a la formación de Acs ASLO.
- Produce toxina eritrogénica responsable del exantema de la fiebre escarlatina;
- Enzimas estreptoquinasas (activador de plasminógeno => plasmina en fibrinolisis); induce a la formación Acs; se utiliza en el hospital en procesos trombo-génicos.
- Enzima desoxirribonucleasa estreptocócica (despolimeriza ADN); son antigénicas y se distingue en 4 grupos (A-B-C-D).
- Enzima Hialuronidasa (hidroliza el acido hialurónico del tejido conjuntivo); facilita su invasión.
- Proteinasa estreptocócica (origina procesos inflamatorios y necrosación)
Patogenicidad de S.pyogenes (grupo A) => Infecciones en la piel o mucosas (+frecuentes - anginas/faringitis sobre todo a niños/contacto directo, otitis y sinusitis) 95% de infecciones naso-faringeas son producidas por estreptococos del grupo A; infecciones NO supuradas/ inmunológica => fiebres reumáticas (complicaciones de tto no adecuados), glomerulonefritis, endocarditis, meningitis, sepsis.
(2) Streptococcus del grupo B (S.agalactiae) => saprofito del hombre en rino-faringe, uro-genital, vaginal e intestinal; produce infecciones oportunistas; hipurato+ (degrada el hipurato sódico) es lo que le diferencia del grupo A; posee factor CAMP (potenciar la acción hemolítica de S.aureus); puede origina meningitis e infecciones pulmonares en el neonato, infecciones del tracto respiratorio, mucosas, piel, etc; son Beta-hemoliticos, resistente a la bacitracina;
(3) Streptococcus del grupo C => es el mas proximo al grupo A; son Beta hemolíticos (también alfa y gamma) y muy sensible a los agentes externos; resistente a la bacitracina; crecen en medios salinos (NaCl 6,5%); posee enzima hialuronidasa; saprofito del hombre en la rinofaringe; puede producir mastitis en vacas, muermo en caballos y sepsis ??? en el hombre.
(4) Streptococcus del grupo D => son alfa, beta y gamma hemolíticos; resistentes a agentes externos y ATB;
- los enterococos => S.faecalis y S.faecium; son saprofitos del intestino del hombre; crecen bien en NaCl 6,5% (a diferencia de los NO enterococos); hidrolizan la bilis esculina; son alfa-beta-gamma hemolíticos; resistente a la bacitracina; puede producir infección urinaria e herida.
- los No enterococos => S.bovis, S.equinus y S.anginosos (afecta vacas y caballos); hidrolizan la bilis esculina; resistente a la bacitracina;
(5) Streptococcus del grupo G, F y E => saprofitos de la rinofaringe, vias genitales e intestino en el hombre; pueden producir infecciones en vias urinarias, heridas; resistente a la bacitracina; son alfa y beta-hemolíticos; crecen variable en medios salinos (NaCl 6,5%)
(6) Streptococcus Alfa hemoliticos (S.viridans) => no son capsulados; producen alfa y gamma hemolisis; saprofitos de la orofaringe, mucosa bucal, placa dental (caries); resistente a la optoquina;
(7) Streptococcus pneumoniae (neumococo) => es un grupo a parte; diplococos, Gram+ y son capsulados; muy sensibles a medios externos; son alfa y gamma hemolíticos; sensibles a optoquina; crecen variable en medios salinos (NaCl 6,5%); saprofito en aparato respiratorio; puede producir neumonias, inflamaciones sinusitis, otitis y meningitis (mas frecuente en adultos);
Aislamiento:
- toma de muestra con total asepsia de la rino-faringe con hisopo estéril, una muestra del pus (si hubiera); se analiza de inmediato (estreptococos son sensibles a medios externos);
- un frotis para la tinción de Gram; si se sospecha S.pneumoniae se realiza una tinción negativa con tinta china y prueba de "Quellung" (determinar Ags de la capsula); se produce una reacción de Quellung cuando un Acs tipo específico se une al polisacárido capsular del neumococo y causa un cambio en el índice refractivo de la cápsula haciéndola aparecer “hinchada” y más visible.
- la siembra en AS-CNA (posibles hemólisis - estreptococos son resistentes a nalidixico que inhibe el crecimiento de otros gérmenes); realizar hemocultivos si se sospecha endocarditis o sepsis; las colonias son grisaceos, redondos de bordes lisos y pequeños; medios selectivo y diferencial con NaCl 6,5% => permite el crecimiento de enterococos del grupo D.
Pruebas bioquímicas:
- pruebas de catalasa-, hemolisis en AS, sensibilidad o no de optoquina y bacitracina; hidrolisis de hipurato (positivo en el grupo B), utilización de bilis esculina.
- identificar los grupos antigénicos según el tipo de sustancia polisacárido C (clasificación de Lancefield) por metodo serológicos => prueba de látex (romper la capsula para sacar la sustancia; reacción inmuno-complejo Ag-Ac).
- los Gram+ en general son sensibles a la vancomicina excepto algunos cocos Gram+, catalasa- que no son estreptococos (Pediococcus es resistente a la vancomicina).
Pruebas serologícas / inmunologicas:
- la búsqueda en el suero (dilución seriadas) del paciente de Acs frente a toxinas y enzimas de estreptococos (sobre todo grupo A) => títulos de Acs antiestreptolisinas O (ASLO); para saber si la infección es aguda o creciendo; en caso de fiebres reumáticas con títulos de ASLO negativos, se determinan los títulos de Acs antiestreptoquinasas (ASK), antihialuronidasas (ASH); pruebas de hinchamiento capsular con suero antineumococico polivalente (prueba de Quellung) muy utilizado para determinar S.pneumonia => se añaden Acs contra Ags capsulados, si hay aglutinación es signo de que esta estreptococo.
Neisseria => cocos Gram-; en forma de diplococos (granos de café), aerobios; son saprofitos de mucosas (genitales, faringe, fosas nasales) y cavidades del hombre y los animales; citocromo-oxidasa y catalasa+; utilizan azucares con metabolismo oxidativa y fermentativa; producen pigmentos carotenoides; nutricional-mente exigentes; sensibles a medios externos.
Especies mas importantes - 4 géneros => Neisseria, Branhamella (B.catharralis), Acinetobacter y Moraxella.
(1) Neisseria meningitidis (meningococo) => es una especie patógena para el hombre; son parásitos obligados del hombre (no se encuentran libre en la naturaleza); es difícil de cultivar si hay competición (acompañadas por otros gérmenes); son capsulados; utiliza glucosa y maltosa; posee fimbrias (facilita su adherencia) y capsulas (contiene polisacáridos con comportamientos serológicos diferentes A,B,C, etc.); crecen a 35-37ºC; son muy sensibles a medios externos; producen meningitis epidémico (contagio por gotas de flugge en contacto íntimos); otros causantes de meningitis => Haemophyllus influenzae, Streptococcus agalactiae, Escherichia coli, Pseudomona aeroginosa, Micobacteria, Neisseria meningitidis, Cryptococcus neoformans y otros.
(2) Neisseria gonorrhoeae (gonococo) => idénticas características que meningococo; utiliza glucosa como fuente de carbono; requieren medios enriquecidos con CO2 5-10% para potenciar su crecimiento a 35-37ºC; son muy sensibles a medios externos y son parásitos estrictos del hombre y produce gonorrea (no se encuentra libre en la naturaleza);
(3) Neisseria saprofitas => saprofitos de la rino-faringe y genitales; son poco exigentes y crecen a 22-35ºC en medios generales; resistentes a medios externos y no son patógenos para el hombre.
Acción patógena e interés clínico
Neisseria meningitidis (meningococo) => diplococos /granos de café; coloniza las mucosas y vías respiratorias (sobre todo superiores); 5-30% son portadores sanos en rino-faríngeo; afectan a niños de 6 meses hasta 5 años (causas mas importantes de mortalidad infantil); también afectan niños mayores y adultos jóvenes de 6 hasta 25 años; estructura antigénica => componentes de su capsula (polisacárido), las fimbrias (facilitar la adherencia y la invasión) y proteínas de la membrana (toxica sobre las celulas invadidas);
Cuadro clínico - comienza con una rino-faringitis de sintomatología leve (sobre todo en niños - en adultos se forman Acs anti meningococo) evoluciona a forma severa, se complica con bronquitis; si el meningococo pasa a la sangre, originara micro-focos en la piel con erupciones petequiales (1-2mm) en el tronco e extremidades inferiores, cefaleas, fiebres altas, artralgias; puede pasar a LCR con fiebres muy altas, cefaleas fuertes, rigidez de nuca, vómitos, diarreas, etc.; se agravan hasta la muerte sin tto efectivo y rápido; el examen LCR es turbio, purulento con abundantes meningococos (debido a acumulación de pmn con meningococo dentro (celulas CLUE); tto con penicilina (G) - el tto del portador es rifampicina.
Neisseria gonorrhoea (gonococo) => idénticas características que el meningococo; su afinidad particular es sobre las mucosas uro-genitales, con fimbrias (adherencia a las celulas epiteliales dificultando la fagocitosis); posee endo-toxina que inactiva Acs próximos; produce gonorrea en hombres y mujeres (ETS);
Cuadro clínico - tras un contacto sexual, los gonococos se adhieren a la superficie de la mucosa gracias a las fimbrias y proteínas de la membrana; posteriormente se penetran a tejidos sub-epiteliales y empiezan a multiplicarse, liberando endo-toxina con efecto toxico a la uretra, cuello del útero, ano (donde colonicen), produce la destrucción de celulas del epitelio y supuración (secreción purulenta) y dolor a la micción; en las mujeres puede ir acompañada por uretritis, vaginitis y 20% salpingitis de las trompas (produce esterilidad en mujeres); 50% de los casos son asintomáticos con lo que la ausencia de tratamiento conduce a la cronificación; puede provocar bacteriémia dando artritis supurativos; tto => penicilina o sus derivados; en neonatos provoca gonococia ocular que conduce a la ceguera - se previene instilando gotas de nitrato de plata - método de "Crede" y (contra Chlamydia es mas efectivo) eritromicina???
Aislamiento - caracteres bioquímicos - diagnostico
N.meningitidis - toma de muestra de LCR (punción lumbar), sangre y/o exudado faringeo; se deben examinar de lo antes posible (sensibilidad al medio externo); se transporta en un medio de Thayer-Martin modificado a 37ºC (en caliente); si la muestra de LCR es turbio o purulento, se divide en 2-3 tubos; 1er tubo se centrifuga y sobre el sedimento se realizan frotis Gram; 2nd tubo se utiliza para la siembra en AS, agar chocolate, Mueller Hinton y Thayer-Martin; 3er tubo se realiza un hemocultivo y recuento celular; meningococo crecen dando colonias transparentes diminutas y no hemolíticas; las placas se incuban a 37ºC en ambiente de CO2 5-10%.
- Pruebas bioquímicas => catalasa+, oxidasa+, prueba de la utilización de glucosa y maltosa por oxidación (aerobio), lactosa-, nitratasa-.
- Estudios serológicos => inmunofluorescencia directa del LCR o el suero, contrainmuno-electroforesis y técnica ELISA.
- Existe sistema de multi-prueba para Neisseria y Haemophylus.
N.gonorrhoeae - toma de muestra a partir de la uretra (hombre), recto en homosexuales y uretra, cuello de útero y recto (mujer), se realizan en el laboratorio (sensibilidad a medio externo), por la mañana antes de la primera micción (al ser posible); se procede de inmediato al estudio directo y la siembra en medios específicos o se transporta en medio TM modificado.
- se realiza la tinción (Gram- en forma de granos de café); en el frotis se ven los pmn con diplococos dentro; la siembra se hará en AS, agar chocolate, Thayer-Martin (con factores de crecimiento y ATB vancomicina, anfotericina, colistina y trimetropin que inhibe el crecimiento de otros gérmenes); en TM los gonococo son colonias pequeñas de color gris y los meningococo son blanquecinas se incuba a 35-37ºC y atmósfera enriquecida de CO2 5-10%;
- Pruebas bioquímicas => utilización de azucares por vía oxidación (glucosa+, lactosa, maltosa+ para meningococo, y sacarosa); oxidasa y catalasa son positivos, nitratasa-.
- Pruebas serologícas => hemo-aglutinación, inmunofluorescencia indirecta, ELISA (mas utilizadas)
- Sistema de identificación multiprueba para Neisseria y Haemophylus.
Neisseria saprofitos (Neisseriaceas) - normalmente son flora de oro-faringe/ naso-faringe; son especies de bajo patogenicidad, aunque a veces implicadas en meningitis y otros; no requieren medios especiales para su crecimiento.
- Branhamella catharralis / Moraxella catharralis => hoy en día la clasificación es confusa (la tendencia - dentro de la familia moraxellacea), otros autores tienden a diferenciarla y la clasifican como familia Branhamellaceae; es Gram-, oxidasa+, catalasa+, nitratasa+ (reducen nitratos a nitritos), no fermentan azucares, crecen bien en medios generales (AS, agar chocolate y Thayer Martin), son aerobias o 5% de CO2; flora normal de naso-faringe, pero a veces se aísla como agente causal en septicemias e infecciones otorrinolaringológicas (sinusitis, otitis).
- Acinetobacter => anteriormente clasificada dentro de la familia Gram- no fermentadoras (pero oxidasa- => bacteria inerte) junto con Pseudomonas; actualmente esta incluido dentro de la familia Moraxellaceae; son microorganismos que pueblan fundamentalmente suelos y aguas y presentes en medios hospitalarios (infección nosocomial); la especie mas importante => A.calcoaceticus (causan neumonías, infecciones urinarias y sepsis); crecen en Mac, AS y otros; en AS producen colonias grises con halos de hemólisis, oxidasa-, catalasa+, son cocobacilos Gram- (se pueden confundir con Neisserias por su tamaño).
- Moraxella => coco-bacilo, Gram-, no fermentador, inmóvil, oxidasa+, catalasa+, difícil de distinguir con Neisseria; en general los no fermentadores son muy difíciles de distinguir y requiere numerosas pruebas bioquímicas para etiquetarlos.
Tema 19 - Entero-bacterias y vibrios (patología e identificación)
Entero-bacterias - bacilos o coco-bacilos Gram-, aerobios y anaerobios facultativos, móviles (flagelación perítrica) o inmóviles, fermentadoras de glucosa (con o sin producción de CO2), oxidasa-, catalasa+; algunos usan metabolismo fermentativo y otros usan metabolismo oxidativo; la mayoría son nitratasa+; algunos son sulfuhidratasa+ (Proteus y Salmonella), indol+ (E.coli); son saprofitas/ flora del tracto gastrointestinal del hombre y de los animales; también se encuentra en el agua y en el suelo; resistentes a medios externos; son potencialmente patógenos en individuos debilitados y produce infecciones oportunistas; algunos son patógenos siempre donde sea se encuentra, otras depende de la muestra donde se aísla y el resto se cuestiona su papel.
Características antigénicas:
- Ag somático / Ag O => es lipo-polisacárido, termo-estables, se encuentra en la pared bacteriana, es una endo-toxina (la parte polisacárido es muy antigénico y la parte lipídica es inactiva bioquímica-mente).
- Ag capsular / Ag K => se encuentra en la capsula bacteriana, es polisacárido, es anti-fagocitarías (relacionado con la virulencia de ciertas especies como E.coli K-1 y Salmonella thyphi).
- Ag flagelar /Ag H => es característico de las cepas móviles, es proteico y responsable de la acción patógena de la bacteria.
Clasificación según su capacidad para fermentar la lactosa:
- Fermentadoras rápidas de lactosa (coliformes) => Escherichia, Enterobacter y Klebsiella (tardía a veces)
- Fermentadoras lentas de lactosa / ONPG+ (coliformes) => Citrobacter, Serratia, Hafnia, Yersinia (patógeno) y Shigella sonnei.
- NO fermentadoras de lactosa (no coliformes) => Salmonella, Shigella, Proteus, Morganella, Providencia y Edwardsiella.
Salmonella - entero-bacterias no coliformes, móviles con flagelación perítrica; bacilos Gram-; en general provocan infecciones entérico febriles (gastroenteritis, entero-colitis o fiebres tifoideas o para-tifoideas).
Especies importantes - S.typhi, S.choleraesuis, S.enteritidis, S.paratyphi A,B y C, S.arizonae.
Acción patógena e interés clínico
- Ag somático O, Ag flagelar H y Ag capsular VI (en S.typhi - Ag termolábil con poder protector frente a los ácidos /ácida gástrica, resistencia y anti-fagocitarías)
- endo-toxina y enterotoxina (efecto irritante y citotóxico sobre el tracto intestinal)
Cuadros clínicos
1. Infecciones entéricas (S.typhi - fiebres tifoideas o S.paratyphi A,B o C - para-tifoideas); Las fiebres tifoideas son transmitidas al hombre vía oral (alimentos crudos, poco hechos, mal conservados y aguas contaminadas), llega al estomago, resiste la acidez gástrica, pasa al intestino delgado (íleon), penetra por endocitosis destruyendo parte de las celulas de la mucosa intestinal; una vez dentro las salmonellas son fagocitadas por macrófagos y transportadas por diferentes vías y provoca bacteriémia => todo sucede en el periodo de incubación (8-15 días); comienzo brusco de signos y sintomas => los macrófagos les transportan hacia el bazo, higado y MO, produciendo multiplicación de nuevas salmonellas, volver al intestino generando placas ulceradas, necrosación de placas de Peyer y en casos mas graves originar perforación y hemorragias.
Las fiebres para-tifoideas son mucho mas leve con un periodo de incubación de entre 7-10 dias con bacteriémia y estado febril que dura varias semanas; no hay perforación intestinal ni hemorragias ni invasión de salmonellas a otros órganos; cuadros clínicos => dolores de cabeza, fiebres altas, anorexia, astenia/ cansancio; preciso un tratamiento que dura 9-10 días.
2. Infecciones gastrointestinales y enterocolitis (S.enteritidis - la mas frecuente, S.choleraesuis, S.typhimurium y otras); periodo de incubación 12-36 horas; se transmite por alimentos contaminados con una concentración de salmonellas de 10 millones a mil millones/ml, depende de tipo de la cepa; el alimento les facilita su llegada a pasar el estomago y llegar al intestino delgado colonizando el íleon y el ciego, se penetran por fagocitosis al epitelio y se multiplican originando una inflamación que genera cuadros diarreicos con dolor abdominal (perdidas de electrolitos y agua), fiebres altas, nauseas, vómitos; re quiere un tratamiento de re-hidratación que dura 6 días - las floras se encargan de eliminarlas.
Aislamiento - pruebas bioquímicas - diagnostico de Salmonella
Salmonelosis => toma muestra de las heces (coprocultivo), análisis del alimento sospechoso; medios de cultivo SS, McConkey, caldo selenito; pruebas bioquímicas: ONPG-, TDA-, Citrato+ (S.cholera-suis y S.enteritidis, tambien son CO2+ y Ornitina descarboxilasa+), SH2+, fermentacion de azucares: Glucosa+, Trehalosa+ (S.typhi y S.enteritidis), etc.
Fiebres tifoideas y para-tifoideas => toma muestra de diferentes localización según la fase de enfermedad; en la fase de incubación se busca en heces (coprocultivos), en orina (urocultivo), sangre (hemocultivo); en la fase inicial de la enfermedad / periodo febril, se realiza hemocultivo; en el periodo posteriores o finales se busca en heces (coprocultivo); medios adecuados; se realiza las pruebas bioquímicas, reacciones de aglutinación cuantitativa (títulos) de Ags O, H y VI a traves de sueros específicos monovalentes y polivalentes, especialmente para Ag VI (pruebas inmunológicas).
Mucaptest => prueba inmunológica utilizando suero polivalente (Acs anti O y anti H), un resultado positivo dara unas colonias fluorescentes (posible Salmonella).
Shigella - bacilo Gram- inmóvil, no fermentador de lactosa (excepto S.sonnei) ; son patógenas para el hombre, provoca afecciones graves y contagiosas sobre el tracto gastrointestinal (disentería bacilar) especialmente en ambientes de salubridad baja.
Acción patógena e interés clínico - se debe a la producción de sustancias toxicas, Ags O y K, plásmidos (facilita la invasión), adhesinas (adherencia a las celulas que invaden), exotoxina con propiedades cito-toxicas (tipo A - origina necrosis celular, ulceras, hemorragias y perforación), neuro-toxicas y entero-invasivas (tipo B - adherencia a las celulas del epitelio gastrointestinal); al llegar al intestino del hombre vía oral (puede resistir el acido gástrico, por la alta cantidad ingerido y también protegido por los alimentos), ejerce su acción toxica, pasar al colon originando necrosis con signos y sintomas características (las toxinas de S.disenteriae no suelen pasar a la sangre); cuadros diarreicos van acompañados de dolor cólico, nausea, vómitos, malestar general y fiebres muy altas con deposiciones sanguinolentas con moco y pus.
Aislamiento - pruebas bioquímicas, diagnostico de Shigella
Toma muestras de heces recién emitidas en los primeros días de la enfermedad (hay mayor numero de shigellas), eligiendo restos de moco y sangre si los hubiera; el estudio riguroso (teniendo en cuenta que Shigella se destruye en medios ácidos y a temperaturas <4ºC; medios de cultivos SS, McConkey, Hektoen, Yersinia CIN, Campylosel, TCBS; pruebas bioquímicas TDA, KIA (K/A para Shigella y A/A para S.sonnei), ONPG (positivo para S.sonnei), fresco, ureasa-, VP-, nitratasa+, manitol (positivo para Shigella y negativo para S.disenteriae); pruebas de aglutinación cuantitativa (titulo) para demostrar Acs en el suero del paciente a traves de sueros específicos mono y polivalentes.
Escherichia - entero-bacterias bacilar o coco-bacilar Gram- móviles, fermentadoras de glucosa y lactosa, produce CO2, aguantan temperaturas altas (la diferencia de otros coliformes), resistente a medios externos, fácil de encontrar en el agua, alimentos (indicativo de contaminación fecal reciente); saprofito de flora aerobia y anaerobia facultativa del tubo digestivo; puede provocar trastornos gastrointestinales de diarrea, infecciones urinarias, meningitis en neonatos y excepcionalmente bacteriémia; la especie mas importante para el hombre es E.coli (según la cepa puede tener Ag somático O, capsular K y flagelar H, fermentos y endo-toxinas).
Acción patógena e interés clínico - los cuadros clínicos son variables según el tipo de toxina que originen; algunas cepas de E.coli forman Ag O y K anti-fagocitarías y resistencia a bactericidas y ATB (alto poder invasivo); otras cepas forman endo-toxinas, causante de cuadros febriles y diarreicos; otras cepas tienen un mecanismo de acción análogo al de Shigella con menor gravedad; a veces la entero-toxina que producen es parecida a la de Vibrio cholerae que causa perdida masiva de agua y electrolitos.
- si la cepa de E.coli forma una entero-toxina citotóxica parecida a Shigella => cuadros diarreicos en brotes epidémicos que afectan a niños y lactantes (E.coli entero-patógena)
- si forma una entero-toxina semejante a Vibrio cholerae => procesos diarreicos en niños, adultos, originándose esporádica-mente brotes epidémicos (diarrea del viajero - E.coli entero-toxígena)
- si forma una entero-toxina citotóxica similar a S.disenteriae => procesos diarreicos graves, hemorragico esporádicamente en brotes (E.coli entero-hemorragica)
- si presenta ciertos plásmidos que incrementan su capacidad de invasión => cuadros diarreicos graves que afectan a niños, adultos con brotes epidémicos en casos aislados (E.coli entero-invasiva)
Las cepas de E.coli se distingue con sueros antigénicos; E.coli también puede provocar infecciones urinarias (cistitis, pielonefritis, etc), infecciones biliares, heridas, meninges (meningitis en neonatos).
Aislamiento, pruebas bioquímicas - diagnostico
Toma de muestra representativa de alimento, agua, heces, exudado; frotis de Gram; medios de cultivo Mc, Levine; pruebas bioquímicas => lactosa+, indol+, citrato-, sensible a la Colistina.
Yersinia - entero-bacterias muy patógenas para el hombre (Y.pestis - causante la peste bubónica); son coco-bacilos Gram-, móviles a 25ºC con flagelación perítrica e inmóviles a 37ºC, fermentadores de glucosa (ONPG variable), capsuladas (Y.pestis) y oxidasa-.
Especies mas importantes - Y.pestis (agente etiológico de la peste bubónica en el hombre) trasmitida a traves de ratas y pulgas, originando enfermedad grave febril, epidémico de alta mortalidad; Y.pseudotuberculosis afecta animales y excepcionalmente al hombre; Y.enterocolitica (sacarosa+ en medio TSI); los 2 últimos afectan mas a animales que al hombre (niños) => originando estados febriles y diarreicos.
Acción patógena e interés clínico de Y.pestis => cuadros agudos y febriles con alta inflamación de los ganglios linfáticos, hemorragias internas, petequias difusas en la piel, en ocasiones septicemia y neumónia; es muy contagiosa, se origina en lugares de salubridad baja; la muerte se produce por shock séptico (fracaso multi sistémico) o por neumónia; factores de virulencia:
- La toxina murina (liberada al medio cuando muera la bacteria) => proteína que bloquea la utilización de O2 por parte de las celulas.
- Endo-toxinas (liberadas en el transcurso de la enfermedad) => origina el proceso febril
- Ag V con propiedades anti-fagocitarías
- Coagulasas y fibrinolisinas
Y.pestis llega al hombre a traves de la picadura de pulga (infectada por ratas con peste), atraviesa los vasos linfáticos, pasa a los ganglios donde se multiplica originando bubones, pasa a la sangre y se disemina por el bazo, higado, pulmones, piel, mucosas, se multiplica provocando lesiones piógenas (toxina murina), hemorrágicas, necrótica y edematosa; en casos graves aparece coagulacion intravascular diseminada (CID) (por la acción de las coagulasas) o diátesis hemorragica (por la acción de las fibrinolisinas), colapso circulatorio, toxemía generalizada y muerte; formas clínicas:
1. Peste bubónica (la mas frecuente); tras el periodo de incubación de 3-7 días después de la picadura, aparecen signos y sintomas con escalofríos, vómitos, formación de bubones en las ingles axilas y/o zonas submaxilares (los tejidos circundantes aparecen inflamados); sin tratamiento se agrava hasta la muerte.
2. Peste pulmonar (es la complicación de peste bubónica); se produce afección pulmonar grave con insuficiencia respiratoria, cianosis; es altamente mortal.
3. Peste septicémica es estadios últimos de la peste en cual quiera de sus formas y es generalmente mortal.
Aislamiento - pruebas bioquímicas - diagnostico
Toma de muestra de exudados purulentos del bubón (por aspiración), de sangre, LCR, tejido pulmonar, nódulos linfáticos o esputo, heces, según los casos; la tinción Gram-, nigrosina (visualización de capsulas); medios de cultivo => Mc, Yersinia CIN (colonias muy pequeñas); pruebas bioquímicas => móvil a 22ºC y inmóvil a 37ºC, Lactosa-, ONPG+, ureasa+, indol y TDA-, oxidasa-, nitratasa+; a veces Y.pestis y Y.pseudotuberculosis son ONPG variable; Y.enterocolitica es sacarosa+.
Entero-bacterias oportunistas - bacilos Gram- aerobios y anaerobios facultativos, poco exigentes nutricional-mente, ampliamente distribuidos en el medio ambiente; son saprofitos de la flora gastrointestinal, resistente a medios externos y ATB; no son patógenos al no ser si el huésped es debilitados, pueden provocar infecciones hospitalario; en la mayoría son lactosa+, bacilos Gram- coliformes;
Principales especies de coliformes/ lactosa+ (Escherichia, Enterobacter, Citrobacter, Serratia, Klebsiella y Hafnia) y no coliformes /lactosa- (Proteus, Morganella y Providencia).
1. Escherichia => Gram- aerobias y anaerobias facultativas, fermentadoras rápidas de lactosa y glucosa, produce CO2, indol+, citrato-, sensible a Colistina, móviles.
2. Enterobacter => fermentadora rápida de lactosa, produce CO2, produce acetoína de la glucosa (VP+), citrato+, móvil, ornitina-descarboxilasa+, son comensales de flora intestinal; puede provocar a individuos debilitados diarreas, infecciones del tracto respiratorio, heridas, etc; especies importantes: E.aerogenes y E.cloacae.
3. Serratia => fermentadora lenta de lactosa (ONPG+) y la glucosa, produce acetoína (VP+), móviles, citrato+, ADNasa+, ornitina-descarboxilasa+, saprofitas del hombre y también en el medio ambiente (agua y otros líquidos), resistentes a ATB y desinfectantes; provoca infecciones urinarias y sepsis a personas debilitadas.
4. Citrobacter (huelen a peste) => fermentadora lenta de lactosa (ONPG+), móvil, fermenta la glucosa y VP- RM+, citrato+; son comensales del tubo digestivo del hombre y puede provocar infecciones urinaria, respiratoria, sepsis, bacteriémias, meningitis a los individuos debilitados; especies importante => C.freundii.
5. Klebsiella => inmóviles, fermentadoras tardía de lactosa, utiliza glucosa y produce acetoína (VP+), citrato+, ureasa+; son comensales del tracto gastrointestinal y vías respiratorias superiores; puede provocar neumonías, rinitis, infecciones urinarias; especies importante => K.pneumoniae (sub especies VP+ y VP-) y K.oxytoca (indol+).
6. Hafnia => móviles a 22ºC y inmóviles a 37ºC, fermentadora lenta de lactosa (ONPG+), citrato+, utiliza glucosa y produce acetoína (VP+); provoca infecciones hospitalarias.
7. Proteus, Morganella y Providencia => NO fermentan la lactosa, pero si glucosa y produce CO2, RM+; móviles, TDA+ (diferenciar del resto entero-bacterias), pueblan aguas residuales, el suelo, materia orgánica y son comensales en la flora intestinal del hombre; pueden provocar infecciones hospitalarias; especies importantes:
- Proteus mirabilis (indol-, ureasa+, TDA+, SH2+), P.vulgaris (indol+, ureasa+, TDA+)
- M.morganii (ureasa+, indol+, TDA+)
- Providencia rettgeri (ureasa-, indol+, TDA+)
P.mirabilis puede provocar infección urinaria, descompone la urea de la orina que genera precipitación de sales cálcicas => formación de cálculos renales; también puede provocar infecciones gastrointestinales, toxinfecciones alimentarias, heridas, etc.
Acción patógena e interés clínico - si el huésped se encuentra debilitado (postoperatorio, tratamiento inmunosupresores) los saprofitos podrían ser patógenos; las infecciones mas frecuentes =>
- tipo urinario (40% de las infecciones hospitalarias - pacientes sondados, encamados, intervencionados quirúrgica-mente) provocado por E.coli, P.mirabilis, P.vulgaris, Klebsiella y Enterobacter, provocando cistitis (de las vías bajas) y pielonefritis (de las vías altas); son infecciones agudas con fiebre, dolor lumbar, polaquiuria o anuria y disuria; es frecuente en los análisis de orina piuria, bacteriuria y proteinuria;
- tipo abdominal son poco frecuente => abscesos y peritonitis debido a perforación intestinal.
- tipo respiratorio (20% de las infecciones hospitalarias) afectando vías respiratorias altas, neumonías y bronco-neumonías (pacientes con afecciones crónicas)
Aislamiento - pruebas bioquímicas - diagnostico
- Toma de muestra según las afecciones o procesos patológicos en condiciones de total asepsia
- Examen directo (fresco y tinción Gram)
- Aislamiento en medios específicos/ selectivos (Hektoen, Mac) que inhiben los Gram+
- Pruebas bioquímicas e inmunológicas
Familia Vibrionaceae - Genero Vibrio, Aeromonas y Pleisomonas (los patogenos)
Especie mas importante y patógeno del genero Vibrio - V.cholerae => bacilos Gram- anaerobios facultativos de morfología curva (pleomórficos), móviles (flagelación lofótrica), crecen bien en medios generales y pH alcalino (sensibles al medios ácidos), oxidasa+ (la diferencia de la enterobacteriaceae), halófilo, catalasa+, afectan al tracto gastrointestinal del hombre; es el agente causal del cólera => provoca diarreas graves hasta llegar a la deshidratación (diarreas masivas), shock hipovolémico, coma y muerte por deshidratación (puede perder hasta 10-15 lt/día de agua y electrolitos); se diferencia de Pseudomonas por la diferencia en el patrón de fermentacion de azucares.
Acción patógena e interés clínico:
- Ag somático O (polisacáridos) se utiliza para su tipación
- Ag flagelar H (no tiene valor para su tipación - común a todas las cepas)
- Exotoxina / entero-toxina proteica (el principal efecto patógeno del cólera - provoca diarrea masiva)
- Adhesina (proteína que tiene afinidad por los azucares) que permite adherirse a la pared intestinal
Para formar cuadros graves es necesario su penetración por vía oral (agua o alimentos contaminados con el bacilo, p.ej. productos marinos crudos), eludir el medio acido del estomago (sucede cuando se ingieren >100 millones de gérmenes - en el caso de epidemias donde se encuentra 1 millón/ ml de agua).
Aislamiento - caracteres bioquímicos - diagnostico
- Toma de muestra a partir de las heces diarreicas, vómitos, procediéndose de inmediato a su identificación (sensible a medios externos); medio de transporte Cary-Blair.
- Aislamiento en medios de cultivo específicos TCBS que impide el crecimiento de gran parte de microorganismos => produce colonias amarillas por la fermentacion de la sacarosa sobre el medio verde y también se siembre en el Mc.
- Pruebas bioquímicas => oxidasa+, catalasa+, sacarosa+ (produce un tipo de acido débiles que no bajara mucho el pH)
- Pruebas serologícas para determinar el titulo de Acs.
Aeromonas - bacilo Gram- no fermentadoras de la misma familia; el especie mas importante Aeromonas hydrophila; catalasa+ y oxidasa+, VP+, lactosa-, ureasa-, indol+, SH2-, móviles; no son halófilo (a diferencia de Vibrio) implicadas en procesos diarreicos.
Plesiomonas - tiene las mismas características bioquímicas que Aeromonas (excepto en pruebas de VP y ornitina descarboxilasa); el especie mas importante Plesiomonas shigelloides (se propone a incluirla a la familia enterobacterias); hay que hacer API para distinguirla de Aeromonas (Plesiomonas - ornitina descarboxilasa+)
Tema 20 - Bacilos y cocobacilos aerobios y anaerobios facultativos (patología e identificación)
Pseudomonas - bacilos pequeño (coco-bacilo) Gram-, móviles (flagelación), en general aerobios estrictos, catalasa y citocromo oxidasa positivos, en general metabolismo glucídico oxidativo; ampliamente distribuidos en el agua y suelo, pasando de aquí a los animales y al hombre; son oportunistas en el ambiente hospitalario (pacientes inmunodeprimidos), en ocasiones resultan muy graves (resistente a muchos ATB - hay que combinar varios).
Los especies mas importantes:
- P. aeroginosa => presenta pigmentos fluorescentes, saprofita en la piel, tubo digestivo??, puede provocar cuadros graves en individuos debilitados y es mortal si se produjese septicemia;
- P. maltophilia (ahora se llama Stenotrophomonas maltophilia) se llama así, porque oxida maltosa (no oxida la glucosa); cogen cada vez mas importancia; oxidasa variable.
Acción patógena e interés clínico - Pseudomonas aeroginosa
- Ag somático O (polisacáridos), Ag flagelar H (proteico), Ag mucoide M (produce exotoxinas => enterotoxina responsables de cuadros diarreicos y toxina eritrodérmica).
- Sustancia => (1) piocina (pigmento azulado de acción bactericida), (2) fluoresceina (pigmento verde amarillo) y (3) pigmento melánico (tiñe de color marrón los cultivos).
- Cuadros graves o muy graves (de carácter oportunista) => sinusitis crónicas, infecciones del aparato respiratorio (neumonías, faringitis, bronco-neumonías); puede producir endocarditis en drogadictos y paciente con SIDA; enterocolitis, pielonefritis y meningitis en neonatos; en grandes quemaduras, agravando la lesión o provoca infección de heridas quirúrgicas; en casos mas graves puede originar bacteriémia (quemaduras graves).
Aislamiento - caracteres bioquímicos - diagnóstico bacteriológico
- Toma de muestra de cualquier producto patológico, especialmente de carácter purulento en total asepsia.
- Examen directo (tinción Gram); si el pus es azulado se sospechara de P.aeroginosa.
- Aislamiento en medios generales (el bacilo piociánico es fácil de cultivar) a temperatura 37ºC; es importante estudiar la presencia de pigmentos que se difunden en el medio; la piocianina es un pigmento responsable de la coloración azul verdosa que puede adquirir el medio y el olor a jabón de las colonias son las características de P.aeroginosa.
- Pruebas bioquímicas de citocromo oxidasa+, catalasa+, gelatinasa+, utilización de la glucosa vía oxidativa (aerobio).
- Pruebas serologícas para buscar Acs anti Pseudomonas.
Brucella - bacilos pequeños (coco-bacilos) Gram- inmóviles, aerobios estrictos, algunas crecen mejor en atmósferas ricas en CO2 (5-10%), su crecimiento es lento, catalasa+, oxidasa+, nitratasa+, ureasa+, sensibles a medios ácidos y se destruyen fácilmente a temperatura de pasteurización.
Especies mas importantes (en función del huésped en el que anidan):
- Brucella melitensis afecta a cabras y ovejas; afecta al hombre a traves de sus leches no esterilizada, quesos frescos, carne cruda o poco hecha.
- Brucella abortus afecta a bóvidos (la mayoría de los casos de brucelosis en España - en menor proporción B.melitensis)
Acción patógena e interés clínico - depende de su estructura antigénica; Brucella es capaz de mantenerse latente en el interior de la celulas que la han fagocitado y posteriormente, empezar a multiplicarse con la consiguiente producción de endo-toxina; penetran en el hombre a traves de heridas y vía digestiva (alimentos procedentes de animales infectados (leche no esterilizada, quesos frescos, carne cruda o poco hecha); posteriormente, pasaran a los ganglios linfáticos, donde serán fagocitadas por neutrófilos (en la sangre) y macrófagos (en los tejidos) y se distribuyen por todo el organismo, volver a pasar al torrente circulatorio originando bacteriémia (brucelosis aguda o fiebres de Malta); se caracteriza por artralgias difusas (dolores de articulaciones), sudoración abundante, esplenomegalia y otras distintas formas clínicas dependientes de la localización de Brucella (orquitis, neumónia brucelar, etc); las fiebres son ondulantes con tendencia a las recidivas (frecuente entre los 3 y 6 meses subsiguientes a la infección por Brucella);
Bordetella - bacilos o coco-bacilos Gram- aerobios estrictos, inmóviles (algunas son móviles), capsulados; son parásitos estrictos (no se encuentran libres en la naturaleza); se transmite por las gotitas de flugge o contacto directo.
Especies mas importantes:
- Bordetella pertussis (bacilo Bordet y Gengou) => la mas patógena y es el agente etiológico de la tosferina
- B.parapertussis => aislada en casos benignos de tosferina y no es estrictamente patógena
- B.bronchiseptica => afecta mas a animales que al hombre; aislada en el hombre excepcionalmente en casos benignos de tosferina.
Acción patógena e interés clínico (Bordetella pertussis) - se infectan a traves de gotitas (flugge) que se producen al hablar; tras periodo de incubación de 1-2 semanas, empiezan a multiplicarse en la superficie de las celulas epiteliales ciliadas de la traquea, bronquios y bronquiolos, originando inflamación en estas zonas, paralización de sus cilios y consiguiente necrosación; presenta una fuerte acción tusígena (tos seca) que puede llegar a agotar debido a la acción de la toxina proteica y incremento de las mucosidades que obstruyen los bronquios (bronco-constricción) lo que facilita un déficit en la ventilación pulmonar; puede originar cianosis, taquicardia y vómitos alimenticios; es altamente contagiosa, pero ya existe vacunas de la tosferina.
Haemophilus - bacilos muy pequeños Gram- aerobios y anaerobios facultativos, inmóviles y patógenos para el hombre y muchos animales; sensibles a medios externos, desecación, el calor y muchos antisépticos; necesita medio de cultivo especifico con sangre como AS o agar chocolate (contiene factores X/hemina o ferroprotoporfirina y factor V/NAD o nicotinamida-adenina-dinucleotido necesarios para el proceso de respiración).
Especies mas importantes (clasificadas en función de los factores que necesitan):
- Haemophilus influenzae (bacilo de Pfeiffer) es el agente etiológico de 10-15% de las meningitis en niños de corte edad en España y de neumonías en ancianos; requiere ambos factores V y X.
- H.parainfluenzae es agente causales en ciertas meningitis, afecciones respiratorias y septicemias; también son saprofitos en fosas nasales y boca; requiere solo factor V.
- H.ducreyi es agente etiológico del chancro blando (enfermedad venérea /ETS); requiere solo factor X.
Acción patógena e interés clínico (Haemophilus influenzae):
- Es capsulada (su capsula esta formada por polisacáridos distintos de A-F) en España es mas frecuente la del tipo B.
- Posee endo-toxina que es responsable de lesiones en la traquea y bronquios en procesos neumónicos
- Suelen afectar a las vías respiratorias originando neumonías, bronquitis aguda en ancianos y adultos debilitados.
- Puede producir meningitis en niños de corta edad; se transmite por vía aérea y mas frecuente en invierno y primavera; comienza como infección de las vías respiratorias altas y posteriormente se extiende via sangre hasta el sistema nervioso produciendo meningitis purulenta con mortalidad alta sin tratamiento a tiempo.
- Existe vacuna para H.influenzae tipo B.
Aislamiento - caracteres bioquímicos - diagnostico de Haemophilus:
- Toma de muestra a partir del exudado faríngeo, esputo o líquidos purulentos (en caso de infección de vías respiratorias), LCR por punción lumbar (en caso de sospechar meningitis).
- Examen directo (tinción Gram, tinción negativa)
- Se cultiva en agar chocolate o AS de conejo/caballo, se añaden discos que contengan factores V y X, ATB como la bacitracina que inhibe a otros gérmenes; se formaran satelitismo según sus necesidades de los factores; incubar en la atmósfera rica en CO2.
- Pruebas bioquímicas => indol+, ureasa+, nitratasa+, oxidasa variable (según la cepa), fermentacion de glucosa positiva, ONPG-.
- Técnicas inmunológicas => determinar el Ags capsular (se realizan por la urgencia del diagnostico)
Legionella - la especie mas importante para el ser humano, es Legionella pneumophila (el agente etiológico de la legionelosis / neumónia atípica por Legionella); un coco-bacilo o bacilo Gram-, aerobio estricto, requiere medios muy específicos para crecer (agar legionella), catalasa+, oxidasa+, en ocasiones puede presentarse de forma filamentosa; en general son móviles, pero algunas cepas son inmóviles.
Acción patógena e interés clínico - se transmite vía aérea a partir de aerosoles procedentes de aguas contaminadas o sistemas de aire acondicionado o humidificadores contaminados con Legionella; tras el periodo de incubación (+/- 1 semana) se produce fiebres altas, astenia, malestar generalizado, tos, anorexia, dolor pleural agudo, disnea (un cuadro típico de una neumónia atípica); se conoce como la enfermedad de los legionarios; el pronostico sera mas severo en ancianos o adultos debilitados aunque con el tratamiento preciso suele remitir sin problema.
Bacillus - de la familia Bacillaceae; el genero Bacillus son bacilos esporulados aerobios o anaerobios facultativos con tamaño entre 1-7 micras Gram+ y en su mayoría móviles; otro genero de la misma familia es Clostridium son bacilos esporulados y anaerobios estrictos, que origina en su mayoría potentes exotoxinas responsables de cuadros clínicos graves.
Especies mas importantes de Bacillus:
- Bacillus anthracis (agente etiológico del ántrax o carbunco)
- Bacillus cereus (responsable en muchas ocasiones de trastornos gastrointestinales)
- otros bacilos son comensales para el hombre o saprofitos del suelo, agua, etc., y que depende del estado inmunitario, puede producir diferentes cuadros clínicos (p.ej. Bacillus subtillis).
Acción patógena e interés clínico de Bacillus anthracis:
- Es un bacilo grande, habitualmente se presenta en forma de cadenas cortas o en parejas, formando fácilmente esporas sobre todo en los cultivos viejos; es inmóvil, presenta capsulas (los patógenos) y exotoxina proteica que proporcionan propiedades anti-fagocitarías.
- En general, el cuadro clínico que produce es el carbunco animal o humano; en el humano tiene lugar tras un primer contacto a partir de animales infectados que tras periodo de incubación de 2-3 días surge una pústula maligna (color negro en la mano) en el punto de contagio (las manos y cabeza); comienza con una pápula eritematosa que se complica a vesícula pruriginosa que se convierte en ulcera o escara, que sin tratamiento puede necrosarse y extenderse en superficie y profundidad; los casos no tratados, podrían ser graves, ya que existe el riesgo de septicemia intensa que en pocas horas podría originar la muerte; lo mas habitual son las formas benignas que curan con facilitad tras un tratamiento.
- En casos excepcionales pueden aparecer formas internas como el carbunco pulmonar ante la inhalación de polvo contaminado con esporas de Bacillus anthracis que da lugar a neumonías graves; también puede producirse carbunco intestinal por la ingestión de alimentos contaminados con las mismas esporas y originara diarreas, vómitos, dolor tipo cólico, fiebre, etc.
Acinetobacter - (también esta descrito en genero de Moraxella/ Neisseriaceas) este genero engloba especies que pueblan la flora de suelos y agua, al igual que Pseudomonas, son bacilos Gram- no fermentadoras, capsuladas y presentes en ambiente hospitalarios donde afectan a pacientes inmunodeprimidos; la especie mas frecuente es Acinetobacter calcoaceticus que produce infección urinaria, neumonías y sepsis; crecen bien en Mc y AS que da colonias grises y B-hemolíticas; se diferencian de Pseudomonas en que Acinetobacter es oxidasa-; son fácilmente confundible con Neisserias porque es bacilo muy pequeño (coco-bacilo); también es muy resistente a los ATB.
Tema 21 - Corinebacterium (patología e identificación)
Genero Corinebacterium - pequeños bacilos inmóviles a temperatura corporal, se comportan como Gram+, suelen agruparse en formas geométricas parecidas a letras chinas o abecedario (empalizadas); presenta granulaciones metacromáticas, catalasa+, anaerobios facultativos y pueden dar lugar a un velo superficial en medios líquidos; presentan ciertos rasgos comunes con Mycobacterium en su pared bacteriana que es muy rica en ácidos micólicos, arabinosa y galactosa, aunque la tinción de BAAR (Zhiel-Nielssen) para Corinebacterium resulta negativa; la especie mas importante es Corinebacterium diphteriae.
Acción patógena e interés clínico de Corinebacterium diphteriae - el bacilo diftérico llega al hombre por vía respiratoria a traves de gotitas de saliva (pflugge) u objetos recientemente contaminados invadiendo la oro-faringe y las amígdalas; desde aquí se extiende, liberando toxinas y enzimas inhibiendo la síntesis proteica celular, originando necrosis en las celulas epiteliales que invade; este epitelio necrosado junto con leucocitos y fibrina formara una pseudomembrana que cubre las amígdalas, que puede llegar a provocar una obstrucción respiratoria si se extiende por la naso-faringe y laringe; tal pseudomembrana se encuentra fuertemente adherida a las mucosas, de forma que si se intenta arrancar, originaria al paciente una fuerte hemorragia; en general los signos y sintomas de la difteria suelen ser de tipo respiratorio; en casos excepcionales, por vía linfática podría pasar a la sangre difundiéndose al resto del organismo.
Tema 22 - Mycobacterium y Nocardia (patología e identificación)
La familia Mycobacteriaceae engloba un solo genero Mycobacterium; son pequeños bacilos finos rectos y a veces incurvados, excepcionalmente pueden encontrarse algo filamentosos; son inmóviles con una pared típica y característica no encontrada en ninguna otra familia excepto Nocardia (altamente enriquecida con ácidos micólicos y componentes céreos que se tiñe muy difícilmente - responde a Gram+), se necesitan colorantes con alta capacidad tintorial para su penetración; una vez teñidos son altamente resistentes a la decoloración ácida (AAR+ o acido alcohol resistencia positivo) lo que les diferencia del resto de microorganismos; son muy distribuidos en la naturaleza, pueden ser saprofitos del agua y suelo y puede provocar infecciones graves al hombre y en ocasiones crónicas como la lepra; necesita gran cantidad de oxigeno para sobrevivir (aerobias estrictas).
Las especies mas importantes del genero Mycobacterium (3 importantes grupos):
(1) Bacilos de Mycobacterium cultivables en medios artificiales, de crecimiento lento (>1semana hasta 3 semanas); en función de los cuadros clínicos se subdividen en 2 grupos:
a. especies que producen tuberculosis al hombre y a los animales (Mycobacterium tuberculosis y Mycobacterium bovis).
b. especies de micobacterias atípicas de crecimiento lento, podrían presentar un poder patógeno para el hombre distinto al de la tuberculosis y la lepra (Mycobacterium avium y Mycobacterium marinum).
(2) Micobacterias de crecimiento rápido (<1semana); no tiene interés clínico (no son patógenos) para el hombre.
(3) Bacilos de Mycobacterium no cultivables sobre medios artificiales y patógenos para el hombre (Mycobacterium leprae) y ciertos roedores (Mycobacterium lepraemurium)
Los micobacterias también se pueden clasificar en función de la producción de pigmentos, de las morfologías de las colonias y de la velocidad del crecimiento.
Acción patógena e interés clínico
Mycobacterium tuberculosis - responsables de tuberculosis en el hombre
Muy rica en componentes lipídicos en su pared celular dotándole un carácter tintorial especifico AAR+ que servirá para su identificación y clasificación; contiene proteínas que provocan la formacion de Acs (reacción de la tuberculina /test de Mantoux); es capaz de crecer en el interior de las celulas que constituyen el sistema retículo endotelial, se multiplican dentro de ellas sin ser destruida; en el frotis de baciloscopia se puede observar forma cordones microscópicos.
Llega al hombre por inhalación (excepcionalmente por ingestión de alimentos contaminados con Mycobacterium o a traves de las heridas de la piel); produce una lesión primaria en el pulmón y mas concretamente a nivel de los alvéolos pulmonares, provocando una intensa reacción inflamatoria que da lugar a exudación; estos bacilos pueden llegar hasta los vasos linfáticos y de aquí a los ganglios, retornando a la circulación venosa y originando focos metástasis en distintos órganos; sin tratamiento se va desarrollando evolucionando hacia una necrosis "caseosa" (parecida a queso de caverna); después de 6 semanas o mas va evolucionando hacia una destrucción y desintegración de las celulas pulmonares con la formación de una masa solida, homogénea, parecida al queso (caverna tuberculosa); provocara fiebres mas o menos variables, sudoración por la tarde, adelgazamiento progresivo, tos débil o intensa (a veces con esputos muco-purulentos) y en fases mas avanzada, hemoptisis; en general cualquier parte del organismo podría verse afectada a causa de diseminación (gastrointestinales, genito-urinarias, pericárdicas, etc.)
Mycobacterium leprae - productoras de la lepra en el hombre
Se multiplica con extraordinaria lentitud y su clínica es bastante insidiosa y no ha podido ser cultivado en ningún medio in vitro, por lo que se conocen poco sus características microbiológicas; su único reservorio es el hombre con autentica predilección por las terminaciones nerviosas; es un bacilo inmóvil, rectilíneo, se tiñe con Zhiel-Nielssen (AAR+); suelen encontrarse en la mucosa nasal, en la dermis y en biopsias de lesiones en individuos con lepra;
La vía de entrada es a traves de lesiones en la piel, se propagan a los nervios superficiales próximos, concretamente a las celulas de Schwam; de aquí propagarse via linfática al sistema venoso y disemina a otros órganos (lepra lepromatosa); se multiplica mejor en las partes mas frías del organismo (la cara, extremidades) invadiendo los nervios mas superficiales; el bacilo se multiplica en el interior de los macrófagos de la piel y las celulas de Schwam, originando inflamación y perdida de sensibilidad; en estado grave también aparece en órganos mas profundos y su pronostico es mas complicado; su periodo de incubación es muy difícil de determinar, puede durar muchos años; su periodo de invasión es muy insidioso, sintomas raros y no asociables a lepra (picor, hormigueo y perdida de sensibilidad en las manos/pies; a partir de aquí, de forma lenta y progresiva aparecen lesiones cutáneas (maculas prominentes en extremidades y cara); su periodo durara toda la vida y su evolución mas o menos grave dependerá del grado de inmunidad del huésped; tto => ATB sistemico.
Micobacterias atípicas - producido por Mycobacterium avium y Mycobacterium marinum
Las micobacterias atípicas son m.o. patógeno para el hombre, frecuentemente de carácter pulmonar, a veces confundido con Mycobacterium tuberculosis ya que la sintomatología es similar => tras una invasión, se producen formación de tubérculos y consiguiente necrosis caseosa con formación de cavernas, diseminación y cuadros de fibrosis pulmonar con rara aparición de focos extra-pulmonares; la gravedad de lesiones depende del estado inmunológico del paciente; los gérmenes invadirá especialmente individuos inmunodeprimidos; la vía de entrada es muy variable (respiratoria o mucosas).
Aislamiento - caracteres bioquímicos - diagnostico
a)- Aislamiento de Mycobacterium tuberculosis
- Muestras puede proceder de esputo, aspirado bronquial, aspirado gástrica; LCR e orina; la muestra de esputo han de someterse a una descontaminación, homogenización y concentración (mediante centrifuga) previa al cultivo; LCR, orina, etc. se puede sembrar directamente, pero lo mejor seria centrifugar-lo antes.
- Se realizara un examen microscópico del frotis previa tinción de Zhiel-Nielssen (AAR); también se pueden utilizar tinciones fluorescentes (auramina, rojo de tiacina, naranja de acridina), cuando se sospecha que hay pocos bacilos (todo se trabaja bajo la campana de flujo laminar).
- Para aislar el bacilo de Koch de muestras estériles (LCR, orina) se utilizara medios líquidos como Proskauer-Beck; si pretendemos hacerlos crecer en medios sólidos (esputo), existe medios específicos como Lowenstein-Jensen o Coletsos, que contienen huevo, aminoácidos, sales minerales y verde malaquita (inhibe los gérmenes contaminantes) cuyo crecimiento es lento (2-4 semanas); también existe agar Middlebrook que se suele emplear junto con el anterior para completar su identificación; Micobacterias son muy exigentes en su crecimiento => incubar a 37ºC, en la oscuridad, en el ambiente con CO2 de 5-10% (en 1ª semana) y en atmósfera normal a partir de la 2ª semana; los tubos desenroscados hasta que se evaporen el agua (sin secar el medio); la mayoría tardan entre 3-6 semanas en crecer (algunos aun mas); si hay crecimiento, se hará la identificación de su morfología mediante tinción de Zhiel-Nielssen y pigmentos.
- Pruebas bioquímicas => la mas importante es la prueba de la niacina+ (todas las micobacterias producen ácido nicotínico durante su crecimiento; M.tuberculosis no metabolizan el ácido nicotínico y por ello lo acumulan y es excretada al medio, sobre todo en medios con base de huevo, del cual puede ser extraída y detectada); es nitratasa+ y catalasa+ (solo algunas cepas de Mycobacterium tuberculosis no tienen la catalasa; en general tienen catalasa termolábil (a temperatura alta no tienen catalasa).
- Pruebas serologícas => la mas utilizada es la técnica ELISA; actualmente la identificación se hace con el PCR, posteriormente se realiza la hibridación con las sondas genéticas (ADN) de M.tuberculosis marcadas.
- Pruebas de alergia /la prueba de la tuberculina (Mantoux); tuberculina es un extracto proteico de bacilo tuberculoso; es solo toxico para individuos que han estado en contacto con dicho germen, originando una reacción intradérmica en la cara anterior del brazo intensa; este eritema endurado (pápula de >10mm es positivo) se debe leer hacia 48-72 horas (se mide la pápula no la zona roja); después de las 4-6 semanas posteriores al contacto, la prueba del Mantoux dará de por vida positiva.
b)- Aislamiento de Mycobacterium leprae
- Muestras a partir de heridas sospechosas en piel y otras localizaciones.
- Se realiza una tinción de Zhiel-Nielssen o AAR, que deberá dar positiva
- No podrá ser cultivada en medios de cultivo
- Se realizara un diagnostico serológico (un estudio de la inmunidad celular y humoral del individuo)
- Pruebas cutáneas: (depende del resultado, se hace los 3 pruebas o solo algunos).
1. reacción de la lepromina => para conocer el tipo de lepra que posee ese individuo (prueba de intra-dermorreacción /Ag de bacterias inactivadas); Las personas que no tienen lepra tendrán poca o ninguna reacción de la piel al Ag. Los pacientes con un tipo particular de lepra, llamado lepra lepromatosa, no tendrán ninguna reacción de la piel al Ag; una reacción positiva de la piel se puede observar en pacientes con lepra tuberculoide y lepra dimorfa tuberculoide.
2. test de pilocarpina => para buscar la ausencia de sudoración de la piel lesionada después de una inyección de clorhidrato de pilocarpina.
3. test de la histamina => inyectar histamina de tal forma que en una piel sana aparecerá una reaccion alérgica característica, mientras que en las lesiones lepromatosas esto no sucede debido a que los nervios periféricos están lesionados y no aparecerá ninguna reacción alérgica.
c)- Aislamiento de Micobacterias atípicas
- Recogida de muestra de los lugares sospechosos en total asepsia
- Tinción de Zhiel-Nielssen (positiva); tinción fluorescencia con auramina, rojo de tiacina, naranja de acridina.
- Cultivos en medios Lowenstein-Jensen, Coletsos o caldo Middlebrook, donde se puede observar el aspecto de las colonias, su velocidad de crecimiento y la presencia de pigmentos.
- Pruebas bioquímicos: niacina- (la diferencia de Mycobacterium tuberculosis), catalasa+, nitratasa+.
- Pruebas serologícas de ELISA
Actualmente en grandes laboratorios, se utilizan medios de cultivos radiométrico (Bactec TB) de deteccion mas rapida que contiene liquido de soporte (agar Middlebrook) con ATB para inhibir los demas gérmenes y el sustrato marcado con un isótopo del carbono C14; las micobacterias al crecer metabolizan el sustrato y liberan gas CO2 marcado radioactivamente que es detectada automáticamente por el Bactec y una vez que se ha detectado crecimiento en alguno de los medios, se realiza la tinción de Ziehl-Neelsen para ver si lo que ha crecido son BAAR o no.
Baciloscopias - las extensiones para baciloscopias se deben hacer previamente a la descontaminación (CHNa 2-4%) de las muestras y homogenización (N-acetil cisteina) , posteriormente su concentración por centrifugación; la preparación del frotis del esputo ha de hacerse seleccionando la parte mas purulenta que es donde hay mas micobacterias; cuando se lleva acabo la tinción de los frotis, se debe evitar el contacto físico entre las portas para evitar contaminación cruzada; es importante cuantificar el numero de bacilos encontrados ya que esta directamente relacionado con el grado de contagiosidad del paciente y con la gravedad de la infección.
El genero Nocardia - corresponde a actinomicetos aerobios que forman micelio vegetativo que tiende a fragmentarse originando estructuras bacilares o coco-bacilares; Gram+ inmovil, aerobios estrictos y AAR+ (tiene características análogas al Mycobacterium) poseen gran cantidad de acidos micolicos de cadena larga en su pared bacteriana; poseen ademas glicolípidos y fosfolípidos que sirve para su identificacion y diferenciación; algunas especies son patógenas para el hombre.
Acción patógena e interés clínico
Gran parte de nocardiosis son infecciones de carácter oportunista; no produce toxinas, pero contiene en su pared bacteriana alta proporción de lípidos que le confiere una resistencia a los sistemas de defensa (macrófagos, linfocitos, etc.); tiene capacidad de crecer y multiplicarse en el interior de los tejidos (macrófagos) como parásito intracelular y solo crece cuando las defensas del individuo se encuentran bajas; las manifestaciones clínicas mas frecuentes son:
A. Nocardiosis pulmonar - causada sobretodo por Nocardia asteroides que produce lesiones pulmonares con abscesos, inflamación diseminada semejante a la tuberculosis; pueden surgir áreas de necrosis y diseminarse por sangre a otros órganos provocando septicemia.
B. Micetomas (lesiones granulomatosas) de carácter crónico originadas en el tejido subcutáneo donde se producen tumefacción, abscesos y pústulas y/o nódulos que al abrirse presentan exudados sero-sanguinolentos; generalmente causados por Nocardia brasiliensis y es frecuente en las extremidades inferiores y superiores; presenta periodos de remisión y es característico de climas tropicales;
Tema 23 - Bacterias anaerobias (patología e identificación)
Anaerobias - todas aquellas bacterias incapaces de crecer y/o mantenerse en contacto con O2 a la presion atmosférica; presentan un metabolismo anoxibiótico => incapaz de utilizar O2 de la atmósfera como aceptor final de electrones; en su lugar utilizan sustratos orgánicos como aceptores finales de electrones (respiración anaeróbica /fermentacion); la presencia de O2 puede ser (1) bactericida /toxica /letal directa o bacteriostático (crecerán de nuevo cuando las condiciones son favorables); (2) inhibir ciertos sistemas enzimáticos o la función reguladora primordial del metabolismo celular; (3) generan producto tóxicos al interaccionar sus componentes propios con O2; los anaerobios son las bacterias predominantes en la flora normal humana y en algunas partes p.ej. boca o intestino están en proporción de 1000:1 con respecto a la flora aerobia, por tanto, la mayoría de la infección que provoca los anaerobios son endógenas; dentro de los anaerobios se distingue => anaerobios estrictos y anaerobios aero-tolerantes /microaerofílicos (puede crecer a 2-8% de O2).
Genero Clostridium - bacterias anaerobias esporuladas; son bacilos Gram+, anaerobios estrictos, forman esporas a nivel terminal o subterminal, presentan flagelación perítrica, móviles, no presentan capsulas excepto Clostridium perfringes; ampliamente distribuidas en el suelo, agua, etc. y altamente resistente a medios externos; responsable de infecciones e intoxicaciones muy graves (tétanos, botulismo, gangrena gaseosa, etc.); las especies mas patógenos actúan mediante la formación de toxina con poder toxico sobre el huésped; algunos podrían formar parte de la flora normal del hombre y animales.
Las especies mas importantes
A. Clostridium que originan toxinas cuyo mecanismo de acción es neuro-toxico => Clostridium tetanii - el agente etiológico de tétanos y Clostridium botulinum - agente etiológico del botulismo.
B. Clostridium que originan toxinas que actúan sobre tejidos provocando histo-toxicidad => Clostridium perfringes - agente etiológico de la gangrena gaseosa; para su penetración en el organismo se requieren lesiones previas.
C. Clostridium que originan toxinas que actúan sobre el tracto digestivo (clostridios entero-toxicos) => Clostridium difficile - responsable de trastornos gastrointestinales no graves.
D. Clostridium responsables de cuadros purulentos (clostridios piógenos) => Clostridium perfringes; es frecuente la presencia ademas, de otras bacterias anaerobias.
Acción patógena e interés clínico
A. Clostridium que ejercen acción neuro-toxica sobre las personas (C.tetanii y C.botulinum)
Clostridium tetanii - es un bacilo Gram+ pequeño, formadora de esporas (aspecto de tambor o cerilla), habitan la tierra y el intestino del hombre y animales; produce 3 toxinas responsables del cuadro típico del tétanos que son transportadas vía sanguínea o humoral hasta SNC bloqueando la liberación de neurotransmisores, originan hiperactividad de las neuronas motoras que da lugar a convulsiones y parálisis espástica o espasmo muscular a nivel periférico; se ve alterado el sistema muscular variando el ciclo de contracción-relajación de forma que este entra en fase de contracción y no se recupera (rigidez tetánica / epistótonos).
Para que se produzca el tétanos es necesario una serie de condiciones tales como que el microorganismo germine (condiciones adecuadas de anaerobiosis); tras una herida profunda (cortante, punzante, mordeduras, arañazos, partos, abortos, quemaduras, ulceras por decubito) o herida superficiales (rozaduras) se pueden infectar y formar costra que facilita la infección anaerobia; en las condiciones favorables de anaerobiosis, las esporas de Clostridium tetanii en el ambiente pasan a la herida, germinan y tras un periodo de incubación (5-7 días), se origina su acción patógena; es rara que se produzca de forma local en la zona de entrada; la forma generalizada es mas habitual y mas grave; es importante la detección precoz y medidas profilácticas (vacunación se renueva cada 10 años).
Clostridium botulinum - bacilos Gram+ anaerobios estrictos, grandes, móviles por su flagelación y presentan esporas; es capaz de formar neuro-toxinas peligrosas y potentes sobre las personas que originan parálisis o debilidad muscular; las esporas son distribuidas ampliamente en el aire, suelo, ciertos alimentos (conservas, pescados, etc.); si las condiciones en el ambiente son de anaerobiosis, germinaran; su accion patógena sobre el organismo sera neuro-paralizante y con una dosis de 10 elevado a -8 (10 nanogramos) de su toxina es suficiente para causar la muerte (es el veneno mas potentes hasta ahora), que solo se producen en condiciones adecuadas de anaerobiosis, temperatura en torno a 30ºC, pH neutro o ligeramente acido y permiten que germine la espora; sus toxinas son de carácter proteico y termolábiles (se destruyen a temperatura 100ºC durante 5 minutos o 70ºC de 30-60 minutos).
El mecanismo de acción de las toxinas botulínicas => a traves de los alimentos contaminados llega esta neuro-toxina al tubo digestivo del hombre y producirá toxinfección alimentaria inicialmente; de aquí via sanguínea y linfática llega hasta sistema nervioso periférico donde actúa en las terminaciones nerviosas, originando parálisis en el musculo esquelético y otras manifestaciones neurológicas como visión borrosa, fotofobia, sequedad de boca, lengua y faringe, disfagia, disartria (dificultad al hablar), debilidad de los musculos (flacidez) incluyendo los respiratorios que puede llegar mortal por fallo respiratorio y arritmias cardíacas (depende de la cantidad de toxina o del germen); su periodo de incubación en torno 18-36 horas después de la ingestión del alimento contaminado y los cuadros mas graves se originan en un periodo de incubación inferior a 24 horas.
B. Clostridium que ejercen acción histo-toxica en múltiples tejidos
Clostridium perfringes - ejercen un efecto toxico importante pero no actúan sobre SNC; son Gram+, anaerobia estricta, la única especie capsuladas, ampliamente distribuida en el suelo; de aquí a traves de heridas profundas, puede pasar al hombre produciendo gangrena gaseosa; también puede encontrarse en la flora intestinal; capaz de formar toxinas que actúan sobre los tejidos, entero-toxina, hemolisina, neuroaminidasa.
El mecanismo de acción => tras la vía de entrada (heridas) en condición anaerobiosis adecuadas, germinan las esporas y proliferan; es frecuente que se contaminen con otro tipo de bacterias aerobias que consiguen agotar el oxigeno aumentando las condiciones de anaerobiosis, se disminuye el pH aumentando el acido láctico y facilitando la liberación de las enzimas proteolíticas y sustancias toxicas; se producirán los efectos lesivos y graves sobre los tejidos extendiéndose a los vecinos, se romperán las estructuras celulares a nivel de sus membranas, se destruirán las celulas hemáticas, las celulas endoteliales, las membranas de las celulas musculares originando procesos de dermo-necrosis con daño tisular (gangrena).
Ademas de provocar la gangrena gaseosa a traves de heridas infectadas, C.perfringes es también el agente etiológico de una toxo-infección alimentaria producida por la ingestión de carne contaminada provocando cuadros diarreicos y dolor abdominal leve; existen otros casos mas excepcionales y graves que da lugar a cuadros diarreicos muy acuosos y sanguinolentos, vómitos y estado de shock producido por C.difficile.
Aislamiento - caracteres bioquímicos - diagnostico
- Toma de muestra representativa, adecuada y estéril en medios específicos de transporte anaerobiosis con sustancias reductoras (bolsas generadoras de CO2) que crean atmósferas sin O2 o en una jeringa sin aire (tapando la aguja).
- Se hará un examen directo (tinción de Gram) donde se pueden apreciar las formas de esporas (palillos de tambor); también se puede realizar tinción de esporas.
- Se cultivaran en medios de cultivos específicos como ASA (agar sangre anaerobio); incubación a 37ºC en 48 horas en condición anaerobisis, utilizando una campana con un sobre generador de gas CO2, da lugar a la liberación de H y CO2; el O2 que existe en el anterior de la campana, se une al H, forman H2O que se depositan en forma de gotitas en las paredes, también hay que introducir un indicador de anaerobiosis (una tira reactiva).
- Pruebas bioquímicas => cuando existe crecimiento en el medio anaerobio, se monta directamente el API en un recipiente/ una caja, también anaerobio.
Bacterias anaerobias no formadoras de esporas - crecen en ambientes de bajo potencial oxido reductor o ambientes microaerófilos; son ampliamente distribuidos en la naturaleza y muy pocas capaces de producir cuadros patógenos graves al hombre; gran parte de ellos forman parte de la flora gastrointestinal, vaginal o bucal del hombre, no ejerciendo efecto patógeno alguno.
Las especies mas importantes
A. Bacilos Gram+ no esporulados:
- Lactobacillus => microaerófilos, crecen mejor en anaerobiosis; son flora habitual de la boca, vagina e intestino del hombre; son de gran utilidad a nivel industrial (produce acido láctico para los yogures); no intervienen en ningún proceso patógeno para el hombre.
- Propionibacterium => son anaerobios, pueden crecer en ambientes microaerófilos; forman parte de la flora normal intestinal, tracto urinario y piel.
- Bifidobacterium => es flora intestinal del hombre y no son patógenos.
B. Bacilos Gram- no esporulados:
- Bacteroides => son flora intestinal, vaginal y bucal del hombre y se ha asociado en ocasiones a procesos gastrointestinales, especialmente Bacteroides fragilis que actúa como oportunista.
- Fusobacterium => solo la especie Fusobacterium nucleatum se asocia a algunos procesos patógenos en el aparato respiratorio y tracto genital femenino, de carácter oportunista.
C. Cocos Gram+ no esporulados:
- Ciertos Streptococcus anaerobios que se encuentran frecuentemente en la flora gastrointestinal y bucal; no son patógenos.
- Peptococcus => no produce efecto patógeno sobre el hombre
D. Cocos Gram- no esporulados:
- Veillonella => forma parte de la flora intestinal y bucal y no son patógenos para el hombre.
Acción patógena e interés clínico
Salvo excepciones, no son relacionados con procesos patógenos y la patogenicidad que pudiera desencadenar alguno de ellos depende sobre todo de las circunstancias del huésped (oportunistas); pueden producir infecciones post-quirúrgicas, complicaciones de escaras o ulceras por decubito, complicaciones de herida en general.
Aislamiento - caracteres bioquímicos - diagnostico
- Toma de muestra en condiciones adecuada (anaerobiosis)
- Examen directo (tinción de Gram)
- Se aislaran en medios anaerobiosis (ASA/ANA - agar sangre anaerobio)
- Pruebas bioquímicas se realiza con API en condición anaerobia
Tema 24 - Espiroquetas (Treponema, Borella y Leptospira); patología e identificación
La familia Espiroquetaceas (con interés clínico para el hombre) - Treponema, Borrelia y Leptospira; corresponden a especies bacterianas cuya morfología es filamentosa, helicoidal o espiral con filamentos axiales relacionados con su movilidad; presenta una pared celular fina y flexible de lipo-polisacárido y lipo-proteica donde se encuentran la mayoría de Ags específicos de estas; son Gram- (difícilmente se tiñe), también se pueden visualizar por el microscopio de contraste de fases; presentan un metabolismo oxidativo y/o fermentativo (aerobias o anaerobias facultativas); difundidas en las aguas, el suelo y como agentes comensales en las mucosas del hombre y animales.
La familia Espiroquetaceae se divide en 5 generos:
- Genero Espiroqueta => espiroquetas mas grandes y no existen especies patógenas para el hombre.
- Genero Cristispira => son de tamaño algo menor que el Espiroqueta y no es patógeno para el hombre.
- Genero Treponema => son espiroquetas muy helicoidales, muy finas, pequeñas y móviles; son microaerofílicas y presentan un metabolismo fermentativo; existen especies patógenas para el hombre - Treponema pallidum (el agente etiológico de la sífilis).
- Genero Borrelia => son espiroquetas mas grandes que Treponema; son microaerofílicas y presentan pocas espiras que son amplias e irregulares; su metabolismo es fermentativo y son difíciles de cultivar en medios artificiales; pueden provocar fiebres recurrentes al hombre transmitido por artrópodos.
- Genero Leptospira => son espiroquetas largas, muy finas y con numerosas espiras, profundas y regulares; es difícil su visualización aunque se suele utilizar microscopia de contraste de fases; son aerobias con un metabolismo oxidativo; se cultivan con facilidad en medios artificiales; ampliamente distribuidas en la naturaleza, especialmente en las aguas; pueden parasitar al hombre provocando leptospirosis.
Genero Treponema - son espiroquetas pequeñas, finas con un numero de espiras entre 5-20 distribuidas de forma regular, con gran movilidad; se tiñe difícilmente con Gram y se tiñe mejor con Giemsa o tincion de plata y se visualiza con la microscopia de campo oscuro y de contraste de fases; no crece en medios de cultivo in vitro y requiere un medio de cultivo in vivo para crecer (testículo de conejo); crece bien en situaciones de bajo potencial oxido-reductor (microaerofila), presentando en ocasiones una respiración anaerobia y un metabolismo fermentativo; el especie patógena para el hombre es Treponema pallidum que transmite la sífilis por contacto directo; existen dentro del genero Treponema especies comensales de las mucosas, tracto urinario, vaginal, tubo digestivo, etc. que no son patógenos para el hombre y se pueden cultivar.
Treponema pallidum es la especie mas importante por su difusión cosmopolitana; es el agente causal de sífilis; no son capaces de vivir fuera del organismo humano, ya que mueren por desecación; su transmisión es por contacto directo (vía sexual) y si no se detecta a tiempo puede durar toda la vida; mecanismo de acción:
- Periodo primario de la sífilis => comienza tras un primer contacto con lesiones ricas en treponemas presentes en las mucosas; periodo de incubación 10-90 días (termino medio de 21 días) aparece en la zona genital un chancro primario con abundantes treponemas, se van diseminando vía hemática y linfática a otras localizaciones convirtiendo-se en una enfermedad sistémica; es frecuente su multiplicación en ganglios próximos a la zona genital originando pequeñas tumoraciones (adenopatias); transcurrido un tiempo corto de 2-6 semanas estos signos desaparecen espontáneamente y entra en una fase silente.
- Periodo secundario o sífilis florida => surge después de un tiempo entre 2 meses y 2 años de la fase silente; de forma súbita se produce una espiroquetemia en general muy florida por las manchas en la piel y en las mucosas, muy ricas en treponemas y altamente infecciosas; también puede surgir excepcionalmente una forma eruptiva como lesiones en otros órganos, fiebre en ocasiones, pústulas o pápulas muy ricas en treponemas; este cuadro clínico de carácter sistémico remite a las pocas semanas (2-6 semanas), volviendo a entrar en una nueva fase de latencia.
- Periodo terciario o sífilis terciaria => surge tras la fase de latencia entre 3-30 años, una forma muy grave con mal pronostico; el numero de treponemas en sangre es muy escaso y muy abundante en ganglios, bazo, huesos, sistema nervioso (neuro-sífilis) y aparato cardiovascular; es frecuente la formación de granulomas, necrosis, gomas, parálisis general progresiva, aneurisma aórtico, etc.
Resumen de la evolución de sífilis => Incubación 10-90 días (termino medio 21 días) - Periodo primario (2-6 semanas) - fase silente (2 meses - 2 años) - Periodo secundario/ sífilis florida (2-6 semanas) - fase latente (3-30 años) - Periodo terciario/ Neuro-sífilis forma muy grave con mal pronostico.
Aislamiento - caracteres bioquímicos - diagnostico del genero Treponema pallidum
- Treponema pallidum se aísla muy difícilmente, no crece en medios in vitro, solo lo hace en medios in vivo (testículos de conejo) y el diagnostico de la infección se establece durante los periodos primario y secundario mediante muestras de exudados, condilomas, etc.
- Examen directo al microscopio de campo oscuro o microscopio de contraste de fases o microscopio de fluorescencia de una tinción de Giemsa o tinción Nitrato de plata (sales de plata; es una técnica difícil de efectuar, reservada a los laboratorios especializados, útil en la detección de Pneumocytis carinii, Legionella, Treponema, hongos, Rickettsias).
- Pruebas serologícas => se realiza la prueba de la presencia de Acs anti Treponema pallidum en el suero del paciente con Ags específicos de Treponema pallidum que presentan una sensibilidad y fiabilidad del 100%; los resultados dependen del periodo de sífilis en el que se encuentre; también se incluyen las inmunofluorescencia indirecta, así como las de hemo-aglutinación pasiva partiendo de hematíes tratados con Treponema pallidum que es muy sensible y económica.
Diagnostico serológico de las sífilis - existe 2 tipos de pruebas (no treponémicas y treponémicas)
a) No treponémicas => son de gran sensibilidad y fácil de hacer; se usa para prueba de screening y si resulta (+), hay que confirmar con pruebas treponémicas; también se utiliza como un seguimiento de la enfermedad; se le llama también prueba de WASSERMANN; consiste en enfrentar el suero del paciente con sustancia lipídica "cardiolipina" que no es Ags treponémicos; si existen Acs anti Tp en el suero, reaccionaran con la cardiolipina (+); pero al no ser la cardiolipina un Ags treponémicos, puede dar lugar falsos positivo con otras enfermedades; 2 tipos de pruebas => VDRL (Venereal Disease Research Laboratory) y RPR (reagina plasmática rápida) son pruebas de aglutinación con partículas de carbón (darán grumitos grises).
b) Treponémicas => se utilizan como prueba confirmativas con varias técnicas: (1) FTA (técnica fluorescencia de Acs anti Tp) enfrentando Ags de Tp con posibles Acs anti Tp en el suero del paciente; (2) FTA abs donde previamente se absorben posibles Acs naturales anti Tp saprofitos; (3) TPHA (Tp Haemagglutination Assay) que tiene como base hemaglutinación y sencillo de realizar (no se necesita microscopio fluorescencia); (4) también se puede utilizar pruebas de ELISA para detectar IgM y IgG; todas son pruebas muy especificas; no se utilizan para el seguimiento, porque sera siempre resulta (+).
Genero Borrelia - son espiroquetas de mayor tamaño con espiras mas amplias e irregulares con extremos afilados y son móviles; las especies patógenas para el hombre y los animales, originan fiebres recurrentes endémicas y epidémicas; es microaerofílica con un metabolismo fermentativo; se tiñen con facilidad de Gram- y se puede cultivar in vitro, pero requiere medios muy específicos; las especies mas importantes del genero Borrelia, se transmiten por piojos y por garrapatas.
Acción patógena e interés clínico - las fiebres recurrentes son una enfermedad muy cosmopolita, en ocasiones endémica a condiciones de salubridad muy baja; tras la picadura del vector, ya sea garrapata o piojo, pasan las borrelias a la sangre del huésped, ayudadas por el rascado que provoca el aplastamiento del piojo /garrapata, que dará lugar a micro-traumas en la piel y facilitan el paso de dichas borrelias; después de unos 7 días de incubación se originan fiebres, dolores musculares, cefalea, etc; clínica que dura unos 10 días y luego desaparecer, produciendo posteriormente recurrencias; no es una enfermedad grave y es fácil de tratar, especialmente con tetraciclinas.
Genero Leptospira - son espiroquetas muy finas con espiras regulares, muy numerosas y apretadas, con sus extremos ligeramente incurvados y móviles; se tiñen débilmente con Gram, también se pueden teñir con Giemsa; su metabolismo es oxidativo (crecimiento aerobio); existe en la naturaleza leptospiras saprofitas y parásitas; puede originar de forma casual leptospirosis en el hombre con cuadros febriles; el reservorio son animales, consideradas como zoonosis.
Tema 25 - Rickettsias, Chlamydias y Micoplasmas (patología e identificación)
Genero Rickettsia - son parásitos celulares estrictos (porque su dotación enzimática es muy escasa) de los artrópodos (crecen muy bien en el citoplasma); son coco-bacilos Gram-; producen en el hombre enfermedades transmitidas por piojos, garrapatas, pulgas y ácaros.
Especies mas importantes de la familia Rickettsiaceae - hay 3 géneros importantes => Rickettsia, Rochalimaea y Coxiella (Coxiella burnetti es coco-bacilo Gram+ que origina la fiebre Q).
Acción patógena e interés clínico:
(1) Tifus exantemático epidémico - producido por R.prowazekii; mediante la picadura de piojo; tras el periodo de incubación de 1-2 semanas, aparecen escalofríos, fiebres altas (40ºC), cefaleas, dolores generalizados, nódulos inflamatorio de los capilares, arteriolas, vénulas, la piel y musculos (dificulta la corriente sanguínea y en casos graves puede provocar gangrena en las extremidades); es frecuente la formación de maculas rosadas y posteriormente pápulas y petequiales.
(2) Tifus murino o endémico - producido por R.typhi mediante la picadura de la pulga, garrapatas y ácaros; tras el periodo de incubación de 4-15 días, se produce fiebres altas, cefaleas, artralgias y mialgias generalizadas con un cuadro clínico leve sin complicaciones ni recidivas como el tifus exantemático.
(3) Fiebres manchadas de las montañas rocosas - producida por R.rickettsii trasmitidas por las garrapatas; tras el periodo de incubación de 3-6 días, aparecen fiebres altas, mialgias generalizadas y una mancha negra en la zona de la picadura; en España la especie mas extendidas es R.conorii, el agente de la fiebre botonosa o exantemática mediterránea, transmitida al hombre por la garrapata (sobre todo del perro); tras el periodo de incubación de 2-6 días provoca una mancha negra a modo de botón en el lugar de la picadura, fiebre, artralgias, mialgias generalizada y manchas maculo-papulosas; no se suelen complicar y responden bien al tratamiento.
(4) Fiebre Q - producida por Coxiella burnetii mediante inhalación de esta u otras (presencia de artrópodos), la vía de entrada no se conocen hasta la fecha; tras el periodo de incubación de 3 semanas, se produce un estado febril con mialgias generalizadas y cuadro clínico leve.
Aislamiento - caracteres bioquímicos - diagnostico del genero Rickettsia
Se toma 2 muestras de sangre en estadios febriles (cuando hay mas Rickettsia):
- La 1ª se centrifuga para obtener un sedimento sanguíneo (concentración alta de Rickettsia); se usa para realizar varias tinciones p.ej. May-Grunwald-Giemsa (las rickettsias aparecen de color purpura), tinción Gram (resulta negativo para Rickettsia y positiva para Coxiella burnetii), tinción inmunofluorescencia y estudios de microscopia electrónica (para observar); el sedimento también se usa para sembrar en medios de cultivo celular o embriones.
- De la 2ª se obtiene sueros para pruebas serologícas (buscando títulos de Acs), con tecnicas inmunofluorescencia, seroaglutinación o ELISA.
Genero Chlamydia - se consideran mas próximos a virus que a bacterias; son parásitos intracelulares estrictos (carecen de mecanismo biosintético auto-suficiente) del hombre y animales; son cocos pequeños de Gram-, inmóviles; poseen ADN y ARN y su multiplicación es por división binaria (a diferencia de virus); es capaz de vivir en medios intracelulares durante mucho tiempo sin presentar una sintomatología clara lo que facilita la cronificación de procesos infecciosos.
Especies mas importantes - dentro de la familia Chlamydiaceae:
- Chlamydia psittaci => parásito intracelular de animales y excepcionalmente del hombre (tras la inhalación de heces de pájaros infectados), provocando brotes neumónicos de distinta gravedad.
- Chlamydia trachomatis => parásito intracelular del hombre, provocando infecciones sistémicas o locales de distinta gravedad y afectando especialmente a los genitales y a los ojos.
Acción patógena e interés clínico - se multiplican en el citoplasma de la célula que parásita, presentando un ciclo con 2 tipos celulares diferentes:
- En 1er periodo formara una célula densa o corpúsculo elemental con gran resistencia a la sequedad, lo que permitirá la dispersión de Chlamydia; es la forma infectiva.
- En 2nd periodo formara una célula mas grande de menor densidad o corpúsculo reticulado, que es responsable de la división binaria y por tanto de crecimiento clamidias.
El proceso del ciclo => la forma infectiva (corpúsculo elemental) penetra en la célula que va a parasitar ayudado por los Ags específicos, se produce infección celular, se forma una vesícula citoplasmática que bloqueara los mecanismos de defensa de la propia célula; a partir de aquí este corpúsculo elemental aumenta su tamaño, su pared se hace mas fina y permeable permitiendo el paso de complejos enzimáticos, ATP y otras sustancias que van a necesitar de la célula que parasitan; el citoplasma de la clamidia se hace mas denso y esponjoso y aparece la segunda forma, donde comienza a multiplicarse por división binaria.
Cuadros clínicos de Chlamydia trachomatis:
- Tracoma => tras un contacto directo se produce una infección crónica en el epitelio conjuntival y corneal, siendo frecuentes las recaídas y sobre infecciones con evolución lenta hacia la ceguera; frecuente en edades infantiles.
- Conjuntivitis neonatal => aparece entre la primera y la segunda semana después del nacimiento; surge una conjuntivitis purulenta al neonato, asociada a infecciones genitales por clamidias en la madre; puede evolucionar positivamente o hacia lesiones análogas al Tracoma.
- Linfogranuloma venéreo => es una infección que se trasmite por contacto venéreo.
Aislamiento - caracteres bioquímicos - diagnostico del genero Chlamydia
Debido al elevado riesgo de infección en el laboratorio al manipular clamidias se suelen utilizar metodos indirectos (serológicos) a veces tambien se realiza examenes citologicos en cultivos específicos.
- Se toman muestras de secreciones oculares y/o genitales
- Se realiza un examen directo que incluyen una tinción de Giemsa y de Gram.
- Se realizan técnicas citológicas
- Se realizaran exámenes indirectos mediante técnicas serologícas (la mas frecuente ELISA) que son mas seguras y fiables; existe un kit para buscar clamidias.
Genero Micoplasma - es uno de los microorganismos mas pequeños existentes en bacteriología y se caracteriza por no contener pared celular => sensible a la presión omotica del medio (se lisan facilmente), su morfología es pleomorfismo y resistente a ciertos antibióticos cuya mecanismo de acción se establece en la pared bacteriana; se dividen por división binaria y vivir de forma independiente y crece bien in vitro a partir de medios artificiales enriquecidos; se encuentra extendidos en la naturaleza; son comensales de la mucosa del hombre; existe especies patógenas como Micoplasma pneumoniae que afecta al aparato respiratorio.
Especies mas importantes - dentro de la familia Micoplasmataceae están los géneros Micoplasma y Ureaplasma; solo unas 10 especies pueden producir algún efecto patógeno en las membranas celulares de las mucosas oro-faríngeas y uro-genitales; la mas importante para el hombre es Micoplasma pneumoniae (produce neumonías); el Ureaplasma urealyticum es otra especie patógeno que se asocia a ETS junto con el Micoplasma hominis.
Acción patógena e interés clínico
- Su infectividad se relaciona con su adherencia (debido a una glicoproteína especifica) a los epitelios de las mucosas; su pleomorfismo puede adoptar formas filamentosas y alargadas que aumenta la superficie de contacto a las estructuras epiteliales a las que se une; una vez adherida, los cilios de las celulas epiteliales que tapizan la mucosa se paralizan y provoca alteraciones metabólicas en dichas celulas epiteliales.
- Cuadros clínicos => cuadro pulmonares y mas raramente cuadros genitales o uro-genitales, siendo Micoplasma pneumonia es mas importante como el agente causal mas frecuente de las neumonías atípicas.
- En casos excepcionales se han podido aislar Micoplasma hominis y Ureaplasma urealyticum en procesos uretrales y genitales como salpingitis, vaginitis, prostatitis, cervicitis, etc. (son casos muy raros)
Aislamiento - caracteres bioquímicos - diagnostico
- Se toman muestras de la mucosa faríngea, secreciones uretrales, exudados, muestras de esputo, de sangre, etc según la patología.
- Se realiza un frotis de la muestra que se puede observar en campo oscuro con nigrosina, al microscopio de contraste de fases o con la tinción de Giemsa (se tiñe débilmente).
- Se siembra en medios específicos y con un alto grado de humedad para evitar la desecación.
- Se realiza pruebas bioquímicas => fermentacion de glucosa, prueba de arginina, ureasa, etc.; existe un kit de la detección micoplasmas.
- Metodos serológicos son mas rápidos, mas fiables y mas utilizados en la actualidad (inmunofluorescencia y ELISA).
Genero Campylobacter - son bacilos Gram- cortos con forma de coma, espiral o alas de gaviota (en cultivos jóvenes); son microaerofílicos, móviles por un único flagelo polar; no fermentan los carbohidratos, oxidasa+ y catalasa+; habitan el tracto gastrointestinal de muchos animales; en el hombre se asocian a infecciones gastrointestinales (via de entrada oral/ digestiva), fundamentalmente, y cada vez en mayor grado a infecciones extra-intestinales (meningitis, endocarditis, artritis séptica), especialmente en pacientes con SIDA.
Especies clínicamente importantes para el hombre - C.jejuni, C.coli y C. laridis son agentes etiológicos de diarrea; C.fetus subsp. fetus produce septicemia en pacientes inmuno-suprimidos.
Aislamiento a partir de "heces" - la siembra inmediata en medios selectivos a la toma de muestra; si se tiene que posponer, se utilizaran medios de transporte especiales (Cary-Blair o Campy-Thio) donde se mantiene viables; el cultivo de campylobacter tiene que cumplir 3 requisitos =>
(1) empleo de medios selectivos p.ej. "Campylosel" contiene sangre de cordero con ATB y antifúngico o "Skirrow" contiene sangre de caballo con ATB
(2) uso de atmósfera reducida de O2/ microaerofílica se consigue mediante sistema de evacuación-reemplazo hasta lograr 5% de O2, 10% de CO2 y 85% de N2 o campanas anaerobios con sobres comerciales que generan la atmósfera deseada.
(3) temperatura de 42ºC en aislamiento inicial entre 24-48 horas (para inhibir la flora fecal acompañante), después pasa a 37ºC el 3º día; las placas han de incubar hasta 72 horas antes de descartarse como negativas; a esta temperatura se consigue el máximo aislamiento de C.jejuni y C.coli.
Si pretende aislar otras especies de campylobacter distintas a C.coli y C.jejuni => ha de emplear medios selectivos sin cefalosporinas, incubación a 37ºC, atmósfera microaerofílica, incubación de 7 días.
Identificación - los campylobacter termofílicos dan lugar a colonias grises, incoloras, mucosa y no hemolíticas; se les hace una tinción Gram (bacilos Gram- con forma de S en cultivo joven y en cultivo viejo pueden dar formas cocoideas); se monta un fresco para observar la movilidad; son oxidasa y catalasa positivos; para diferenciar entre las especies se puede montar un API o se realizan varias pruebas => (1) crecimiento a distintas temperaturas, (2) sensibilidad al acido nalidixico y a la cefalotina (3) hidrólisis del hipurato (se introduce una tableta dentro de un tubo inoculado, dará + si cambia a color amarillo).
Campylobacter jejuni => crecimiento a 42ºC, hipurato+, sensibilidad a Nalidixico y resistente a Cefalotina
Campylobacter coli => crecimiento a 42ºC, hipurato-, sensibilidad a Nalidixico y resistente a Cefalotina
Campylobacter fetus => no crecen a 42ºC, hipurato-, resistente a Nalidixico y sensible a Cefalotina
Campylobacter laridis => crecimiento a 42ºC, hipurato-, resistente a ambos Nalidixico y Cefalotina
Patogenia y patologia - C.jejuni es la especie con mayor frecuencia se asocia a infeccion en el hombre (gastroenteritis con eliminación de sangre en heces), se adquiere por via oral (comida y bebidas contaminadas) o por contacto con animales infectados; sensible a pH gástrico (debe ingerirse una concentración elevada de ellos para que se produzca infeccion); se multiplica en el intestino delgado, invade el epitelio y produce inflamación; en ocasiones puede pasar al torrente circulatorio y desarrollarse un cuadro de fiebre entérica; la diarrea acompañada de dolor abdominal agudo, dolor de cabeza y fiebre; la infección es autolimitada resolviendose en una semana sin necesidad de ATB; los casos graves se trata con eritromicina.
Helicobacter Pylori - se aislaron por 1ª vez (1982) del estomago de pacientes con lesiones gástricas y ulcera péptica; son bacilos curvados Gram- con forma de espiral y gran actividad ureasa; se les denomino Campylobacter pyloridis, posteriormente se rectifico a Campylobacter pylori y cuando demostraron que difería morfologicamente del genero Campylobacter, se propuso la creación de un nuevo genero Helicobacter que se incluyo la especie de Helicobacter pylori; se trata de una especie de reciente descubrimiento, implicada en procesos de infección gástrica.
Metodos de detección de H.pylori
- Metodos directos => las muestras mas idóneas para el aislamiento de H.pylori son las biopsias de las zonas pliegues de la mucosa gástrica del antro, cuerpo y fundos; se remitirán directamente al laboratorio para proceder a su cultivo inmediato en medios específicos para H.pylori; una porción de la biopsia se invertirá en la realización de un frotis para la tinción Gram o Giemsa.
- Incubación => las placas deben incubarse en condiciones reducidas de O2 (5%), de 10% CO2 y 85% N2. Se consigue mediante sistema de evacuación-reemplazo o usando jarras de anaerobios con sobres comerciales que generan dicha atmósfera; la temperatura optima es de 37ºC (no se desarrolla a 25ºC, 30ºC ni 42ºC); en aislamiento primario, es conveniente incubar las placas hasta 7 días; Las colonias son de 1-2 mm de diámetro, translucidas y poco hemolíticas.
- Identificación => son oxidasa+, catalasa+, ureasa+, hipurato- (algunas cepas son capaces de virar la urea de Christensen en minutos); es sensible a la cefalotina y resistente al nalidixico (algunas cepas pueden ser sensibles); no son fermentadora de carbohidrato; crece a 37ºC.
Metodos indirectos:
- Prueba de la urea rápida (de Christensen) => un trozo de biopsia se inocula en un medio con alta concentración de urea y un indicador de pH.
- Prueba de la urea respiratoria => el paciente ingiere urea marcada y tras un periodo de tiempo se mide el nivel de CO2 espirado; se puede emplear urea marcada con C13, que se detecta con un espectrofotómetro de masas y urea marcada con C14 detectada con un contador de centelleo (un método diagnostico rápido y no invasivo, pero requiere un equipo especial par al lectura).
- Prueba serología => para detectar Acs utilizando la técnica de ELISA.
Patología - existen pruebas claras de que H.pylori esta implicado en diversas patologías gástricas, pero se cuestiona como la causa de dichas infección; parece claro que es agente etiológico de gastritis aguda; se piensa que también pueda tener un papel en la gastritis crónica activa; en las ulceras pépticas se aísla 100% de pacientes con ulcera duodenal y 77% de ulcera gástrica; parece ser que su presencia no es suficiente para desarrollar la ulcera; no esta claro el papel que desempeña en la dispepsia no ulcerosa, en el reflujo gastro-esofágico y en el carcinoma gástrico; hasta 50% de la población adulta de >60 años es portadora de este microorganismo; se desconoce su modo de transmisión; se ha propuesto una posible adquisición del mismo por contacto con animales, región periodontal y transmisión persona-persona (ninguno están demostrados)
Sensibilidad antibiótica - H.pylori es sensible in vitro a un gran numero de ATB, pero, el tratamiento in vivo es difícil; nunca se emplea mono-terapia porque no es eficaz, suelen administrarse varios fármacos juntos y aun así no se consigue erradicar al m.o. por lo que son frecuentes las recaídas tras la supresión de la terapia.
Tema 26 - VIROLOGÍA CLÍNICA (características generales de los virus)
Introducción - virus es un parásito intracelular estricto que requiere infestar una célula para sintetizar sus componentes y ensamblar nuevos viriones; son de muy pequeños tamaños (filtrables) y se caracteriza por su mecanismo de replicación, organización y composicion; virología clínica se remonta al siglo XX y la composicion de un virus fue determinada por Schlesinger en 1933; en los últimos años se han descubierto otros agentes infecciosos mas simples como los viroides y los priones;
- los viroides => moleculas circulares de ARN de bajo Pm sin cubierta proteica que causan enfermedades a las plantas, infectar a los hombres y animales;
- los priones => son proteínas que parecen estar codificadas por genes celulares y actúan como señales reguladoras en las celulas que invaden, resistentes a los procesos físico-químicos que inactivan a los virus y no producen respuesta inmune o inflamatoria en el huésped; provocan prurigo lumbar de las ovejas y cabras (scrapie), encefalopatía espongiforme en las vacas y enfermedades neuro-degenerativas transmisibles en el hombre (p.ej. Creutzfeldt-Jacob /encefalopatía espongiforme progresiva y síndrome de Gerstman-Straussler-Streinker y el kuru); la patogenia (de todas) se caracterizan por desordenes progresivos como ataxia (dificultad motórica), demencia, deterioro cognitivo y motor; tras un periodo de incubación largo (meses o años), aparecerá los sintomas clínicos; el tropismo de la infectividad es SNC, seguido por el bazo y nódulos linfáticos; en el cerebro se detecta acumulación anormal de proteína-prion en el genoma del huésped; los priones son resistentes a las proteasas e induce una degeneración neuronal.
Concepto de virus - es un bloque de material genético (ADN o ARN) rodeado de una cubierta proteína (cápside) que le sirve como vehículo para su transmisión; algunos presenta membrana lipídica (envuelta) que se adquieren de la membrana citoplasmática de la célula infectada durante el proceso de salida; los virus envueltos tienen un matriz proteica que sirve como puente entre la nucleocápside y la envoltura; carecen de organelas citoplasmáticas para crecer y multiplicarse, por lo que necesitan la maquinaria de una célula huésped, pero si poseen algunos enzimas (nucleasas, transcriptasas, etc.); virión es la partícula viral completa (genoma + nucleocápside); se clasifican por el tipo de huésped que parasitan (virus animales, vegetales, bacteriófagos)
Estructura y morfología de los virus - son de tamaño entre 20-25 nm hasta 200-300 nm; su observación requiere un microscopio electrónico.
- Estructura del genoma => ADN o ARN mono-catenario o bicatenario; la mayoría de virus ARN tienen genomas mono-catenaria excepto los reovirus/rotavirus (bicatenario); los virus ADN suelen ser bicatenario, excepto parvovirus (mono-catenario); los genomas (core o núcleo) pueden ser moleculas lineales o circulares únicas o segmentadas en varios fragmentos.
- Estructura de la cápside => su función es de proteger el genoma del medio extracelular y facilitar la entrada al interior de la célula; están compuestas de subunidades proteicas repetidas (capsómeros) que a su vez están compuestas de moleculas proteicas (protómeros); según la disposición que adopten los capsómeros /la cápside, se clasifican en virus de simetría helicoidal (normalmente son virus ARN), icosaedrica (20 caras triangulares y 12 vértices) y compleja.
- Estructura de la envoltura => los lípidos de la envoltura es lipoprotéica y procede de la membrana célula infectada, pero las proteínas suelen ser virales desplazados a las proteínas celulares originales; en algunos casos, las proteínas incluyen una matriz (proteína M) que contacta/ engancha con la nucleocápside; los virus envueltos tienen estructuras glucoprotéicas (espículas) importantes para los procesos de adsorción y penetración al interior de la célula.
Ciclo vital de los virus - las estrategias de replicación varían dependiendo de la estructura del virus y de su material genómico, pero en general conlleva pasos de => adsorción/ adherirse - penetración - decapsidación - replicación - ensamblaje - liberación.
- Adsorción => la unión de la partícula viral a la superficie de la célula; no requiere energía y no depende de la temperatura; intervienen moleculas proteicas de la superficie del virión (proteínas de unión) y proteínas de la superficie de la membrana de la célula diana (proteínas receptoras); en los virus envueltos, la proteína de adherencia viral son las espículas de la capa externa de la envoltura.
- Penetración => tras ser adherido, se penetra el virión completo o solo el genoma y las polimerasas entran en el citoplasma celular, esto se lleva a cabo por 3 mecanismos: penetración directa, endocitosis o fusión; penetración directa => la membrana solo permite la entrada del genoma viral (ocurre en virus sin envuelta p.ej. fagos); endocitosis => los viriones adsorbidos, quedan rodeados por la membrana citoplasmática de la célula huésped formándose una vesícula endosómica (mecanismo mas utilizados de los virus sin envuelta); fusión => utilizado por los virus envueltos; existen 2 maneras de fusión: en los paramyxovirus, su envuelta se fusiona con la membrana citoplasmática directamente y la nucleocápside se libera al interior del citoplasma; en el resto de virus envueltos, la envoltura viral se fusiona con la membrana celular formándose una vesícula endosómica que posteriormente libera la partícula viral hacia el citoplasma.
- Decapsidación => se degrada la cápside viral para que el genoma viral pueda liberarse e iniciar la transcripción y la traducción; en la mayoría la penetración y la decapsidación se produce a la vez.
- Replicación => es la fase donde se produce la síntesis de todas las macro-moleculas virales; la célula huésped debe proporcionar la energía y los medios suficientes que a veces puede afectar su propio metabolismo celular, pero en otros casos apenas se alteran; es esencial que los ARNm transcriban la información viral y la replicación de la información genética y que posteriormente mediante los componentes celulares se traducen para fabricar proteínas que se necesitan.
a. Replicación de virus ADN bicatenario => tras la adsorción y la penetración, el ADN viral es liberado y penetra en el núcleo + ARN polimerasas celulares => ARNm transcrito y traducido para la síntesis ADN viral; para el proceso de traducción => ARNm emigra al citoplasma celular y es traducido para formar las proteínas de la cápside => que posteriormente son transportadas al núcleo para ensamblar el virión completo que serán liberados por lisis celular; la excepción dará al virus ADN poxvirus (grande y de simetría compleja) que realiza el proceso de transcripción y traducción en el citoplasma celular utilizando su propia ARN polimerasa dependiente del ADN viral, ya que no pueden utilizar ARN de la célula huésped que se localiza en el núcleo.
b. Replicación de virus ADN mono-catenario (fagos, parvovirus) => necesitan un intermediario replicativo para formar ADN bicatenario que puede transcriben el ARNm (ARN polimerasa celular necesita como plantilla una ADN bicatenario); como resumen: ADN mono-catenario + ADN polimerasas de la célula huésped => produce ADN bicatenario + ARN polimerasas celulares => forma ARNm
c. Replicación de virus ARN mono-catenario de polaridad (+) => ARN viral penetrado en el citoplasma de la célula huésped es reconocida de inmediato como ARNm por los ribosomas, los cuales la captan e inician su traducción a proteínas virales y también un enzima RNA polimerasa (transcriptasa); RNA polimerasa producida + ARN viral (se utiliza como molde) => replicación del ARN viral (todo ocurre en el citoplasma independientes del ADN del huésped).
d. Replicación de virus ARN mono-catenario de polaridad (-) => su ARN de polaridad (-) complementa el ARNm que es de polaridad (+); mediante su propio ARN polimerasas sintetizara el ARNm que después le servirá de molde para la síntesis de nuevo ARN de polaridad (-) y también para la traducción de sus proteínas utilizando la maquinaria celular.
e. Un caso especial de Retrovirus => virus ARN mono-catenario de polaridad (+) que poseen un enzima transcriptasa de reversión (transcriptasa inversa / retro-transcriptasa); su genoma ARN + retro-transciptasa => produce ADN de polaridad (-) + (la misma) retrotranscriptasa => origina ADN bicatenario que se integran al ADN celular y permanece alli durante tiempo prolongado; En un momento dado el ADN integrado se reactiva y es transcrito a ARNm vírico por la polimerasa del huésped y entonces, se completa el ciclo replicativo.
- Ensamblaje y liberación => se puede producir tanto en el núcleo como en el citoplasma, tras la replicación del genoma viral y la transcripción de las proteínas virales, los viriones se ensambla y se libera de la célula huésped; consiste en la unión ordenada del acido nucleico y de las proteínas para formar la nucleocápside, dando lugar a un virión viable; la liberación de los virus sin envuelta (desnudos) se produce por lisis celular; en caso de virus envueltos, salen al exterior por gemación de una zona de la membrana nuclear o citoplasmática (depende si son virus ADN o ARN); la zona de la membrana por donde se producirá la gemación, adquiere primero las espículas y las proteína de la matriz (codificadas por el virus), que atrae a la nucleocápside, fusionándose a la membrana, formándose la envuelta y liberándose el virión al exterior; en caso de poxvirus (mas grandes y complejos), estos pueden sintetizar sus propias envueltas; en caso de retrovirus, el virus no se libera de la célula sino que se integra en su genoma y permanecer así largo tiempo o de por vida; el proceso de ensamblaje y liberación es a veces ineficaz, formándose partículas no infectivas.
Taxonomía vírica - los virus se dividen en familias, genero, especie o tipo y según su forma del genoma, tamaño, forma, estructura, sintomatología clínica que producen, tropismo celular, etc; según el tipo de genoma que contienen y su estructura => se clasifica en virus ARN y virus ADN.
Virus ARN
1. De simetría cubica o icosaedrica sin envuelta - mono-catenario de polaridad (+) que utiliza su propio ARN como mensajero (pueden ser inmediatamente traducidos por la célula huésped ya que no se necesita transcribir ARNm) con la excepción de Reoviridae (bicatenarios) que utilizan su propia ARN polimerasa para transcribir ARNm; todos se ensamblan en el citoplasma de la célula huésped y son resistentes al éter.
- Familia Reo-viridae => tamaño intermedio (60-80 nm de diámetro), los únicos bicatenarios; el mas importante para el hombre es el Rotavirus (provoca problemas diarreicos), tiene forma redonda.
- Familia Calici-viridae => son pequeños (35-39 nm), tienen poca importancia en microbiología clínica; el mas importante /patógeno para el hombre es el virus de Norwalk (productor de gastroenteritis) y el virus de Hepatitis E (su inclusión no es definitiva)
- Familia Picorna-viridae => son pequeños (20-30 nm); los géneros mas importantes son los Enterovirus (>70 enterovirus que incluyen el Poliovirus, Echovirus, Cosxackievirus y el virus de la hepatitis A) y los Rhinovirus (>100 rhinovirus).
2. De simetría cubica o icosaedrica con envuelta - mono-catenario de polaridad (+), todos se ensamblan en el citoplasma de la célula huésped y son sensibles al éter.
- Familia Retro-viridae => son grandes +/- 100nm, de elevado Pm, contienen trazas de ADN y poseen transcriptasa inversa (retro-transcriptasa) en su dotación; adquieren su envoltura en la membrana citoplasmática de la célula huésped; se engloban todos los virus ARN tumorales; se divide 3 subfamilias: Oncoviridae (causan tumores y canceres), Spumaviride y Lentiviridae (dentro de esta estaría VIH).
- Familia Toga-viridae => son de 40-70 nm y adquieren su envoltura en la membrana citoplasmática; se incluyen la mayoría de los arbovirus (transmitidos por artrópodos - los arbovirus pertenecen a numerosas familias como Togaviridae, Flaviviridae, Arenaviridae, Reoviridae); se incluyen también los no arbovirus: Alphavirus con virus Sindbis su principal tipo, Pestivirus con el virus de la diarrea mucosa como su principal tipo y Rubivirus con rubeolavirus su principal tipo.
- Familia Flavi-viridae => son de 40-50 nm y adquieren su envoltura en las membranas intra-citoplasmáticas (antes se incluyen dentro de la familia Togaviridae y los han separado por su menor tamaño y por el lugar de su ensamblaje que ocurre en el retículo endo-plasmático); incluyen 2 géneros de importancia clínica: (1) Flavivirus (antes llamados arbovirus del grupo B) que destaca el virus de la fiebre amarilla y del dengue; (2) virus de la Hepatitis C; actualmente se incluye de manera no definitiva al virus de la hepatitis G.
3. De simetría helicoidal - todos son envueltos, mono-catenario de polaridad (-) que utiliza su propia transcriptasa (ARN polimerasa) para transcribir ARNmensajero; se ensamblan en el citoplasma y son sensibles al éter.
- Familia Rhabdo-viridae => de forma bala o bastón; el diámetro del cilindro +/- 70nm con longitud de 175nm; adquieren su envuelta en la membrana citoplasmática; el genero mas importante es virus de la rabia.
- Familia Paramyxo-viridae => de tamaño 150-300nm, son pleomórficos predominando formas esféricas rugosas y filamentosas; adquieren su envuelta en la membrana citoplasmático; se incluyen 3 géneros: Paramyxovirus (virus de la parotiditis/paperas, parainfluenza tipos 1,2,3,4A,4B...), los Morbilivirus (virus del sarampión, entre otros) y los Pneumovirus (virus sincitial respiratorio - causan bronquiolitis en niños pequeños).
- Familia Orthomyxo-viridae => morfológicamente semejante a la familia Paramyxoviridae pero mas pequeños 80-120nm, parecidos también a la familia Rhabdoviridae (los 3 proceden de un ancestro común); adquieren su envoltura en la membrana citoplasmática; se incluyen 2 géneros: los virus de la influenza o de la gripe tipos A, B y C.
- Familia Arena-viridae => de tamaño 50-300nm, adquieren su envoltura de la membrana citoplasmática; algunos producen infecciones virales "lentas"; el mas importante es virus de la fiebre de Lassa (en Africa).
- Familia Bunya-viridae => de tamaño 80-100nm, de forma esférica, adquieren su envoltura en el aparato de Golgi; la mayoría de los géneros son arbovirus.
- Familia Corona-viridae => de tamaño 80-130nm, morfológicamente se parecen a Orthomyxovirus, pero sus proyecciones en la superficie a modo de pétalos o "corona solar"; adquieren su envoltura en las membranas intra-citoplasmáticas; la mayoría de los géneros son virus respiratorios de vías altas.
Virus ADN
a. De simetría cubica o icosaedrica sin envuelta - su genoma es ADN bicatenario con excepción de Parvo-viridae (mono-catenario); todos se ensamblan en el núcleo y son resistentes al éter
- Familia Adeno-viridae => de tamaño mediano 70-90nm; se conocen 34 tipos que afectan al hombre y mucho de ellos afectan el tracto respiratorio.
- Familia Parvo-viridae => de tamaño muy pequeño 18-26nm con genoma ADN mono-catenario; la mayoría no tienen importancia clínica, excepto parvovirus B19, pertenece al genero Parvovirus que causa eritema infeccioso.
- Familia Papova-viridae => son de tamaño pequeños 45-55nm con ADN de tira circular; el genero mas importante es el Papilomavirus o virus de las verrugas con 66 tipos de papilomavirus humanos (PVH); los Papovavirus en general producen enfermedades latentes y crónicas y algunos son oncogénicos.
b. De simetría cubica o icosaedrica con envuelta - son bicatenarios y todos se ensamblan en el núcleo con excepción de Irido-viridae que se ensamblan en el citoplasma.
- Familia Herpes-viridae => de tamaño medio +/-100nm, adquieren su envoltura en la membrana nuclear y son sensibles al eter; de los 80 virus que existen, solo 8 tienen interés clínico para el hombre y se divide en 3 subfamilias: (1) Alphaherpesviridae con géneros importantes el virus Herpes simples tipo 1 y 2 y el virus Varicella-zoster; (2) Betaherpesviridae con géneros Citomegalovirus al citomegalovirus humano (Herpesvirus humano tipo 5) y al Herpesvirus humano tipo6, y al genero Roseolovirus con el herpesvirus humano tipo 7; (3) Gammaherpesvirus que incluyen virus de Epstein-Barr (herpesvirus humano tipo 4) que provoca enfermedad de Beso, pertenece al genero Limphocriptovirus.
- Familia Hepadna-viridae => de tamaño 40-50nm, adquieren su envoltura en el citoplasma, son resistentes al éter y poseen un genoma ADN parcialmente bicatenario; el mas importante es el virus de la hepatitis B.
- Familia Irido-viridae => de tamaño grande 130-300nm, sensibles al éter, adquieren su envoltura en la membrana citoplasmática y también se ensamblan en el citoplasma (a diferencia de otros); no tienen importancia clínica para el hombre, pero si en veterinaria como el virus de la fiebre porcina africana.
c. De simetría compleja
- Familia Pox-viridae => son virus animales mas grandes 230x400nm de forma ladrillo o ovoide; se caracteriza como la única familia de virus ADN que se replica y ensambla en el citoplasma, pues contienen una RNA polimerasa ADN dependiente (no necesita la maquina nuclear), de hecho su replicación es posible en celulas a-nucleadas (sin núcleo); son resistentes al éter y poseen una doble envuelta (una la adquieren en el aparato Golgi y la otra en la membrana citoplasmática; los mas importante son virus de la viruela, virus de la vacuna o vaccinia y virus del molluscum contagiosum.
Principales familias de virus de interés clínico
1. Virus ARN (mono-catenario)
1.1. Familia Reo-viridae (tamaño mediano 60-80nm - icosaedrico - sin envuelta - se ensamblan en el citoplasma) - contiene 6 géneros, únicamente cabe destacar Rotavirus)
Rotavirus (forma de rueda - el único bicatenario) => descubiertos en 1973 en niños con gastroenteritis; el único con importancia clínica (agente causal de gastroenteritis esporádica y epidémica en lactantes y niños; la infección suele ser asintomática en neonatos; afecta principalmente a niños entre 6-24 meses; la prevalencia máxima en invierno y raramente en verano; periodo de incubación 1-3 días, precediendo los vómitos a la diarrea que suele mantenerse de 4-5 días; el virus se detecta en heces (dura bastante horas fuera del huésped)
1.2. Familia Calici-viridae (pequeños 35-40 nm - icosaedrica - sin envuelta - de polaridad+) - se ensamblan en el citoplasma) => tiene poca importancia en clínica, posibles agentes causales de gastroenteritis en cualquier día del año y a cualquier edad; es el agente Norwalk (virus que causan gastroenteritis en EEUU) que ahora esta dentro de Parvovirus - Parvoviridae; se incluye de forma no definitiva el virus de Hepatitis E.
1.3. Familia Picorna-viridae (virus muy pequeños 20-30nm - icosaedrica - sin envuelta - de polaridad+) - es una familia importante y una de las que mayor numero de virus presenta, destacando 2 géneros Enterovirus y Rhinovirus.
Enterovirus - se asocian con distintos síndromes clínicos como parálisis, meningitis aséptica, encefalitis, miocarditis, pericarditis, pleurodinia, herpangina, infecciones agudas del tracto respiratorio y fiebre aftosa; son habitantes transitorios del tracto digestivo humano; existen >70 sero-tipos, siendo el tipo 72 es el virus de la Hepatitis A; todos se diseminan por vía fecal-oral y la mayoría son asintomáticas; los mas importantes son Poliovirus, Echovirus y Coxsackievirus;
- Los virus de poliomielitis /Poliovirus son tres (tipos 1,2 y 3), mas temidos normalmente por la parálisis flácida (de cintura para-bajo) y deformidades aunque son complicación infrecuente; la vacuna es de Sabin (virus atenuados), también Salk (virus inactivados); la vacuna de poliomielitis se administra a los niños de 2-4-6-18 meses.
- Los virus Echo y Coxsackie tienen distintas manifestaciones (muy ubicuo/ de todo tipo).
Para el diagnostico debe recurrirse al cultivo; el aislamiento de un enterovirus de heces o de faringe no indica necesariamente una relacion causal con el cuadro clínico, y deben descartarse otras causas; por el contrario si se trata de LCR.
Rhinovirus - agentes etiológicos mas frecuentes del resfriado común (rinitis agudas); existen >100 tipos
1.4. Familia Toga-viridae y Familia Flavi-viridae (toga=envuelta - icosaedrica - de polaridad+ - se ensamblan en el citoplasma); ambos son de forma icosaedrico, virus de RNA mono-catenario con envuelta; se incluyen la mayoría de los arbovirus; los v.Togaviridae (pequeño 40-70 nm, adquiere su envuelto en la membrana citoplasmática de la célula mientras los v.Flaviviridae (40-50 nm, lo adquieren de retículo endo-plasmático; dentro de Togaviridae están los arbovirus y los géneros no arbovirus como Alphavirus (sindbis), Pestivirus y Rubivirus (rubeola) dentro de Flaviviridae esta el virus Hepatitis C y otros que producen enfermedades como fiebre amarilla, dengue, de genero flavivirus que pertenecen a los arbovirus tipo B (transmitidos por artrópodos).
Virus de la Rubeola del genero Rubivirus (no es un arbovirus) - descrito hace >200 años; consta la importancia como agente causal de malformaciones congénitas desde la epidemia de 1940 en Australia (un oftalmólogo australiano constato un elevado numero de cataratas congénitas y ceguera asociados a esta enfermedad); la infección suele ser benigna y auto-limitada; sintomas => procesos respiratorios superiores leves, erupción eritematosa y linfadenopatía sub-occipital y retro-auriculares; en adultos se puede complicar con artritis transitoria o artralgias; rara vez produce encefalitis o purpura trombocitopénica; muy importante la infección en gestantes por posibles aparición de sordera neuro-sensitiva, alteraciones cardíacas, cataratas, retraso del crecimiento y sintomas encefalíticos; la incubación dura 14-21 días; diagnostico por método serológico (técnica de ELISA) para detectar IgG y sobre todo IgM en las embarazadas y un resultado positivo indica inmunización frente al virus; actualmente es poco frecuente debido a la vacuna obligatoria que se incluye en la triple vírica (paperas, sarampión y rubeola) que se pone a los niños de15 meses (suele dar inmunidad permanente) y una dosis de recuerdo a los 6 años (solo las niñas); a los 11 años solo se dan vacuna de varicela.
Clínica de Rubeola => empieza con eritema en la cara y se extiende hacia abajo (es un eritema maculo papuloso); es menos llamativo que de la sarampión; dura +/- 3 días y puede haber enantema palatino.
1.5. Familia Retro-viridae (de tamaño grande +/- 100nm - icosaedrica - con envuelta - de polaridad+ - se ensamblan en el citoplasma) => poseen enzima transcriptasa inversa / retro-transcriptasa; a esta familia pertenece el virus de la inmuno-deficiencia humana VIH que se estudia aparte.
1.6. Familia Orthomyxo-viridae (de tamaño 80-120nm - helicoidal - envuelta - de polaridad (-) y se ensamblan en el citoplasma) - en1918 tras la Guerra Mundial, mato mas personas que la propia guerra; esta compuesta por los distintos tipos de virus influenza/ Gripe (tipo A, B y C).
Virus Influenza /la gripe española (empezó en España) - causan gripe, infección respiratoria aguda epidémica normalmente durante mes de noviembre-abril; la vía de transmisión es aérea, periodo de incubación 1-4 días, seguido de clínicas tipo respiratorias superior, mas grave en los ancianos; se realizan campañas de vacunación todos los años (sobre todo a los ancianos y pacientes bronco-pulmonares), ya que presentan gran variabilidad antigénica segun el serotipo que causa la epidemia (tiene gran poder mutagénico); existe 3 tipos => A, B y C (A y B causan epidemias de importancia); los influenza A se subdividen según la diferente composicion antigénica (en la envoltura) de la hemaglutinina y la neuraminidasa; el diagnostico es clínico; recientemente se introduce metodos de diagnostico de muestras clínicas de antígenos virales; el de mayor importancia clínica es virus respiratorio sincitial (VRS); para el diagnostico rápido se usa la inmuno-fluerescencia directa en aspirados naso-faringeos, esputos o biopsia de pulmón; existe un kit con Ags virales para detectarlos.
1.7. Familia Paramyxo-viridae (de tamaño grande 150-300nm - helicoidal - envuelta - de polaridad (-) y se ensamblan en el citoplasma) => morfológicamente parecida al de anterior/ Orthomyxoviridae; todos ellos son causas importantes de enfermedad respiratoria en los niños; se incluyen 3 géneros Paramyxovirus (virus de la parotiditis/paperas y parainfluenza), Morbilivirus (virus del sarampión), Pneumovirus (virus sincitial respiratorio)
Virus Parainfluenzae (VPI) del genero Paramyxovirus - los 5 tipos de VPI producen infecciones del tracto respiratorio, siendo el 1 y el 2 los principales causantes de laringo-traqueobronquitis, el 3 de bronquiolitis y neumónia en niños (segundo agente después del VRS), el 4 y el 5 causan infecciones mas suaves; el diagnostico es clínico.
Virus respiratorio sincitial (VRS) del genero Pneumovirus - es la causa mas importante de neumónia y bronquiolitis en niños y recién nacidos; produce un amplio espectro de infecciones, siendo la mas frecuente es el resfriado común con abundante rinorrea; VRS es muy contagioso y se manifiesta en forma de brotes invernales; la inmunidad no es completa por lo que se dan las re-infecciones (mas suaves); Es importante que la excreción de virus se mantenga durante 2 o 3 semanas (mas tiempo para los inmunodeprimidos), por lo que al ingresar un niño en el hospital durante 1 o 2 semanas, puede ser contagioso todavía (es el agente mas frecuente de infección nosocomial en pediatría); las infecciones graves se trata con la ribavirina (inhibe la síntesis del ARN viral); el diagnostico rápido es la inmunofluorescencia en secreciones respiratorias.
Virus del Sarampión - causa una enfermedad aguda, febril, exantemática, de gravedad variable que afecta a niños de 5-9 años, se contagia por vía respiratoria y conjuntival; sintomas clínico => los primeros días como un catarro naso-oculo-faringo-laringeo, luego aparece fiebre, cara rubicunda, congestión de mucosa y a los 3-4 días aparece "manchas Koplik" (manchas blanquecinas diminutas delante del 1º y 2º molar) dura un par de días; empieza aparecer exantema, primero retro-auricularmente, despues se extiende a todo el cuerpo, las palmas y las plantas de los pies mas tenue en zonas distales, sube a la fiebre y el exantema tenue se hace muy eritematoso; tras 2-3 días mejora bruscamente y desapareciendo los signos en el orden del aparecimiento (dará inmunidad permanente); el diagnostico es por metodos serológicos.
Virus de la parotiditis - es una enfermedad endémica con incidencia todo el año; es rara en niños < 1 año, gracias a la inmunidad de la madre; afecta a niños de 5-14 años, se transmite por vía aérea y por objetos introducidos a la boca (dará inmunidad permanente); clínica => tras 24horas de clínica inespecifica, aparecerán dolor y tumefacción de retro-parotidia y oído, aumento de fiebre, puede haber afectación de nervio facial leve y bilateral; complicación => meningitis, orquitis, pancreatitis o artritis; diagnostico es por vía serológico; el diagnostico es por metodos serológicos.
1.8. Familia Rhabdo-viridae (de tamaño grande en forma de bastón, diámetro 70nm y longitud 175nm - helicoidal - con envuelta - de polaridad (-) y se ensamblan en el citoplasma) => característica típica de su morfología es forma de "bala"; el mas importante es el causante de la rabia o hidrofobia (se atraganta con el agua).
Virus de la rabia - causa enfermedad infecciosa aguda del SNC, de gran importancia histórica por los trabajos de Pasteur; existe la obligación de vacunar todos los años a perros y gatos, ya que es una zoonosis en la que el hombre es un eslabón irrelevante; existen 2 formas epidemiológicas => urbana (lo adquieren perros y gatos no inmunizados) y salvática (los zorros); normalmente el virus esta presente en la saliva de animales rabiosos, transmitiéndose por mordeduras (son fuentes de infección humana); el diagnostico solía realizarse postmortem, mediante la observación de los cuerpos de Negri (cerebro); también se pueden cultivar en laboratorio; clínica de animales => cambian de carácter, se vuelven caprichosos, pierden apetito, ingerir objetos no engullibles autllan con ronca, irritabilidad creciente y muerden a personas y animales; mueren en 2 semanas; clínica de humanos => la incubación 1-3 meses depende del lugar de la mordedura; el virus se propaga por los nervios a una velocidad 1mm/hora; comienza con la alteración del sueño, dolor de la mordedura, también parestesias/ hormigueos de la zona, trastornos respiratorios (en la voz), posteriormente aparece espasmos faríngeos tras la ingestión de líquidos o solo de verlo (hidrofobia), salivación espumosa y espasmos en las extremidades (basta con pequeños estímulos de luz o ruidos, para provocar lo); las personas suelen morir por parálisis en pocas horas tras la afectación de bulbo-raquídeo; el cuadro normal es de 3-6 días, después mueren.
1.9. Familia Corona-viridae (de tamaño 80-130nm - helicoidal - envuelta - de polaridad (-) y se ensamblan en el citoplasma) => adquieren su envoltura (con proyecciones a modo de pétalos/ corona solar) en las membranas intra-citoplasmáticas; escasa importancia en patología, únicamente causan el resfriado común y pueden estar involucrados en cuadros de gastroenteritis.
2. VIRUS ADN (bicatenario)
2.1. Familia Parvo-ridae (de tamaño muy pequeño 18-26nm - icosaedrico - sin envuelta - se ensamblan en el núcleo - resistentes al eter) => son de tamaño muy pequeño y son los únicos que presentan ADN de una sola hebra (mono-catenario); algunos tienen importancia en veterinaria y solo destaca uno como patógeno humano (Parvovirus B19).
Parvovirus B19 (estaban incluidos en virus Norwalk) - fue vinculado al eritema infeccioso en 1983; es benigna y afecta niños en edad escolar; presentan una erupción eritematosa en las mejillas (cara enbofetada) y un exantema en extremidades y tronco (respeta a las palmas, las plantas y los labios); los adultos son propensos a artropatía asociada, que se resuelve en 2-4 semanas; diagnostico por método serológico y metodos de ELISA.
2.2. Familia Papova-viridae (de tamaño pequeño 45-55nm - ADN de tira circular - icosaedrico - sin envuelta - se ensamblan en el núcleo - resistente al éter) => son unos viruses oncogénicos (efecto cancerígeno), producen enfermedades latentes y crónicas, causantes verrugas genitales o condilomas (se asocian a carcinoma de cérvix) y papilomas (Papilomavirus/ virus Papiloma humano); el diagnostico es de tipo clínico y serológico; prevención => se vacunan a las niñas de < 14 años.
2.3. Familia Adeno-viridae (de tamaño mediano 70-90nm - icosaedrico - sin envuelta - se ensamblan en el núcleo - resistente al éter) => producen principalmente patología al tracto respiratorio, ocular y gastroenteritis; las infecciones respiratorias solo son significativas en niños <6 años; el diagnostico se realiza mediante clínicas y técnicas serologícas.
2.4. Familia Hepadna-viridae (de tamaño pequeño 40-50nm - ADN parcialmente bicatenario - icosaedrico - envueltos - se ensamblan en el núcleo - resistentes al éter) => su envuelta se adquiere en la membrana citoplasmática y se ensamblan en el núcleo; en esta familia se encuentra virus hepatitis B que se estudiara a parte.
2.5. Familia Herpes-viridae (de tamaño medio +/-100nm - icosaedrico - envueltos - se ensamblan en el núcleo - sensibles al éter) => adquiere su envuelta de la membrana nuclear y se ensamblan en el núcleo; destaca 3 subfamilias => Alphaherpesviridae (VHS 1y2, virus Varicella-Zooster), Betaherpesviridae (CMV y Roseolovirus), Gammaherpesvirus (VEB/Limphocriptovirus); todos los virus producen infecciones latentes, capaces de reactivarse.
Virus Herpes Simple (VHS) - producen infecciones latentes que se reactivan con o sin lesiones que sirven de fuente de infección para individuos susceptibles (los virus de Herpes no se cura, solo se acantona y se puede reactivar); existen 2 tipos => VHS-1 (tropismo por lesiones por encima de la cintura y suele ser leve) y VHS-2 (se encuentra principalmente en los genitales, transmitiéndose por vía venérea); cada individuo tiene un tropismo estable; suele ser bucal, comienza con hormigueo y luego aparecen vesículas, costra y desaparece en +/- 1 semana; VHS-1 se transmite por secreción oral, infección a nivel peri-oral, también otras zonas como los ojos; VHS-2 normalmente daran infección genital y se contrae por vía sexual; en EEUU en ciertas capas sociales, es la enfermedad venérea mas frecuente; en mujer gestante se puede transmitir al bebe vía placenta o canal de parto o en los primeros días de vida; en general estos virus tienen capacidad oncogénicos como VEB (virus Epstein-Barr), puede producir cáncer cervical; el diagnostico se realiza mediante la tinción de Giemsa de celulas raspadas de lesiones herpéticas, para observar las características de las celulas gigantes multi-nucleadas; también se cultivan en SHELL-VIAL.
Citomegalovirus (CMV) - producen infección asintomática, pero con gran importancia en huéspedes inmuno-comprometidos; las infecciones se pueden clasificar en congénitas, peri-natales o pos-natales (antes o después del parto); es la causa mas frecuente de infección congénita; el CMV se ha detectado en saliva, orina, leche materna, semen, por lo que su transmisión es variada; también se transmite por transfusiones o trasplantes; en pacientes inmuno-competentes, normalmente son asintomática, si da clínica va a ser semejante a mononucleosis infecciosa (virus Epstein-Barr), como fiebre, adenopatias, hepatomegalia; en paciente inmunodeprimidos es diferente, en general dará fiebre, neumonitis, colitis, esofagitis, hepatitis, infección congénita y perinatal, puede dar retraso mental, ictericia y sordera; el diagnostico => por serología buscando Acs anti CMV (metodos ELISA), cultivo en SHELL-VIAL (artificial) ya que no se pueden cultivar en celulas vivas.
Virus Varicela-Zóster (VVZ) - la varicela y el herpes zóster representan diferentes manifestaciones clínicas de un mismo virus; la varicela es mas frecuente en niños y se caracteriza por fiebre y exantema vesicular generalizado; es una infección primaria mientras su re-activación producirá el herpes zóster, aparece normalmente en adultos (cuando hay una disminución de la inmunidad) que consiste en una erupción dolorosa circunscrita de lesiones vesiculares, acompañada de inflamación de las raíces dorsales de los nervios raquídeos o de los ganglios sensitivos craneales; los estadios son => macula - pápula - vesícula - umbilicación - costra; característicamente existe estados evolutivos todos mezclado a la vez y prurito sobre todo en el tronco y cara (menos en las extremidades); el diagnostico sera tipo clínico y también por los distintos metodos en laboratorio => examen directo previa tinción Giemsa por microscopio electrónica, por serología (ELISA) y por cultivo celular.
Virus de Epstein-Barr (VEB) - es uno de los virus humanos mas ubicuos, linfotrópico y oncogénico; la infección primaria suele pasar en la infancia, aumentando su sero-prevalencia 60-70% en jóvenes y 80-90% en adultos; el síndrome clínico mas frecuente es la mononucleosis infecciosa (enfermedad de beso) que presenta fiebre, adenopatias, faringitis y linfocitosis con linfocitos atípicos; VEB también se ha asociado a carcinoma naso-faríngeo y al linfoma de Burkitt; diagnostico => la prueba de Paul Bunnell es la detección de Acs heterofilos y también por método de ELISA.
Herpesvirus Humano 6 (HHV-6) - es un virus de muy reciente aparición, se ha aislado en síndromes linfo-proliferativos y se ha vinculado al exantema súbito (elevación brusca de la temperatura hasta 40ºC de 2-4 días, seguida de un descenso rápido que coincide con la aparición de un exantema maculo-papular que persiste 1-2 días; el diagnostico sera clínico y serológico.
Herpesvirus Humano 7 - se descubrió en 1989 (reciente); tiene tropismo por los linfocitos T, provocando exantema súbito; se investiga si tiene relacion con síndrome de fatiga crónica (que lo padecen sobre todo mujeres mayores).
2.6. Familia Pox-viridae (ADN bicatenario - doble membrana) - son de tamaño grande 230-400nm, con forma de ladrillo, se replica en citoplasma y se ensamblan en el citoplasma; el mas importante es el virus de la viruela, virus de Moluscum Contagiosum y virus de la Vaccinia;
- Viruela se contagia por inhalación y tras 15 días aparece fiebre, mialgias y erupción pápula vesicular dura y luego evoluciona a pústulas y a la curación; a veces puede provocar muerte por exantema hemorragica o una sobre infección bacteriana.
- Virus de la Vaccinia es muy próximo al virus de la viruela; en individuos inmunodeprimidos puede provocar complicaciones, pero en los inmuno-competentes es auto-limitado; es importante en los principios de la vacunación (Jennen); últimamente se investiga su utilización como vector para actuar como vacuna contra virus de Hepatitis B, Herpes simple y VIH, ya que su genoma es susceptible de poder insertarle secuencias de genes que codifiquen proteínas de otros virus y que se expresarían posteriormente cuando el virus se replique, con lo cual tendríamos Acs contra estos virus.
- Virus de Moluscum Contagiosum - provoca enfermedad cutánea benigna, contagiosa que pueda adquirir por compartir objetos o contacto sexual; aparece en epidermis lesiones nodulares blancas de aspecto nacarado de 2-10 mm que son indoloras; cualquier traumatismo provoca su contagio; desaparece entre 2 meses y 1 año.
Esquema de Virus Respiratorio
HEPATITIS VIRAL - es una enfermedad sistémica que afecta fundamentalmente el Hígado; se conocen 7 virus de la hepatitis, denominados A,B,C,D,E,F y G que pertenecen cada uno a familias y géneros distintos, pero que tienen todos un tropismo hepático (no tienen relación taxonómica); existen además otros virus que producen hepatitis, como Citomegalo virus y el virus de Epstein-Barr; se pueden clasificar según la principal vía de transmisión y la tendencia a la cronicidad en 2 grandes grupos (1) transmisión fecal-oral y no cronifican: VHA, VHE y VHF (2) transmisión parenteral y pueden cronificar: VHB, VHC, VHD y VHG.
Virus de la Hepatitis A (VHA) - aislado en 1973, pero se sospechó mucho antes; virus ARN de la familia Picornaviridae (de pequeño tamaño 20-30nm, icosaédrica, sin envuelta, polaridad+) dentro del género Enterovirus, el tipo 72; la mayoría de infecciones son aguda sin cronificarse (<1% fulminante); se encuentra en las heces durante el periodo de incubación (hasta 2 semanas).
Transmisión - se disemina por la ruta fecal-oral (estrecho contacto persona-persona) con la implicación de agua y alimentos que pueden causar brotes epidémicos; la mayor excreción del virus en heces se da en las semanas previas a la aparición de la ictericia, sobre todo en la fase tardía de la incubación; otras vías de transmisión del virus son posibles pero poco probables; existe casos durante todo el año, con un pico en otoño.
Sintomatología clínica – suele ser menos grave que la hepatitis B; en general, la infección es asintomática y la gravedad aumenta con la edad; el periodo de incubación 20-45 días, a continuación suele aparecer fiebre, mialgias, fatiga, ictericia, anorexia, dolor de cabeza o dolor en epigastrio y aumento de las transaminasas (GPT, GOT) y hepatomegalia.
Diagnostico – requiere la confirmación del laboratorio; se observó el virus por la primera vez por Feinstone en 1973 y es cultivable, pero se utiliza la serología basada en la respuesta inmunitaria; el método más utilizado es ELISA detectando Acs IgMVHA en su fase aguda; también se pueden detectar Ags virales en heces (detectar Acs total de IgG y IgM no tiene utilidad clínicamente); IgM suele durar 6 meses; IgG confiere inmunidad y la mayor parte de nuestra población de >40 años los tienen; hasta la fecha no se han descrito casos de cronicidad.
Prevención – las medidas más importantes son la higiene personal, lavado y desinfección de manos y objetos contaminados; no es necesario el estricto aislamiento del paciente mientras se mantiene las medidas de desinfección-esterilización, cloración y nivel higiénico-sanitarias; inmunización pasiva => se dispone una inmunoglobulina eficaz tanto para profilaxis pre-exposición (se estudia la relación coste-eficacia antes de utilizarla/ solo si viajan a zonas endémicas) como post-exposición; inmunización activa => existe una vacuna con buenos resultados (virus inactivados) que se pone al mes, 6 meses y al año (3x).
Virus de la Hepatitis B (VHB) – es un virus ADN de la familia Hepadnaviridae (ADN parcialmente bicatenario, icosaédrica con envuelta, resistentes al éter), de gran importancia socio-sanitaria y distribución mundial (250 millones portadores asintomático – 1% desarrollan cirrosis hepática o carcinoma hepato-celular que son complicaciones más importantes); primeros casos se describieron en 1833 en Bremen (Alemania), por la administración de la vacuna de la viruela que contiene suero humano, pero hasta los años 40-50 no se distinguió de la hepatitis A; en 1965 Blumberg descubrió el Ag Australia y se identificó el virus.
Estructura – se distinguen una serie de estructura del virus que dan lugar a los marcadores serológicos:
-Ag de superficie => HBsAg o Ag Australia (marcador de infecciosidad, codificado por el gen S) que induce a la formación de HBsAc o anti-HBs que confiere inmunidad.
-Ag del core o nucleo-cápside => HBcAg codificado por el gen C que no se detecta en sangre pero si su HBcAc (marcador epidemiológico que se mantiene de por vida); IgM-HBcAc se detecta como marcador más fiable de hepatitis B aguda.
-Ag soluble => HBeAg que induce al HBeAc (HBeAg es el marcador de pronóstico de la enfermedad, ya que se correlacionan con el nivel de replicación del virus; HBeAc es un marcador de buena evolución).
-Además se distinguen su genoma ADN y una polimerasa.
- El virión completo se denomina partícula de Dane, ya que existen formas incompletas en sangre (como p.ej. HBsAg).
Infección por VHB – la mayoría son sub-clínicas/ asintomática (50-80%) y solo se detectan en controles serológicos; la mayoría de las infecciones sintomáticas son auto limitadas y se resuelven en menos de 6 meses (Hep.aguda); la lesión hepática puede ser nula o leve o llegar a casos de hepatitis fulminante (> de 6 meses se pueden cronificar); la sintomatología clínica es similar a la de Hepatitis A; un periodo de incubación es de 1-6 meses; entre 5-10% de las infecciones se hacen persistentes y se mantiene de por vida (como portador asintomático o sintomático); en la mayoría de ocasiones la función hepática y la histología son normales, pero en otras ocasiones dan lugar a síndromes hepatitis crónica persistentes (HCP) y hepatitis crónica activa (HCA); HCP es menos progresiva que HCA (puede ser más grave y desembocar en cirrosis).
Epidemiologia – existen áreas hiper-endémicas, endemia media y baja (España está en baja); el único reservorio importante es el hombre que transmite el virus por contacto íntimo (vía sexual, parenteral y vertical-perinatal) y mediante objetos personales o materiales de hospitales (familiares y personal sanitario corre un mayor riesgo); la existencia de HCP presenta un reservorio estable para el virus y asegura su supervivencia indefinida que se detecta en líquidos corporales (sangre, heces, orina, bilis, lagrimas, semen, leche materna, sudor, secreciones vaginales, LCR, liquido sinovial y sangre de cordón);
Marcadores en la infección aguda auto-limitada (en el orden de aparición):
-HBsAg (aparece antes del 1º mes y desaparece antes de 6º mes)
-HBeAg (aparece el 1º mes y desaparece antes del 3º mes)
-DNA viral (aparece después del 1º mes y desaparece al 3º mes)
-Anti HBc (aparece entre 1º-2º mes; Anti-HBc IgM desaparece antes del 5º mes => Hepatitis aguda)
-Anti HBe (aparece al 3º mes)
-Anti HBs (aparece antes del 7º mes)
Prevención – es la medida más eficaz para combatir la infección; es un virus muy contagioso cuando hay exposición parenteral; existe inmunización pasiva (gammaglobulina hiper-inmune eficaz en situaciones de pre y post-exposición ) y inmunización activa (vacuna de HBsAg que se administra universalmente a 0-1-6 meses que produce respuesta inmunitaria de 90-95%).
Virus de la Hepatitis D (VHD) – descubierto en 1977; es un virus ARN incompleto /defectivo que requiere HBsAg para su replicación (adquieren su envuelta del virus B y si no hay infección de por VHB no la hay por VHD).
Tipos de infección:
1-Coinfección => infección simultáneamente por ambos virus (VHB y VHD); el curso natural de VHB no se modifica; al resolverse la infección de VHB, re resuelve también la de VHD; clínicamente la hepatitis es más grave y la tasa de hepatitis fulminantes es mayor (hasta 20%).
2-Sobreinfección => cuando el VHD sobre infecta a portadores crónicos de VHB; aquí si se modifica el curso natural de VHB y la mayoría de las sobreinfecciones (70%) desembocan en hepatitis crónica y acaban en cirrosis entre 15-20 años.
El pronóstico de VHD depende de marcadores de replicación del virus (anti-HBe) => puede acabar en hepatitis crónica o cirrosis; cuando no hay marcadores de replicación => puede evolucionar a la curación.
Virus de la Hepatitis C (VHC) – es de reciente descubierto (1988 - aunque se sospechó desde hace mucho tiempo) del que quedan aún muchos interrogantes por resolver; en actualidad se sabe que VHC es responsable del 80-90% de los casos de hepatitis post-transfusional y del 20-50% de los hepatitis esporádica; es un virus del tamaño medio dentro de la familia Flaviviridae (virus ARN icosaédrica pequeño de tamaño 40-50nm con envuelta, de polaridad+ y sensibles al éter); se distingue regiones para la envoltura (E), el core (C) y otras no estructurales (NS).
Infección por VHC – se diseminan fundamentalmente por la vía parenteral; es la causa más frecuente de hepatitis post-transfusional, hepatitis esporádica y ampliamente distribuido entre ADVP (adicto a la droga de vía parenteral), pacientes en diálisis y hemofílicos; se puede transmitir por contacto sexual o convivencia con portadores (menor importancia que Hep.B); la clínica es similar a la de la hepatitis B; 25% cursan con ictericia y la tasa de mortalidad es <1%; el curso es indolente y prolongado; el inicio no es muy brusco, es frecuente las recurrencias, 50-70% tienden a cronificar y 20-25% acaban desarrollando cirrosis.
Prevención – tratar todo tipo liquido corporal como potencialmente infeccioso; todavía no se dispone inmuno-profilaxis; un paciente con VHC negativa no significa que no lo padece, porque la sensibilidad de las técnicas más utilizadas no es 100% fiable; si se sufre un accidente en el laboratorio o en la práctica clínica con sangre anti-VHC+, se debe realizar un protocolo de seguimiento serológico de la persona; existen evidencias de que VHC puede estar implicada en cáncer hepático.
Virus de la Hepatitis E (VHE) – se descubrió en 1983 y es responsable de la epidemias por transmisión fecal-oral en India, Paquistán, África del Norte y Méjico (países de baja salubridad); el curso es corto y parece ser que se puede transmitir parenteralmente, pero no transfusional-mente; el virus todavía no está catalogado, se parece más a los calcivirus da la familia Calciviridae (virus ARN icosaédrica de tamaño pequeño 35-40nm sin envuelta, de polaridad+); clínica => aunque no se cronifica al igual que VHA, tiene un pronóstico peor (la mortalidad 1-2%), más grave en gestantes del 3º trimestre del embarazo (mortalidad de 20%); la habitual vía de transmisión es a través del agua de bebida.
Virus de la Hepatitis G (VHG) – se transmite por vía parenteral; esta relacionado con virus de la familia Flaviviridae (virus ARN icosaédrica de tamaño pequeño 40-50nm, con envuelta de polaridad+); provoca aisladamente un cuadro benigno, pero puede dar una coinfección con el VHB y VHC con mayor tendencia a la cronicidad.
Virus de la Hepatitis F (VHF) – se transmite por vía entérica (fecal-oral)
SEROLOGIA DE LAS HEPATITIS VIRICAS (1993)
Marcadores serológicos para el diagnóstico de la hepatitis A – la mayoría de infecciones son aguda sin cronificarse (<1% se fulmina); se encuentra en las heces durante el periodo de incubación (hasta 2 semanas); su detección con fines diagnósticos no se emplea rutinariamente.
-Ac Anti-VHA IgM => siempre es positivo en el inicio de la sintomatología clínica (hasta 3-6 meses); se usa como marcador de infección aguda; en Ag viral es detectado solamente en el hígado y no se utiliza para el diagnóstico.
-Ac Anti-VHA IgG => su presencia demuestra un contacto previo con el virus (se mantiene durante largos periodos de tiempo).
Marcadores serológicos para el diagnóstico de la hepatitis B – la evolución clínica es variable (desde asintomática y anictérica hasta una enfermedad aguda que se puede complicar hacia la cronicidad, la cirrosis o forma fulminante fatal); es evidente su relación con el carcinoma hepato-celular; la determinación cualitativa y cuantitativa de ciertas proteínas virales (Ags) y de los Acs nos sirve para evaluar la situación actual y pronosticar el futuro de la infección.
-Ag de superficie HBs Australia (HBsAg) => se sintetiza en el citoplasma del hepatocito; debido a que los hepatocitos fabrica un exceso de estos, una parte es liberada a la sangre y puede ser detectada durante el periodo de incubación (es el 1º marcador que aparece, incluso 2-6 semanas antes de que aparezca los síntomas, aunque pueda haber de 5-10% de hepatitis aguda sin este marcador), en la fase aguda de la enfermedad y en el estadio crónico; si la evolución es favorable desaparecerá a los 3-6 meses de la enfermedad; por el contrario, si se mantiene más de 6-8 semanas después o si no existe una disminución significativa de su título, es indicio de mal pronóstico y de evolución a la cronicidad.
-Ac anti-HBs => es el indicador de recuperación de la enfermedad y el ultimo en aparecer (+/- a los 3 meses de su evolución); persiste durante mucho tiempo neutralizando al virus y confiriendo protección; en los individuos vacunados es el único marcador presente.
- Ac anti-HBc => Ag HBc pertenece a la cápside y no se detecta serológicamente, ya que no se encuentra libre, sino en el virus entero; solo se detecta Anti-HBc; es el 1º Ac que aparece en la enfermedad, detectable con los primeros síntomas de la enfermedad en la fase aguda y en la crónica (entre 3-5 semanas después de Ag Australia y es el 4º marcador en hacerse positiva); puede significar una infección pasada o curada dada la larga persistencia de estos Acs en el suero (su positividad confirmada en solitario no asegura la protección frente a la enfermedad).
-Ag e (HBeAg) => es parte del Ag core; proteolíticamente degradado y antigénicamente diferente; es el 2º marcador, detectable en la fase aguda y en algunas formas de enfermedad crónica en las que histológicamente se corresponde con hepatitis crónica activa (HCA); su valor clínico se funda en su excelente correlación con la presencia de replicación viral y viremia; la sangre con HBeAg (+) se debe considerar como infecciosa; su estudio es obligatorio en todos los sueros de HBsAg (+).
-Ac anti-HBe => es el 5º marcador; su aparición indica buena evolución y una baja infectividad del paciente; en la mayoría de los casos es detectable poco antes de que desaparezca HBsAg, pudiendo encontrarlo (+) durante varios años después de la infección.
-DNA viral libre (VHB-DNA) => es el 3º marcador; su detección en el suero mediante la hibridación no es una técnica de rutina, a pesar de tratarse de un marcador muy sensible tanto de la presencia del virus como de su actividad replicativa; el VHB-DNA es positivo en un elevado número de pacientes HBeAg (+).
Marcadores serológicos para el diagnóstico de la hepatitis D
1º- Antígeno delta (HDcAg) => aparece fugazmente en sangre en la primo infección y su utilizad clínica es muy limitada.
2º- Anticuerpos Anti-Delta (Anti-HD IgM) => es el marcador más importante que aparece después de la aparición del Ag y se mantiene positivo a bajos títulos a un tiempo limitado si la evolución es favorable; persistirá su positividad a títulos altos en casos que evolucionan a la cronicidad.
3º- Anticuerpos Anti-Delta IgG (Anti-HD IgG) => aparecen más tardía y se mantiene positivo durante largos periodos de tiempo; su detección indica solamente contacto con el virus.
Esquema evolutivo:
-Coinfección de VHB y VHD = Ag Australia (+), Anti-HBc IgM (+) y AntiHD IgM (+)
-Sobre infección de VHD en paciente con VHB = Ag Australia (+), Anti-HBc IgM (-) y Anti-HD IgM (+)
4º- RNA Viral (HD-RNA) => la positividad por técnicas de hibridación o PCR indica presencia del virus.
Marcadores serológicos para el diagnóstico de la hepatitis C
-Anticuerpos Anti-VHC => se detecta empleando Ags sintéticos o recombinantes; pruebas confirmatorias de Acs Anti-VHC => se detectan por método Western Blot para ver las bandas.
-RNA viral (VHC-ARN) => no se suele hacer porque la epidemia es corta.
Marcadores serológicos para el diagnóstico de la hepatitis E – se están comercializando pruebas que detectan Ag y Acs específicos (IgG y IgM) mediante técnica de ELISA.
DIAGNOSTICO DE LA INFECCION
A-Hepatitis Aguda
Marcadores de rutina (los que se suelen pedir al laboratorio):
VHA => anti-VHA IgM
VHB => HBsAg o Ag Australia y HBc IgM
VHC => anti-VHC (totales)
VHD => anti-VHD IgM (en pacientes ADVP)
Criterios generales de interpretación:
-La presencia de anti-VHA IgM => es diagnostica de infección aguda por VHA.
-La presencia de HBsAg y anti-HBc IgM => es diagnostica de infección aguda por VHB;
-La presencia simultánea de anti-VHD IgM y anti-HBc IgM asociada a hepatitis aguda => se considera diagnostica de coinfección aguda por ambos VHB y VHD; la presencia de anti-VHD IgM y HBsAg en ausencia de anti-HBc IgM => indica sobre infección por VHD en un portador crónico de VHB. En cualquier caso, dada la situación epidemiológica actual en España, no parece recomendable la búsqueda rutinaria de la infección delta en pacientes ADVP.
-La seroconversión de anti-VHC es un criterio fiable para un diagnóstico de infección aguda por VHC (cambio de negativo a positivo); la seroconversión suele retrasarse mas de 3 meses desde el comienzo de los síntomas, por lo que requiere el estudio de muestras de seguimiento al menos hasta el 6º mes; no se ha demostrado que la detección de anti-HVC IgM sea de utilidad en el diagnóstico de la hepatitis C aguda.
Criterios de interpretación en pacientes ADVP – las tasas de seropositividad para VHB (anti-HBc total) y VHC (anti-VHC) en individuos ADVP superan el 80%; entre los ADVP crónicamente infectados por VHB (positivos para HBsAg), la seropositividad para VHD (anti-VHD total) se aproxima a dicho porcentaje; es frecuente que los ADVP se hallen crónicamente infectados por uno o más de dichos agentes en un episodio de hepatitis aguda, resultando imposible precisar su etiología.
B-Hepatitis Crónica
Marcadores de rutina:
VHB => HBsAg y anti-HBc total (IgM + IgG)
VHD => anti-VHD total (en pacientes ADVP positivos para HBsAg)
VHC => anti-VHC
Criterios de interpretación:
-La presencia de HBsAg y anti-HBc total asociada a hepatitis crónica => es diagnostica de hepatitis B crónica; la presencia adicional de anti-VHD total => indica una sobre infección crónica por ambos VHB y VHD.
-La presencia de anti-VHC asociada a hepatitis crónica => es altamente indicativa de hepatitis C crónica, aunque no es un diagnostico seguro; la detección de ARN viral en suero mediante PCR ayuda a establecer el diagnostico, pero un resultado negativo aislado no lo descarta, ya que la viremia es intermitente en muchos casos; dado el alto costo de métodos de confirmación de anti-VHC, se considera que una re comprobación del resultado positivo mediante un segundo método de cribado (método screening con técnica de ELISA) que utilice Ags obtenidos por tecnología diferente, es suficiente para establecer la presencia de anti-VHC en pacientes con hepatitis crónica.
VIH o SIDA
Descubrimiento del virus – se sospechó desde 1981 en 5 casos de neumonía por Pneumocystis carinii en varones homosexuales previamente sanos y va aumentando el número de casos y se fue asociando esta inmunodeficiencia adquirida al sarcoma de Kaposi; en junio de 1982 se contabilizaron 439 casos y en EEUU se emite un informe para definir los casos de SIDA; en febrero del mismo año Montagnier expone la hipótesis de un retrovirus linfotropico pudiera ser el agente causante del síndrome; en Mayo de 1983 se aislo por primera vez el virus por Montagnier en Francia a partir de un ganglio linfático de un paciente con linfadenopatia persistente (LAV) y Gallo en EEUU de un enfermo de SIDA (HTLV-III).
El virus – es un virus ARN de la familia Retroviridae, subfamilia Lentiviridae (=incubación lenta >10 años) con tipos 1 y 2; esta familia de virus se caracteriza por sintetizar ADN a partir de ARN viral, mediante una retro-transcriptasa; consta de nucleo-cápside y envoltura; es muy sensible a los agentes químicos y calor; sus principales genes son:
a) Estructurales:
-Gen GAG (Core) => proteínas 24
-ENV (Envoltura) => glicoproteínas 41, 120 y 160
-POL (Polimerasa) => es importante
b) Reguladores => genes que regulan la replicación viral y el papel de todos ellos no está completamente dilucidado
Patogenia – en la infección aguda, el virus se une principalmente a receptores CD4 gracias a gp41 y gp120; por lo tanto, sus células diana fundamentalmente son los linfocitos T4 (aunque también se unirá a los linfocitos B que tiene CD4, a los macrófagos, a las células cerebral, y a los precursores de hematíes); este episodio se manifiesta como un cuadro pseudogripal; es importante saber que la respuesta inmunitaria en forma de Acs frente al virus se puede demorar 6-8 semanas (periodo de ventana +/- 3 semanas); a continuación el ARN se copia a ADN por acción de la transcriptasa inversa, se pone en circulación y se integra en el ADN de la célula (periodo de latencia); latencia o crecimiento es clave de la patogenia de la enfermedad; normalmente la fase de latencia se prolonga durante periodos largos de tiempo (2-8 años incluso más), pero en un momento dado puede progresar la enfermedad con un progresivo deterioro de la inmunidad hasta desarrollar el SIDA; el ciclo biológico se resumen =>
Entrada de virus – transcripción de ARN al ADN – integración en la genoma de T4 – formación de nuevos viriones tras periodo de latencia (al salir, el virión tomara en su salida parte de la membrana celular para utilizarla como su envuelta, esto hace que se destruye los T4, se paraliza el sistema inmunológica y acaba provocando el SIDA.
Epidemiologia – las vías de transmisión del virus => por sangre, sexual y vertical-perinatal; en España la tasa de transmisión por sangre es importante (el principal grupo afectado son los UDVP/ ADVP y homosexual), a diferencia de Francia o EEUU, donde los mas afectados son homosexuales; en cuanto a las tasas de transmisión madre-hijo oscilan 15-50%, cobrando una especial importancia en África; la transmisión al personal sanitario o similar es 0,2% y requiere contacto con mucosas de la sangre o liquido corporal infeccioso (o también de líquidos donde se haya cultivado al virus).
Sintomatología clínica de SIDA – desde que una persona se infecta hasta que se desarrolle la enfermedad, suele transcurrir 6-10 años; el estudio de la evolución de SIDA puede realizarse por las manifestaciones clínico que van apareciendo o por marcadores bioquímicos (el descenso de la cifra de linfocitos T4); a partir del 1996 la determinación de la cantidad de virus circulante en la sangre de la persona infectada (carga viral) se ha convertido en principal marcador de la evolución de la enfermedad.
Fases de la enfermedad
(1) fase de la infección aguda => la mayoría de los pacientes experimentan al cabo de unas 3 semanas de haber infectado con el virus una serie de síntomas pseudogripales como fiebre, cefalea, eritema, adenopatías y sensación de mal estar, desaparecen después de 1-2 semanas; durante esta fase, el VIH se multiplica a gran velocidad; en un primer momento se produce un descenso de la cifra de linfocitos (total), pero dentro de poco alcanzan las cifras normales en respuesta de una activación del sistema inmunológico; los individuos son altamente contagiosos durante esta fase;
(2) fase asintomática que puede durar 10 años o incluso mas; durante este periodo, el virus continua replicándose, causando destrucción progresiva del sistema inmune; durante esta fase, el recuento de los linfocitos es normal;
(3) fase sintomática precoz, se suele iniciar el desarrollo del síntoma clínico característica de la enfermedad; apareciendo infecciones oportunistas de carácter leve p.ej. de tipo viral => CMV, Herpes zoster, de tipo bacterianas => Mycobacterium, Legionella, infestación de parásitos => Pneumocystis carinii, Cryptosporidium, algunos hongos => Aspergillus y Cándida;
(4) fase avanzada en la que aparecen infecciones y tumores, definitorios del SIDA (sarcoma de Kaposi) que además, puede complicarse con un cuadro neurológico (demencia del SIDA) con alteraciones motoras y del área cognitiva, debido a la acción directa del virus sobre SNC; la supervivencia media de los pacientes con la SIDA ya desarrollado suelen ser 18-125 semanas, dependiendo del tipo de infección que tenga; en ningún caso habrá supervivencia cuando están en esta fase.
(1) fase de la infección aguda => la mayoría de los pacientes experimentan al cabo de unas 3 semanas de haber infectado con el virus una serie de síntomas pseudogripales como fiebre, cefalea, eritema, adenopatías y sensación de mal estar, desaparecen después de 1-2 semanas; durante esta fase, el VIH se multiplica a gran velocidad; en un primer momento se produce un descenso de la cifra de linfocitos (total), pero dentro de poco alcanzan las cifras normales en respuesta de una activación del sistema inmunológico; los individuos son altamente contagiosos durante esta fase;
(2) fase asintomática que puede durar 10 años o incluso mas; durante este periodo, el virus continua replicándose, causando destrucción progresiva del sistema inmune; durante esta fase, el recuento de los linfocitos es normal;
(3) fase sintomática precoz, se suele iniciar el desarrollo del síntoma clínico característica de la enfermedad; apareciendo infecciones oportunistas de carácter leve p.ej. de tipo viral => CMV, Herpes zoster, de tipo bacterianas => Mycobacterium, Legionella, infestación de parásitos => Pneumocystis carinii, Cryptosporidium, algunos hongos => Aspergillus y Cándida;
(4) fase avanzada en la que aparecen infecciones y tumores, definitorios del SIDA (sarcoma de Kaposi) que además, puede complicarse con un cuadro neurológico (demencia del SIDA) con alteraciones motoras y del área cognitiva, debido a la acción directa del virus sobre SNC; la supervivencia media de los pacientes con la SIDA ya desarrollado suelen ser 18-125 semanas, dependiendo del tipo de infección que tenga; en ningún caso habrá supervivencia cuando están en esta fase.
Diagnóstico de laboratorio de la infección por VIH – en España fundamentalmente serológico, por la importancia y las implicaciones que conlleva; se realiza mediante técnicas de ELISA en primera instancia (técnica de cribado), aplicando a los positivos, métodos de confirmación => Western Blot (WB), inmunofluorescencia (IFI) o radioinmuno-precipitacion (RIPA).
**) El Western Blot es más utilizado y permite diferenciar los Acs frente a las distintas proteínas del virus; tiene distintos criterios para la interpretación de los resultados (OMS, CDC, Cruz Roja) y los resultados se clasifiquen en:
-Positivos => lo más aceptado es que haya bandas de envoltura (g41, gp120 y gp160) y además bandas del core (p24, p31 y p66) o de la polimerasa o de ambos.
-Indeterminados => se detecta la presencia de alguna banda frente a alguna proteína del virus (solo algunas proteínas del core en pacientes con lupus y factor reumatoide).
-Negativo => ausencia de banda o que no se corresponde a ninguna del virus (a estas personas se hace un seguimiento durante 6 meses, para descartar que no sean falsos negativos).
La técnica de WB consiste básicamente en la incubación de unas tiras de nitrocelulosa en los que sean transferido las proteínas de los virus, básicamente las estructuras con el suero del problema durante un tiempo que oscila 2-4 horas hasta los 18 horas; tras cual se revela la presencia de Acs frente a diferente proteínas del virus mediante diferentes técnicas inmuno-enzimáticas dependiendo del fabricante; el resultado será la aparición de bandas coloreadas de mayor o menor intensidad en el lugar de la tira donde están situadas las proteínas de VIH contra las cuales existen Acs en el suero del problema; la lectura puede hacerse de manera manual, comparando las bandas con un control (+) o de manera automatizada por densitometría; recordar en valores absolutos, la cifra de CD4 900-1500 linfocitos/m3 de sangre (en valores relativos 35-45%); las de CD8 600-900 linfocitos/m3 de sangre; cuando la cifra de CD4 disminuye por debajo de las 200-400 linfocitos/m3 de sangre, será indicativo de SIDA.
*) Los métodos de cribado (ELISA) son más sensibles y más específicos, siendo lo más novedoso los de 3ª generación con capacidad de detectar IgG e IgM, acortando el periodo de ventana.
*) También existen métodos rápidos, aplicables en situación de urgencia como la aglutinación con partículas de látex o los que utilicen Ags fijados a soportes solidos o membranas (se llama Dot-Blot).
*) Las técnicas de centros especializados => cultivo y PCR; la PCR es una técnica con mucho futuro que presenta una enorme sensibilidad y especificidad, pero no están al alcance de la mayor parte de los laboratorios; una importancia aplicación de estas técnicas es el diagnostico de hijos y madres portadoras del VIH.
*) Marcadores de monitorización o seguimiento de la enfermedad (detección del Ag p24); en fases tardías, se puede observar el declinar de los Acs anti p24 que se pueden utilizar con el mismo fin.
*) De todos modos, el que más se utiliza para un diagnóstico de SIDA es el recuento celular de los linfocitos CD4 o T4 (o el cociente respecto a los T8).
MÉTODOS DIAGNÓSTICOS EN VIROLOGÍA CLÍNICA
Objetivo de laboratorio - proporcionar el diagnóstico etiológico y orientar correctamente el tratamiento en el menor tiempo posible; de manera simultanea se intenta practicar 2 tipos de diagnostico =>
- Dº directo (visualizar o aislar el germen mediante el cultivo e identificarlo => en virología clínica no es posible, por las características físicas y biológicas del virus, porque se ha de hacer mediante la detección de sus componentes, p.ej. Ags o ácidos nucleicos).
- Dº indirecto (la identificación de los componentes de la respuesta inmune especifica/ Acs generados).
Objetivo de laboratorio - proporcionar el diagnóstico etiológico y orientar correctamente el tratamiento en el menor tiempo posible; de manera simultanea se intenta practicar 2 tipos de diagnostico =>
- Dº directo (visualizar o aislar el germen mediante el cultivo e identificarlo => en virología clínica no es posible, por las características físicas y biológicas del virus, porque se ha de hacer mediante la detección de sus componentes, p.ej. Ags o ácidos nucleicos).
- Dº indirecto (la identificación de los componentes de la respuesta inmune especifica/ Acs generados).
Metodos de diagnostico directos:
a) Examen directo de la muestra (macroscópica /a simple vista) => aspecto purulenta (en una infección viral nunca hay pus), presencia de sangre, moco, etc.
b) Microscópia => con la Microscópia óptica solo se puede identificar los cambios celulares (efecto citopático) sufrido por las celulas infectadas y con la Microscópia electrónica se puede visualizar el virus (en laboratorios de experimentación).
c) Cultivo => los virus se multiplican exclusivamente en el interior de las celulas vivas, por ello debemos preparar previamente un soporte celular que permita su crecimiento in vitro mediante siguientes técnicas:
- cultivo de órganos => las secciones de algunos órganos pueden ser viables varias semanas y nos permiten cuidadosamente aislar por ej. virus sincitial respiratorio (VRS) mediante secciones de tejido respiratorio.
- cultivo de tejidos => fragmentos de tejidos en suspensión (cultivar adenovirus en un tejido adenoideo)
- cultivos celulares => celulas aisladas obtenidas por disociación mecánica y con enzimas proteolíticas a partir de tejidos; las celulas disociadas y separadas se colocan en un frasco de cristal o de plástico; las celulas se adhieren a las paredes del frasco y se cubren con medios nutritivos para mantenerlas viables; en condiciones optimas, las celulas se multiplican hasta que cubran la pared formando una capa continua de crecimiento sobre las que se podrán replicar los virus del problema; tipos de cultivos celulares:
*) cultivos primarios => es el primer pase in vitro, tomados directamente de un organismo vivo; las celulas se siembran en un frasco con medio de crecimiento, conservan el numero de cromosomas, tienen un periodo de vida corto y permiten el crecimiento de gran variedad de virus (p.ej. celulas del riñon de conejo y mono, embrión de pollo).
*) lineas diploides => son celulas de un solo tipo (somáticas) que se pueden cultivar durante un tiempo limitado, conservan el numero de cromosomas (46) y con ventaja de que se mantiene durante mas tiempo que cultivo primario.
*) lineas celulares continuas => se cultivan in vitro indefinidamente y tiene un cariotipo heteroploide (numero menor que las celulas somáticas); se originan de tejido maligno o por mutación de una célula diploide; el cultivo se multiplican de forma indefinida y suelen presentar aberraciones en el numero de cromosomas; estas celulas se pueden mantener a -70ºC o -90ºC indefinidamente (p.ej. lineas celulares Hep-2 y Vero).
*) Shell-vial => es una técnica de cultivo celular que se ha desarrollado en los últimos años y que permite obtener el crecimiento de numerosos virus y ciertas bacterias en un corto periodo de tiempo (24-48 horas); sobre un vial se coloca una mono capa de celulas con 1ml de medio de crecimiento, y sobre ello se coloca 0,2 ml de la muestra problema; el método se basa en la centrifugación (suave) de la muestra sobre la mono capa, y tras un corto periodo de incubación se pone de manifiesto la expresión de los Ags virales en la mono capa mediante tinción inmunológica; la ventaja => la rapidez de obtención de resultados en 24-48 horas, detectamos los Ags a las pocas horas de iniciarse la infección; tiene una sensibilidad superior al cultivo celular, porque inoculamos el mismo volumen de muestra en un área mas pequeña y mas fácil la observación al microscopio de fluorescencia.
Identificación del crecimiento en el cultivo celular - las mas frecuentes y disponibles en el laboratorio:
1). Efecto citopático - los virus al multiplicarse provocan cambios en la célula donde se replican que se manifiesta por una modificación en la morfología celular que se pueden observar (p.ej. inclusiones dentro de las celulas, hinchazón del citoplasma, formación de celulas gigantes multi-nucleadas) en la célula sin teñir o teñidas (se ve mas detalladas); cada virus presenta un tipo de efecto citopático característico que puede ser identificado en menos de 1 semana (p.ej. enterovirus, herpesvirus, adenovirus o poxvirus tienen como efecto citopático la destrucción o lisis celular en 24-48 horas; la fusión celular/ formación de sincition son característico de herpes virus, CMV, virus herpes zóster, etc.)
2). Formación de cuerpos de inclusión - son cambios histológicos que se producen en las celulas por los componentes virales o por variaciones en las estructuras celulares; pueden localizarse en el núcleo, en el citoplasma o en ambos y se clasifican según su tinción en eosinófilos o basófilos; cada virus produce unos cuerpos de inclusiones característicos.
3). Hem-adsorción - es la capacidad que adquieren las celulas infectadas por un virus para adherir a su superficie los hematíes de diversas especies (p.ej.aves, carnero).
4). Hem-aglutinación - la capacidad que adquieren las celulas infectadas por el virus de aglutinar diversos tipos de hematíes, por la formación en su membrana de este tipo de proteínas, las hemaglutininas.
5). Detección mediante metodos inmuno-enzimáticos o por inmunofluorescencia, de los Ags virales mediante Acs específicos para los cuerpos de inclusión celular.
Las muestras para el aislamiento de virus se deben recoger lo antes posible, no después de los 3-7 primeros días del inicio de la enfermedad; se pueden conservar a 4ºC durante 24 horas y si no, se deben congelar a -70ºC porque muchos virus son lábiles a -20ºC; las muestras que se utilizan con mayor frecuencia son secreciones nasales, frotis faríngeo, exudado conjuntival, líquidos vesiculares, raspados de piel, heces, orina, LCR, etc.
d) Detección de los componentes estructurales virales - las técnicas mas usadas que permiten detectar Ags en suero y líquidos orgánicos (cuando existe una alta concentración viral, sera fácil detectarlos) son:
- Aglutinación en látex => a las moleculas de látex se les une varias moléculas de Acs conocidos y cuando se pone en contacto con una solución que contiene el Ag (la muestra problema) se origina una aglutinación que puede visualizarse; es una técnica sencilla, sensible, re-producible y barata. Su sensibilidad dependerá de la pureza del Ac utilizado.
- Contra-inmunoelectroforesis => esta basada en el principio de que los Ags virales (o bacterianos en su caso) suelen tener carga (-) y los Acs (+), en medio alcalino; con este fundamento se colocan las soluciones de Acs conocidos y del Ag problema en unas cavidades realizadas en un gel de agarosa de tal manera que puedan difundir libremente; se colocan unas mechas en los extremos de la capa de agarosa, que conectan con unas cubetas que contienen un buffer con una composicion diferente dependiendo del sistema Ag-Ac; cuando se aplica una corriente eléctrica, las moléculas de Ags con carga (-) migran hacia el ánodo que esta en el extremo opuesto de la placa; los Acs son arrastrados por el buffer levemente alcalino y, en el punto en que ambas lineas se encuentran, se forma una banda de precipitación visible; es una técnica de alta sensibilidad pero laboriosa, que precisa una alta concentración de Ag y Ac.
- Enzimoinmunoensayo => se basa en la detección de Ags mediante el empleo de un Ac unido a una enzima, que mantiene la capacidad de canalizar la reacción Ag-Ac; el enzima utilizado puede ser peoxidasa de rabano, Beta-galactosidasa o fosfatasa alcalina; la presencia del inmuno-complejo es detectada por una reacción coloreada que se produce al añadir el sustrato; el empleo de enzimas tiene una serie de ventajas:
*) el enzima se une al Ac pero deja libre los lugares de unión al Ag
*) el enzima no se modifica con la reacción Ag-Ac y queda unido al inmuno-complejo junto con el sustrato amplificando la reacción y aumentando la posibilidad de detección
*) los conjugados con enzimas son muy estables
*) la lectura de la reacción se realiza en un espectrofotómetro y la cantidad de sustrato liberado es directamente proporcional a la cantidad de Ag fijado en la reacción
*) la lectura también puede hacerse cualitativamente de forma manual, "de visu".
La reacción tiene lugar en 2 fases => en la 1ª- en unos pocillos sobre los que se ha fijado un Ac especifico; al agregarle la muestra que puede contener los Ags, se unen formando el complejo Ag-Ac; posteriormente se hace un lavado para eliminar el resto de Ags no unidos a los Acs de la placa y otras partículas que pudieran interferir, en la 2ª- se agrega un Ac marcado con un enzima que se une a los sitios de unión del Ag y al añadirse un sustrato, da lugar a una reacción coloreada, que procederemos a medir en un espectrofotómetro; es una técnica que necesita varias horas para su realización.
- Radioinmunoanalisis => tiene el mismo fundamento que el ELISA, pero en vez de unir un enzima al Ac, se le une un radioisótopo, y lo que se mide en ultima instancia es la radiactividad que estará en proporción directa a la cantidad de Ag que había en la muestra problema; es una técnica con la misma sensibilidad que el ELISA, pero es mas costosa y se necesita trabajar con material radioactivo, lo que plantea problemas en cuanto al personal y las instalaciones; esta técnica se utilizo por primera vez para detectar el Ag de superficie del virus de la hepatitis B.
- Inmunofluorescencia directa (IFD) => el Ag unido a una fase solida, en este caso un portaobjetos, se pone en contacto con el Ac marcado con una sustancia fluorescente (p.ej. isocianato de fluoresceina, rodamina, europio, etc.); tras un periodo de incubación, se lava para eliminar el exceso de Acs y se observa al microscopio de luz ultravioleta; esta técnica nos permite demostrar no solo la reacción Ag-Ac, sino también la localización exacta donde se produce (superficie celular, citoplasma, núcleo...).

.jpg)















.jpg)











































